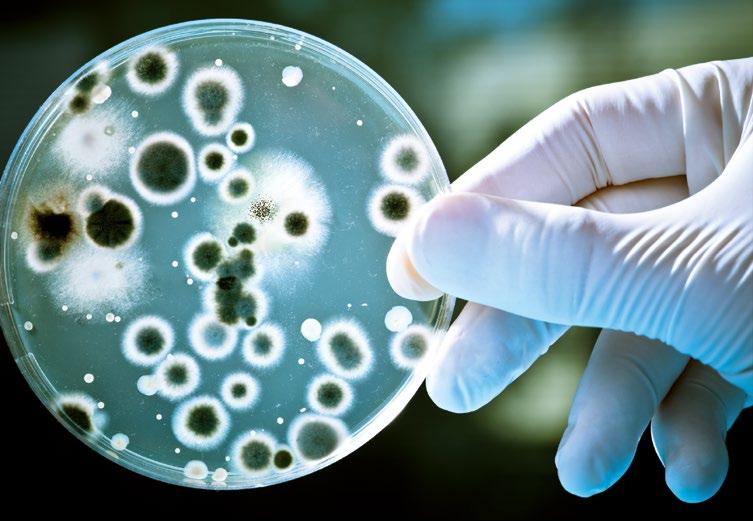

LIEFERPROGRAMM
Putz- und Fassadensysteme




40.000 250 Werke weltweit 90 80 Rohsteinbetriebe
Knauf ist ein Familienunternehmen, aus dem längst eine Unternehmensfamilie geworden ist. Zur Familie gehören unsere Mitarbeiterinnen und Mitarbeiter, unsere Kunden und Konsumenten. Unsere Kraft stammt aus der Erde. Ökologie und Ökonomie sind daher für uns untrennbar verbunden. Das zeigen wir. Danach handeln wir. Unser Kunde steht im Mittelpunkt. Er ist Sinn und Ziel unseres Denkens und Handelns. Wir machen Markt. Wir planen Innovation für den Bedarf von

morgen. Wir sind Marktführer. Das verpflichtet uns zur Verantwortung für Öffentlichkeit und Umwelt. Mit der hohen Qualität unserer Produkte fördern und gestalten wir das Wohlbehagen der Menschen. Wir sind so gut wie die Summe unserer Mitarbeiter. Wir bauen auf ihre Leistungsfähigkeit und Kreativität. Unsere Zukunft verwirklichen wir mit unserem Gewinn. Erfolgreiche und zufriedene Kunden sind dafür die Voraussetzung. Modernste Fertigungstechniken
kennzeichnen unsere Betriebe. Sie sind mitarbeiterfreundlich, rationell, ressourcen- und umweltbewusst. Von der Planung über den Handel bis zum Handwerk: Das Portfolio von Knauf ergibt ein bestmöglich abgestimmtes Leistungsspektrum für Architekten, Bauherren und Handwerker.
„Mehrwert bieten“ – das bedeutet: Wir und Ihre Märkte, generieren daraus pass- wicklungsmöglichkeiten. Knauf-Mitarbeiter sind kommunikative Allrounder: Freundlich und unbürokratisch stehen sie Ihnen jederzeit zur Seite. Wir wissen: Nur wer Wissen teilt, sorgt dafür, dass Wissen sich vermehrt und „mehr wert“ ist.
Symposien, Händlerveranstaltungen, Messen und Workshops zeigen hautnah, wie man mit Knauf-Systemen noch effizienter arbeitet. Sie bieten Innovatives und Bewährtes in Praxis und Theorie.


Knauf pflegt gute Verbindungen zu allen bedeutenden Fachmedien. Berichte über Referenzobjekte mit fachgerechten und oft spektakulären Ausführungen rücken Knauf-Lösungen regelmäßig in das Brancheninteresse.
www.knauf.de/presse

Unsere Forschung ist Ihr Vorsprung: Knauf ist Spitzenreiter bei der Entwicklungs- und Innovationsarbeit. Unsere Prüfgeräte und -methoden gehören zu den international leistungsfähigsten Anlagen. Damit gewährleisten wir offiziell zertifizierte und zulassungsrelevante Prüfungen.
Fachunternehmer Club – Mehrwerte für echte Profis
Wir bei Knauf arbeiten genau wie unsere Fachunternehmer Club-Mitglieder mit höchstem Qualitätsanspruch und kundenorientiert. Um unsere Mitglieder im Geschäftsalltag dabei zu unterstützen, bieten wir ihnen ein umfangreiches Angebot an exklusiven Leistungen.

Qualifizierte Berater begleiten Unternehmen von der Planungsphase bis zur Gewährleistung. Persönliche Systembetreuer sind Ansprechpartner für Kostenoptimierung, Produktberatung und Sonderlösungen, Ausschreibungen, Objekteinweisungen oder Bauberatung.
Schnelle Antworten für effektive Arbeit mit täglich zahlreichen Empfehlungen an Baustoff-Fachhändler, Fachunternehmer und Architekten gibt der telefonische Auskunftsservice von Knauf. Architekten, Stuckateure, Bauingenieure und Holzbautechniker geben fachmännisch Auskunft. Jeden Wochentag von 7:00 bis 18:00 Uhr (Freitag bis 17:00 Uhr).


www.knauf.de/tas

Seminare, Webinare, Podcasts und vieles mehr: Unter dem Begriff „Knauf Akademie“ findet sich alles, was zum Bereich Bildung gehört. Neben umfangreichen Weiterbildungsmaßnahmen treibt Knauf auch die Einrichtung branchenrelevanter Studiengänge voran. Hierfür werden unter anderem Gastvorlesungen gehalten und Lehrer sowie Dozenten unterstützt.

www.knauf-akademie.de
Bei der Auftragsabwicklung zeigt sich, wer gut organisiert ist. Ob Containerlogistik oder der einzigartige Logistik-Service SPRINTER plus IMBAG für die Fassadendämmung – Knauf-Logistiker sind bestens ausgebildet, kundenorientiert und garantieren pünktliche Lieferungen.
www.knauf.de/pufalogistik
Es liegt an uns und unseren Kunden, die Chancen der aktuellen Marktlage zu erkennen und zu nutzen. Hierfür bietet das Partner Programm die besten Voraussetzungen erfolgreicher Marktbearbeitung. Dabei profitieren die Knauf Partner von einer Vielzahl zusätzlicher Leistungen und Förderungen.
Erste Ansätze zur e ffi zienten Wärmedämmung? Einen Überblick über Gebäudeenergieverluste oder zur Fassadengestaltung? Was ist zu tun, wie geht‘s, was passt? Viele Fragen, auf die es zeitgemäße, gesicherte und verständ-
liche Antworten gibt. Die umfangreichen Knauf Tools sind die schnelle Lösung, wann Sie wollen, wo Sie wollen. Benutzerfreundliche und sichere Menüführung bringt Sie schnell zu den gewünschten Ergebnissen. Knauf Beratungskompe -

Top-Themen beim Hausbau
tenz per Mausklick, für Architekten, Fachunternehmer und Mitarbeiter im Baustoffhandel. Da kommt zusammen, was zusammen passt.
Wer sich seinen Traum vom eigenen Wohnen verwirklichen möchte, hat unzählige Fragen und steht vor vielen Entscheidungen.
Deshalb haben wir hier viele Informationen rund um die Top-Themen Schallschutz, Energieeffizienz, Raumklima und Feuchteschutz zusammengestellt.
Leistungsverzeichnisse – schnell, komfortabel, umfassend
Ein komplettes Wärmedämm-Verbundsystem in nur wenigen Minuten ausschreiben?
› Über 3.000 tagesaktuelle Ausschreibungstexte
› Systembezogen gegliedert
› Alle gängigen Formate (Word, GAEB, PDF, HTML)


Knauf Farbcenter
Harmonische Farbkonzepte einfach gestalten
› Informationen zu Hellbezugswerten des Farbtons
› Informationen zu Machbarkeit des Farbtons in Knauf Farben und Putzen
› ... und vieles mehr
Keine Zeit verlieren ... registrieren!
Mit der neuen Bestellplattform für lose Ware, Knauf Container Next, gewinnen Sie täglich Zeit für Ihr Geschäft.
› Neustellung, Nachfüllung und Rückholung per Fingertipp
› Silobewegungen planen & beauftragen – wann Sie wollen
› Bestell- und Lieferstatus tagesaktuell sichtbar
› ... und vieles mehr

Technische Detailblätter
Rund um die Uhr abrufbar
Hier finden Sie ständig aktualisiert alle Technischen Blätter zu Putzen, Farben und WARMWAND Systemen im PDF-Format. Sie enthalten wichtige Hinweise zu
› Produkteigenschaften
› Einsatzgebieten
› Verarbeitung
Überzeugende Lösungen
› Technischen Daten
› Ausschreibungstexten
www.knauf.de/tb
Gewinnen Sie einen Eindruck über die vielfältigen mit Knauf durchgeführten Objekte – ob Neubau, Modernisierung, unterschiedlichste Gebäudetypen oder Raumsysteme. Hier findet sich für nahezu alle Anforderungen ein erfolgreich mit Knauf durchgeführtes Objekt.
www.knauf.de/referenzen
Alles an einem Ort: myKnauf myKnauf ist unser neues, digitales Kundenportal, das Ihnen jede Menge Vorteile bringt.


› Verfolgung von Bestellungen und Lieferungen
› Stammdaten
› Lieferscheine online verfügbar
› Archiv Ihrer Bestellungen
› Produktkatalog,Videos und Marketing-Vorlagen
Knauf Infothek-App


Neues Design, neue Funktionen. Mit unserer Knauf Infothek-App bleiben Baufachleute keine Antwort lange schuldig. Ihnen stehen sämtliche Dokumentationen der Knauf Gips KG rund um die Uhr in der aktuellen Fassung zur Verfügung. So bleibt man sicher immer auf dem neuesten Stand.
www.knauf.de/myknauf
www.knauf.de/infothek


SCHLAU, weil die Knauf WARM-WAND Systeme alle Dämm-Anforderungen abdecken.
Schutzfassade Hochleistungsfassade
Brandschutz A / Unbrennbar B1 / Schwer entflammbar Bis A / Unbrennbar (Je nach Dämmstoff) B1 / Schwer entflammbar B2 / Normal entflammbar
Schallschutz
Dämmwert
Wasserdampfdiffusion
Dämmstoff Mineralwolle Polyurethan, Phenolharz Mineralwolle, EPS EPS Holzweichfaser



SCHLAU, weil Sie die mineralische Knauf-Kompetenz zu Ihrem Vorteil machen.
› Höhere Schichtstärken sorgen für hervorragenden Schall- und Brandschutz
› Höhere Schichtstärken schützen besser vor Witterung und mechanischer Belastung



› Schon immer ohne Biozide
› Generell nicht brennbar



Sockel-SM Pro Der Sockelputz mit Feuchteschutz

SM700 Pro Der Alleskönner an der Fassade
SCHLAU, weil Ihre Fassaden optisch jeden Wunsch erfüllen.
SP 260 Pro Der Universal-Scheibenputz mit höchster Ergiebigkeit
Kammzug Besenstrich Betonoptik Filzputz Kratzputz Harte Beläge Farbvielfalt Scheibenputz
Alle Strukturen und über 400.000 Farbrezepturen sind möglich.


SCHLAU, weil Sie die Umwelt schonen und lange Zeit für schöne Fassaden sorgen.
MineralAktiv
Das Putz-Farbe-System gegen Algen und Pilze
Biozidfreier Fassadenschutz
› Drei innovative Schutzfaktoren halten dauerhaft Pilze und Algen fern
› Hochergiebig und schnell trocknend

› Wirtschaftliche Verarbeitung
› Umfassende Gestaltungsmöglichkeiten
ALLE VORTEILE FACHHÄNDLER FINDEN
MEN IN WHITE SCHON DABEI?
Die interaktive Präsentation bietet Ihnen kompakt und verständlich alle Vorteile inklusive Erklärvideos, Online-Trainings und vieler Beispielprojekte.
Unsere Systeme und Produkte erhalten Sie bei allen Knauf Handelspartnern. Tipp: Besondere Beratung und Services bieten Ihnen 100 Knauf Fassadenkomptenz-Händler.



Exklusive Infos und Prämien bieten wir Stuckateuren, Verputzern und Malern in unserem Dialogprogramm. Weit über 4.000 Fachunternehmer gehören bereits dazu.
www.knauf.de/seischlau
www.knauf.de/haendlersuche
www.men-in-white.de

Zur besseren Verarbeitung und guten Haftung des Putzes ist je nach Untergrund oft eine Vorbehandlung des Putzuntergrundes erforderlich. Untergrundvorbehandlungen gewährleisten eine gleichmäßige Trocknung und Erhärtung der aufzutragenden Putzschichten.

Anwendung
Außen Innen Mit Maschine Von Hand
Putzgrundvorbehandlungen
Schalungsrauer Beton
Glatte Betonfertigteile
Porenbeton Mauerwerk
Untergründe
Porenbeton Plansteine
Porosierte Ziegel
Bimssteine
Kalksandstein Mauerwerk (kleinformatig)
Kalksandstein Planstein (großformatig)
Der Vorspritzer ! !
Grundol
Casiol Grund
Minerol Fixaktiv X
Atonol
Haftbrücken
Betokontakt X ! !
Spraykontakt X ! !
PutzPin X X
Aton Sperrgrund
Quarzgrund Pro X
Raumklima Grundierung X X
SM300/SM700/Lustro ! ! !
Aufbrennverhinderung
Aufbrennsperre X ! ! !
Isogrund ! !
Spezialanwendungen
Algizid X X
HWL-Platten
Mischmauerwerk
Altanstriche
EPS/XPS-R/PUI/PIR Tragfähige
Kalk-Zement-Putze
Tragfähige
Trockene Gipsund Gips-Kalk-Putze
Gipsund Gipsfaserplatten
Schaumglas/Foamglas
Folgebeschichtung
Möglich X Nicht möglich
Gipsputze
Kalkund Kalk-Zement-Putze
Farben Oberputze
! Erforderlich Je nach Beschaffenheit des Untergrundes Nicht geeignet/ nicht zweckmäßig
1) Zusätzliche Gewebearmierung
2) Putzträger verwenden
3) In Abhängigkeit vom Farbton
Da der Zustand des Untergrundes für die Putzhaftung von wesentlicher Bedeutung ist, ist die Prüfung des Putzgrundes zwingend erforderlich. Ganz allgemein und unabhängig vom Material muss der Untergrund für Putzarbeiten fest, sauber, hinreichend eben, trocken und frostfrei sein. Ausschlaggebend für die sichere Haftung des Putzes am Untergrund sind außerdem dessen Saugfähigkeit und die Rauheit der Oberfläche. Während zunehmende Rauheit die Putzhaftung stets verbessert, darf die Saugfähigkeit weder zu groß noch zu gering sein. Mauerwerk ist in der Regel ein problemloser, putzfreundlicher Untergrund. Bei Modernisierungs- oder Sanierungsmaßnahmen können jedoch sehr unterschiedliche Mauerwerksarten und -qualitäten auftreten, die eine jeweils differenzierte Beurteilung und ggf. Behandlung erfordern.
Der Putzgrund (Untergrund) hat maßgeblichen Einfluss auf die Auswahl des Putzmaterials und vor allem auf die Art der Verarbeitung. Vor Beginn der Putzarbeiten ist der Putzgrund auf seine diesbezügliche Eignung zu prüfen. So sollte ein guter Putzgrund folgendermaßen sein:
› Trocken und saugfähig (Benetzungsprobe)
› Staubfrei
› Griffig und tragfähig

› Frei von Schalungs- und Trennmittel
› Frostfrei und mit Untergrundtemperatur über +5°C
› Rissfrei
› Frei von Algen, Moosen und Ausblühungen
Der Auftragnehmer hat bei festgestellten Mängeln des Untergrundes dem Auftraggeber schriftlich Bedenken nach VOB/B § 4 Nr. 3 hinsichtlich der Ausführung der Putzarbeiten bekanntzugeben. Der Empfang ist schriftlich zu bestätigen. Zur Dokumentation der Mängel sollten diese zusätzlich fotografiert werden. Außerdem empfiehlt es sich, ein Protokoll über die durchgeführten Prüfungen zu erstellen.
Die Prüfung durch Wischprobe mit der flachen Hand ist erforderlich, um Staub und Schmutz festzustellen. Die Wischprobe ist unbedingt an mehreren Stellen durchzuführen

Bei leichtem Anklopfen des Untergrundes können Hohlstellen festgestellt werden. Diese sind zu entfernen und mit artgleichem Material zu schließen.
Bei der Benetzungsprobe wird sauberes Wasser mit einer gut angenässten Deckenbürste gleichmäßig aufgetragen. Der Untergrund ist ausreichend saugfähig, wenn nach spätestens 3–5 Minuten der Farbumschlag von hell- auf dunkelgrau stattfindet und das Wasser nicht vom Untergrund abperlt.

Dämmstoffe wie extrudierte PolystyrolHartschaumplatten (XPS-R) oder Holzwolle-Leichtbauplatten (HWL)

Sehr häufig werden Betonuntergründe wie z. B. Deckenstirnseiten, Über- oder Unterzüge mit XPS-R-Dämmstoffplatten wärmegedämmt. Rollladenkästen bestehen größtenteils an der Oberfläche aus HWL-Platten. Bei beiden Dämmstoffen ist es wichtig, dass sie einen kraftschlüssigen Verbund zum Untergrund haben. Je nach Putzart sind entsprechende Untergrundvorbehandlungen notwendig.
Betonuntergründe
Bei Beginn der Putzarbeiten muss die Feuchtigkeitsabgabe des Betons größtenteils abgeschlossen sein, sodass der Putzgrund saugfähig ist. Der Haftverbund zum Putz lässt sich durch eine Haftbrücke verbessern.
Hartgebrannte Klinker, Natursteine, glasierte Steine
Hier können Probleme mit glatten und zu wenig saugenden Oberflächen auftreten. Der Haftverbund zum Putz lässt sich durch eine Haftbrücke verbessern.
Vorhandene Altputze
Wände, die noch mit Altputz versehen sind, können neu verputzt werden, ohne dass der alte Putz entfernt werden muss. Dafür muss der vorhandene Altputz fest haftend, tragfähig sowie frei von Hohlstellen, Ausblühungen und Absonderungen sein und darf nicht stark absanden. Alle losen Bestandteile und Verschmutzungen sind durch gründliche Reinigung zu entfernen. Sollte ein hohes Saugvermögen festgestellt werden, kann dies durch Auftragen einer Aufbrennverhinderung reguliert werden.
Prüfung auf Maßnahme
Durch Augenschein
mürbe, lockere Teile Sinterhaut Kondenswasser anhaftende Kalkausscheidungen
Metall- und Stahluntergründe
Sie sind zum Verputzen nicht geeignet und müssen generell mit einem Putzträger überspannt werden. Vor dem Überspannen der Bauteile mit einem metallischen Putzträger ist ein Korrosionsanstrich auszuführen. Die Befestigung des Putzträgers erfolgt nach Angaben des Herstellers. Die Putzdicke über dem metallischen Putzträger muss mindestens 15 mm betragen.
Im Zuge von Umbauarbeiten kann das vorhandene (Alt-)Mauerwerk durch neues Mauerwerk ergänzt werden, z. B. beim Verschließen von Durchgängen, Fenstern etc. Durch die verschiedenen Steinqualitäten entsteht fast immer ein unterschiedliches Saugverhalten, was durch Auftragen einer Aufbrennverhinderung auszugleichen ist.
mechanisch entfernen mit Stahlbesen oder Stoßscharre aufrauen, sandstrahlen Trocknung abwarten mechanisch entfernen
Wischprobe anhaftenden Staub feucht abbürsten
Kratzprobe Oberflächenfestigkeit (Abplatzungen, Absanden, Abblättern)
Saugfähigkeitsprüfung (bei Betonuntergründen) Saugfähigkeit
Verarbeitungstemperatur
Raum-, Luft- und Umgebungstemperatur
Prüfung mit CM-Gerät Feuchtegehalt
Abreißprobe mit Armiergewebe Prüfung der Tragfähigkeit von Bestandsputzen/-beschichtungen
Oberfläche mit Stahlbesen aufrauen, sandstrahlen
Oberfläche mit Wasser und Bürste unter Zusatz von geeignetem Beton-Reinigungsmittel behandeln und mit klarem Wasser nachwaschen. Nach Trocknung sind die Flächen mit Betokontakt vorzubehandeln.
Nicht unter +5 °C Luft-, Material- und/oder Untergrundtemperaturen verarbeiten bzw. muss sichergestellt sein, dass bis zum ausreichenden Erhärten des Putzes die Temperatur nicht darunter absinkt.
Trocknung abwarten, eventuell heizen
Bestandsputz/-beschichtung entfernen
Merkblatt Gipsputz und gipshaltige Putze auf Beton und weitere Merkblätter des Bundesverbandes der Gipsindustrie e. V. unter www.knauf.de/dokumentencenter

Mit einem großen Programm an speziellen Produkten für die Untergrundvorbehandlung und deren ständiger Qualitätsüberwachung bietet Knauf die Gewähr für professionelle Verarbeitung und höchste Sicherheit im Ergebnis. Produkte für die Untergrundvorbehandlung haben wichtige Aufgaben zu erfüllen. Sie sorgen dafür, dass der Untergrund dem nachfolgenden Putz nicht zu viel Wasser entzieht. Sie gewährleisten eine einheitliche Trocknung, eine gleichmäßige Erhärtung und sichern eine optimale Haftung auf dem Untergrund
Festigkeit und Haltbarkeit des Putzes. Durch die staubbindende Wirkung erhöhen sie die Untergrundhaftung und sorgen für solide, langlebige Ergebnisse.
Eines haben sie aber alle gemeinsam –Knauf Grundierungen und Vorbehandlungen bilden die Basis für perfekte Oberflächen.
Maßnahmen zur Untergrundvorbehandlung sind besondere Leistungen und generell zu vergüten. Sind notwendige Untergrundvorbehandlungen nicht im Leistungsverzeichnis erfasst, so sind diese Leistungen nach Vorankündigung und Beauftragung durch den Auftraggeber gesondert zu vergüten. Erfolgt keine Maßnahme zur Vorbehandlung des Untergrundes, so kann im Allgemeinen der Erfolg der Leistung nicht sichergestellt werden.
Manueller Auftrag
Den Eimerinhalt vor der Verarbeitung gut aufrühren. Anschließend kann die Untergrundvorbehandlung entsprechend den technischen Blättern verdünnt oder unverdünnt mit der Lammfellrolle oder Bürste gleichmäßig aufgetragen werden.
Maschineller Auftrag
Untergrundvorbehandlungen können auch maschinell mit einem Handspritzgerät oder einem Airless-Gerät besonders rationell aufgetragen werden

Gehen Sie auf Nummer sicher Berührungen mit den Augen oder der Haut sollten nach Möglichkeit vermieden werden. Bei Berührung mit den Augen sofort gründlich ausspülen und gegebenenfalls einen Arzt aufsuchen. Bei Hautkontakt mit Wasser und Seife abwaschen. Im erhärteten Zustand sind Knauf Produkte physiologisch und ökologisch unbedenklich.
Knauf Spraykontakt



Voranstriche müssen vor der Weiterarbeit mindestens zwölf Stunden trocknen.
Die Ausnahme bildet Knauf Spraykontakt – die gebrauchsfertige, schnelltrocknende Spezialhaftbrücke für Gipsputze.
Durch das schnelle Trocknungsverhalten kann bereits nach ca. zwei Stunden (handtrocken) mit dem Putzauftrag begonnen werden. Damit geht das Grundieren jetzt noch leichter und sicherer. Unter kritischen Bedingungen zeigt diese Grundierung auf Basis einer Spezial-Kunstharzdispersion deutlich bessere Haftung als herkömmliche Putzhaftbrücken.
Im Innenbereich, vorzugsweise auf Beton, aber auch auf EPS und XPS-R, Ziegelmauerwerk, Porenbeton oder Kalksandstein, wird Spraykontakt als Putzhaftbrücke für Gipsputze nach DIN 18550 bei einer BetonRestfeuchte bis max. 4 Gew.- % eingesetzt.
Spraykontakt kann mit einer Rolle, einem Flächenstreicher oder, besonders rationell, einem Airless-Spritzgerät wie z. B. der PFT SAMBA aufgetragen werden.
Haftbrücken
Haftbrücken werden zur Haftvermittlung auf nicht oder schwach saugenden, glatten Untergründen (insbesondere Beton) eingesetzt. Dispersionshaftbrücken wie z. B. Knauf Betokontakt sind mit Zuschlägen wie Quarzsand gefüllt hoch alkalibeständig und somit z. B. für relativ frischen Beton geeignet. Sie tragen zur besseren Haftung von Gipsputz und gipshaltigem Putz bei und dienen nach DIN 18550 als Ersatz für einen Zementvorspritz im Innenbereich. Sie bewirken keinen Porenverschluss, sodass die Diffusionsfähigkeit des Untergrundes nicht nennenswert beeinflusst wird.
Mineralische Putzhaftbrücken werden zur Verbesserung der Putzhaftung von Kalk-, Kalk-Zement oder Zementputzen auf nicht saugenden oder glatten Untergründen wie z. B. Beton verwendet. Ebenfalls können Zementvorspritzmörtel eingesetzt werden.
Absperrmittel
Absperrmittel, auch bekannt als Sperrgrund oder Isoliergrund, sind filmbildende Voranstriche, die das Anlösen von löslichen Stoffen aus dem Untergrund, wie z. B. Lignin bei Gipsplatten, verhindern sollen. Um ein Durchschlagen dieser Stoffe sicher auszuschließen, müssen Absperrmittel einen porenfreien Film bilden. Absperrgrundierungen wie z. B. Knauf Aton Sperrgrund bilden zudem eine Haftbrücke zwischen dem Putzgrund und dünnlagigen Oberputzen.
Aufbrennverhinderungen reduzieren die Saugfähigkeit des Untergrundes und bewirken dadurch eine Verbesserung der Putzhaftung. Um auf einem stark unterschiedlich saugenden Putzuntergrund (z. B. Stein mit Mörtelfugen) eine gute Putzoberfläche ohne Fugenabzeichnung zu erzielen, ist eine Vorbehandlung mit einer Aufbrennverhinderung erforderlich. Es ist wichtig, die jeweiligen Verdünnungsangaben einzuhalten. Je saugfähiger der Untergrund, umso stärker kann die Grundierung verdünnt werden. Die Grundierungen bewirken keinen Porenverschluss, sodass die Diffusionsfähigkeit des Untergrundes nicht nennenswert beeinflusst wird.
Putzträger
Wenn kein tragfähiger und zur Aufnahme von Putz geeigneter Untergrund vorhanden ist und dieser auch nicht im Rahmen der Untergrundvorbehandlung hergestellt werden kann, kommen Putzträger zum Einsatz. Putzträger sind meist metallische Drahtgewebe, insbesondere Streckgitter, Schilfmatten oder Holzwolleplatten, die zur Verbesserung der Putzhaftung oder zur Trennung der Putzlagen vom Putzgrund eingesetzt werden.
Für das Verputzen von kritischen Betondecken mit Gipsputzen eignet sich der Knauf PutzPin. Dieser wird im System mit Knauf MP 75 L auf Deckenflächen aus Beton verwendet, die ein übliches Verputzen nicht zulassen. Mit dem Putzträger können ansonsten ordnungsgemäße bzw. entsprechend vorbehandelte Betonuntergründe mit Restfeuchten bis 6 Gew.- % und Untergrundtemperaturen ≥ 2 °C verputzt werden. Speziell beim Einsatz von Deckenkühlsystemen können mit mechanisch befestigten Putzträgern die Kühlelemente zusätzlich fixiert und Putzdicken von 20 bis 25 mm aufgebracht werden.

Die Gebinde sind kühl und frostfrei (+ 5°C bis + 25°C) im ungeöffneten Originalgebinde lagerfähig. Das Produktionsdatum und die Mindesthaltbarkeit sind auf den einzelnen Gebinden abzulesen. Anbruchgebinde dicht verschließen. Vor direkter Sonneneinstrahlung oder Wärmeeinwirkung schützen.
Vorbehandlungen
Gipsputze
Spachtel pastös
Kalkputze
Unterputze
Oberputze
Sanierung
Dämmschüttungen
Innendämmung
WARM-WAND Dämmstoffe
WARM-WAND Klebe- und Armiermörtel
WARM-WAND Zubehör
AQUAPANEL® VHF
Gestaltungselemente
Farben
Vorbehandlungen
Haft- und Vorspritzmörtel
Aufbrennverhinderungen
Grundierungen
Haftbrücken
Spezialanwendungen
Aufbrennsperre ist eine Kunstharzdispersion mit hoher Alkalibeständigkeit, die innen auf stark saugenden Untergründen eingesetzt wird, bevor diese mit Gipsputzen verputzt werden. Sie reduziert die Saugfähigkeit des Untergrundes und das Risiko des Aufbrennens. Aufbrennsperre wird ebenfalls auf den Dämmplatten im Rotkalk in-System verwendet. Das Konzentrat wird abhängig vom Untergrund mit Wasser verdünnt (1:1 bis 1:3 Raumteile).

Details finden Sie im techn. Blatt K456.de
Eigenschaften und Mehrwert
› Für den Innenbereich
› Lösemittelfrei
› Saugfähigkeitsregulierend
› Gelb pigmentiert
› Verarbeitung mit Maschine oder von Hand
› Hohe Alkalibeständigkeit
› Verdünnung 1:1 bis 1:3 (Raumteile)
Diese Angaben sind Zirka-Werte und können je nach Art des Untergrundes abweichen.
Isogrund ist eine Aufbrennverhinderung auf trockene, staubfreie Unterputze und Armiermörtel, bevor dünnlagige Scheiben- oder Rillenputze aufgetragen werden.
Details finden Sie im techn. Blatt K455a.de
Eigenschaften und Mehrwert
› Für innen und außen
› Gebrauchsfertig
› Saugfähigkeitsregulierend
› Weiß pigmentiert
› Verarbeitung mit Maschine oder von Hand

› Wässrige Emulsion
› Trocknet weiß färbend aus
Diese Angaben sind Zirka-Werte und können je nach Art des Untergrundes abweichen.

Casiol Grund ist eine gebrauchsfertige, weiß pigmentierte, hoch diffusionsoffene, mineralische Calcium-Silikat-Grundierung zur Minderung von Kalkausblühungen, sowie zum Ausgleich des Saugverhaltens auf alkalischen Oberputzen vor dem Aufbringen von Farbanstrichen.
Details finden Sie im techn. Blatt B165C.de
Eigenschaften und Mehrwert
› Gebrauchsfertig
› Hoch diffusionsoffen
› Verkieselungsfähig für nachfolgende Dispersions-Silkatanstriche
› Für innen und außen
› Saugfähigkeitsregulierend
› Sehr emissionsarm, EMICODE EC1Plus
› Schützt vor Kalkausblühungen bei mineralischen Putzen
› Verarbeitung mit Maschine oder von Hand
› Weiß pigmentiert
› Annähernd tönbar nach Farbtonfächer Knauf ColorConcept
Diese Angaben sind Zirka-Werte und können je nach Art des Untergrundes abweichen.
Atonol ist ein weiß pigmentierter, lösemittelfreier Absperrgrund mit feinstem Quarzsand für Anstriche.

Atonol ist sowohl innen als auch außen auf Untergründen einsetzbar, bei denen mit einer Verfärbung durch lösliche Bestandteile gerechnet werden muss.
Details finden Sie im techn. Blatt B102.de
Eigenschaften und Mehrwert
› Für innen und außen
› Gebrauchsfertig
› Absperrend gegen Lignin und Gilbstoffe
› Schafft griffige Oberfläche
› Weiß pigmentiert
› Verarbeitung mit Maschine oder von Hand
› Lösemittelfrei
› Geruchsarm
› Alkaliresistent
› Saugfähigkeitsregulierend
Diese Angaben sind Zirka-Werte und können je nach Art des Untergrundes abweichen.

Grundol ist ein siliconverstärkter Tiefengrund für innen und außen zur Verfestigung von an der Oberfläche abgewitterten, leicht sandenden, aber sonst tragfähigen Kalk-, Kalkzement- und Zementputzen sowie Gipsputzen, Gipsspachtelmassen und Gipsplatten, bevor diese gestrichen oder überputzt werden. Grundol bindet kreidende, aber fest haftende und tragfähige Dispersionsfarbbeschichtungen.
Details finden Sie im techn. Blatt K451a.de
Eigenschaften und Mehrwert
› Für innen und außen
› Gebrauchsfertig
› Sehr hohes Eindringvermögen
› Diffusionsoffen
› Oberflächenverfestigend
› Staubbindend
› Saugfähigkeitsregulierend
› Lösemittel- und weichmacherfrei, emissionsarm
› Hydrophob eingestellt
› Verarbeitung mit Maschine oder von Hand
Diese Angaben sind Zirka-Werte und können je nach Art des Untergrundes abweichen.
Minerol Fixativ dient zur Verdünnung von Silikatfarben wie Minerol, Rotkalk Farbe E.L.F. und Silikatweiss E.L.F. sowie als Voranstrich zur Untergrundverfestigung.

Details finden Sie im techn. Blatt B135b.de
Eigenschaften und Mehrwert
› Für innen und außen
› Wasserverdünnbar
› Hoch diffusionsoffen
› Gutes Eindringvermögen
› Gute Verfestigungswirkung
› Milchig weiß
› Emissions- und lösemittelfrei
› Verarbeitung von Hand
› Untergrundverkieselnd
Diese Angaben sind Zirka-Werte und können je nach Art des Untergrundes abweichen.
Der Vorspritzer wird vorrangig zur Putzgrund-Vorbehandlung für Wandbaustoffe der Druckfestigkeitsklassen > 6 N/mm² auf rauem und rau geschaltem offenporigen Beton, Bruchsteinen, gereinigtem Altoder Mischmauerwerk, Holzwolle-Leichtbauplatten sowie KS-Mauerwerk verwendet. Der Vorspritzer schafft griffige Oberflächen und reguliert ungleiches Saugverhalten bei unterschiedlich oder zu stark saugendem Putzgrund.
Details finden Sie im techn. Blatt P286.de
Eigenschaften und Mehrwert
› Normalputzmörtel GP nach DIN EN 998-1
› Druckfestigkeitskategorie CS IV nach DIN EN 998-1
› Für innen und außen
› Wasserabweisend
› Grobkörnig
› Schafft griffige Oberfläche
› Verarbeitung mit Maschine oder von Hand
Diese Angaben sind Zirka-Werte und können je nach Art des Untergrundes abweichen.

Primerstift für Fensteranschlussprofile zur Haftverbesserung auf niederenergetischen Oberflächen, z.B. Lacke, Holzlasuren, Pulverbeschichtungen, Kunststoffoberflächen. Freigegeben für die Anwendung bei Fensteranschlussprofil Flexibel, Fensteranschlussprofil Duo G6, Fensteranschlussprofil Duo G10 und Fensteranschlussprofil Unterputz. Eine Klebeprobe ist weiterhin zwingend erforderlich.
Details finden Sie im techn. Blatt
Eigenschaften und Mehrwert
› Zur Haftverbesserung auf niederenergetischen Oberflächen
› Handliches Format
› Einfache Handhabung


Spraykontakt ist eine gebrauchsfertige Spezialhaftbrücke für Gipsputze auf Basis einer Kunstharzdispersion mit speziellen Feinstfüllstoffen. Im Innenbereich, vorzugsweise auf Beton, als Putzhaftbrücke für Gipsputze nach DIN 18550-2 zu verwenden. Abweichend von der DIN 18550-2 kann die Restfeuchte hier bis max. 4 Masse-% betragen.
Details finden Sie im techn. Blatt K454S.de
Eigenschaften und Mehrwert
› Für den Innenbereich
› Gebrauchsfertig
› Schnelle Trocknung
› Orange pigmentiert
› Verarbeitung mit Maschine oder von Hand
› Für maschinelle Verarbeitung optimiert
› Emissionsarm (geprüft nach AgBB)
› Emissionsklasse A+ gem. französischer VOC-Verordnung
› Geeignet für mineralische Untergründe (insbesondere Beton)
Diese Angaben sind Zirka-Werte und können je nach Art des Untergrundes abweichen.

Betokontakt ist eine mit reinem Quarzsand abgemischte Kunstharzdispersion mit hoher Alkalibeständigkeit. Im Innenbereich, auf dichten, nicht saugenden Untergründen als Putzhaftbrücke zu verwenden. Vor dem Auftrag von Gips- und Gipskalk-Putzen bzw. vor dem Ansetzen von Trockenputz ist eine Vorbehandlung mit Betokontakt erforderlich. Die Anwendung von Betokontakt ist besonders bei glattgeschaltem Ortbeton oder Vollbetondecken aus Bauelementen sowie abgezogenen Betonfertigteilflächen zu empfehlen.
Details finden Sie im techn. Blatt K454.de
Eigenschaften und Mehrwert
› Für den Innenbereich
› Besonders emissionsarm
› Gebrauchsfertig
› Schafft griffige Oberfläche
› rosa pigmentiert
› Verarbeitung mit Maschine oder von Hand
› Bei mineralischen Untergründen (insbesondere Beton)
› Emicode EC1PLUS geprüft
Diese Angaben sind Zirka-Werte und können je nach Art des Untergrundes abweichen.
PutzPin 8 und PutzPin 18 sind punktuelle Putzträger aus speziellem Kunststoff mit auf die Anwendungsgebiete abgestimmter Form und Oberfläche. PutzPin 8 ist geeignet für Putzdicken von 11 bis 16 mm. PutzPin 18 findet Anwendung bei Deckenkühlsystemen mit Putzdicken von 21 bis 28 mm.
Die Verwendung erfolgt im System mit Maschinenputz MP 75 L oder MP 75 Diamant auf Deckenflächen aus Beton, die ein Verputzen nach Merkblatt
„Gipsputze und gipshaltige Putze auf Beton“ nicht zulassen. Mechanische Befestigung im Untergrund mit Hilfe eines Bolzenschubgerätes unter Verwendung eines Stahlnagels.
Details finden Sie im techn. Blatt P631.de
Eigenschaften und Mehrwert
› Putzträgersystem für Gipsputz auf Beton
› Formstabil
› Schlagzäh
› PutzPin 8 = 11 – 16 mm Putzdicke
› PutzPin 18 = 21 – 28 mm Putzdicke

› Befestigung mit Bolzenschubgerät

Quarzgrund Pro ist ein schnelltrocknender und gebrauchsfertiger Haftgrund als Voranstrich mit Quarzzusatz auf trockene, staubfreie Unterputze und Armiermörtel, geglätteten Gipsputzflächen oder fest haftenden Dispersionsanstrichen, bevor dünnlagige Scheiben- oder Rillenputze aufgetragen werden.
Details finden Sie im techn. Blatt K457b.de
Eigenschaften und Mehrwert
› Für innen und außen
› Nach ca. 2 Stunden überarbeitbar
› Gebrauchsfertig
› Saugfähigkeitsregulierend
› Schafft griffige Untergründe
› Weiß pigmentiert
› Verarbeitung von Hand
› Annähernd tönbar nach Farbtonfächer Knauf ColorConcept
Diese Angaben sind Zirka-Werte und können je nach Art des Untergrundes abweichen.
Raumklima Grundierung ist ein hochdiffusionsoffener, schnelltrocknender und gebrauchsfertiger Haftgrund für Raumklima Scheibenputze, Raumklima Spritzputz und Oberputze im Innenbereich.
Details finden Sie im techn. Blatt K457c.de
Eigenschaften und Mehrwert
› Für den Innenbereich
› Nach ca. 2 Stunden überarbeitbar
› Hoch diffusionsoffen
› Gebrauchsfertig
› Saugfähigkeitsregulierend
› Schafft griffige Untergründe
› Frei von Lösemitteln, Weichmachern und fogging-aktiven
Substanzen
› Weiß pigmentiert
› Verarbeitung von Hand
› Annähernd tönbar nach Knauf Farbtonfächern
Diese Angaben sind Zirka-Werte und können je nach Art des Untergrundes abweichen.
Voranstrich mit Quarzsand als Absperrgrundierung auf Gipsplatten, fest haftenden Dispersionsanstrichen und mineralischen Untergründen, bei denen mit einer Verfärbung durch lösliche Bestandteile gerechnet werden muss. Bei starken Durchdringungen, wie z. B. durch Lignin, wird ein zweimaliger Anstrich notwendig. Aton Sperrgrund bildet eine Haftbrücke zwischen dem Putzgrund und dünnlagigen Oberputzen.
Details finden Sie im techn. Blatt K453a.de
Eigenschaften und Mehrwert
› Für innen und außen
› Gebrauchsfertig
› Absperrend gegen Lignin und Gilbstoffe
› Schafft griffige Oberfläche
› Weiß pigmentiert
› Verarbeitung mit Maschine oder von Hand
› Wässrige Emulsion mit Quarzsand


› Trocknet weiß aus
Diese Angaben sind Zirka-Werte und können je nach Art des Untergrundes abweichen.
Verarbeitungsfertige Sanierlösung zur Passivierung von Keimen an Flächen, die mit Algen, Moos und/ oder Pilzen befallen sind. Algizid kann auch vorbeugend unter Anstrichen eingesetzt werden. Biozidprodukte vorsichtig verwenden. Vor Gebrauch stets Etikett und Produktinformationen lesen.
Details finden Sie im techn. Blatt B101.de
Eigenschaften und Mehrwert
› Gebrauchsfertig
› Wässriges Biozidgemisch
› Gutes Eindringvermögen
› Zerstört Mikroorganismen
› Diffusionsoffen
› Verarbeitung von Hand
› Biologisch abbaubar

› Farblos
› Für außen
Diese Angaben sind Zirka-Werte und können je nach Art des Untergrundes abweichen.
Gips zählt zu den ältesten Baustoffen der Menschheit und kommt unserem wachsenden Bedürfnis nach Nachhaltigkeit entgegen. Im Innenbereich eingesetzt, schafft Gips durch seine hervorragenden baubiologischen Eigenschaften die idealen Voraussetzungen für ein ausgeglichenes und angenehmes Raumklima.
Alle Möglichkeiten der Oberflächengestaltung stehen Ihnen offen: Von edel anmutenden glatten Oberflächen bis hin zu ausdrucksstarken Filzputzstrukturen. Auch wenn die Fläche später gestrichen, tapeziert oder verfliest werden soll, bietet dieser moderne Baustoff in jedem Fall den idealen Untergrund.

Die ersten Gipslager enstanden bereits vor 100 bis 200 Millionen Jahren durch Verdunstung des Meerwassers in flachen Becken unserer Erdkruste. Chemisch betrachtet ist Gips Calciumsulfat, das in Verbindung mit Wasser kristallisiert.
Bereits 7.000 Jahre vor Christus war Gips ein beliebter Baustoff, der schon beim Bau der Türme von Jericho eine wichtige Rolle spielte. Diese Bedeutung hat Gips im Bauwesen bis heute beibehalten. Gipsputze sind universell einsetzbar. Ob im Neubau, Ausbau, bei der Sanierung oder für tragende Hochbaukonstruktionen – vom Keller bis zum Dach, in der Küche ebenso wie im Bad.
In enger Zusammenarbeit mit Naturschutzverbänden übernimmt Knauf Verantwortung
für die Umwelt. Stillgelegte Naturgipsabbauflächen werden behutsam zu wertvollen Biotopen für selten gewordene Pflanzenund Tierarten als ökologische Lebensräume renaturiert.

Damit Naturressourcen geschont werden, setzt Knauf neben Naturgips auch REA-Gips ein. REA-Gips entsteht gewissermaßen im Schnellverfahren als Nebenprodukt bei der Rauchgasentschwefelung von Kohlekraftwerken. Die chemische Formel für REA-Gips ist dieselbe wie für Naturgips, also CaSO4 × 2H2O. REA-Gips ist daher wie Naturgips ein gesundheitlich und baubiologisch hochwertiger, völlig unbedenklicher Baustoff von höchster Reinheit und Qualität.
Gips ist außerdem ein Recycling-Wunder. Nicht nur als Natur- oder REA-Gips, sondern auch als mineralischer Baustoff kann Gips beliebig oft zu Pulver gebrannt und mit Wasser angemacht werden. Er wird immer wieder abbinden. Gips umweltfreundlich zu recyclen und wieder zu verwenden ist also denkbar einfach.
Das Institut für Baubiologie in Rosenheim hat Knauf Gipsputze unter gesundheitlichen und baubiologischen Aspekten untersucht und bestätigt:
Knauf Gipsputze sind uneingeschränkt empfehlenswert!
Gipsputze zeichnen sich durch eine besonders gute Haftung am Untergrund aus. Beim Anspritzen oder Anwerfen des feinteiligen Gipsputzes entsteht ein Vakuumeffekt. Zusätzlich dringen der Gipsputz und das Anmachwasser in die Poren des Untergrundes ein.
Während der anschließend einsetzenden Dihydratbildung bilden sich in diesen Untergrundporen Kristallite, die wie unzählige kleine Anker wirken, mit denen sich der Putz im Untergrund dauerhaft verbindet. Dies bedeutet eine ideale Verzahnung mit hoher Haftung am Untergrund.
Knauf Gipsputze und Gips-Kalkputze werden nicht nur als Untergrund zur Aufnahme von Fliesen, Tapeten etc. eingesetzt, sondern weisen auch mit ihrer eigenen Oberfläche einen dekorativen Charakter auf. In geglätteter oder auch gefilzter Struktur können sie direkt mit Anstrichen farblich gestaltet werden. Aber auch freie Strukturen, wie Kellenstrich oder Kellenschlag, Pinselstrich etc., sind möglich.
Mit steigender Putzdicke erhöht sich die Austrocknungszeit exponentiell. Eine 4 cm dicke Putzschicht benötigt ca. dreimal so lange wie eine 2 cm dicke Putzschicht.
Das Trocknungsschwinden von Gipsputzen ist sehr gering und wird zudem durch einen Quellprozess im Abbindevorgang überlagert. Dadurch sind Gipsputze im Allgemeinen raumneutral, d. h. Gipsputze werden ohne maßgebliche Volumenveränderungen fest. Korrespondierend zur Abbindecharakteristik trocknen Gipsputze außerordentlich spannungsarm aus.
Einlagiges Ausgleichen größerer Unebenheiten
Gipsputze können auch bei größeren Unebenheiten der Wand, wie sie im Bestand anzutreffen sind, schnell und kostengünstig einlagig bis 35 mm aufgetragen werden.
Rundum behaglich
Gipshaltige Putze sind oberflächenwarm, klimaregulierend und diffusionsoffen. „Kalte“ Betonoberflächen werden mit Gipsputzen raumklimatisch aufgewertet.
Bei gleichen Oberflächen- und Raumtemperaturen von 18 °C bis 20 °C werden verputzte Oberflächen als wärmer und behaglicher empfunden – somit kann auch gleichzeitig Energie gespart werden.

Wandoberflächen mit Gipsputz fühlen sich warm an, da Gipsputz wegen der geringen Wärmeleitfähigkeit Wärmeverluste reduziert.

Bei zweilagiger Ausführung wird durch das vorhergehende Austrocknen der ersten Lage die Gesamtaustrocknungszeit reduziert.
Im Kristallgefüge des Gipses sind zwei Moleküle Wasser eingelagert. Bei Brandbelastung werden sie als Kühlwasser frei. Und bei Hitzeentwicklung bildet frei werdender Wasserdampf einen feuerhemmenden Dampfschleier.
Bei höheren Putzdicken zweilagig arbeiten, dabei die erste Lage auftragen und rau abziehen. Nach dem Aushärten und Austrocknen Aufbrennsperre (1:3 mit Wasser verdünnt) vorstreichen und trocknen lassen. Anschließend kann die zweite Putzlage bis zur Gesamtputzdicke von 50 mm aufgetragen werden.
Maschinenputze sind speziell für das Anmischen und Auftragen mit der Maschine vorgesehene Werktrockenmörtel. Durch die verschiedenen Anteile von Gipsbinder, Kalkhydrat, Leicht- und Normalzuschlägen sowie Additiven entsteht ein Mörtel, mit dem sich vor allem große Flächen wirtschaftlich verputzen lassen.
Die Verarbeitung ist leichter und schneller als bei Handarbeit. Der Maschinenputzgips wird entweder als Sackware in die Putzmaschine eingefüllt oder aus einem Container kontinuierlich durch eine pneumatische Förderanlage automatisch in die Putzmaschine eingeblasen.
Maschinenputzklassiker wie die Produkte der Knauf MP 75 Familie zeichnen sich durch beste Verarbeitungseigenschaften aus. Auch wenn die Fläche im Anschluss gestrichen, tapeziert oder verfliest werden soll – Maschinenputze der Knauf MP 75 Familie bieten für jede Art der Weiterverarbeitung den idealen Untergrund.
Das Anmischen erfolgt durch intensives Mischen in der Putzmaschine. Die Wasserzugabe ist so zu regeln, dass die dünnste Konsistenz erreicht wird, die bei dem vorhandenen Untergrund und der vorgesehenen Auftragsdicke eine einwandfreie Verarbeitung zulässt. Der geschmeidige Gipsbrei lässt sich gut zum Spritzkopf fördern und ergibt einen gleichmäßigen, leicht zu verteilenden und gut „stehenden“ Putzauftrag.
Maschineller Putzauftrag
Maschinenputze werden in der Regel einlagig in Schichtdicken von 10 mm bis 35 mm angetragen. In Ausnahmefällen sind Schichtdicken bis 50 mm möglich. Der Maschinenputzgips wird durch die im Spritzkopf zugeführte Druckluft gleichmäßig und in gewünschter Dicke auf den Putzgrund gespritzt. Durch den Anspritzdruck wird eine verbesserte Haftung erzielt, da der Gips gut in Fugen und Vertiefungen eindringt.
Verteilen
Nach dem Anspritzen wird der Putzmörtel mit der Kartätsche lot- und flutrecht verteilt. Mit beginnender Versteifung wird die Putzfläche ggf. mit der Kartätsche oder dem Flächenspachtel abgezogen, um Unebenheiten zu entfernen. Sollen als Endbeschichtung ein Oberputz oder Fliesen angebracht werden, darf die Oberfläche nur abgezogen werden.
Oberfläche gestalten (filzen)
Ist der Putz ausreichend versteift, wird er leicht angenässt und mit der Schwammscheibe oder maschinellen Filzgeräten gefilzt.
Oberfläche gestalten (glätten)
Noch vor dem endgültigen Austrocknen sorgfältig mit der Traufel oder Flächenspachtel glätten und dabei die Schlämme abziehen. Dabei werden die Poren und evtl. noch vorhandene kleine Fehlstellen des Putzes geschlossen.
Knauf Trenn-Fix


Zur Trennung von Putzflächen Knauf TrennFix mit selbstklebendem Haftbereich an die nicht zu verputzenden Bauteile kleben und dagegen putzen. Nach Aushärten des Putzes den überstehenden Trenn-Fix-Streifen abschneiden.




Knötchenbildung kann auf einen verschlissenen Mischwendel oder eine schlechte Benetzung des Putzes hinweisen. Es empfiehlt sich daher, den Mischwendel auszuwechseln bzw. einen Leichtputzwendel einzusetzen.
Zu kurze Abbindezeiten können unter Umständen auch von Maschinenproblemen herrühren, z. B.:
› Unsaubere Schläuche oder Maschinen
› Wasserschlauch liegt in der Sonne
› Zu dicke Konsistenz
› Verschmutztes Wasser
Konsistenzschwankungen
können viele Ursachen haben:
› Verbrauchte Schneckenpumpe (Rotor/Stator)
› Spannschelle nicht gleichmäßig angezogen/defekt (oval)
› Verschlissener oder defekter Mischwendel
› Druckminderventil falsch eingestellt, defekt oder verschmutzt
› Nicht ausreichender Wasserdruck oder Menge (3/4‘‘-Anschluss wählen)
› Zu langes oder zu schwaches Stromkabel (Spannungsverlust)
› Bei wartungsfreien Schneckenmänteln
Mörtelschlauch zu lang
› Schlechtes Nachrutschen des Materials in die Mischzone

› Zu große Förderhöhe oder -weite
Sauberes Ausarbeiten der Ecken gelingt besonders gut mit der Verwendung eines Eckspachtels oder eines Eckhobels
Maschinenputzgips zeichnet sich durch einen gleichmäßigen, gezielten Versteifungsverlauf aus, der eine praxisgerechte Verarbeitungszeit von ca. drei Stunden gewährleistet. Dies ermöglicht einen rationellen und großflächigen Putzauftrag. Da der Maschinenputzgips lange plastisch bleibt, sind Arbeitsunterbrechungen bis zu 15 Minuten möglich. Nach Beendigung des Anspritzens müssen Maschine, Schläuche und Spritzkopf sorgfältig gereinigt werden
Bei einlagigen Innenputzen aus Werktrockenmörtel ist eine mittlere Putzdicke von 10 mm (zulässige Mindestputzdicke 5 mm) ausreichend, soweit keine anderen Angaben zum Produkt gemacht werden. Die jeweils zulässige Mindestputzdicke muss sich auf einzelne Stellen beschränken und darf auch über Stegleitungen nicht unterschritten werden. Bei metallischen Putzträgern und Holzwolle-Leichtbauplatten beträgt die Mindestputzdicke
Renovieren und Bauen im Bestand zählt zu den anspruchsvollsten Herausforderungen. Die Umgestaltung von beschädigtem Mauerwerk, unschönen Oberflächen oder Altputzen erfordert häufig Handarbeit mit gipshaltigen, mineralischen Putzen. Die Produktfamilie der Knauf Handputze wie z. B. Rotband, Rotband Pro oder Goldband bieten die nötige Flexibilität, wenn unterschiedliche Putzdicken oder verkürzte Abbindezeiten erforderlich sind.

Spezielle Haftzusätze schaffen auch bei schwierigsten Untergründen ideale Arbeitsbedingungen.


Schimmel und andere Mikroorganismen, häufig Ursache für gesundheitliche Beschwerden und Auslöser von Allergien, haben bei MP 75 L Raumklima und Raumklima Beschichtungen keine Chance. Durch die hohe Feuchteaufnahme der Aktivkohle bleibt die Oberfläche trocken und wird mikrobiellem Wachstum auf ganz natürliche Weise die Lebensgrundlage entzogen.
Anmachen
Einen Sack Handputz mit sauberem Wasser ohne weitere Zusätze mit einem Rührquirl auf verarbeitungsgerechte Konsistenz anmischen.

Putzauftrag
Nach dem Anmischen wird der Mörtel mit der Kelle angeworfen oder mit dem Aufziehbrett aufgezogen, wobei ein kräftiges Andrücken an den Putzgrund für die vollflächige Haftung erforderlich ist
Verteilen
Anschließend wird der Putzmörtel mit der Abziehlatte oder der Kartätsche eingeebnet und lot- und fluchtgerecht verteilt.
Annässen
Für die Herstellung einer geglätteten Oberfläche wird der Putz bei ausreichender Versteifung (matt werden) leicht angenässt.
Oberfläche gestalten (filzen)
Anschließend wird die Oberfläche mit der Filzscheibe durchgeschwämmt. Sollen als Endbeschichtung ein Reibeputz oder Keramikfliesen angebracht werden, darf die Oberfläche nur abgezogen werden.
Oberfläche gestalten (glätten)
Mit beginnender Versteifung wird die Putzfläche ggf. mit der Kartätsche oder dem Flächenspachtel abgezogen. Dabei werden die Poren und evtl. noch vorhandene kleine Fehlstellen des Putzes geschlossen


Haftputzgips Rotband –die Lösung für glatte Untergründe Haftputzgips wird zum manuellen Auftragen einlagiger Innenputze auf Betonflächen verwendet. Durch entsprechende Zusätze, Stellmittel und Füllstoffe wird die Haftung erheblich verbessert. Knauf Rotband ist besonders für Betondecken und Wandflächen sowie Betonfertigteile geeignet.
Fertigputzgips Goldband – die richtige Antwort für jeden Untergrund Fertigputzgips wird im Gegensatz zum Haftputzgips für einlagige Innenputze auf Mauerwerksuntergründen aller Art verwendet. Zusätze, Stellmittel und Füllstoffe ermöglichen eine gute Haftung zum Untergrund. Der Fertigputzgips Knauf Goldband schafft ideale Arbeitsbedingungen auch bei schwierigsten Untergründen.
Stuckgips und Modellgips –für feinste Handwerkskunst
Bei der Renovierung alter Bausubstanz, insbesondere in der Denkmalpflege, wird vielfach ein Stuckgips mit hohem Weißgrad und Mahlfeinheit gefordert. Knauf Rocaso ist optimal abgestimmt auf die Herstellung von Stuckleisten und Ornamenten, aber auch zur Formenherstellung in der keramischen Industrie.

Rotband Pro
Modernisieren bekommt eine neue Perspektive: Die besonders feine Körnung von Rotband Pro macht diesen Haftputz enorm flexibel. Er meistert jede erdenkliche Art von Untergrund – egal ob Beton, Gipsputz, Kalkzementputz, Mauerwerk, Styropor oder fast alle fest haftenden Kunstharzputze und Dispersionsanstriche.
Gerade bei Modernisierungsarbeiten, wo unterschiedliche Putzdicken zu meistern sind, ist Rotband Pro unschlagbar. Er ist geschmeidig, lässt sich leicht verarbeiten und überzeugt mit hoher Standfestigkeit. Gilt es größere Flächen zu verputzen, ist Rotband Pro selbstverständlich maschinengängig –am besten mit der leichten und handlichen Mischpumpe PFT RITMO.
Gips-Trockenmörtel für die Handverarbeitung haben eine Verarbeitungszeit zwischen 60 und 100 Minuten und sind grundsätzlich auf eine praxisgerechte Verarbeitungszeit eingestellt.
Genaue Angaben zu den einzelnen Produkten entnehmen Sie bitte unseren technischen Blättern unter www.knauf.de/dokumentencenter
Veränderungen in der Bauweise, exakt dimensionierte, mit Dünnbettmörtel verklebte planebene Steine oder ebene Betonfertigteile verlangen keine dicke, Unebenheiten ausgleichende Putzschicht mehr. In manchen Fällen dienen sie schlicht der Perfektion einer schon nahezu perfekten Vorarbeit. Diese dünnschichtig aufzubringenden Putze (Schichtdicken ab 2 mm) werden als Dünnlagenputze bezeichnet.
Kann das Material auch auf Null ausgezogen werden, spricht man von Spachtelmassen oder Spachtelputzen.
Spachtelputze sind insbesondere zum Verspachteln von rauen und unebenen Untergründen, zum Schließen von BetonFertigteilfugen, Schlitzen und Löchern, zum dünnen Verputzen von ebenen Untergründen wie Betonflächen, Gipsplatten und vorhandenen Putzen geeignet.


Anmachen
Bei manueller Verarbeitung den Sackinhalt unter Zugabe von Wasser mit dem Mischquirl anrühren und manuell aufziehen. Bei maschineller Verarbeitung wird der Dünnlagenputz als Sackware in die Putzmaschine eingefüllt. Die Wasserzugabe ist so zu regeln, dass die dünnste Konsistenz erreicht wird, die bei dem vorhandenen Untergrund eine einwandfreie Verarbeitung zulässt.
Schließen von Fugen
Zum Schließen der Fugen von Beton-Fertigteildecken ist der Spachtelputz quer zur Fuge nach beiden Seiten einzudrücken, sodass beidseitig eine gute Fugenflankenhaftung entsteht.
Glätten von Fugen
Anschließend wird die Fuge unter Ausbildung eines Wulstes längs überglättet. Mit beginnendem Versteifen wird das überstehende Material abgestoßen und sofort nachgeglättet. Ist ein Höhenausgleich erforderlich, wird der Spachtelputz in einem zweiten Arbeitsgang aufgezogen und beigespachtelt.

Die bauteilbedingte Rissneigung bei Fertigteilelementen kann durch Einlegen eines Fugenarmierungsstreifens (z. B. Knauf Kurt) reduziert, jedoch auch in diesem Fall nicht völlig ausgeschlossen werden.

Bei maschineller Verarbeitung von Dünnlagenputzen sind Pumpen mit einstellbarer Förderleistung und andere geringfügige Modifikationen erforderlich. Der weichplastische Gipsbrei lässt sich gut zum Spritzkopf fördern und ergibt einen gleichmäßigen Putzauftrag.
Für den großflächigen Einsatz als Dünnputz ist der Gips-Maschinenspachtel MultiFinish M Pro die richtige Wahl. Der feinteilige, kunststoffmodifizierte Gipsspachtel hat alle Vorteile von Knauf Multi-Finish, wird aber in der Regel maschinell aufgetragen.


Knauf Multi-Finish M Pro lässt sich von Hand oder besonders schnell und wirtschaftlich mit den bewährten Verputzmaschinen PFT G 4 oder PFT RITMO verarbeiten. Der geschmeidige Gips-Maschinen-Dünnputz lässt sich äußerst leicht, sicher und wirtschaftlich auftragen und verteilen. Gerade auf großen Flächen lässt sich mit diesem Material Zeit gutmachen.


Aufgrund der speziellen Zuschlagstoffe können auch größere Unebenheiten im Untergund mühelos in einem Arbeitsgang ausgeglichen werden. Mit Multi-Finish M Pro können Schichtstärken von 2 mm bis 8 mm realisiert werden – dadurch ist er auch für Modernisierungsarbeiten prädestiniert.
Ob dünnes vollflächiges Verputzen von ebenen Betonflächen, Gipsplatten oder Putzen – für Multi-Finish M Pro kein Problem. Die besonders feine Körnung und die hohe Standfestigkeit sorgen für optimale Arbeitsabläufe im Alt- und Neubau.
Dekorative Oberflächen
Multi-Finish M Pro eignet sich hervorragend zur Herstellung von Oberflächen der Qualitätsstufe Q3 geglättet und zur Erstellung hochwertiger dekorativer Oberflächengestaltungen im Innenbereich.
Generationenwechsel
Die legendäre PFTG4 gilt bis zum heutigen Tag bei Fachleuten als „die“ Verputzmaschine schlechthin. Mit der neuen PFTG4 neXt generation kommt nun die Mischpumpe der nächsten Generation. Optimierungen und praktische Details machen die Beste nun noch besser.
Auch im Silo erhältlich
Bei größeren Baustellen ist der Einsatz von Sackware nicht rentabel. Dafür bietet Knauf die Anlieferung im Silo an. Damit kann die jeweils gewünschte Menge Putz immer frisch angemischt werden. Es enfällt Verpackungsmüll, ergonomisches Arbeiten wird einfacher. Der Putz ist vor dem Verwittern und vor Diebstählen geschützt und seine Qualität bleibt über einen längeren Zeitraum gleich.
› Besonders einfache und rationelle Verarbeitung mit den bewährten Verputzmaschinen PFT G 4 oder PFT RITMO
› Auftragsdicke 2 mm bis 8 mm
› Durch die hohe Füllkraft können kleinere Unebenheiten des Untergrundes in nur einem Arbeitsgang ausgeglichen werden
› Geeignet für Oberflächenqualität Q3 geglättet
Erfahren Sie mehr!
Ausführliche Informationen rund um
Gipsputze finden Sie in unserer Knauf Gipsputz-Kompetenz-Broschüre „P10“. www.knauf.de/gipsputzkompetenz
Der Gipsputz MP 75 L Fire stellt den Brandschutz z. B. in Flughäfen, Hoch- und Krankenhäusern, Parkhäusern, Einkaufszentren oder Supermärkten sicher. Die Beschichtung schützt im Brandfall auf einfache Weise alle Konstruktionselemente aus Stahl und Stahlbeton und hält deren Funktion aufrecht.
Das Material ist schnell und einfach zu verarbeiten. Zudem zeichnet es sich durch geringe Schichtdicken und eine besonders komfortable Verarbeitung aus. MP 75 L Fire ertüchtigt konstruktive Bauteile in Innenräumen und optimiert die Tragfähigkeit bis zur geforderten Feuerwiderstandsklasse.
Knauf MP 75 L Fire verbessert den Brandschutz von Stützen und Trägern aus Beton, von Betondecken und -wänden sowie von Trapezblechdecken mit Aufbeton. Selbst Stahl kann direkt verputzt werden. Bereits ab 11mm Dicke kann mit MP 75 L Fire auf Stahlträgern und Stützen eine Feuerwiderstandsklasse von 90 Minuten erreicht werden. Und das direkt auf dem rostgeschützten Stahlträger –ohne Putzträger oder Haftvermittler!


Verarbeitung
Stahl und profilierte Bleche unbeschichtet Auf Rost überprüfen und gegebenenfalls entfernen. Stahlprofile anschließend mit einem Rostschutzanstrich auf Basis von Epoxidharz, Alkyd oder Zinksilikat entsprechend der Herstellerangaben behandeln.
Stahl und profilierte Bleche mit bestehender Beschichtung Fest haftende Beschichtungen auf Basis von Alkyd, Epoxyd, Zinksilikat oder auf Basis einer Verzinkung sind als Untergrund für MP 75 L Fire geeignet. Andere Alt-Beschichtungen entfernen. Bei fest haftenden Beschichtungen, die nicht entfernt werden können, einen nicht brennbaren Putzträger einsetzen.
Beton unbeschichtet
Filmbildende Schalungstrennmittel, vorhandene Sinterhaut und sonstige Verunreinigungen sind mit geeigneten Mitteln zu entfernen. Siehe auch Broschüre P10.de (Teil: Untergrundprüfung).
Beton mit bestehender Beschichtung
Alt-Beschichtungen entfernen. Bei fest haftenden Alt-Beschichtungen, die nicht entfernt werden können, einen nicht brennbaren Putzträger einsetzen.
Maschinell mit PFT G 4

› Verarbeitungskonsistenz durch Wasserdosierung auf 1,3 bar/Meter Mörtelschlauch einstellen
› Je nach Auftragsdicke und zu ertüchtigenden Flächen mit Schneckenmantel D4-3 oder D6-3
› Nassmörtelförderweite 25 m
› Mindestauftragsdicke 6 mm; max. Schichtdicke 40 mm
Für Planer ist der neue MP 75 L Fire die günstige Lösung für die Brandschutzertüchtigung. Fachhandwerker profitieren von der einfachen Verarbeitung mit den gewohnten Putzmaschinen – zum Beispiel der Mischpumpe PFT G 4 – sowie von der Einsparung des Putzträgers bzw. des Spritzbewurfs. Damit stellt der MP 75 L Fire seine Wirtschaftlichkeit unter Beweis, erhöht die Wertschöpfung im Betrieb und profiliert den Fachunternehmer als Profi für Brandschutzbekleidungen. Der MP 75 L Fire ist deutlich wirtschaftlicher als vergleichbare Produkte.
Feuerwiderstandsklasse R 90 erreicht!
Im untenstehenden Beispiel mit einer Stahlkonstruktion U/A Wert 180 – 300 Kritische Stahltemperatur 500 °C.
23 mm Putz
Aufwand gespart: 60 %
25 mm Putzschicht
10 mm Durchdringung der Putzträger
Montage der Putzträger
MP 75 L Fire im Überblick
› Einfache Brandschutzertüchtigung von Beton- und Stahlkonstruktionen im Innenbereich
› Kann ohne zusätzliche Maßnahmen direkt auf das Bauteil aufgebracht werden
› MP 75 L Fire unterliegt einer ständigen Prüfung und Überwachung (Europäische Technische Zulassung ETA-11/0229)
› Deutlich ergiebiger als vergleichbare Produkte
› Offene Zeit je nach Putzuntergrund 180 – 300 Minuten
› Schnell und einfach zu verarbeiten
Erfahren Sie mehr!
Ausführliche Informationen können dem technischen Blatt und der Planungshilfe unter www.knauf.de/mp75lfire entnommen werden.


Vorbehandlungen
Gipsputze
Spachtel pastös
Kalkputze
Unterputze
Oberputze
Sanierung
Dämmschüttungen
Innendämmung
WARM-WAND Dämmstoffe
WARM-WAND Klebe- und Armiermörtel
WARM-WAND Zubehör
AQUAPANEL® VHF
Gestaltungselemente
Farben
Gipsputze
Maschinenputze
Handputze
Dünn- und Spachtelputze
Ergänzungsprodukte
MP 75 L Fire ist ein Gipsputz mit erhöhtem Anteil von Leichtzuschlägen für den passiven Brandschutz von konstruktiven Bauteilen im Innenbereich. Durch die vorbeugende Bekleidung mit MP 75 L Fire wird die Stabilität und Tragfähigkeit dieser Bauteile im Brandfall deutlich verlängert.
MP 75 L Fire ist optimal geeignet für den passiven Brandschutz in industriellen Bereichen, Flughäfen, Hochhäusern, Krankenhäusern, Parkplätzen, Einkaufszentren oder Supermärkten.
Details finden Sie im techn. Blatt P911.de
Eigenschaften und Mehrwert
› Feuerwiderstand für Betondecken und -wände bis REI 240, für Betonstützen und -träger bis R 180, für profilierte Bleche mit Beton bis REI 120
› Verarbeitung mit Maschine
› Hohe Ergiebigkeit
› Auf Gipsbasis
› Für den Innenbereich
› Farbe: weiß
Diese Angaben sind Zirka-Werte und können je nach Art des Untergrundes abweichen.
MP 75 L Raumklima nimmt durch den Zusatz von Aktivkohle überdurchschnittlich viel Luftfeuchtigkeit auf und gibt diese bei Bedarf wieder ab. Das reduziert das Schimmelrisiko wirksam und trägt zu einem angenehmen Raumklima bei. MP 75 L Raumklima entnimmt VOCs aus der Raumluft und baut zudem Gerüche und Formaldehyd wirksam ab.
Egal ob der geglättete MP 75 L Raumklima nur mit Farbe gestrichen werden soll oder ein Oberputz gewünscht ist: Die perfekte diffusionsoffene Beschichtung erfolgt mit Knauf Raumklima-Produkten.
Details finden Sie im techn. Blatt P116b.de
Eigenschaften und Mehrwert
› Gips-Putztrockenmörtel für Innenanwendungen


› Erhöhte Feuchteaufnahme
› Mit Aktivkohle
› Schafft behagliches und wohngesundes Raumklima
› Diffusionsoffen
› Brandschutztechnisch wirksam
› Verarbeitung mit Maschine oder von Hand
› Baut Gerüche und Formaldehyd aus der Raumluft ab
MP 75 Diamant ist ein vorgemischter Trockenmörtel auf bewährter Gips-Basis mit einer erhöhten Oberflächenhärte und Druckfestigkeit für besonders beanspruchte Oberflächen wie z. B. in öffentlichen Gebäuden, Schulen oder Treppenhäusern. Das Mauerwerk ist generell mit Knauf Aufbrennsperre vorzubehandeln. Bei schwierigen Putzuntergründen, wie Beton, kommen Haftbrücken, wie Knauf Betokontakt oder Spraykontakt, zum Einsatz. Bei Verwendung im Deckenbereich sind weitere Maßnahmen, wie der Einsatz von Knauf PutzPin, nötig. Einsetzbar in allen Räumen mit üblicher Luftfeuchtigkeit einschließlich häuslicher Feuchträume wie Küchen und Bädern.
Details finden Sie im techn. Blatt P111a.de
Eigenschaften und Mehrwert
› Gips-Putztrockenmörtel für Innenanwendungen


› Mineralisch
› Sehr hohe Wärmeleitfähigkeit
› Schafft behagliches und wohngesundes Raumklima
› Feuchtigkeitsregulierend und diffusionsoffen
› Brandschutztechnisch wirksam
› Abrieb- und nagelfest
› Auftragsdicke bis 50 mm
› Verarbeitung mit Maschine oder von Hand
Diese Angaben sind Zirka-Werte und können je nach Art des Untergrundes abweichen.
MP 75 L ist ein leichter und besonders ergiebiger, vorgemischter Trockenmörtel auf bewährter Gips-Basis mit speziellen Leichtzuschlagstoffen. Für Porenbeton, Kalksandsteine, Bims, Betonsteine, Mischmauerwerk oder porosierte Wandbausteine eignet sich MP 75 L ideal, weil er den spezifischen Eigenschaften hinsichtlich Saugfähigkeit und Beschaffenheit der Untergründe weitgehend entgegen kommt. Bei schwierigen Putzuntergründen wie Beton kommen Haftbrücken wie Knauf Betokontakt oder Knauf Spraykontakt, bei stark saugenden Untergründen Knauf Aufbrennsperre zum Einsatz. Einsetzbar in allen Räumen mit üblicher Luftfeuchtigkeit einschließlich häuslicher Feuchträume wie Küchen und Bädern.
Details finden Sie im techn. Blatt P113.de
Eigenschaften und Mehrwert
› Gipsleicht-Putztrockenmörtel für Innenanwendungen
› Mineralisch
› Leicht und ergiebig
› Schafft behagliches und wohngesundes Raumklima
› Feuchtigkeitsregulierend und diffusionsoffen
› Brandschutztechnisch wirksam
› Abrieb- und nagelfest
› Auftragsdicke bis 50 mm
› Verarbeitung mit Maschine oder von Hand
Diese Angaben sind Zirka-Werte und können je nach Art des Untergrundes abweichen.
MP 75 ist ein klassischer vorgemischter Trockenmörtel auf Gips-Basis, der einlagig als Innenwand- und Deckenputz verarbeitet wird. Auf putzfreundlichen Untergründen ohne Vorbehandlung, bei schwierigen Putzuntergründen wie Beton kommen Haftbrücken wie z. B. Knauf Betokontakt oder Knauf Spraykontakt, bei stark saugenden Untergründen Knauf Aufbrennsperre zum Einsatz.
Einsetzbar in allen Räumen mit üblicher Luftfeuchtigkeit einschließlich häuslicher Feuchträume wie Küchen und Bäder.
Details finden Sie im techn. Blatt P111.de
Eigenschaften und Mehrwert
› Gips-Putztrockenmörtel für Innenanwendungen
› Mineralisch
› Schafft behagliches und wohngesundes Raumklima
› Feuchtigkeitsregulierend und diffusionsoffen
› Brandschutztechnisch wirksam
› Abrieb- und nagelfest
› Auftragsdicke bis 50 mm
› Verarbeitung mit Maschine oder von Hand
› Geeignet zum Beschichten mit Farbe, Tapete usw.
Diese Angaben sind Zirka-Werte und können je nach Art des Untergrundes abweichen.
MP 75 CL ist ein leichter, vorgemischter Gips-Putztrockenmörtel auf bewährter Putzgips-Basis mit speziellen Leichtzuschlagstoffen für geglättete Oberflächen im Innenbereich.
Details finden Sie im techn. Blatt P113c.de
Eigenschaften und Mehrwert
› Gips-Putztrockenmörtel für Innenanwendungen

› Mineralisch
› Feuchtigkeitsregulierend und diffusionsoffen
› Leicht und ergiebig
› Schafft behagliches und wohngesundes Raumklima
› Brandschutztechnisch wirksam
› Abrieb- und nagelfest
› Auftragsdicke bis 50 mm
› Verarbeitung mit Maschine oder von Hand
Diese Angaben sind Zirka-Werte und können je nach Art des Untergrundes abweichen.

MP 75 G/F-Leicht ist ein universell einsetzbarer Trockenmörtel auf Gips-Kalk-Basis. Durch den speziellen Kornaufbau ist sowohl eine Glätt- als auch Filzstruktur möglich. Einlagig als Innenwand- und Deckenputz auf putzfreundlichen Untergründen. Bei schwierigen Putzuntergründen wie Beton kommen Haftbrücken wie z. B. Knauf Betokontakt oder Knauf Spraykontakt, bei stark saugenden Untergründen Knauf Aufbrennsperre zum Einsatz.
Einsetzbar in allen Räumen mit üblicher Luftfeuchtigkeit einschließlich häuslicher Feuchträume wie Küchen und Bädern.
Details finden Sie im techn. Blatt P118.de
Eigenschaften und Mehrwert
› Gips-Kalk-Putztrockenmörtel für innen
› Mineralisch
› Leicht und ergiebig
› Glätt-/filzbar, Körnung 1,2 mm
› Schafft behagliches und wohngesundes Raumklima
› Feuchtigkeitsregulierend und diffusionsoffen
› Abrieb- und nagelfest
› Auftragsdicke bis 50 mm
› Verarbeitung mit Maschine oder von Hand
Diese Angaben sind Zirka-Werte und können je nach Art des Untergrundes abweichen.
MP 75 L-F ist ein leicht filzbarer Trockenmörtel auf Gips-Kalk-Basis für Wände und Decken. Bei schwierigen Putzuntergründen wie Beton kommen Haftbrücken wie z. B. Knauf Betokontakt oder Knauf Spraykontakt, bei stark saugenden Untergründen Knauf Aufbrennsperre zum Einsatz. Einsetzbar in allen Räumen mit üblicher Luftfeuchtigkeit einschließlich häuslicher Feuchträume wie Küchen und Bädern.
Details finden Sie im techn. Blatt P114.de
Eigenschaften und Mehrwert
› Gips-Putztrockenmörtel für Innenanwendungen

› Mineralisch
› Leicht und ergiebig
› Körnung 1,2 mm für gefilzte Oberflächen
› Schafft behagliches und wohngesundes Raumklima
› Feuchtigkeitsregulierend und diffusionsoffen
› Abrieb- und nagelfest
› Auftragsdicke bis 50 mm
› Verarbeitung mit Maschine oder von Hand
Diese Angaben sind Zirka-Werte und können je nach Art des Untergrundes abweichen.

MP 75 F ist ein vorgemischter Trockenmörtel auf Gips-Kalk-Basis zum Filzen. Der Gipsputz wird einlagig als Innenwand und Deckenputz verarbeitet. Auf putzfreundlichen Untergründen ohne Vorbehandlung, bei schwierigen Putzuntergründen wie Beton kommen Haftbrücken wie z. B. Knauf Betokontakt oder Knauf Spraykontakt, bei stark saugenden Untergründen Knauf Aufbrennsperre zum Einsatz. Einsetzbar in allen Räumen mit üblicher Luftfeuchtigkeit einschließlich häuslicher Feuchträume wie Küchen und Bädern.
Details finden Sie im techn. Blatt P112.de
Eigenschaften und Mehrwert
› Gips-Putztrockenmörtel für Innenanwendungen
› Mineralisch
› Körnung 1,2 mm für gefilzte Oberflächen
› Schafft behagliches und wohngesundes Raumklima
› Feuchtigkeitsregulierend und diffusionsoffen
› Abrieb- und nagelfest
› Auftragsdicke bis 50 mm
› Verarbeitung mit Maschine oder von Hand
› Geeignet zum Beschichten mit Farbe, Tapete usw.
Diese Angaben sind Zirka-Werte und können je nach Art des Untergrundes abweichen.
MP 75 F Edelfilz ist ein vorgemischter Trockenmörtel auf Gips-Kalk-Basis für gefilzte Oberflächen mit feinem Filzbild im Innenbereich. Der Gipsputz wird einlagig als Innenwand und Deckenputz verarbeitet. Bei Putzuntergründen wie Beton kommen Haftbrücken wie z.B. Knauf Betokontakt oder Knauf Spraykontakt, bei stark saugenden Untergründen Knauf Aufbrennsperre zum Einsatz. Einsetzbar in allen Räumen mit üblicher Luftfeuchtigkeit einschließlich häuslicher Feuchträ ume wie Küchen und Bädern.
Details finden Sie im techn. Blatt P112E.de
Eigenschaften und Mehrwert
› Gips-Putztrockenmörtel für Innenanwendungen


› Mineralisch
› Körnung 0,6 mm
› Schafft behagliches und wohngesundes Raumklima
› Feuchtigkeitsregulierend und diffusionsoffen
› Abrieb- und nagelfest
› Auftragsdicke bis 50 mm
› Verarbeitung mit Maschine oder von Hand
Diese Angaben sind Zirka-Werte und können je nach Art des Untergrundes abweichen.
MP 75 GP ist ein einlagig zu verarbeitender Grundputz (abgezogene Oberfläche) auf Kalk-Gips-Basis als Innenwand- und Deckenputz auf putzfreundlichen Untergründen. Bei schwierigen Putzuntergründen wie Beton kommen Haftbrücken wie z. B. Knauf Betokontakt oder Knauf Spraykontakt, bei stark saugenden Untergründen Knauf Aufbrennsperre zum Einsatz. Für geglättete Oberflächen muss MP 75 GP in einer zweiten Lage mit Knauf Putzglätte überzogen werden. Einsetzbar in allen Räumen mit üblicher Luftfeuchtigkeit einschließlich häuslicher Feuchträume wie Küchen und Bädern.
Details finden Sie im techn. Blatt P163.de
Eigenschaften und Mehrwert
› Mineralisch
› Schafft behagliches und wohngesundes Raumklima
› Feuchtigkeitsregulierend und diffusionsoffen
› Auftragsdicke bis 50 mm
› Verarbeitung mit Maschine oder von Hand
› Kalk-Gips-Grundputz


› Grundputz für Knauf Putzglätte
› Abrieb- und nagelfest
Diese Angaben sind Zirka-Werte und können je nach Art des Untergrundes abweichen.
Maschinenputzgips MP 75 LL ist ein leichter und besonders ergiebiger vorgemischter Gips-Trockenmörtel mit speziellen Leichtzuschlagstoffen mit längerer Abbindezeit, für geglättete Oberflächen im Innenbereich.
Details finden Sie im techn. Blatt P113L.de
Eigenschaften und Mehrwert
› Gips-Trockenmörtel für Innenanwendungen
› Mineralisch
› Leicht und ergiebig
› Für Innen
› Schafft behagliches und wohngesundes Raumklima
› Feuchtigkeitsregulierend und diffusionsoffen
› Verarbeitung mit Maschine
Maschinenputzgips MP 75 G-L ist ein leichter und besonders ergiebiger vorgemischter Gips-Trockenmörtel für geglättete Oberflächen im Innenbereich.
Details finden Sie im techn. Blatt P113G.de
Eigenschaften und Mehrwert
› Für Innen
› Mineralisch
› Leicht und ergiebig
› Feuchtigkeitsregulierend und diffusionsoffen
› Brandschutztechnisch wirksam
› Verarbeitbar mit Maschine
Diese Angaben sind Zirka-Werte und können je nach Art des Untergrundes abweichen.

Knauf Rotband Pro ist ein maschinengängiger Gips-Haftputz mit speziellen Leichtzuschlagstoffen. Aufgrund von Haftzusätzen besonders geeignet für Renovierungsarbeiten auf Betondecken- und Wandflächen sowie Betonfertigteilen und allen üblichen Putzgründen.

Einsetzbar in allen Räumen mit üblicher Luftfeuchtigkeit einschließlich häuslicher Küchen und Bäder.
Details finden Sie im techn. Blatt P121a.de
Eigenschaften und Mehrwert
› B4/20/2 nach DIN EN 13279-1
› Für den Innenbereich
› Verarbeitung mit Maschine oder von Hand
› Brandschutztechnisch wirksam
› Mineralisch
› Besonders leicht und ergiebig
› Feuchtigkeitsregulierend und diffusionsoffen
› Besonders geeignet zum Anputzen an alte Putzflächen
› Oberfläche strukturierbar oder geglättet
Diese Angaben sind Zirka-Werte und können je nach Art des Untergrundes abweichen.
Rotband Haftputzgips ist ein Gipsputz mit speziellen Leichtzuschlagstoffen. Aufgrund von Haftzusätzen besonders geeignet auf Betondecken und Wandflächen sowie Betonfertigteilen und allen üblichen Putzgründen.
Einsetzbar in allen Räumen mit üblicher Luftfeuchtigkeit einschließlich häuslicher Feuchträume wie Küchen und Bädern.
Details finden Sie im techn. Blatt P121.de
Eigenschaften und Mehrwert
› B4/20/2 nach DIN EN 13279-1
› Geeignet für Kleinflächen und Modernisierungsarbeiten
› Für den Innenbereich
› Verarbeitung von Hand
› Brandschutztechnisch wirksam
› Mineralisch
› Leicht und ergiebig
› Feuchtigkeitsregulierend und diffusionsoffen
› Oberfläche strukturierbar oder geglättet
Diese Angaben sind Zirka-Werte und können je nach Art des Untergrundes abweichen.


Rotband Haftputzgips ist ein Gipsputz mit speziellen Leichtzuschlagstoffen. Aufgrund von Haftzusätzen besonders geeignet auf Betondecken und Wandflächen sowie Betonfertigteilen und allen üblichen Putzgründen.
Einsetzbar in allen Räumen mit üblicher Luftfeuchtigkeit einschließlich häuslicher Feuchträume wie Küchen und Bädern.
Details finden Sie im techn. Blatt P121b.de
Eigenschaften und Mehrwert
› C4/20/2 nach DIN EN 13279-1
› Oberfläche gefilzt
› Für den Innenbereich
› Verarbeitung von Hand
› Brandschutztechnisch wirksam
› Mineralisch
› Leicht und ergiebig
› Feuchtigkeitsregulierend und diffusionsoffen
› Geeignet für Kleinflächen und Modernisierungsarbeiten
› Körnung 1,2 mm
Diese Angaben sind Zirka-Werte und können je nach Art des Untergrundes abweichen.
HP 100 ist ein Handputz auf Gips-Basis für alle Putzuntergründe im Innenbereich. Besonders geeignet für Renovierungs- und Ausbesserungsarbeiten.

Einsetzbar in allen Räumen mit üblicher Luftfeuchtigkeit, einschließlich häuslicher Feuchträume wie Küchen und Bädern.
Details finden Sie im techn. Blatt P152.de
Eigenschaften und Mehrwert
› B4/20/2 nach DIN EN 13279-1
› Mineralisch
› Leicht und ergiebig
› Kurze Abbindezeit
› Schafft behagliches und wohngesundes Raumklima
› Feuchtigkeitsregulierend und diffusionsoffen
› Brandschutztechnisch wirksam
› Abrieb- und nagelfest
› Auftragsdicke bis 50 mm
› Verarbeitung von Hand
Diese Angaben sind Zirka-Werte und können je nach Art des Untergrundes abweichen.
Goldband ist ein Fertigputz auf Gips-Basis mit speziellen Leichtzuschlagstoffen als Innenputz für die einlagige Handverarbeitung auf allen rauen Putzgründen und aufgekämmten oder ausgehärteten festen Unterputzen.
Einsetzbar in allen Räumen mit üblicher Luftfeuchtigkeit, einschließlich häuslicher Feuchträume wie Küchen und Bädern.
Details finden Sie im techn. Blatt P131.de
Eigenschaften und Mehrwert
› B4/20/2 nach DIN EN 13279-1
› Besonders leicht und ergiebig
› Oberfläche strukturierbar oder geglättet
› Schafft behagliches und wohngesundes Raumklima
› Feuchtigkeitsregulierend und diffusionsoffen
› Brandschutztechnisch wirksam
› Abrieb- und nagelfest
› Auftragsdicke bis 50 mm
› Verarbeitung von Hand
Diese Angaben sind Zirka-Werte und können je nach Art des Untergrundes abweichen.

Knauf Multi-Finish Universal ist eine Spachtelmasse, Dünnputz und Füllspachtel auf Gips-Basis. Universell einzusetzen im Innenbereich, zum rationellen Verspachteln von (un)ebenen und rauen Flächen, zum Schließen von Beton-Fertigteilfugen und Löchern/ Schlitzen im Innenbereich. Multi-Finish Universal eignet sich hervorragend zum Herstellen von Oberflächen der Qualitätsstufe Q4 (geglättet) und Q1-Q4 im Trockenbau.


Details finden Sie im techn. Blatt P511c.de
Eigenschaften und Mehrwert
› Für Innen
› Hohe Risssicherheit
› Hoher Weißgrad
› Universell einsetzbar
› Sehr gutes Haftvermögen
› Hohes Füllvermögen
› Schnell trocknend
› Verarbeitung von Hand
› Diffusionsoffen
Diese Angaben sind Zirka-Werte und können je nach Art des Untergrundes abweichen.
Multi-Finish M Pro ist ein Maschinen-Dünnputz auf Gips-Basis und kann mit allen gängigen Putzmaschinen, wie z. B. der PFT G 4, verarbeitet werden. Einzusetzen ist Multi-Finish M Pro im Innenbereich zum rationellen, dünnlagigen Verputzen von ebenen und rauen Flächen sowie zum Schließen von Beton-Fertigteilfugen, Löchern und Schlitzen.
Multi-Finish M Pro eignet sich zum Herstellen von Oberflächen der Qualitätsstufe Q3 (geglättet).
Details finden Sie im techn. Blatt P511b.de
Eigenschaften und Mehrwert
› Für den Innenbereich
› Verarbeitung mit Maschine
› Universell einsetzbar
› Hohe Ergiebigkeit
› Auftragsdicke 2 bis 8 mm
› Schnelle Trocknung
› Mineralisch
Diese Angaben sind Zirka-Werte und können je nach Art des Untergrundes abweichen.
Knauf Multi-Finish ist eine Gips-Spachtelmasse und ein Dünnputz auf Gips-Basis. Einzusetzen ist MultiFinish im Innenbereich, zum rationellen Verspachteln von unebenen und rauen Flächen, zum Schließen von Beton-Fertigteilfugen, Löchern und Schlitzen. Multi-Finish eignet sich hervorragend zum Herstellen von Oberflächen der Qualitätsstufe Q4 (geglättet).


Details finden Sie im techn. Blatt P511.de
Eigenschaften und Mehrwert
› Gips-Flächenspachtel für Innenanwendungen
› Mineralisch
› Pulverförmig, anmachfertig
› Universell einsetzbar
› Hohe Ergiebigkeit
› Auf Null ausziehbar
› Schnelle Trocknung
› Verarbeitung von Hand
› C7/20/2 nach DIN EN 13279-1
Diese Angaben sind Zirka-Werte und können je nach Art des Untergrundes abweichen.
Putzglätte ist ein auf Gips-Basis aufgebautes, durch Zusätze auf seinen Anwendungsbereich abgestimmtes, pulverförmiges Spachtelmaterial.
Kann im Innenbereich zum Glätten von Grundputzen wie MP 75 GP eingesetzt werden.
Details finden Sie im techn. Blatt P513.de
Eigenschaften und Mehrwert
› Gips-Flächenspachtel für Innenanwendungen
› Mineralisch
› Pulverförmig, anmachfertig
› Gut füllend
› Hohe Ergiebigkeit
› Verarbeitung von Hand
› Gipsgebunden
› C7/20/2 nach DIN EN 13279-1
Diese Angaben sind Zirka-Werte und können je nach Art des Untergrundes abweichen.
Montagegips ist ein schnell erhärtender Baugips, der im Innenbereich für Ausbesserungsarbeiten, Installationsarbeiten und zum Setzen von Eckschutzleisten, Putzprofilen und Elektrodosen eingesetzt werden kann.
Details finden Sie im techn. Blatt P156.de
Eigenschaften und Mehrwert
› Hohe Festigkeit
› Gutes Haftvermögen
› Schnell erhärtend
› Abriebfest
› Feuerhemmend
› Verarbeitung von Hand
› Verarbeitungszeit ca. 8 Minuten
› Verbrauch abhängig vom Einsatzgebiet

Stuckgips ist ein schnell erhärtender Baugips, der im Innenbereich für Ausbesserungsarbeiten, Installationsarbeiten und zum Setzen von Eckschutzleisten, Putzprofilen und Elektrodosen eingesetzt werden kann.
Details finden Sie im techn. Blatt P155.de
Eigenschaften und Mehrwert
› Hohe Festigkeit
› Gutes Haftvermögen
› Schnell erhärtend
› Abriebfest
› Feuerhemmend
› Verarbeitung von Hand

› Verarbeitungszeit ca. 8 Minuten
› Verbrauch abhängig vom Einsatzgebiet

Rocaso Modellgips ist ein hochwertiger Gipsbinder aus selektiertem Rohstein für Zug- und Gießarbeiten im Stuckateurhandwerk, für künstlerische und denkmalpflegerische Arbeiten.
Einsetzbar auch im Hobby, Modell- und Formenbau, in der Sanitär- und Porzellanproduktion sowie in der keramischen und feinkeramischen Industrie.
Details finden Sie im techn. Blatt P158.de
Eigenschaften und Mehrwert
› Fertig gemischter Stuckgips mit feiner Körnung
› Hoher Weißgrad
› Hohe Stoß- und Druckfestigkeit
› Geringes Expansionsverhalten
› Leichte Ziehbarkeit bei Stuckleisten
› Verarbeitung von Hand
› Weißgrad > 79
› Verbrauch abhängig vom Einsatzgebiet
Spachtel pastös
Raufaser war gestern. Heute stehen glatte, beschichtete Flächen für moderne Innenraumgestaltung. Und Knauf Rotband pastös steht für optimale Verarbeitung und feine, leicht zu schleifende Oberflächen. Egal, ob Sie kleine oder große Flächen verspachteln, auf Beton oder Altuntergründen, maschinell oder von Hand arbeiten – holen Sie sich das passende, gebrauchsfertige Produkt einfach aus dem Eimer. „Direkt losarbeiten“ heißt die Devise. „Hervorragende Qualität“ das Ergebnis.

Immer öfter wird bei Neubauten Ortbeton und Fertigteilbeton eingesetzt. Das stellt Profis vor neue Fragen: Wie erzeugt man edle Wand- und Deckenoberflächen wirtschaftlich und in Top-Qualität? Unsere pastösen Spachtelprodukte auf Dispersionsbasis sind die logische Antwort darauf, denn sie passen ideal auch zu modernen Bauweisen aus Fertigteilbeton oder Planstein. Und schließlich steht die Marke Knauf Rotband für optimale Verarbeitung und exzellente Ergebnisse seit es Putz gibt.
Aber auch in der Renovierung haben die pastösen Spachtelmassen ihre Stärke. Ob punktuelles Ausbessern oder großflächiges Verspachteln: Die gebrauchsfertigen Knauf Spachtelmassen sind hervorragend zu verarbeiten. Rotband Reno und Reno M sind bestens für die Anwendung auf Altputz und Betonuntergründen im Neubau geeignet. Das M steht für die maschinengängige Variante – auch im praktischen Schlauchbeutel. Knauf Rotband Spachtel ist einfach aufzutragen, hat eine perfekte Rotband-Haftung, hohes Füllvermögen und eine kurze Trocknungszeit.
Verarbeitung Von Hand
Die Vorteile auf einen Blick
› Perfekte Rotband-Haftung auch auf schwierigen Untergründen und ohne Vorbehandlung*
› Ein Maximum an Füllvermögen und Standfestigkeit
Auftrag 0 – 3 mm pro Lage und gesamt bis 5 mm
› Sofort loslegen mit der Maschine (z. B. Swing Airless von Knauf PFT) oder von Hand (Reno), ohne Zugabe von Wasser


› Hoher Weißgrad und gute Schleifbarkeit für feine, ebene Oberflächen
› Schnell trocknend für eine zügige Weiterverarbeitung
*Der Untergrund muss trocken, tragfähig und frei von Staub oder losen Putzrückständen sein. Fliesen sind mit Spraykontakt vorzubereiten.
Einsatzbereich
Für Bestandsuntergründe und Beton
Maschinell – zum Beispiel mit den Airless Spritzmaschinen von Knauf PFT
Renovierungs- und Ausbesserungsarbeiten auf ebenen Bestandsuntergründen wie Altputz (Rillen-, Scheiben- und Kalk-/Zementunterputz), Fliesen und Plansteinmauerwerk sowie ebene Betonuntergründe
Oberfläche Geschliffen/geglättet
Auftragsdicke 0 – 3 mm pro Lage/mehrlagig bis 5 mm
Pastöse Spachtelmasse
Produktgebinde
Eimer 20 kg
Pastöse Spachtelmasse
Eimer 20 kg /Schlauchbeutel 20 kg
›
› Kein Grundieren: aufbringen, verziehen – fertig
›
› Schichtstärke bis 3 mm
› Geringer Materialverbrauch
› Kein Schleifen oder Grundieren: aufbringen, verziehen – fertig
› Gesamt-Schichtstärke bis 5 mm
› Falls erforderlich, mit Hand- oder Stielschleifer (z. B. Giraffe) glätten

›
Multi-Finish Beton










Bestandsuntergründe (z. B. Altputz,Fliesen,Reparaturflächen)
› Top-Oberflächen mit heller Optik
› Geringer Materialverbrauch
› Für Beschichtungen oder Bekleidungen evtl. vorbehandeln und grundieren
Vorbehandlungen
Gipsputze
Spachtel pastös
Kalkputze
Unterputze
Oberputze
Sanierung
Dämmschüttungen
Innendämmung
WARM-WAND Dämmstoffe
WARM-WAND Klebe- und Armiermörtel
WARM-WAND Zubehör
AQUAPANEL® VHF
Gestaltungselemente
Farben
Spachtel pastös
Rotband Spachtel Spachtel für Betonflächen
Knauf Rotband Reno ist bei Renovierungs- und Ausbesserungsarbeiten besonders geeignet für das Überspachteln von ebenen Bestandsuntergründen wie Altputzen, Fliesen und Plansteinmauerwerk. Rotband Reno wird von Hand aufgetragen und eigenet sich ebenfalls bestens zum Spachteln von Betonuntergründen. Es sind Schichtdicken von 5 mm (mehrlagig) möglich. Rotband Reno ist schnell trocknend, gut schleifbar und hat einen hohen Weißgrad.
Details finden Sie im techn. Blatt P545a.de
Eigenschaften und Mehrwert
› Gebrauchsfertig
› Organisch gebunden
› Gut füllend
› Schnelle Trocknung
› Gutes Haftvermögen
› Auftragsdicke bis 3 mm pro Lage
› Verarbeitung von Hand
› Lösemittel- und weichmacherfrei
Diese Angaben sind Zirka-Werte und können je nach Art des Untergrundes abweichen.


Knauf Rotband Reno M ist bei Renovierungs- und Ausbesserungsarbeiten besonders geeignet für das Überspachteln von ebenen Bestandsuntergründen wie Altputzen, Fliesen und Plansteinmauerwerk. Rotband Reno M wird maschinell verarbeitet und ist ebenfalls bestens zum Spachteln von Betonuntergründen geeignet. Es sind Schichtdicken von 5 mm (mehrlagig) möglich. Rotband Reno M ist schnell trocknend, gut schleifbar und hat einen hohen Weißgrad.
Details finden Sie im techn. Blatt P545b.de
Eigenschaften und Mehrwert
› Gebrauchsfertig
› Organisch gebunden
› Gut füllend
› Schnelle Trocknung
› Gutes Haftvermögen
› Auftragsdicke bis 3 mm pro Lage
› Verarbeitung mit Maschine
› Lösemittel- und weichmacherfrei
Diese Angaben sind Zirka-Werte und können je nach Art des Untergrundes abweichen.

Spachtel C ist eine organische Spachtelmasse für die rationelle Anwendung im Innenbereich.
Details finden Sie im techn. Blatt P549.de
Eigenschaften und Mehrwert
› Verarbeitungsfertig
› Gut füllend
› Schnelle Trocknung
› Auftragsdicke bis 2 mm pro Schicht
› Verarbeitung mit Maschine
Diese Angaben sind Zirka-Werte und können je nach Art des Untergrundes abweichen.
Die Qualität der Luft nimmt wesentlichen Einfluss auf unsere Gesundheit und unser Wohlbefinden. Gerade dort, wo wir uns die meiste Zeit aufhalten: in geschlossenen Räumen. Die richtigen Baustoffe können einen entscheidenden Beitrag zum Wohlbefinden leisten.

Rotkalk ist ein mineralischer Kalkputz der seinen Namen aufgrund seines rötlichen Farbtons erhalten hat. Dieser Farbton entsteht durch das zugesetzte rötliche Ziegelmehl. Ziegelmehl entsteht durch das sortenreine Zermahlen von Ziegelbruch, das nach dem Brennvorgang nicht zur Verwendung als Ziegelmauerwerk geeignet ist.
Wissenschaftliche Untersuchungen zeigen, dass Rotkalk Umweltstoffe wie VOC´s, Formaldehyd und Stickstoff aus der Raumluft absorbieren und eliminieren kann.
Neueste wissenschaftliche Untersuchungen zeigen auch, dass Rotkalk nicht nur durch die hohe Feuchtigkeitsaufnahme und die
Dämpfung von kurzfristigen Feuchtigkeitsspitzen, z. B. in Feuchträumen und Schlafzimmern, einen Schimmelpilzbefall verhindert, sondern auch, dass der hohe pH-Wert von Rotkalk über einen vergleichsweise langen Zeitraum erhalten bleibt.
Die stark alkalische Oberfläche von Rotkalk schädigt dabei zum einen die Zellstruktur der Schimmelpilze und verhindert damit zusätzlich deren Wachstum.
Rotkalk ist die erste Wahl im Neubau, bei der Modernisierung, Renovierung oder Sanierung. Von den Wohn- und Schlafräumen über die häuslichen Feuchträume bis zum Keller.

Das Knauf Kalkputzsystem Rotkalk wurde vom Institut für Baubiologie in Rosenheim (IBR) mit dem Prüfsiegel „Geprüft und empfohlen vom IBR“ ausgezeichnet. Dieses Zertifikat erhalten Produkte, die gesundes Wohnen und zugleich den Schutz der Umwelt ermöglichen.

Kann Rotkalk auf jeden Wanduntergrund aufgebracht werden?
Grundsätzlich ja, selbstverständlich auch im Altbau. Je nach Untergrund ist vom Fachunternehmer eine entsprechende Vorbehandlung durchzuführen, um so die optimale Haftung des Rotkalk Putzes an der Wand sicherzustellen.
Kann Rotkalk auch in häuslichen Feuchträumen eingesetzt werden?
Rotkalk ist von Natur aus alkalisch, besitzt also einen hohen pH-Wert. Dadurch wirkt der Putz desinfizierend und stellt eine zuverlässige Vorbeugung gegen Schimmel dar – mit Langzeitschutz, auch für Räume mit hohem Wasserdampfaufkommen wie häusliche Bäder oder Küchen.
Was gilt es für eine optimale Wohlfühlwirkung zu bedenken?


Die Wechselwirkung von Rotkalk mit der Raumluft darf nicht behindert werden. Wandflächen sollten nicht tapeziert oder mit ungeeigneten Farben gestrichen werden. Dadurch kann eine Barriere entstehen, die die Wechselwirkung unterbindet. Am besten ist es, den Edelputz natürlich wirken zu lassen. Oder Sie lassen Ihrer Kreativität mit Farbtönen der Rotkalk-Farbe freien Lauf.
Müssen mit Rotkalk verputzte Räume überhaupt noch gelüftet werden?
Rotkalk wirkt rund um die Uhr, auch dann, wenn über einen längeren Zeitraum mal niemand zu Hause ist. Dennoch – gelüftet werden sollte immer! Die empfohlene „Stoßlüftung“ sorgt für einen Luftaustausch innerhalb kürzester Zeit.
Bleiben Sie im System: Das neue Rotkalk in-System vereint die einzigartigen Qualitäten der hochwirksamen natürlichen Innendämmung mit den Vorteilen des Rotkalk-Putzes.
Mehr Informationen im Kapitel Innendämmung auf Seite 145.
Rotkalk nimmt Wasserdampf aus der Raumluft auf und gibt sie bei Bedarf wieder ab. Dadurch entsteht der optimale Ausgleich der Raumluftfeuchte.

Mit dem Rotkalk-System können optimale Innen- und Außenputze ausgeführt werden. Vom Unterputz über Oberputze und Glätte bis hin zur Rotkalk-Farbe bietet das System alle Komponenten für höchst anspruchsvolle Gestaltung. Alle Produkte sind aufeinander
Produkt
abgestimmt, sodass sich die einzigartige Wirkung von Rotkalk optimal entfalten kann. Höchste Funktionalität und eine einzigartige Raumatmosphäre – überzeugend im System.
Putzart Anwendung
Unterputz Rotkalk Grund Unterputz innen und außen
Rotkalk Fein
Dünnputz und gefilzter oder frei strukturierbarer Oberputz innen und außen
Oberputz
Rotkalk Filz 05, Filz 1
Filzputz mit Marmorkorn innen
Rotkalk Filz 2 Filzputz mit Marmorkorn innen und außen
Rotkalk Struktur 1.5
Rotkalk Glätte
Scheibenputz mit Marmorkorn innen
Kalk-Glätte innen
Glättputz
Rotkalk Finish Feinste Kalk-Glätte innen
Farbe Rotkalk Farbe Silikatfarbe innen
Neueste wissenschaftliche Untersuchungen zeigen, dass Rotkalk Umweltstoffe wie VOCs, Formaldehyd und Stickstoff aus der Raumluft absorbieren und eliminieren kann. Zusätzlich beugt Rotkalk durch seine hohe Alkalität der gesundheitsschädlichen Schimmelbildung vor.

Der Trend zum ökologischen Bauen hat dem Kalkputz eine wahre Renaissance beschert. Seine hervorragenden bauphysikalischen Eigenschaften erfüllen die höchsten Ansprüche an die Raumhygiene, Raumluft und die Wohnqualität.
Durch den hohen Kalkanteil ist Knauf Rotkalk spannungsarm und deshalb auch für hochwärmedämmendes Mauerwerk hervorragend geeignet.
Gut zu wissen
In häuslichen Feuchträumen wie Küchen und Bädern können Produkte des Rotkalk-Systems bedenkenlos eingesetzt werden. In klassischen Feuchträumen des öffentlichen und gewerblichen Bereichs, wie beispielsweise in Schwimmhallen, Gemeinschaftsduschen, Großküchen u. Ä. darf Rotkalk nicht eingesetzt werden. Dazu eignen sich Zementputze wie z. B. UP 310.
Außenbereich
Unterputz Rotkalk Grund
Ausführung einlagig zweilagig
Putzdicke 1. Lage 10 mm
max. 15 mm
Putzdicke 2. Lage Zweite Lage innerhalb von 30 Min. nass in feucht bis zur Gesamtputzdicke von 20 mm auftragen
Putzdicke gesamt 10 mm 20 mm
Bei Bedarf Unterputzgewebe oberflächennah einlegen
Standzeit mind. 2 Wochen und nach erfolgtem Estricheinbau 1 Tag je mm Putzdicke
Oberputz
Anmischen
Rotkalk Filz 05, Rotkalk Filz 1, Rotkalk Filz 2, Rotkalk Struktur 1.5 oder Rotkalk Fein
Auftragen
Mineralische Oberputze wie z. B. Rotkalk Filz 2, Noblo, RP 240 u. a.
Filzen
Bei Handverarbeitung den Sackinhalt mit sauberem Wasser in der vom Hersteller angegebenen Menge ohne weitere Zusätze anmischen.
Bei maschineller Verarbeitung ist die Wasserzugabe beim Anfahren konsistenzgerecht einzustellen.
Den Rotkalk Oberputz in der laut technischem Blatt vorgegebenen Dicke auf den Unterputz auftragen und mit der Traufel oder Glättkelle eben verziehen.
Das beste Ergebnis wird bei einem volldeckenden Auftrag in Kornstärke erreicht. Die erste Lage zunächst ansteifen lassen, dann eine zweite Lage auftragen und eben verziehen.
Das Material kann sofort ohne zusätzliche Zugabe von Wasser mit der Rotkalk Schwammscheibe abgerieben oder gefilzt werden.
Zusammenhängende Flächen sollten am selben Tag fertiggestellt werden.
Makellos
Feine Haarrisse in der geglätteten Oberfläche können durch eine zusätzliche vollflächige Gewebearmierung mit Rotkalk Fein und Armiergewebe 5 × 5 mm oder 4 × 4 mm auf den ausgetrockneten Unterputz vermieden werden.
Belastbar
Rotkalk Grund kann bei einer Putzdicke von 15 mm in häuslichen Bädern und Küchen auch als Fliesenuntergrund (nicht bei großformatigen KS-Steinen und zementär gebundenem Mauerwerk) für Keramikfliesen mit einer maximalen Fliesengröße von 33 × 33 cm und einem Flächengewicht von max. 25 kg/m² (inkl. Fliesenkleber) eingesetzt werden. Dazu ist eine Trocknungsund Erhärtungszeit von mindestens sechs Wochen einzuhalten. Danach können die Fliesen mit einem schnell abbindenden, verformbaren Fliesenkleber (z. B. Knauf Flexkleber schnell) angebracht werden.
Absolut sicher
Mineralische Mörtel reagieren mit Wasser alkalisch und können bei direktem Kontakt die Augen und die Haut reizen. Daher sollten Berührungen mit den Augen und der Haut vermieden und eine Schutzbrille bzw. ein Gesichtsschutz und Handschuhe getragen werden. In abgebundenem Zustand sind sie physiologisch und ökologisch völlig unbedenklich.
Strahlend schön
Alle mit Wasser gefilzten mineralischen Putze trocknen im Farbton nicht einheitlich aus. Um eine einheitliche Farbtongestaltung sicherzustellen, sollten diese im Innenbereich mit der auf das Rotkalk-System optimal abgestimmten Rotkalk Farbe E.L.F. gestrichen werden. Im Außenbereich muss ein einmaliger Anstrich mit der hoch diffusionsoffenen MineralAktiv Fassadenfarbe im Putzfarbton ausgeführt werden.
Der Oberputz Rotkalk Struktur 1.5 überzeugt als Scheibenputz nicht nur durch sein schönes, feines Strukturbild. Da er als Scheibenputz, im Gegensatz zur zweilagigen Ausführung bei Rotkalk Filzputzen, einlagig aufgetragen wird, ist er auch ganz besonders wirtschaftlich.
Schimmel und andere Mikroorganismen, häufig Ursache für gesundheitliche Beschwerden und Auslöser von Allergien, haben bei Rotkalk keine Chance. Durch die hohe Alkalitat von Kalk wird mikrobiellem Wachstum auf ganz natürliche Weise die Lebensgrundlage entzogen.
Vorbehandlungen
Gipsputze
Spachtel pastös
Kalkputze
Unterputze
Oberputze
Sanierung
Dämmschüttungen
Innendämmung
WARM-WAND Dämmstoffe
WARM-WAND Klebe- und Armiermörtel
WARM-WAND Zubehör
AQUAPANEL® VHF
Gestaltungselemente
Farben
Kalkputze
Kalkunterputze
Kalkoberputze
Kalkglätten
Kalk-Unterputz mit Kaolin und Ziegelmehl als Unterputz im Innen- und Außenbereich. Besonders geeignet, wo hohe bauphysikalische Ansprüche an die Wohnqualität gestellt werden. Ideal im Bereich der Denkmalpflege, bei der Kalkputze nach historischem Vorbild gefragt sind.
Details finden Sie im techn. Blatt P202.de
Eigenschaften und Mehrwert
› Normalputzmörtel GP nach DIN EN 998-1
› Druckfestigkeitskategorie CS I nach DIN EN 998-1
› Für innen und außen
› Feuchtigkeitsregulierend und diffusionsoffen
› Hohe Alkalität, vorbeugend gegen Schimmelbildung
› Schadstoffabbauende Wirkung für VOC, Formaldehyd und Stickoxide
› Wasserhemmend
› Verarbeitung mit Maschine oder von Hand
› Farbton rötlich-braun
Diese Angaben sind Zirka-Werte und können je nach Art des Untergrundes abweichen.

Kalk-Oberputz mit Kaolin und Ziegelmehl zur Herstellung gefilzter oder frei strukturierter Oberflächen im Innen- und Außenbereich. Innen als Kalk-Dünnputz direkt auf Plansteinmauerwerk und Betonwänden sowie Decken, ggf. nach Vorbehandlung, zu verwenden. Rotkalk Fein ist optimal auf den Unterputz Rotkalk Grund abgestimmt. Ideal im Bereich der Denkmalpflege, bei der Kalkputze nach historischem Vorbild gefragt sind, als Armiermörtel für Rotkalk in-System oder als System Unter- und Oberputz.
Details finden Sie im techn. Blatt P203.de
Eigenschaften und Mehrwert
› Normalputzmörtel GP nach DIN EN 998-1
› Druckfestigkeitskategorie CS I nach DIN EN 998-1
› Für innen und außen
› Wasserhemmend
› Feuchtigkeitsregulierend und diffusionsoffen
› Hohe Alkalität, vorbeugend gegen Schimmelbildung
› Schadstoffabbauende Wirkung für VOC, Formaldehyd und Stickoxide
› Verarbeitung mit Maschine oder von Hand
› Farbton rötlich-braun

Diese Angaben sind Zirka-Werte und können je nach Art des Untergrundes abweichen.
Mineralischer, hochergiebiger und schnell abbindender Kalk-Leichtputz mit mineralischem Leichtzuschlag. Auf allen Mauerwerksarten und Beton im Innenbereich. Sowohl zur Anwendung im Neubau als auch bei der Sanierung und Modernisierung. Der hohe Kalkanteil führt zu einer effektiven Feuchtigkeitsregulierung. Der mineralische Leichtzuschlag und die schnelle Endbearbeitung, sind Grundlage für eine optimale und leichte Verarbeitung.
Details finden Sie im techn. Blatt P206L.de
Eigenschaften und Mehrwert
› Leichtputzmörtel LW nach DIN EN 998-1


› Druckfestigkeitskategorie CS II nach DIN EN 998-1
› Leichtputz Typ I
› Feuchtigkeitsregulierend und diffusionsoffen
› Hohe Alkalität, vorbeugend gegen Schimmelbildung
› Schnell abbindend
› Mit mineralischem Leichtzuschlag
› Für innen und außen
› Verarbeitung mit Maschine oder von Hand
Diese Angaben sind Zirka-Werte und können je nach Art des Untergrundes abweichen.
Klassischer, mineralischer Kalk-Unterputz für den Neubau sowie Renovier- und Sanierungsbereich auf allen Mauerwerksarten und Beton. Eine effektive Feuchtigkeitsregulierung wird durch den hohen Kalkanteil erreicht.
Details finden Sie im techn. Blatt P206g.de
Eigenschaften und Mehrwert
› Normalputzmörtel GP nach DIN EN 998-1
› Druckfestigkeitskategorie CS II nach DIN EN 998-1
› Für Innen
› Feuchtigkeitsregulierend
› Diffusionsoffen
› Brandverhalten A1
› Verarbeitung mit Maschine oder von Hand
› Körnung 1,0 mm
› Farbton naturweiß
Diese Angaben sind Zirka-Werte und können je nach Art des Untergrundes abweichen.
Marmor-Edelputz als feiner Scheibenputz zur Herstellung dekorativer, feinstrukturierter Oberflächen auf Innenwandflächen. In Verbindung mit Rotkalk Grund oder Rotkalk Fein speziell geeignet, wo hohe bauphysikalische Ansprüche an die Raumhygiene, Raumluft und die Wohnqualität gestellt werden.
Details finden Sie im techn. Blatt P207.de
Eigenschaften und Mehrwert
› Edelputzmörtel CR nach DIN EN 998-1
› Druckfestigkeitskategorie CS I nach DIN EN 998-1
› Beeinflusst das Raumklima positiv
› Feuchtigkeitsregulierend und diffusionsoffen
› Für den Innenbereich
› Verarbeitung mit Maschine oder von Hand
› Farbton weiß (ca. RAL 9016)
› Eingeschränkt tönbar nach Farbtonfächer Knauf ColorConcept
Diese Angaben sind Zirka-Werte und können je nach Art des Untergrundes abweichen.
Marmor-Edelputz als feinster Filzputz oder mit freier Struktur zur Herstellung dekorativer, feinstrukturierter Oberflächen auf Innenwandflächen. In Verbindung mit Rotkalk Grund oder Rotkalk Fein speziell geeignet, wo hohe bauphysikalische Ansprüche an die Raumhygiene, Raumluft und die Wohnqualität gestellt werden.
Details finden Sie im techn. Blatt P204.de
Eigenschaften und Mehrwert
› Edelputzmörtel CR nach DIN EN 998-1


› Druckfestigkeitskategorie CS I nach DIN EN 998-1
› Beeinflusst das Raumklima positiv
› Für den Innenbereich
› Feuchtigkeitsregulierend und diffusionsoffen
› Verarbeitung mit Maschine oder von Hand
› Farbton weiß (ca. RAL 9016)
› Eingeschränkt tönbar nach Farbtonfächer Knauf ColorConcept
Diese Angaben sind Zirka-Werte und können je nach Art des Untergrundes abweichen.
Marmor-Edelputz als feiner Filzputz oder mit freier Struktur zur Herstellung dekorativer, feinstrukturierter Oberflächen auf Innen- und Außenwandflächen oberhalb des Spritzwasserbereichs. In Verbindung mit Rotkalk Grund oder Rotkalk Fein speziell geeignet, wo hohe bauphysikalische Ansprüche an die Raumhygiene, Raumluft und die Wohnqualität gestellt werden.
Details finden Sie im techn. Blatt P204b.de
Eigenschaften und Mehrwert
› Edelputzmörtel CR nach DIN EN 998-1
› Druckfestigkeitskategorie CS I nach DIN EN 998-1
› Beeinflusst das Raumklima positiv
› Für innen und außen
› Verarbeitung mit Maschine oder von Hand
› Farbton weiß (ca. RAL 9016)
› Feuchtigkeitsregulierend und diffusionsoffen
Diese Angaben sind Zirka-Werte und können je nach Art des Untergrundes abweichen.
Spezielle Filzscheibe mit 30 mm feinporigem Schwamm. Für gefilzte Oberflächenstrukturen wie Rotkalk Filz 05, Rotkalk Filz 1, Rotkalk Filz 2, Rotkalk Fein, SM700 Pro oder Noblo Filz.
Details finden Sie im techn. Blatt
› Abmessungen 200 x 300 mm

› VPE: 10 Stück

Kalk-Glätte auf Rotkalk Grund, Rotkalk Fein und Kalk-Zement-Putzen wie UP 210 oder UP210s für geglättete Oberflächen.
Details finden Sie im techn. Blatt P205.de
Eigenschaften und Mehrwert
› Normalputzmörtel GP nach DIN EN 998-1
› Druckfestigkeitskategorie CS I nach DIN EN 998-1
› Beeinflusst das Raumklima positiv
› Feuchtigkeitsregulierend und diffusionsoffen
› Für den Innenbereich
› Verarbeitung von Hand
› Farbton beige
Diese Angaben sind Zirka-Werte und können je nach Art des Untergrundes abweichen.


Vergütete Kalk-Glätte zum Feinglätten auf Rotkalk Glätte für geglättete Oberflächen, die nur noch gestrichen, lasiert oder imprägniert werden. Bei Flächen, die nur noch gestrichen werden sollen, sind mindestens zwei Glättvorgänge auf der Rotkalk Glätte notwendig.
Details finden Sie im techn. Blatt P205a.de
Eigenschaften und Mehrwert
› Normalputzmörtel GP nach DIN EN 998-1
› Druckfestigkeitskategorie CS I nach DIN EN 998-1
› Beeinflusst das Raumklima positiv
› Feuchtigkeitsregulierend und diffusionsoffen
› Für den Innenbereich
› Verarbeitung von Hand
› Farbton beige
Diese Angaben sind Zirka-Werte und können je nach Art des Untergrundes abweichen.
Unterputze
Für ebene und schön strukturierte Oberflächen wird eine solide Basis benötigt. Knauf Unterputze schaffen einen einheitlichen und sicheren Putzgrund – also die ideale Voraussetzung für nachfolgende Beschichtungen.

Als Unterputz oder auch Grundputz bezeichnet man die unterste Lage eines zweioder mehrlagigen Putzsystems, das in getrennten Arbeitsschritten auf das Mauerwerk aufgetragen wird.
Er hat im Wesentlichen die Aufgabe, Unebenheiten der Wandkonstruktion auszugleichen, um eine ebene Oberfläche zu erreichen und im Außenbereich den geforderten Witterungsschutz sicherzustellen.
Bei partiellem Ausgleich von unebenen Untergründen können je nach Bindemittel und Untergrundbeschaffenheit Auftragsdicken
Produktbezeichnung
bis ca. 30 mm einlagig ausgeführt werden. Größere Putzdicken sind mehrlagig auszuführen. Außenputze sollten erst dann fertiggestellt werden, wenn die Innenputz- und Estricharbeiten ausgeführt und ausgetrocknet sind. Der Unterputz muss an die Festigkeit des Putzgrundes angepasst sein und sollte außerdem eine gewisse Elastizität besitzen, um kleinere Druck- und Zugspannungen, die durch klimatische Veränderungen insbesondere im Außenbereich auftreten, ausgleichen zu können.
Je nach Anforderung werden sie mit Bindemittel aus Kalk, Kalk-Zement oder Zement
hergestellt und sind so optimal auf den Untergrund abgestimmt.
Gerade im sockel- und erdberührten Bereich müssen Sockelputze zusätzlich widerstandsfähig gegen kombinierte Einwirkungen wie Feuchte und Frost sein. Durch den Einsatz des richtigen Feuchteschutzes kann dem entgegengewirkt werden. Knauf Sockel-Dicht hält, was der Name verspricht! Die mineralische, hoch vergütete, elastische Dichtungsmasse für Sockel und Kellerwände wird jeder Herausforderung gerecht.
Abbindeverhalten Leichtzuschlag
Mauerwerk aus Ziegel-, Bimsund Leichtbeton, gleichmäßig und normal saugender Kalksandstein
Bei stark saugenden Untergründen oder hochsommerlicher Witterung in einer Putzlage, zweischichtig nass in nass, auftragen
Porenbeton Mauerwerk aus Kalksandstein, der ein unterschiedliches oder geringes Saugverhalten aufweist Glatt geschalter Beton, Betonfertigteile und Kalksandsteinmauerwerk bei späterer Fliesenbelegung
XPS-R Dämmplatten Mauerwerk aus kleinformatigen Ziegeln, Bruchstein und Mischmauerwerk Leichthochlochziegel Rohdichte < 0,8 kg/dm³ Bimsund Leichtbeton Wärmeleitfähigkeit λ < 0,14 W/(m∙K) mit Dämm - stofffüllung ohne Dämmstofffüllung
Untergrundvorbehandlung 1 Anwendung auf Beton im Leichtputz Grundputz Normal Beschleunigt Mineralischer Leichtzuschlag Organischer (EPS) Leichtzuschlag
ggf. Press-Spachtelung mit Gigamit und zweischichtig, nass in nass auftragen
In einer Putzlage, zweischichtig nass in nass auftragen
SM700 Pro, SM700, SM300, Sockel-SM
1 Untergrundvorbehandlung max. 3 Tage Standzeit bis zur Weiterbeschichtung
Wärmedämmputze wie der Knauf DP 007 werden zur Verbesserung der Wärmedämmung an Innen- und Außenwänden eingesetzt. Die dämmenden Zuschlagstoffe, meist in Form von Polystyrol, sind in den Unterputz eingebettet. Zu einem Wärmedämmputzsystem gehört zusätzlich das Auftragen eines Oberputzes, der vor Witterungseinflüssen schützt und eine optische Gestaltung ermöglicht. Wärmedämmputze erreichen nicht die Dämmwirkung von WDV-Systemen, haben aber den Vorteil, dass fugenlose Dämmschichten erzielt werden können, die sich an alle Untergrund-Geometrien anpassen. Daher sind sie besonders für denkmalgeschützte Fassaden geeignet.
Leichtunterputze wie Knauf LUP 222 und Lumit oder die faserarmierten, schnell abbindenden Leichtputze Typ II wie Super Lupp, LUP schnell oder Super Lupp mineralisch sind Unterputze mit geringer Rohdichte und geringem E-Modul. Dadurch lassen sich höhere Schichtdicken auftragen und kritische, zur Rissbildung neigende Untergründe besser verputzen. Leichtputze sind mineralisch, enthalten organische Leichtzuschlagstoffe und sind dadurch sehr diffusionsoffen.
Schnell abbindende Leichtputze Typ II wie Super Lupp, LUP schnell und Super Lupp mineralisch sind leichter, ergiebiger und damit deutlich wirtschaftlicher zu verarbeiten.
Eine vollflächige Armierungsputzlage ist einer Untergrundertüchtigung im Aussenbereich immer vorzuziehen.
Von Grund auf perfekt
Die Anwendung der Unterputze ist abhängig vom Mauerwerk. Dessen Saugfähigkeit beeinflusst die Putzhaftung. Normal saugende Untergründe können ohne Untergrundvorbehandlung verputzt werden. Bei stark saugenden Untergründen erfolgt die Ausführung zweischichtig nass in nass.
Die Untergrundertüchtigung erfolgt mit dem geeigneten Knauf Klebe- und Armiermörtel (siehe Tabelle Untergrundvorbehandlung) mit Gewebeeinlage direkt auf den zu verputzenden Untergrund. Die Überlappung der Gewebeeinlage muss ca. 10 cm betragen. Auf benachbarte Bauteile muss die Überlappung ca. 20 cm betragen. Zur Minderung der Kerbrissgefahr ist an allen Gebäudeöffnungsecken eine zusätzliche Diagonalarmierung einzulegen. Die Mindestdicke des Armierungsputzes beträgt 5 mm. Diese Ausführung dient sowohl als Haftbrücke als auch zur Untergrundstabilisierung. Bei dieser Maßnahme wird nicht der Putz armiert, sondern der Putzgrund ertüchtigt. Mit dieser Anordnung werden aus unterschiedlichen Untergrundeigenschaften herrührende Spannungen auf eine größere Fläche verteilt.
Zur Minimierung des Risikos von Putzrissen hat es sich bewährt und entspricht den allgemein anerkannten Regeln der Technik, einen Armierungsputz mit vollflächiger Gewebeeinlage auf einen Leichtputz aufzubringen.
Unterputze sind die untere Putzlage in einem Putzsystem. Sie dienen überwiegend dazu, einen gleichmäßigen und ebenen Untergrund für nachfolgende Beschichtungen herzustellen. Ihre fachgerechte Ausführung ist von besonderer Bedeutung, da sie die Haftung und die Gestaltung der nachfolgenden Putzschichten beeinflussen kann. Knauf Unterputze können, mit Ausnahme des Wärmedämmput-
zes DP 007, bedenkenlos auch in häuslichen Küchen und Bädern als Untergrund für Fliesenbelegung eingesetzt werden. Feuchträume mit hoher Beanspruchung wie Duschräume in öffentlichen Schwimmbädern, Sportstätten sowie in gewerblichen Anlagen erfordern Kalk-Zement oder Zementputze.
Unterputze werden in der Regel einlagig im Innenbereich in einer Schichtdicke von etwa 10 mm, im Außenbereich von etwa 15 mm aufgetragen. Sind die Unebenheiten des Untergrundes zu groß, kann eine zweilagige Beschichtung nötig sein.

Normal saugende Untergründe können ohne Untergrundvorbehandlung verputzt werden. Bei stark saugenden Untergründen erfolgt die Ausführung nass in feucht. Dabei eine Lage von 5 –10 mm vorlegen und die zweite Lage bis zur erforderlichen Putzdicke nass in feucht auftragen. Bei nicht saugenden Untergründen ist eine mineralische Putzhaftbrücke mit SM700 Pro, SM300, Sockel-SM oder Lustro auszuführen.
Auftrag
Bei einer Vorbehandlung des Untergrundes zunächst die auf den Untergrund aufgebrachte Grundierung vollkommen trocknen lassen. Unterputze werden meist mit einer Mischpumpe, wie z. B. PFT G4, verarbeitet und sind damit besonders rationell und zeitsparend. Sie können aber auch händisch auf die Wand angetragen werden. Anschließend die Putzfläche mit der Kartätsche oder einem Richtscheit gleichmäßig verteilen und nach Mörtelansteifung nachschaben.
Die fertige Grundputzfläche muss vor der Weiterbeschichtung vollkommen ausgetrocknet sein. Die Trocknungszeit ist abhängig von der Putzdicke bzw. von äußeren Bedingungen wie Witterung, Temperatur etc. Um ein zu schnelles Austrocknen zu verhindern, müssen Außenputze vor direkter Sonneneinstrahlung geschützt werden. Grundsätzlich gilt aber für die Trocknungszeit: mindestens 1 Tag/mm Putzdicke. Bei beschleunigten Produkten, wie Super Lupp, LUP schnell, Lumit, UP 210s und Sockel LUP, kann bei Beschichtung mit dünnschichtigen Knauf Oberputzen bei günstigen Witterungs- und Trocknungsbedingungen die Standzeit auf 1 Tag pro 2 mm Putzdicke (Mindeststandzeit 5 Tage) verkürzt werden.

Wärmedämmputz DP007 kann in einer Mindestputzdicke von 20 und max. 120 mm aufgetragen werden. Einlagig kann die Putzdicke bis 60 mm ausgeführt werden, bei Putzdicken > 60 bis 120 mm ist zweilagig zu arbeiten. Bei der ersten Lage wird empfohlen, den Erstauftrag (ca. 2/3 der Putzdicke) in einer etwas steiferen Konsistenz und das letzte Drittel bis zur Endputzdicke in etwas plastischerer Konsistenz aufzutragen. Die untere Lage mit einem Besen aufrauen. Am

Folgetag kann die nächste Lage bis zur max. Putzdicke von 120 mm aufgetragen werden. Nach einer Trocknungszeit von mindestens zwei Tagen/cm Wärmedämmputz, frühestens jedoch nach zwei Wochen, können dünnlagige, mineralische Oberputze auf einer Zwischenlage mit Lustro (ca. 6–8 mm), mit Gewebeeinlage, aufgetragen werden.

Schnell abbindende Unterputze
Super Lupp, UP 210s, Lumit, LUP schnell, Sockel LUP und Flotto Füll sind schnell abbindende Unterputze. Das bedeutet, dass eine frühere Endbearbeitung erfolgen kann. Je nach Putzgrund können nach ca. zwei Stunden vorhandene Unebenheiten, Mörtelgrate etc. abgestoßen werden. Die Standzeit von einem Tag/mm bis zur weiteren Beschichtung ist einzuhalten. Aufgrund der Beschleunigung sind Spritzunterbrechungen von max. 15 Minuten (bei kühler Witterung von max. 25 Minuten) möglich. Bei längeren Pausen sind der Nassbereich der Mischpumpe und die Mörtelschläuche zu reinigen. Bei vorheriger Verarbeitung von Gipsputzen bzw. gipshaltigen Materialien ist es zwingend notwendig, die Putzmaschine gründlich zu reinigen.
Verfüllmörtel
Verfüllmörtel wie Flotto Füll kommen dort zur Anwendung, wo hohe Putzdicken erforderlich werden. Diese sind speziell beim Verfüllen von teilweise oder komplett entkerntem Gefache bei Fachwerkgebäuden notwendig. Hier sind Putzdicken bis zu 200 mm keine Seltenheit. Zusätzlich kommt durch den Zuschlag von EPS-Leichtzuschlägen eine zusätzliche, wärmedämmende Wirkung hinzu.
Auch bei der Überdeckung von Sanitärinstallationen, z. B. im Badbereich, wird Flotto Füll sehr häufig eingesetzt. Durch den hier einlagig auszuführenden Putzauftrag ist Flotto Füll, was die Rationalität angeht, unschlagbar. Gleichzeitig ist ein optimaler Untergrund für die spätere Fliesenverlegung vorhanden.
Beim Verfüllen von Deckendurchbrüchen oder tiefen Leitungsschlitzen wird durch das schnelle Abbindeverhalten ein optimaler Baustellenablauf geschaffen.
Sockelputze wie Sockel Gigamit, Sockel LUP oder UP 310 werden speziell im spritzwasserbelasteten Sockelbereich, bis max. 30 cm über GOK, wo hoher Widerstand gegen Stoßbelastung gefordert wird, oder als Fliesenuntergrund in Feuchträumen eingesetzt.
Feuchteschutz/Bauwerksabdichtung
Alle von Erde oder Kiesschüttung berührten Putzflächen nach Austrocknung von der Kellerwandabdichtung bis ca. 5cm über Geländeoberkante gemäß DIN 18195 vor Feuchtigkeit schützen/ abdichten. Hierzu kann Sockel-Dicht in 2,5 mm Schichtdicke (zweilagig) aufge-
bracht werden. Nach Trocknung eine vlieskaschierte Noppenfolie davorstellen.
Knauf Sockel-SM Pro –Sockelputz mit Feuchteschutz!

Mit dem Sockel-SM Pro steht ein einzigartiger Sockelputz zur Verfügung: Bei fachgerechter Ausführung und einer Gesamtschichtdicke ab 7 mm (Armierung + Oberputz) ist kein zusätzlicher Feuchteschutz nötig. Nach Trocknung ist lediglich eine vlieskaschierte Noppenfolie davorzustellen.
Leicht-Armier-Putze – Die neue Generation
Mit Gigamit, als Leicht-Armier-Putz in der Fassadenfläche und Sockel Gigamit, als Leicht-Armier-Sockelputz im Sockelbereich werden drei Arbeitsschritte mit einem Produkt ausgeführt. Die sonst übliche Untergrundvorbehandlung entfällt komplett, ob auf XPS-R Dämmplatten oder auf bituminöser oder mineralischer Bauwerksabdichtung im Sockelbereich.
Zusätzlich muss keine zusätzliche Armierungsputzlage auf den Unterputz ausgeführt werden. Sowohl beim Gigamit als auch bei Sockel Gigamit kann das Armiergewebe direkt in den Armier-Unterputz eingebettet werden.
Schneller und wirtschaftlicher
Gigamit und Sockel Gigamit haben eines gemeinsam: Sie sind 3-in-1-Hochleistungsputze. Sie sind Putzhaftbrücke, (Sockel-) Leichtputz und Armierungsputz in einem. Ohne Vorbehandlung können sie auf nahezu allen Untergründen aufgebracht werden und eine eventuell notwendige, vollflächige Gewebeeinlage ausgeführt werden. Gigamit und Sockel Gigamit sind Ihre TopLösung für schnelle, perfekte Ergebnisse.
Wie Sie Gigamit verarbeiten, können Sie in folgendem Video anschauen.
3-in-1 mit massig Vorteilen!
Drei Arbeitsschritte mit nur einem Putz. Das spart Stand- und Rüstzeit. Denn mit dem Sockel Gigamit können Sie die Unterputzarbeiten am Sockel – sowie mit dem Gigamit an der Fassadenfläche – ohne Unterbrechung und damit besser planbar durchführen.
Wie Sie Sockel Gigamit verarbeiten, können Sie in folgendem Video anschauen.
Vorteile auf einen Blick:
› Putzhaftbrücke, (Sockel-)Leichtputz und Armierungsputz in einem
› Ohne Vorbehandlung einsetzbar auf schwach oder nicht saugenden Untergründen (Gigamit) bzw. nahezu allen Untergründen im Sockelbereich (Sockel Gigamit)
› Ideal für flächenbündige Sockel mit durchgehendem oder getrenntem Oberputz
› Mit mineralischen Leichtzuschlägen
› Maschinell und von Hand verarbeitbar




Fassade Gigamit
Untergrundvorbehandlung
Nicht erforderlich
Unterputz Gigamit mit Gewebeeinlage
Vollflächiger
Armierungsputz mit Gewebeeinlage
Nicht erforderlich
Oberputz Alle Knauf Oberputze für den Außenbereich
Ausführung Sockelbereich
Sockel Zurückspringend Flächenbündig mit durchgehendem Oberputz Flächenbündig mit getrenntem Oberputz
Untergrundvorbehandlung
Sockelputz
Vollflächiger
Armierungsputz mit Gewebeeinlage
Sockel Gigamit
Oberputz Alle Knauf Oberputze für den Außenbereich
Sockel-SM Pro
Feuchteschutz Nicht erforderlich Sockel-Dicht
Anstrich Alle Knauf Farben für den Außenbereich
Sockel Gigamit gefilzt
Vorbehandlungen
Gipsputze
Spachtel pastös
Kalkputze
Unterputze
Oberputze
Sanierung
Dämmschüttungen
Innendämmung
WARM-WAND Dämmstoffe
WARM-WAND Klebe- und Armiermörtel
WARM-WAND Zubehör
AQUAPANEL® VHF
Gestaltungselemente
Farben
Unterputze
Leichtunterputze
Unterputze
Wärmedämmputz
Sockelputze/-abdichtung
VorWand System
Ergänzungsprodukte

Hochergiebiger polymermodifizierter Kalk-Zement-Leichtunterputz mit mineralischen Leichtzuschlägen auf hochwärmedämmendes Mauerwerk. Auf nicht oder schwach saugenden Untergünden ist eine mineralische Putzhaftbrücke nicht erforderlich. Gigamit mit einer vollflächigem Gewebeeinlage erfüllt die gleichen Kennwerte wie ein Unterputz mit zusätzlichem, volllfächigem Armierungsputz mit Gewebeeinlage. Als Fliesenuntergrund für Fliesen in Bädern und Küchen bis zu einem Fliesengewicht von max. 25 kg/ m² (incl. Fliesenkleber) geeignet.
Details finden Sie im techn. Blatt P258g.de
Faserarmierter, mineralischer, hochergiebiger und schnell abbindender Kalk-Zement-Leichtputz Typ II mit organischem (EPS) Leichtzuschlag. Die schnelle Endbearbeitung ist Grundlage für die wirtschaftliche Verarbeitung. Durch die halbierte Standzeit bis zur Weiterbeschichtung ist eine rationelle Arbeitsweise möglich. Als Leichtunterputz für mineralische und pastöse Oberputze auf allen gängigen Mauerwerksarten und Beton im Innen- und Außenbereich. Als Fliesenuntergrund für Fliesen in Bädern und Küchen bis zu einem Fliesenformat von 60 x 30 cm und einem Fliesengewicht von max. 25 kg/m² (incl. Fliesenkleber) geeignet.
Details finden Sie im techn. Blatt P259.de
Eigenschaften und Mehrwert
› Leichtputzmörtel LW nach DIN EN 998-1
› Polymermodifizierter Leichtputzmörtel nach DIN 13914
› Druckfestigkeitskategorie CS II nach DIN EN 998-1
› Leichtputz Typ II
› Direkt auf schwach saugenden Untergründen anwendbar
› Für innen und außen
› Mit mineralischem Leichtzuschlag
› Maschinelle Verarbeitung oder von Hand
› Farbton naturweiß
Eigenschaften und Mehrwert
› Leichtputzmörtel LW nach DIN EN 998-1
› Druckfestigkeitskategorie CS II nach DIN EN 998-1
› Leichtputz Typ II
› Schnell abbindend
› Faserzusatz
› Hohe Ergiebigkeit
› Für innen und außen
› Organischer (EPS) Leichtzuschlag
› Halbierte Standzeit von 1 Tag pro 2 mm Putzdicke

› Verarbeitung mit Maschine oder von Hand
Diese Angaben sind Zirka-Werte und können je nach Art des Untergrundes abweichen.
Faserarmierter, hochergiebiger und schnell abbindender Kalk-Zement-Leichtputz

Faserarmierter, mineralischer, ergiebiger und schnell abbindender Kalk-Zement-Leichtputz Typ II mit organischem (EPS) Leichtzuschlag. Die schnelle Endbearbeitung ist Grundlage für die wirtschaftliche Verarbeitung. Durch die halbierte Standzeit bis zur Weiterbeschichtung ist eine rationelle Arbeitsweise möglich. Als Leichtunterputz für mineralische und pastöse Oberputze auf allen gängigen Mauerwerksarten und Beton im Innen- und Außenbereich. Als Fliesenuntergrund für Fliesen in Bädern und Küchen bis zu einem Fliesengewicht von max. 25 kg/m² (incl. Fliesenkleber) geeignet.
Details finden Sie im techn. Blatt P255b.de
Eigenschaften und Mehrwert
› Leichtputzmörtel LW nach DIN EN 998-1
› Druckfestigkeitskategorie CS II nach DIN EN 998-1
› Leichtputz Typ II
› Schnell abbindend
› Faserzusatz
› Für innen und außen
› Hohe Ergiebigkeit
› Organischer (EPS) Leichtzuschlag
› Verarbeitung mit Maschine oder von Hand
› Halbierte Standzeit von 1 Tag pro 2 mm Putzdicke
Diese Angaben sind Zirka-Werte und können je nach Art des Untergrundes abweichen.

Mineralischer, ergiebiger Kalk-Zement-Leichtputz mit organischem (EPS) Leichtzuschlag. Im Innenbereich auf allen gängigen, im Außenbereich auf allen für Leichtputz Typ I geeigneten Mauerwerksarten wie Mauerwerk mit Dämmstofffüllung, Leichthochlochziegel mit einer Rohdichteklasse ≥ 0,8 kg/dm³, Porenbetonmauerwerk mit einer Rohdichte ≥ 500 kg/m³, Leichtbetonmauerwerk mit einer Wärmeleitfähigkeit λ ≥ 0,14 W/(mK) und auf Beton.
Als Fliesenuntergrund für Fliesen in Bädern und Küchen bis zu einem Fliesengewicht von max. 25 kg/ m² (incl. Fliesenkleber) geeignet. Auf verschiedenen Untergründen wird eine Vorbehandlung notwendig.
Details finden Sie im techn. Blatt P255a.de
Eigenschaften und Mehrwert
› Leichtputzmörtel LW nach DIN EN 998-1
› Druckfestigkeitskategorie CS II nach DIN EN 998-1
› Leichtputz Typ I
› Ergiebig
› Für innen und außen
› Organischer (EPS) Leichtzuschlag
› Verarbeitung mit Maschine oder von Hand
Diese Angaben sind Zirka-Werte und können je nach Art des Untergrundes abweichen.
Mineralischer, ergiebiger Kalk-Zement-Leichtputz mit mineralischem Leichtzuschlag. Im Innenbereich auf allen gängigen, im Außenbereich auf allen für Leichtputz Typ I geeigneten Mauerwerksarten wie Mauerwerk mit Dämmstofffüllung, Leichthochlochziegel mit einer Rohdichteklasse ≥ 0,8 kg/dm³, Porenbetonmauerwerk mit einer Rohdichte ≥ 500 kg/m³, Leichtbetonmauerwerk mit einer Wärmeleitfähigkeit λ ≥ 0,14 W/(mK) und auf Beton. Als Fliesenuntergrund für Fliesen in Bädern und Küchen bis zu einem Fliesengewicht von max. 25 kg/m² (incl. Fliesenkleber) geeignet.
Auf verschiedenen Untergründen wird eine Vorbehandlung notwendig.
Details finden Sie im techn. Blatt P255m.de

Eigenschaften und Mehrwert
› Leichtputzmörtel LW nach DIN EN 998-1

› Druckfestigkeitskategorie CS II nach DIN EN 998-1
› Leichtputz Typ I
› Ergiebig
› Für innen und außen
› Mit mineralischem Leichtzuschlag
› Verarbeitung mit Maschine oder von Hand
Mineralischer Kalk-Zement-Unterputz. Im Innenbereich auf allen gängigen, im Außenbereich auf allen für Normalputze geeigneten Mauerwerksarten und Beton geeignet. Im Innenbereich kann durch eine zusätzliche Putzlage die Oberfläche abgefilzt werden. Als Fliesenuntergrund für Fliesen in Bädern und Küchen bis zu einem Fliesengewicht von max. 25 kg/ m² (incl. Fliesenkleber) geeignet.
Details finden Sie im techn. Blatt P258.de
Eigenschaften und Mehrwert
› Normalputzmörtel GP nach DIN EN 998-1
› Druckfestigkeitskategorie CS II nach DIN EN 998-1
› Für innen und außen
› Schnell abbindend
› Verarbeitung mit Maschine oder von Hand
› Körnung 0,8 mm
Mineralischer Kalk-Zement-Unterputz. Im Innenbereich auf allen gängigen, im Außenbereich auf allen für Normalputze geeigneten Mauerwerksarten und Beton geeignet. Im Innenbereich kann durch eine zusätzliche Putzlage die Oberfläche abgefilzt werden. Als Fliesenuntergrund für Fliesen in Bädern und Küchen bis zu einem Fliesengewicht von max. 25 kg/ m² (incl. Fliesenkleber) geeignet.
Details finden Sie im techn. Blatt P251a.de
Eigenschaften und Mehrwert
› Normalputzmörtel GP nach DIN EN 998-1
› Druckfestigkeitskategorie CS II nach DIN EN 998-1
› Für innen und außen
› Verarbeitung mit Maschine oder von Hand
› Körnung 1,2 mm
Diese Angaben sind Zirka-Werte und können je nach Art des Untergrundes abweichen.

Mineralischer, schnell abbindender Kalk-Zement-Unterputz. Im Innenbereich auf allen gängigen Mauerwerksarten und Beton geeignet. Mit einer zusätzlichen Putzlage kann die Oberfläche abgefilzt werden. Die schnelle Endbearbeitung ist Grundlage für die wirtschaftliche Verarbeitung. Durch die halbierte Standzeit bis zur Weiterbeschichtung ist eine rationelle Arbeitsweise möglich. Als Fliesenuntergrund für Fliesen in Bädern und Küchen bis zu einem Fliesengewicht von max. 25 kg/m² (incl. Fliesenkleber) geeignet.
Details finden Sie im techn. Blatt P251b.de
Eigenschaften und Mehrwert
› Normalputzmörtel GP nach DIN EN 998-1
› Druckfestigkeitskategorie CS III nach DIN EN 998-1
› Schnell abbindend
› Für innen
› Halbierte Standzeit von 1 Tag pro 2 mm Putzdicke

› Verarbeitung mit Maschine oder von Hand
› Körnung 1,0 mm
Diese Angaben sind Zirka-Werte und können je nach Art des Untergrundes abweichen.
DP 007 ist ein Kalk-Zement-Wärmedämmputz mit organischen Leichtzuschlägen (EPS) für alle gängigen Mauerwerks-Untergründe im Innen- und Außenbereich. Nicht als Fliesenuntergrund geeignet.
Details finden Sie im techn. Blatt P262.de
Eigenschaften und Mehrwert
› Druckfestigkeitskategorie CS I nach DIN EN 998-1
› Wärmedämmputzmörtel T1 nach DIN EN 998-1
› Für innen und außen
› Wasserhemmend
› Mit Leichtzuschlag
› Verarbeitung mit Maschine oder von Hand
› Spannungsarm
› Diffusionsoffen
› Wärmeleitfähigkeit λ10,dry = 0,066 W/(mK)

Diese Angaben sind Zirka-Werte und können je nach Art des Untergrundes abweichen.
Knauf Sockel Gigamit ist ein polymermodifizierter Leicht-Armier-Sockelputz mit mineralischen Leichtzuschlägen. Er erfüllt die Anforderungen einer mineralischen Putzhaftbrücke, eines Sockel-Leichtputzes und eines Armierungsputzes für die Anwendung im Sockelbereich. Sockel Gigamit kann ohne Untergrundvorbehandlung direkt auf nahezu alle Untergründe im Sockelbereich (z.B. Sockel- und XPS-R Perimeterdämmplatten, mineralische und bituminöse Bauwerksabdichtungen, bestreute Polymerbitumenschweißbahn) aufgetragen werden. Es ist keine sonst übliche Haftbrücke notwendig. In Sockel Gigamit kann direkt eine vollflächige Gewebeeinlage mit Knauf Armiergewebe erfolgen. Es ist kein zusätzlicher Armierungsputz notwendig.

Als Fliesenuntergrund in Feuchträumen geeignet.
Details finden Sie im techn. Blatt P258f.de
Eigenschaften und Mehrwert
› Normalputzmörtel GP nach DIN EN 998-1
› Druckfestigkeitskategorie CS III nach DIN EN 998-1
› Direkt auf mineralische und bituminöse Bauwerksabdichtungen und bestreute Polymerbitumenschweißbahn
› Direkt auf Beton, Sockel- und XPS-R Dämmplatten
› Für innen und außen
› Mit mineralischem Leichtzuschlag
› Maschinelle Verarbeitung oder von Hand
Leicht-Armier-Sockelputz mit mineralischen Leichtzuschlägen für den Sockel
Schnell abbindender Kalk-Zement-Leichtunterputz mit Leichtzuschlägen auf alle gängigen Mauerwerks-Untergründe als Kellerwand- und Sockelputz im Außenbereich. Auch als Fliesenuntergrund in Feuchträumen geeignet.
Details finden Sie im techn. Blatt P293.de
Eigenschaften und Mehrwert
› Normalputzmörtel GP nach DIN EN 998-1
› Druckfestigkeitskategorie CS III nach DIN EN 998-1
› Schnell abbindend
› Für innen und außen
› Halbierte Standzeit von 1 Tag pro 2 mm Putzdicke


› Mit Leichtzuschlag
› Verarbeitung mit Maschine oder von Hand
Diese Angaben sind Zirka-Werte und können je nach Art des Untergrundes abweichen.
Zement-Unterputz für Untergründe mit normaler und hoher Rohdichte. Als Kellerwand- und Sockelputz im Außenbereich. Auch als Fliesenuntergrund in Feuchträumen geeignet.
Details finden Sie im techn. Blatt P291a.de
Eigenschaften und Mehrwert
› Normalputzmörtel GP nach DIN EN 998-1
› Druckfestigkeitskategorie CS IV nach DIN EN 998-1
› Für innen und außen
› Verarbeitung mit Maschine oder von Hand
Diese Angaben sind Zirka-Werte und können je nach Art des Untergrundes abweichen.
Rissüberbrückende, mineralische und flexible Dichtschlämme als Putzabdichtung auf Außenputzen, die ins Erdreich einbinden. Als mineralische, rissüberbrückende Dichtschlämme (MDS) zur Anwendung nach DIN 18533 und als rissüberbrückende, mineralische Dichtschlämme (CM) zur Anwendung nach DIN 18534.
Details finden Sie im techn. Blatt P292a.de
Eigenschaften und Mehrwert
› Einkomponentige, zementgebundene Dichtschlämme

› Allgemeine bauaufsichtliche Prüfzeugnisse P-AB074-03 und 084-03
› Für innen und außen
› Wasserundurchlässig
› Hoch flexibel
› Rissüberbrückung bis 0,2 mm
› Überstreich- und überputzbar
› Streich- und spachtelfähig
› Lösemittelfrei
› Verarbeitung von Hand

Diese Angaben sind Zirka-Werte und können je nach Art des Untergrundes abweichen.
Schnell abbindender, hochergiebiger Kalk-Zement-Leichtunterputz mit organischen Leichtzuschlägen (EPS) für große Putzdicken im Innen- und Außenbereich. Geeignet als „spritzbare Vorwand” zur Überdeckung von Sanitärinstallationen in Bad, Küche, etc., als Fachwerk-Verfüllmörtel zum Ausspritzen von teilweise oder komplett entkernten Gefachen oder als schnellabbindender Schlitz- und Verfüllmörtel für die Verfüllung von Leitungsschlitzen, Deckendurchbrüchen etc.
Details finden Sie im techn. Blatt P264.de
Eigenschaften und Mehrwert
› Leichtputzmörtel LW nach DIN EN 998-1
› Druckfestigkeitskategorie CS II nach DIN EN 998-1
› Schnell abbindend
› Faserverstärkt
› Hohe Ergiebigkeit
› Hohe Auftragsdicken
› Für innen und außen
› Organischer (EPS) Leichtzuschlag
› Verarbeitung mit Maschine oder von Hand
Schnell erhärtender Zement-Haftputz zum Ansetzen von Putzprofilen und als Montagemörtel im Innenund Außenbereich. AM 300 eignet sich durch seine kurze Abbindezeit besonders für Kleinarbeiten oder als sogenannter Schnellzement zum Einmörteln von Haken, Gerüstverankerungen o. ä. im Außenbereich.
Details finden Sie im techn. Blatt P282.de
Eigenschaften und Mehrwert
› Druckfestigkeitskategorie CS IV nach DIN EN 998-1
› Für innen und außen
› Schnell abbindend
› Verarbeitung von Hand


› Witterungsbeständig
› Schnell erhärtend
› Feuchteunempfindlich, auch im Sockelbereich
Anputzleiste mit selbstklebendem PE-Dichtband und Schutzlasche für Abdeckfolie zur Herstellung sauberer und gerader Putzanschlüsse an Fenster und Türen. Als Anputz- und Schutzleiste für Innenputze.
Details finden Sie im techn. Blatt
Eigenschaften und Mehrwert
› Dauerhaft UV-beständige Bewegungsfuge
› Für Putzdicke bis 9 mm
› Kunststoff weiß
› Ohne Armiergewebe
› Optisch saubere Putzabschlüsse
Selbstklebendes, zweiteiliges Laibungsanschlussprofil mit gelochtem Einputzschenkel, einem starren Abziehstreifen und weißem PE-Schaumklebeband. Der gelochte Einputzschenkel mit Gewebestreifen verstärkt die Putzverkrallung.
Details finden Sie im techn. Blatt P632.de
Eigenschaften und Mehrwert
› Optisch ansprechender Putzanschluss (Schattenfuge)
› Dreidimensionale Bewegungsaufnahme
› Gewebebreite 120 mm
› Maschenweite 6 x 6 mm


Selbstklebendes, einteiliges Fensteranschlussprofil mit Dichtlippe für einen sauberen Anschluss an Fenster und Türen. Die Schlagregendichtheit wird ausschließlich durch ein zusätzliches Fugendichtband hergestellt. Die Schutzlippe schützt das PE-Dichtband und verdeckt die Fuge.
Details finden Sie im techn. Blatt P385a.de
Eigenschaften und Mehrwert
› Für Fenster- und Türgrößen ≤ 2,6 m²
› UV-beständige Schutzlippe
› Entspricht einer dauerelastischen Verfugung
› Mit leicht abziehbarer Schutzlasche
› Alkalibeständiges Armiergewebe mit Kunststoffschenkel verbunden
› Für Putzdicken von 6 bis 12 mm
Einsatz als Armiergewebe für Unterputze und Gewebearmierungen auf Altfassaden. Gewebe 20 cm über angrenzende Bauteile und 10 cm überlappend bei vollflächiger Armierung, oberflächennah einbetten.
Details finden Sie im techn. Blatt
Eigenschaften und Mehrwert
› Maschenweite 8 x 8 mm
› Flächengewicht ca. 210 g/m²

› Zugfestigkeit ca. 2,5 kN/5 cm
› Ca. 50 m²/Rolle
› Dauerhaft alkalibeständig
Oberputze von Knauf lassen Oberflächen in den unterschiedlichsten Strukturen erstrahlen und schützen die Bausubstanz. Verschiedene Möglichkeiten der Oberflächengestaltung geben jedem Bauvorhaben ein individuelles Profil. Das Ergebnis sind Oberflächen, die dem Anspruch an höchste Funktionalität und Ästhetik mühelos gerecht werden.

Bauen beschäftigt Menschen seit jeher. Sie schaffen und gestalten Lebensräume – mit dem Wunsch nach Funktion und Identität.
Hochwertige Putzsysteme von Knauf erfüllen diese Wünsche. Mit ausgezeichneter Verarbeitungsqualität, Langlebigkeit und in hohem Maße ökologischen und ökonomischen Eigenschaften.
Oberputze schützen die Fassade und zeichnen sich durch eine Vielfalt an Strukturen, Formen und Farben aus.
Ob Kratzputz, Scheibenputz, Rillenputz, Filzputz oder als freie Struktur – Ihrer individuellen Gestaltungsfreiheit sind keine Grenzen gesetzt.
Knauf Oberputze geben Fassaden und Innenräumen ein individuelles Profil und verbinden Funktion und Ästhetik ideal. Gleichzeitig schützen und sichern sie die vorhandene Bausubstanz und steigern deren Wert nachhaltig.
Gut zu wissen
Kalkhydrat und Zement als Bindemittel vieler Putze füllen nach der Zugabe von Wasser beim Erhärtungsprozess den Raum zwischen den Zuschlagkörnern aus. Gleichzeitig verdunstet das nicht benötigte Anmachwasser und der Putz verfestigt sich. Bei Silikatputzen kommt zusätzlich zum Verdunsten des Wassers die Verkieselung mit dem Untergrund hinzu. Bindemittel
Kalkhydrat und Zement als Bindemittel vieler Putze füllen nach der Zugabe von Wasser beim Erhärtungsprozess den Raum zwischen den Zuschlagkörnern aus. Gleichzeitig verdunstet das nicht benötigte Anmachwasser und der Putz verfestigt sich. Bei Silikatputzen kommt zusätzlich zum Verdunsten des Wassers die Verkieselung mit dem Untergrund hinzu.
Mineralische Putze bestehen aus hochwertigen mineralischen Rohstoffen und Bindemitteln auf Kalk- oder Kalk-Zement-Basis. Sie sind besonders langlebig und haben durch ihr feinporiges Kapillargefüge einen idealen Feuchtehaushalt. Wasseraufnahme- und Trocknungsverhalten sowie die Alkalität der mineralischen Bindemittel bieten den besten Schutz vor Algen- und Pilzbefall.
Silikatputze sind pastöse Putze mit einem mineralischen Charakter. Kaliwasserglas als mineralisches Hauptbindemittel in Verbindung mit einem geringen Dispersionsanteil sind die Grundlagen für eine hohe Wasserdampfdurchlässigkeit. Sie sind gut wasserabweisend und wie alle mineralischen Putze in mittelkräftigen bis pastellen Farbtönen einfärbbar.
Siliconharzputze vereinen die Vorteile mineralischer und dispersionsgebundener Systeme. Das Resultat ist ein Putz mit hoher Wasserdampfdurchlässigkeit und gleichzeitig einem schmutz- und wasserabweisenden Effekt. Mit Siliconharzputzen lassen sich attraktive farbige Akzente setzen.
Der Einlagen-Kratzputz wird direkt auf das entsprechend vorbehandelte Mauerwerk aufgetragen. Einlagen-Kratzputz ist Unter- und Oberputz in Einem. Die Endbearbeitung erfolgt, wie bei Kratzputzen üblich, durch das Kratzen. Er erfüllt dieselbe Funktion wie die eines mehrlagigen Außen-Putzsystems mit Unter- und Oberputz.
Farbpigmente sind feinteilige Farbpulver oder -pasten, die Oberputzen bei der Produktion im Herstellwerk zugemischt werden. Sie besitzen hohe Farbkraft. Deshalb reichen kleine Mengen aus, um den gewünschten Farbton zu erzielen.
Farbpigmente sind nicht wasserlöslich und werden beim Aushärten fest in den Putz eingebunden. Sie sind alkalibeständig, lichtecht, wetterfest und ökologisch unbedenklich.
In Kunstharzputzen sind über 80 % mineralische Bestandteile enthalten. Wasser bestimmt mit ca. 10 % Anteil die Konsistenz. Hauptbindemittel sind Dispersionen. Diese geben dem Putz seine Elastizität und Festigkeit und sind dadurch sehr widerstandsfähig. In puncto Farbtonvielfalt sind sie allen anderen Oberputzen überlegen. Intensive Farbtöne können perfekt realisiert werden.
Hauptbindemittel ist Kalkhydrat, welches in Verbindung mit Wasser nicht erhärtet und deshalb als verarbeitungsfertiger, pastöser Oberputz hergestellt werden kann. Durch die hohe Alkalität von Kalkhydrat können pastöse Kalkputze ohne Konservierungsstoffe hergestellt werden. Dank Zuführung eines weiteren mineralischen Bindemittels entsteht eine robuste widerstandsfähige Oberfläche. Durch die Kombination beider Bindemittel (Hybridbindemittel) entsteht ein feuchtigkeitsregulierender, hochabriebfester Oberputz.
NEU: Noblo Filz 1 in Scheibenputzstruktur Mit Noblo Filz 1 kann eine feine, dezente Scheibenputzstruktur mit 1 mm Körnung ausgeführt werden. Aufgebaut auf die jahrelange Erfahrung in der SM-Fasertechnologie ist eine zusätzliche Armierungsputzlage bei WARM-WAND Systemen nicht erforderlich. Noblo Filz 1 in Kornstärke auftragen, antrocknen lassen, nochmals in Kornstärke auftragen und anstatt mit der Schwammscheibe abzufilzen, mit der Plastiktraufel abscheiben.
Kleiner Unterschied in der Endbearbeitung – große Änderung der Oberflächenstruktur.
• geeignet
•• gut geeignet
••• sehr gut geeignet
Mineralische Außenputze schaffen Fassaden, die wirken. Fast unbegrenzt ist der Gestaltungsspielraum, der sich Planern, Architekten und Bauherren eröffnet. Unterschiedliche Farben, Strukturen und Verarbeitungsformen ermöglichen individuelle Akzente – zeitlos schön und mit exzellenter Ästhetik. Das Gleiche gilt auch für den Innenraum. Mineralische Innenputze bieten fast unendliche Gestaltungsmöglichkeiten und sorgen – je nach Struktur und Farbe – für besondere Raumatmosphäre. Pastöse, organisch vergütete Silikat- und
Siliconharzputze haben eine mikroporöse Oberfläche. Selbst der kleinste Wassertropfen hat keine Chance, den Putz zu durchdringen, da er rund 10.000 mal größer als die Mikroporen des Putzes ist. Von innen hingegen kann die Feuchtigkeit – die Wasserdampfmoleküle sind ca. 2.500 mal kleiner als die Mikroporen – leicht nach außen entweichen.
Farbiger Putz verdankt seine Farbe der Absorption von Licht. Der absorbierte Anteil wird in Wärme umgewandelt. Je dunkler der Putz ist, desto größer ist der absorbierte Anteil und desto stärker erwärmt sich der Putz im Sonnenlicht. Bei dunklem Putz sind an sonnigen Tagen Temperaturen von 60 Grad Celsius und darüber nicht ungewöhnlich, während weißer Putz sich nur unwesentlich erwärmt.

Filzstruktur
Die erste Lage volldeckend in Kornstärke auftragen und ansteifen lassen. Anschließend eine zweite Lage in Kornstärke auftragen und sofort, ohne Wasser, mit der Filz- oder Schwammscheibe abreiben/filzen.
Gekratzte Struktur
Nach dem Auftrag den Kratzputz im Kreuzgang verdichten, mit der Zahnkartätsche zuziehen und mit der Bodenlegertraufel zuglätten (Verminderung der Gefahr von Lufteinschlüssen). Evtl. entstandene Schwindrisse vor dem Kratzen zudrücken und verdichten/zuklopfen. Bei Erhärtungsbeginn, evtl. noch am gleichen, in der Regel aber am folgenden Tag kurze Unebenheiten per Ziehklinge begradigen und mit kreisrunden Bewegungen kratzen. Idealerweise sollte das Korn springen, wenn mit dem Kratzen begonnen wird. Sehr frühes Kratzen verursacht einen dunkleren Farbton und keine klare Struktur. Um witterungs- oder verarbeitungsbedingten Farbtonunterschie-
Pastöse Oberputze sind verarbeitungsfertig eingestellt. Der Eimerinhalt ist lediglich aufzurühren und bei Bedarf mit maximal 0,7 Liter Wasser auf Verarbeitungskonsistenz einzustellen. Sie sind nur auf vollständig ausgetrocknete, erhärtete und vorbehandelte Unterputze und Armiermörtellagen aufzutragen. Eine Vorbehandlung des Untergrundes ist für das Erreichen einer optimalen Produktqualität notwendig und für die Verarbeitung dringend zu empfehlen.
Mineralische Oberputze werden bei manueller Verarbeitung mit dem Mischquirl unter Zugabe von Wasser angerührt. Bei maschineller Verarbeitung erfolgt das Anmachen durch intensives Mischen in der Maschine. Die Wasserzugabe ist so zu regeln, dass die Konsistenz eine einwandfreie Verarbeitung zulässt. Nach dem Auftragen des Putzes kann dieser entsprechend seiner Eigenschaften unterschiedlich strukturiert werden.
den vorzubeugen, sind zusammenhängende Putzflächen immer ohne Unterbrechung von Ecke zu Ecke zu verputzen.
Freie Struktur
Zur Erstellung einer freien Struktur den Oberputz zunächst auf einer zusammenhängenden Fläche ca. 3 – 5 mm auftragen, mit der Kartätsche oder Glättkelle (Traufel) verziehen und sofort mit gewünschtem Werkzeug (Traufel, Kelle, Bürste, Rolle, etc.) strukturieren.
Scheibenputzstruktur
Den Scheibenputz mit einer rostfreien Stahltraufel vollflächig in Kornstärke aufziehen und unmittelbar nach dem Auftrag gleichmäßig und ohne Unterbrechung mit einer harten Kunststofftraufel (auch PVCTraufel, Moosgummi- oder Styroporbrett) rund abscheiben. Die Art des verwendeten Werkzeuges beeinflusst die Rauheit der Oberfläche, deshalb stets mit gleichen Strukturscheiben arbeiten.
Rillenstruktur
Mörtel auftragen, mit der Traufel/Glättkelle in Kornstärke verziehen und sofort mit gewünschtem Werkzeug (PVC-Reibebrett, Styroporbrett) strukturieren. Nass in nass arbeiten, angezogene Flächen nicht mehr nachreiben. Zusammenhängende Flächen sollten in einem Arbeitsgang fertiggestellt werden.
Zur Herstellung von feinen sandpapierartigen Oberflächen werden sehr feine Oberputze verwendet, die eventuell in drei Arbeitsgängen ausgeführt werden müssen. Die erste Lage ca. 2–3 mm dick auftragen, Grate entfernen und trocknen lassen. Nach Trocknung die zweite Lage in Kornstärke auftragen und nach Ansteifung nochmals in Kornstärke glatt überziehen.
Oberputze von Knauf sind sicher, dauerhaft und schön – passend zu jedem Stil und jeder Architektur. Mit besten Rezepturen, vielfältigen Körnungen und unverwechselbarer Optik.
Sie sind das perfekte Finish für jedes WARM-WAND System und lassen die gedämmte Fassade in den unterschiedlichsten Farben und Strukturen erstrahlen. Attraktive, hochwertige und langlebige Fassaden in edlem Weiß oder in vielen exquisiten Farbtönen lassen Raum für Kreativität und Individualität. Als Material aus rein natürlichen
Bestandteilen bieten Edelputze eine vielfältige Auswahl an Farbtönen. Bei eingefärbten Putzen sind lichtechte Farbpigmente Teil des Baustoffs – das garantiert lange Farbhaltbarkeit.
Je dunkler ein Farbton ist, umso stärker erwärmt sich der Putz im Sonnenlicht. Insofern ist bei Anwendung auf WDV-Systemen der Hellbezugswert eines Farbtons unbedingt zu beachten. Der kritische Bereich liegt bei Anwendung auf WDV-Systemen bei einem Hellbezugswert < 20. Bei niedrigeren Hellbezugswerten werden zusätzliche Maß-
• einfache Gewebearmierung
•• doppelte Gewebearmierung
nahmen wie beispielsweise eine doppelte Gewebearmierung notwendig. Bei Hellbezugswerten unter 20 ist auf WDV-Systemen der TSR-Wert maßgeblich.
Der Hellbezugswert ist eine bauphysikalische Kenngröße und gibt Auskunft über den Grad der Helligkeit und das Reflexionsvermögen eines Farbtons. Durch Umwandlung von Licht in Wärme wird die Fassade aufgeheizt. Je dunkler der Putz ist, desto stärker erwärmt er sich im Sonnenlicht.
••• nur Kleinflächen mit doppelter Gewebearmierung
Anfrage





Knauf MineralAktiv – eine neue Ära


Mit Knauf MineralAktiv beginnt eine neue Ära: Das wegweisende Putz-Farbe-System bewahrt Fassaden vor Algen und Pilzen –und das für lange Zeit. Auf mineralischer Basis. Und ohne biozide Filmkonservierer.
Pulver oder pastös – Sie haben die Wahl! Der pastöse MineralAktiv Scheibenputz wird verarbeitungsfertig in vier Körnungen im Eimer geliefert. MineralAktiv Scheibenputz Dry ist ein Pulverprodukt, das in zwei Körnungen angeboten wird.
Vorteile auf einen Blick:
› Hohe Schutzwirkung gegen Algen und Pilze für lange Zeit
› Ohne bioziden Fassadenschutz
› Keine Schadstoffauswaschung
› Wirtschaftliche Verarbeitung
› Farbe hochergiebig, schnell trocknend und regensicher
Der Dreifach-Fassadenschutz ohne biozide Filmkonservierer
Schutzfaktor 1: Dauerhafte Alkalität
Das innovative Bindemittel in Putz und Farbe sorgt zuverlässig und dauerhaft für bewuchsfeindliche Bedingungen. Und kommt dabei ohne schädliche Chemie aus. Das heißt: keine Auswaschung von Bioziden.
Schutzfaktor 2: Aqua-Reverse Feuchtemanagement Komplett wasserabweisend war gestern. Moderne Putz- und Beschichtungssysteme von Knauf funktionieren intelligenter: Regentropfen leitet die Fassade schnell ab. Und kleine Tropfen – z. B. während Tauphasen – werden kontrolliert aufgenommen und verdunsten kurz darauf. Somit fehlt Algen und Pilzen das für ihr Wachstum benötigte Wasser.
Schutzfaktor 3: IR-Rücktrocknung
In Tauphasen sind Fassaden oft über viele Stunden Feuchtigkeit ausgesetzt. Hier spielt die MineralAktiv Fassadenfarbe einen zusätzlichen Trumpf aus: Infrarotaktive Farbpigmente verwandeln Licht in Wärme und erhöhen so die Oberflächentemperatur der Fassade. Das verringert Tau-Niederschlag und beschleunigt die Rücktrocknung.
15 °C 10 °C 5 °C 0 °C
algenfeindliche Fassade mit MineralAktiv
MineralAktiv
Silikat
Siliconharz
Kunstharzdispersion
algenfeindliche Fassade mit MineralAktiv
MineralAktiv Fassade ohne IR-Absorber
Taupunkt

Der Einlagen-Kratzputz Knauf Presto One ist ein Edelputz, der sich durch effiziente und zeitsparende Verarbeitung auszeichnet. Seine Stärke zeigt der in dieser Form erste Einlagen-Kratzputz am deutschen Markt in seinem Einsatzbereich auf hochwärmedämmendem Mauerwerk (z. B. Ziegel-, Bims- und Leichtbetonmauerwerk und Porenbeton). Er ist widerstandsfähi-
ger Witterungsschutz für das Mauerwerk und hochattraktive Oberfläche. Da keine Standzeiten zu berücksichtigen sind, ist mit dem maschinell verarbeitbaren und auftragbaren Presto One eine schnelle und unterbrechungsfreie Baustellenabwicklung gewährleistet – bei gleichzeitig hoher optischer Qualität und leichter Handhabung beim Veredeln per Hand.
Silo statt Sack!
Noch mehr Effizienz bei größeren Mengen: Presto One ist auch im Silo inklusive Maschinentechnik erhältlich. Mehr unter www.knauf.de/logistik

Mehr Wirtschaftlichkeit
› Schnelle Baustellenabwicklung, da keine Standzeiten berücksichtigt werden müssen
› Einsparung eines ganzen Arbeitsschritts (Auftrag des Unterputzes)

› Geringe Rüstzeiten und kurze Arbeitsvorbereitung
› Verbesserte Personaleinsatzplanung durch unterbrechungsfreie Baustellenabwicklung
Dezent noble Oberflächen
Für die Putzstruktur eines Knauf Scheibenputzes wird ein Mörtel mit gebrochenem Strukturkorn mit einer Glättkelle aufgetragen, auf Kornstärke abgezogen und gerieben. Das Ergebnis ist eine verschmutzungsarme, ausgeprägte Struktur, die – je nach Korngröße – eine unterschiedliche Optik erzielt.
Beeindruckend vielfältig
Der Rillenputz ist eine Putzstruktur, für die ein Mörtel mit rundem Strukturkorn mit einer Glättkelle aufgetragen, scharf abgezogen und gerieben wird. So bildet sich eine mehr oder weniger ausgeprägte Rillenstruktur, die sich je nach Korngröße wesentlich voneinander unterscheidet. Ob senkrecht, waagerecht oder klassisch rund abgerieben – es entsteht stets ein anderer Eindruck.
Korn für Korn Sicherheit
Kratzputz ist ein klassischer Oberputz mit einer feinen bis groben Körnung. Es wird ein sehr eckiges Splittkorn eingesetzt, das sich durch eine Korn-an-Korn-Struktur auszeichnet. Nach dem Erhärten wird die Oberfläche mit einem Nagelbrett (Edelputzkratzer) ansatzlos und durchgehend gekratzt. Hierdurch entsteht die typische, edel anmutende Kratzputzstruktur.
Gestaltung mit persönlicher Note



Wer Ausgefallenes mag und etwas für besondere Strukturen übrig hat, entscheidet sich für den Modellierputz. Dieser wird in beliebiger Dicke aufgetragen und anschließend ganz nach Geschmack mit einer Kelle oder einem Spachtel frei strukturiert. Werden die strukturierten Flächen anschließend noch mit einer Quaste verbürstet, entsteht eine verwaschene Struktur.

Filzputz
Ästhetisch ansprechend
Wer ein dezentes Erscheinungsbild wünscht, ist mit einer gefilzten Putzstruktur bestens beraten. Er vermeidet eine völlig glatte Oberfläche und hält sich zugleich mit deren Strukturierung zurück. Ein Filzputz wird mit der Kelle oder einem Spachtel aufgetragen und mit einer Schwammscheibe abgefilzt. Dadurch wird das feine Strukturkorn an der Oberfläche sichtbar.
Glättputz
Eleganter Klassiker
Glatter Oberputz ist der Klassiker unter den Putzen. Mit ihm erzielt man besonders ebene, feine, sandpapierartige Oberflächen. Der auch als Glattputz bezeichnete Oberputz besteht aus sehr feinkörnigem Mörtel und wird fast strukturlos aufgezogen. Dies macht ihn zum idealen Putz für eine besonders edle, ruhige Optik.



Buntsteinputz
Robust und extravagant
Buntsteinputz ist widerstandsfähig, auch gegenüber Umweltschadstoffen und Mikroorganismen. In Kornstärke aufgetragen und mit der Traufel glattgezogen entstehen ausdrucksvolle Oberflächen mit Waschputzeffekt. Buntsteinputz ist witterungsbeständig, wasserdampfdiffusionsoffen, kratz- und stoßfest. Er ist ideal für Sockelflächen, Treppenhäuser und Hauseingänge.
Der Spritzputz ist eine Oberputzvariante, die mit Spritzgeräten aufgebracht wird. Dies erlaubt eine plastischere Art der Verarbeitung, als es manuell aufzutragende Putzarten zulassen. Charakteristisch für den Spritzputz ist sein gleichmäßiges Strukturbild, das ein harmonisches Ambiente erzeugt. Er kann rustikal grob oder dezent fein ausgeführt werden.

Lockere Streifenstruktur
Bei der Besenstrichtechnik wird zunächst SM700 Pro auf die ausgeführte Gewebearmierung aufgebracht und die Oberfläche anschließend mit einer Kartätsche eingeebnet. Die typische Struktur liefert schließlich ein Besen mit kräftigen Borsten.
Geordnete Bahnen
Je nach Belieben kann mit halbrunder oder eckiger Spachtelzahnung gearbeitet werden, wobei deren maximale Breite 15 mm beträgt. Um ein optimales Ergebnis zu erzielen, wird SM700 Pro in der von der Schablone vorgegebenen Breite und Schichtstärke aufgetragen und in einem Zug von unten nach oben über die gesamte Fläche gezogen.
Um eine ansprechende Betonoptik zu erzielen, wird nach dem Auftragen von SM700 Pro am besten mit einem sandgestrahlten Schalbrett gearbeitet, das vorher mit einem 2-Komponenten-Lack lackiert wurde. Die gesamte Fläche mit diesem „stempeln“ und jeweils mit einem Gummihammer leicht anklopfen.



Die Herstellung verschiedener Putzstrukturen und andere hilfreiche Tipps zeigt die Knauf Akademie in unserem neuen Format Knauf Tipp-Clips. Diese finden Sie auf dem Knauf YouTube-Channel unter www.youtube.de/knaufgipskg


Als Voranstrich für die einzelnen Butz-Farbtöne empfehlen wir einen eingefärbten Quarzgrund in den folgenden Farben:


Vorbehandlungen
Gipsputze
Spachtel pastös
Kalkputze
Unterputze
Oberputze
Sanierung
Dämmschüttungen
Innendämmung
WARM-WAND Dämmstoffe
WARM-WAND Klebe- und Armiermörtel
WARM-WAND Zubehör
AQUAPANEL® VHF
Gestaltungselemente
Farben
Oberputze
Innenputze
Scheibenputze
Rillenputze
Modellierputz
Kratzputze
Filz- und Feinputze
Buntsteinputze
Mineralischer Kalk-Spritzputz mit feuchtigkeitsregulierender Wirkung für den Innenbereich. Raumklima Spritzputz sorgt in der Körnung 1,0 mm für schön strukturierte und extrem widerstandsfähige Oberflächen. Durch die Alkalität schützen Raumklima Beschichtungen wirksam und lange Zeit vor Schimmel.


Details finden Sie im techn. Blatt P519b.de
Eigenschaften und Mehrwert
› Für den Innenbereich
› Verarbeitungsfertig
› Feuchtigkeitsregulierend
› Hoch diffusionsoffen
› Hoch abriebfest
› Sehr emissionsarm
› Ohne Konservierungsmittel und frei von Lösemitteln, Weichmachern und fogging-aktiven Substanzen
› Glanzgrad: stumpfmatt
› Farbton weiß (ca. RAL 9016)
› Eingeschränkt tönbar nach Farbtonfächer Knauf ColorConcept
Diese Angaben sind Zirka-Werte und können je nach Art des Untergrundes abweichen.
Mineralischer Kalk-Oberputz mit feuchtigkeitsregulierender Wirkung für den Innenbereich. Raumklima Scheibenputze sorgen in der Körnung 1,0 und 1,5 mm für schön strukturierte und extrem widerstandsfähige Oberflächen. Durch die Alkalität schützen Raumklima Beschichtungen wirksam und lange Zeit vor Schimmel.
Details finden Sie im techn. Blatt P519a.de
Eigenschaften und Mehrwert
› Pastöser Oberputz nach EN 15824
› Für den Innenbereich
› Feuchtigkeitsregulierend
› Hoch diffusionsoffen
› Hoch abriebfest
› Sehr emissionsarm
› Ohne Konservierungsmittel und frei von Lösemitteln, Weichmachern und fogging-aktiven Substanzen
› Glanzgrad: stumpfmatt
› Farbton weiß (ca. RAL 9016)
› Eingeschränkt tönbar nach Farbtonfächer Knauf ColorConcept
Diese Angaben sind Zirka-Werte und können je nach Art des Untergrundes abweichen.
Marmor-Edelputz als feiner Scheibenputz zur Herstellung dekorativer, feinstrukturierter Oberflächen auf Innenwandflächen. In Verbindung mit Rotkalk Grund oder Rotkalk Fein speziell geeignet, wo hohe bauphysikalische Ansprüche an die Raumhygiene, Raumluft und die Wohnqualität gestellt werden.
Details finden Sie im techn. Blatt P207.de
Eigenschaften und Mehrwert
› Edelputzmörtel CR nach DIN EN 998-1
› Druckfestigkeitskategorie CS I nach DIN EN 998-1
› Beeinflusst das Raumklima positiv
› Feuchtigkeitsregulierend und diffusionsoffen
› Für den Innenbereich
› Verarbeitung mit Maschine oder von Hand
› Farbton weiß (ca. RAL 9016)
› Eingeschränkt tönbar nach Farbtonfächer
Knauf ColorConcept
Diese Angaben sind Zirka-Werte und können je nach Art des Untergrundes abweichen.
Marmor-Edelputz als feinster Filzputz oder mit freier Struktur zur Herstellung dekorativer, feinstrukturierter Oberflächen auf Innenwandflächen. In Verbindung mit Rotkalk Grund oder Rotkalk Fein speziell geeignet, wo hohe bauphysikalische Ansprüche an die Raumhygiene, Raumluft und die Wohnqualität gestellt werden.
Details finden Sie im techn. Blatt P204.de
Eigenschaften und Mehrwert
› Edelputzmörtel CR nach DIN EN 998-1


› Druckfestigkeitskategorie CS I nach DIN EN 998-1
› Beeinflusst das Raumklima positiv
› Für den Innenbereich
› Feuchtigkeitsregulierend und diffusionsoffen
› Verarbeitung mit Maschine oder von Hand
› Farbton weiß (ca. RAL 9016)
› Eingeschränkt tönbar nach Farbtonfächer Knauf ColorConcept
Diese Angaben sind Zirka-Werte und können je nach Art des Untergrundes abweichen.
Mineralischer Edelputz mit glatter Oberflächenstruktur zur Gestaltung feindekorativer Oberputze, z. B. als feine sandpapierartige Oberfläche mit Rotkalk Schwammscheibe Fein strukturiert, in Kellenstrichtechnik mit Glättkelle oder Spachtel, als Roll- und Patschputz, strukturiert mit Rolle oder Schwammscheibe oder als strukturlos zugezogener, spachtelartiger Glattputz.
Details finden Sie im techn. Blatt P532a.de
Eigenschaften und Mehrwert
› Edelputzmörtel CR nach DIN EN 998-1
› Druckfestigkeitskategorie CS II nach DIN EN 998-1
› Für den Innenbereich
› Wasserabweisend
› Verarbeitung von Hand
› Körnung 0,6 mm
› Farbton weiß (ca. RAL 9016)
› Eingeschränkt tönbar nach Farbtonfächer
Knauf ColorConcept
› Auf Wunsch mit erhöhtem Glimmerzusatz
Diese Angaben sind Zirka-Werte und können je nach Art des Untergrundes abweichen.
Mineralischer, feinkörniger Oberputz für dezent gefilzte Oberflächen. Besonders als Filzputz auf Kalkund Kalk-Zementputzen im Innen- und Außenbereich geeignet. Im Außenbereich ist eine zusätzliche Armierungsputzlage auszuführen.
Details finden Sie im techn. Blatt P538.de
Eigenschaften und Mehrwert
› Edelputzmörtel CR nach DIN EN 998-1


› Druckfestigkeitskategorie CS II nach DIN EN 998-1
› Für innen und außen
› Wasserabweisend
› Verarbeitung mit Maschine oder von Hand
› Brandverhalten A1
› Körnung 1,0 mm
› Farbton weiß (ca. RAL 9001)
› Diffusionsoffen
Diese Angaben sind Zirka-Werte und können je nach Art des Untergrundes abweichen.
Mineralischer, feinkörniger Oberputz zur Herstellung dezent gefilzter oder frei strukturierter Oberflächen im Innenbereich. Im Außenbereich als gefilzte Oberfläche im Bereich von Faschen und Fensterlaibungen, die zusätzlich mit einem zweifachen Anstrich versehen werden müssen.
Besonders als Filzputz auf Kalk- und Kalk-Zementputzen für Anforderungen der Qualitätsstufe Q2 - Q4 gefilzt geeignet (Merkblatt „Putzoberflächen im Innenbereich“, herausgegeben vom Deutschen Stuckgewerbebund).
Details finden Sie im techn. Blatt P538a.de
Eigenschaften und Mehrwert
› Druckfestigkeitskategorie CS II nach DIN EN 998-1
› Für den Innenbereich
› Wasserabweisend
› Verarbeitung mit Maschine oder von Hand
› Brandverhalten A1
› Körnung 0,6 mm
› Farbton weiß (ca. RAL 9001)
› Diffusionsoffen
› Feine, sandpapierartig gefilzte Oberfläche
Diese Angaben sind Zirka-Werte und können je nach Art des Untergrundes abweichen.
Im System mit MineralAktiv Fassadenfarbe bietet der mineralische Scheibenputz auf natürliche Weise höchsten Schutz vor Algen- und Pilzbefall und trägt so für lange Zeit zum Erhalt makelloser Fassaden bei. Der mineralische MineralAktiv Scheibenputz Dry ist dabei biozidfrei und überzeugt zudem durch eine edle Struktur.
Details finden Sie im techn. Blatt P277b.de
Eigenschaften und Mehrwert
› Hoch diffusionsoffen
› Für innen und außen
› Hohe Witterungsbeständigkeit
› Verarbeitung mit Maschine oder von Hand
› Farbton weiß (ca. RAL 9003)
› Optimiertes Feuchtemanagement zur Algen- und Pilzprävention
› Eingeschränkt tönbar nach Farbtonfächer Knauf ColorConcept

Diese Angaben sind Zirka-Werte und können je nach Art des Untergrundes abweichen.

Mineralischer Edelputz mit Scheibenputzstruktur in 2, 3 oder 5 mm Korngröße. SP 260 Pro zeichnet sich durch ein Top-Strukturbild und einfache Verarbeitungseigenschaften aus. SP 260 Pro lässt sich leicht auf- und verziehen. Auch das Strukturieren geht einfach, schnell und gleichmäßig.
Durch Abreiben mit einer PVC- oder rostfreien Stahltraufel wird eine dezente bis rustikale Oberflächenstruktur erreicht. Mit der Schwammscheibe wird die Struktur noch rustikaler bzw. rauer.
Details finden Sie im techn. Blatt P277c.de
Eigenschaften und Mehrwert
› Druckfestigkeitskategorie CS II nach DIN EN 998-1
› Für innen und außen
› Wasserabweisend
› Verarbeitung mit Maschine oder von Hand
› Brandverhalten A1
› Körnung 2 / 3 / 5 mm
› Farbton weiß (ca. RAL 9016)
› Eingeschränkt tönbar nach Farbtonfächer Knauf ColorConcept
Diese Angaben sind Zirka-Werte und können je nach Art des Untergrundes abweichen.

Im System mit MineralAktiv Fassadenfarbe bietet der mineralische Scheibenputz auf natürliche Weise höchsten Schutz vor Algen- und Pilzbefall und trägt so für lange Zeit zum Erhalt makelloser Fassaden bei - ohne bioziden Fassadenschutz. MineralAktiv Scheibenputz überzeugt zudem durch eine edle Struktur und ist verarbeitungsfertig im Eimer.
Details finden Sie im techn. Blatt P239m.de
Eigenschaften und Mehrwert
› Verarbeitungsfertig
› Für innen und außen
› Hoch diffusionsoffen
› Hohe Witterungsbeständigkeit
› Verarbeitung mit Maschine oder von Hand
› Farbton weiß (ca. RAL 9010)
› Eingeschränkt tönbar nach Farbtonfächer
Knauf ColorConcept

› Ohne biozide Filmkonservierung
› A2-s1, d0
Diese Angaben sind Zirka-Werte und können je nach Art des Untergrundes abweichen.
Mineralischer Edelputz mit Marmorkorn in Scheibenputzstruktur für dezent-noble Oberflächen in 1,5 sowie 2 und 3 mm Korngröße. Durch unterschiedliches Werkzeug und Bearbeitung lassen sich beliebige, richtungsfreie Strukturen ausführen.
Details finden Sie im techn. Blatt P561.de
Eigenschaften und Mehrwert
› Druckfestigkeitskategorie CS II nach DIN EN 998-1
› Für innen und außen
› Wasserabweisend
› Verarbeitung mit Maschine oder von Hand
› Brandverhalten A1
› Körnung 1,5 / 2 / 3 mm
› Farbton weiß (ca. RAL 9003)
› Eingeschränkt tönbar nach Farbtonfächer Knauf ColorConcept
› Leicht strukturierbar
Diese Angaben sind Zirka-Werte und können je nach Art des Untergrundes abweichen.
Verarbeitungsfertig eingestellter, pastöser, verschmutzungsarmer Siliconharz-Scheibenputz mit hoher Wasserabweisung und hoher Wasserdampfdiffusion.
Bei nasskalter Witterung kann eine Zugabe mit dem Verfilmungsbeschleuniger TS Mix erfolgen, um so eine schnellere Standfestigkeit zu erzielen.
Details finden Sie im techn. Blatt P238.de
Eigenschaften und Mehrwert
› Verarbeitungsfertig
› Hoch diffusionsoffen
› Hohe Witterungsbeständigkeit
› Verschmutzungsarm
› Hoch wasserabweisend
› Für außen
› Farbton weiß (ca. RAL 9010)
› Tönbar nach Farbtonfächer Knauf ColorConcept


› A2-s1, d0
Diese Angaben sind Zirka-Werte und können je nach Art des Untergrundes abweichen.
Verarbeitungsfertig eingestellter, mineralischer Silikat-Scheibenputz mit max. 5 % organischem Anteil, mit hoher Wasserabweisung und sehr hoher Wasserdampfdiffusion.
Details finden Sie im techn. Blatt P239.de
Eigenschaften und Mehrwert
› Pastöser Oberputz nach EN 15824
› Verarbeitungsfertig
› Hohe Witterungsbeständigkeit
› Verschmutzungsarm
› Diffusionsoffen
› Wasserabweisend
› Verzögernd und vorbeugend gegen Algen und Pilze
› Für außen
› Farbton weiß (ca. RAL 9010)
› Eingeschränkt tönbar nach Farbtonfächer
Knauf ColorConcept


Diese Angaben sind Zirka-Werte und können je nach Art des Untergrundes abweichen.
Verarbeitungsfertig eingestellter, pastöser, organisch-gebundener und siliconharzverstärkter Scheibenputz für intensive Farbtöne. Sehr strapazierfähig, wasserabweisend und wasserdampfdurchlässig.
Bei nasskalter Witterung kann eine Zugabe mit dem Verfilmungsbeschleuniger TS Mix erfolgen, um so eine schnellere Standfestigkeit zu erzielen.
Details finden Sie im techn. Blatt P237.de
Eigenschaften und Mehrwert
› Verarbeitungsfertig
› Intensivste Farbtönung
› Hoch diffusionsoffen
› Hohe Witterungsbeständigkeit
› Verschmutzungsarm
› Wasserabweisend
› Für außen
› Farbton weiß (ca. RAL 9010)
› Tönbar nach Farbtonfächer Knauf ColorConcept
› A2-s1, d0
Diese Angaben sind Zirka-Werte und können je nach Art des Untergrundes abweichen.
TS Mix ist ein Verfilmungsbeschleuniger zur nachträglichen Ausrüstung der pastösen Oberputze Addi S und Conni S. Dadurch erreichen die Materialien bei nasskalten Witterungsverhältnissen eine schnellere Standfestigkeit.
Details finden Sie im techn. Blatt B103.de
Mineralischer Edelputz mit Rillenstruktur in 2 oder 5 mm Korngröße zur Herstellung von horizontal, vertikal bzw. rund geriebener Rillenstruktur, Roll- oder Patschputz oder mit der Glättkelle gedrücktem Kellenstrich.
Details finden Sie im techn. Blatt P276a.de
Eigenschaften und Mehrwert
› Verarbeitungsfertig zum Einrühren
› Für außen
› Hohe Witterungsbeständigkeit
› Keine Veränderung der Produkteigenschaften
› Farblos
› Schnellere Standsicherheit bei nasskalter Witterung
Eigenschaften und Mehrwert
› Druckfestigkeitskategorie CS II nach DIN EN 998-1
› Für innen und außen
› Wasserabweisend
› Verarbeitung mit Maschine oder von Hand
› Brandverhalten A1
› Farbton weiß (ca. RAL 9016)
› Eingeschränkt tönbar nach Farbtonfächer Knauf ColorConcept

Diese Angaben sind Zirka-Werte und können je nach Art des Untergrundes abweichen.

Mak3 ist ein klassischer mineralischer Edelkratzputz in 2, 3 und 4 mm Korngröße mit Glimmeranteil. Mak3 wird ca. 15 mm dick aufgetragen und nach genügend Erhärtung mit einem Kratzputz-Nagelbrett auf Enddicke ca. 10 mm gekratzt. Dabei wird die bindemittel- und spannungsreiche Oberfläche des angetragenen Oberputzes entfernt. Durch das herausspringende Korn entsteht die hierfür charakteristische, gleichmäßige Kratzputzstruktur. Mak3 bietet den besten Witterungsschutz und weist durch seine Oberfläche einen Selbstreinigungseffekt auf. Mak3 ist ideal für den Einsatz auf Unterputzen mit einer zusätzlichen Armierungslage und WARM-WAND Systemen.
Details finden Sie im techn. Blatt P272.de
Eigenschaften und Mehrwert
› Für außen
› Wasserabweisend
› Glimmeranteil
› Brandverhalten A1
› Verarbeitung mit Maschine
› Körnung 2 / 3 / 4 mm
› Farbton naturweiß (ca. RAL 9001) bei 2 / 3 / 4 mm Körnung, Körnung 2 / 3 mm mit Marmorkorn, weiß (ca. RAL 9016)

› Auf Wunsch mit erhöhtem Glimmerzusatz
› Eingeschränkt tönbar nach Farbtonfächer Knauf ColorConcept
Diese Angaben sind Zirka-Werte und können je nach Art des Untergrundes abweichen.
Mineralischer Kratzputz in 1,5 mm Korngröße als klassischer Einlagen-Kratzputz auf hochwärmedämmendes Mauerwerk. Die Edelkreidung sorgt dabei für einen Selbstreinigungseffekt und das Feuchtemanagement wirkt auf natürliche Weise vorbeugend gegen Algen und Pilze. Presto One ist rein mineralisch, spannungsarm und tönbar.
Details finden Sie im techn. Blatt P271d.de
Eigenschaften und Mehrwert
› Einlagenputzmörtel OC nach DIN 998-1
› Druckfestigkeitskategorie CS II nach DIN EN 998-1
› Für außen
› Erfüllt die typischen Kennwerte eines Leichtputz Typ II
› Wasserabweisend
› Verarbeitung mit Maschine
› Eingeschränkt tönbar nach Farbtonfächer Knauf ColorConcept
Diese Angaben sind Zirka-Werte und können je nach Art des Untergrundes abweichen.
Mineralischer, feinkörniger Oberputz mit 1 mm oder 1,5 mm Marmorkörnung für dezent gefilzte Oberflächen. Als feiner Scheibenputz mit 1 mm Körnung sowie als Modellierputz zur Herstellung vielfältig strukturierter oder verbürsteter Oberputzstrukturen im Innen- und Außenbereich. Aufgebaut auf die jahrelange Erfahrung in der SM-Technologie bietet die spezielle Faserverstärkung dabei die höchste Sicherheit.
Details finden Sie im techn. Blatt P561f.de
Eigenschaften und Mehrwert
› Druckfestigkeitskategorie CS II nach DIN EN 998-1
› Hohe Scherzugfestigkeit durch Zusatz von Spezialfasern
› Für innen und außen
› Wasserabweisend
› Verarbeitung mit Maschine oder von Hand
› Körnung 1 / 1,5 mm
› Farbton weiß (ca. RAL 9003)
› Eingeschränkt tönbar nach Farbtonfächer Knauf ColorConcept

Diese Angaben sind Zirka-Werte und können je nach Art des Untergrundes abweichen.

Mineralischer Edelputz mit glatter Oberflächenstruktur zur Gestaltung feindekorativer Oberputze, z. B. als feine sandpapierartige Oberfläche mit Rotkalk Schwammscheibe Fein strukturiert, in Kellenstrichtechnik mit Glättkelle oder Spachtel, als Roll- und Patschputz, strukturiert mit Rolle oder Schwammscheibe oder als strukturlos zugezogener, spachtelartiger Glattputz.
Details finden Sie im techn. Blatt P532a.de
Eigenschaften und Mehrwert
› Edelputzmörtel CR nach DIN EN 998-1
› Druckfestigkeitskategorie CS II nach DIN EN 998-1
› Für den Innenbereich
› Wasserabweisend
› Verarbeitung von Hand
› Körnung 0,6 mm
› Farbton weiß (ca. RAL 9016)
› Eingeschränkt tönbar nach Farbtonfächer
Knauf ColorConcept
› Auf Wunsch mit erhöhtem Glimmerzusatz
Diese Angaben sind Zirka-Werte und können je nach Art des Untergrundes abweichen.
Mineralischer, feinkörniger Oberputz für dezent gefilzte Oberflächen. Besonders als Filzputz auf Kalkund Kalk-Zementputzen im Innen- und Außenbereich geeignet. Im Außenbereich ist eine zusätzliche Armierungsputzlage auszuführen.
Details finden Sie im techn. Blatt P538.de
Eigenschaften und Mehrwert
› Edelputzmörtel CR nach DIN EN 998-1


› Druckfestigkeitskategorie CS II nach DIN EN 998-1
› Für innen und außen
› Wasserabweisend
› Verarbeitung mit Maschine oder von Hand
› Brandverhalten A1
› Körnung 1,0 mm
› Farbton weiß (ca. RAL 9001)
› Diffusionsoffen
Diese Angaben sind Zirka-Werte und können je nach Art des Untergrundes abweichen.
Mineralischer, feinkörniger Oberputz zur Herstellung dezent gefilzter oder frei strukturierter Oberflächen im Innenbereich. Im Außenbereich als gefilzte Oberfläche im Bereich von Faschen und Fensterlaibungen, die zusätzlich mit einem zweifachen Anstrich versehen werden müssen.
Besonders als Filzputz auf Kalk- und Kalk-Zementputzen für Anforderungen der Qualitätsstufe Q2 - Q4 gefilzt geeignet (Merkblatt „Putzoberflächen im Innenbereich“, herausgegeben vom Deutschen Stuckgewerbebund).
Details finden Sie im techn. Blatt P538a.de
Eigenschaften und Mehrwert
› Druckfestigkeitskategorie CS II nach DIN EN 998-1
› Für den Innenbereich
› Wasserabweisend
› Verarbeitung mit Maschine oder von Hand
› Brandverhalten A1
› Körnung 0,6 mm
› Farbton weiß (ca. RAL 9001)
› Diffusionsoffen
› Feine, sandpapierartig gefilzte Oberfläche
Diese Angaben sind Zirka-Werte und können je nach Art des Untergrundes abweichen.
Marmor-Edelputz als feinster Filzputz oder mit freier Struktur zur Herstellung dekorativer, feinstrukturierter Oberflächen auf Innenwandflächen. In Verbindung mit Rotkalk Grund oder Rotkalk Fein speziell geeignet, wo hohe bauphysikalische Ansprüche an die Raumhygiene, Raumluft und die Wohnqualität gestellt werden.
Details finden Sie im techn. Blatt P204.de
Eigenschaften und Mehrwert
› Edelputzmörtel CR nach DIN EN 998-1


› Druckfestigkeitskategorie CS I nach DIN EN 998-1
› Beeinflusst das Raumklima positiv
› Für den Innenbereich
› Feuchtigkeitsregulierend und diffusionsoffen
› Verarbeitung mit Maschine oder von Hand
› Farbton weiß (ca. RAL 9016)
› Eingeschränkt tönbar nach Farbtonfächer
Diese Angaben sind Zirka-Werte und können je nach Art des Untergrundes abweichen.
Marmor-Edelputz als feiner Filzputz oder mit freier Struktur zur Herstellung dekorativer, feinstrukturierter Oberflächen auf Innen- und Außenwandflächen oberhalb des Spritzwasserbereichs. In Verbindung mit Rotkalk Grund oder Rotkalk Fein speziell geeignet, wo hohe bauphysikalische Ansprüche an die Raumhygiene, Raumluft und die Wohnqualität gestellt werden.
Details finden Sie im techn. Blatt P204b.de
Eigenschaften und Mehrwert
› Edelputzmörtel CR nach DIN EN 998-1

› Druckfestigkeitskategorie CS I nach DIN EN 998-1
› Beeinflusst das Raumklima positiv
› Für innen und außen
› Verarbeitung mit Maschine oder von Hand
› Farbton weiß (ca. RAL 9016)
› Feuchtigkeitsregulierend und diffusionsoffen
Diese Angaben sind Zirka-Werte und können je nach Art des Untergrundes abweichen.
Systemgeprüfter, mineralischer, universeller Alleskönner für die Fassade und den Sockel. SM700 Pro eignet sich insbesondere für das Verkleben und Armieren aller Knauf WARM-WAND Systeme. Die spezielle Faserverstärkung bietet dabei höchste Sicherheiten. SM700 Pro kann naturweiß oder eingefärbt als Oberputz gefilzt oder frei strukturiert werden. Auch als universeller Renoviermörtel zur Überarbeitung von Putzen und Fassaden ist SM700 Pro bestens geeignet. Für besondere Highlights an der Fassade kann SM700 Pro auch in Besenstrich-, Kammzugtechnik, Betonoptik oder sonstigen Oberputzstrukturen aufgebracht werden.

Details finden Sie im techn. Blatt P241c.de
Eigenschaften und Mehrwert
› Normalputzmörtel GP nach DIN EN 998-1
› Druckfestigkeitskategorie CS III nach DIN EN 998-1
› Faser- und Haftzusatz
› Sehr hoch wasserabweisend
› Sehr hohe Klebekraft
› Diffusionsoffen
› Körnung 1,0 mm
› Farbton weiß (ca. RAL 9001)
› Eingeschränkt tönbar nach Farbtonfächer Knauf ColorConcept
Diese Angaben sind Zirka-Werte und können je nach Art des Untergrundes abweichen.

Buntsteinputz mit Waschputzeffekt für die Oberflächengestaltung an stark beanspruchten Bereichen wie Sockelflächen im Spritzwasserbereich, in Treppenhäusern, Fluren und Eingangsbereichen etc.
Details finden Sie im techn. Blatt P234a.de
Eigenschaften und Mehrwert
› Für innen und außen
› Verarbeitungsfertig
› Wasserabweisend
› Diffusionsoffen
› Dauerhafter Schlagregenschutz
› Kratz- und stoßfest
› Verarbeitung von Hand
Diese Angaben sind Zirka-Werte und können je nach Art des Untergrundes abweichen.

Historische Bauwerke – ob denkmalgeschützt aus dem 17. Jahrhundert oder aus den 50er-Jahren des letzten Jahrhunderts – sind wertvolle und langlebige Kulturgüter, die für das Erscheinungsbild eines Landes oder einer Region prägend sind. Gleichzeitig ist deren Erhalt mit gewissen Herausforderungen verbunden.
Saniersysteme von Knauf bieten für jedes Problem die richtige und vor allem nachhaltige Lösung.
Gestiegene Anforderungen an den Wohnraum, aktualisierte Auflagen an den Energiehaushalt oder die Steigerung der Attraktivität eines Gebäudes sind häufig Anlass für eine Sanierung. Aber sie stellen an die Bauherren auch besondere Anforderungen, da sanierungsbedürftige Gebäude in den häufigsten Fällen umfassende Instandsetzungs- und Modernisierungsaufgaben nach sich ziehen, um sie aufzuwerten und langfristig nutzbar zu gestalten. Eine weitere Herausforderung ist die gelungene Verbindung von alt und neu – innen wie außen.
Die Sanierung von Einfamilienhäusern, Mehrfamilienhäusern oder historischen Gebäuden erfordert häufig objektspezifische Saniermethoden und ineinandergreifende, umfassende Lösungen mit speziell darauf abgestimmten Knauf Sanierprodukten. Vor der Erarbeitung und Realisierung eines Maßnahmenpakets kommt die Schadensanalyse und Salzbestimmung. Das ist perfekte, dauerhafte Sanierung.

Die Saniersysteme Popo und Stens sind WTA 2-9; Ausgabe 03/2020/D zertifiziert. Die WTA ist die WirtschaftlichTechnische Arbeitsgemeinschaft für Bauwerkserhaltung und Denkmalpflege. In einem intensiven Austausch von Praktikern und Wissenschaftlern werden Richtlinien und Merkblätter für die Instandsetzung von Gebäuden im Bestand und zur Sanierung und Restaurierung der historischen Bausubstanz erarbeitet.
Woran erkennt man, dass ein Mauerwerk salzbelastet ist?
Insbesondere bei älteren oder historischen Bauwerken treten Salze im Mauerwerk sehr häufig auf. Sie sind in den meisten Fällen anhand weißer Ausblühungen oder Feuchtigkeitsanreicherung bereits visuell erkennbar und führen zu Schäden am Mauerwerk sowie am Putz- und Anstrichsystem.
Wie gelangen Salze in das Mauerwerk?
Auf mineralischen Untergründen treten am häufigsten die bauschädlichen Sulfatsalze, Chloridsalze und Nitratsalze auf. Sulfatsalze gelangen meist aufgrund fehlender Horizontalsperren durch aufsteigende Feuchtigkeit in das Mauerwerk. Die im Wasser gelösten Salze werden durch Kapillarkräfte im Porengefüge des Mauerwerks transportiert. An der Oberfläche verdunstet das Wasser und die Salze kristallisieren aus, wobei sie ihr Volumen erheblich vergrößern. Der dadurch entstehende Kristallisationsdruck zerstört letztlich den Baustoff.
Im Sockelbereich können sich auch Chloridsalze ablagern, die durch den Einsatz von Streusalzen gegen Eis und Schnee in das Mauerwerk gelangen.
Nitratsalze stehen häufig im Zusammenhang mit Ställen, Jauche- und Mistgruben. Sie entstehen durch die Reaktion von Kalk, Harnstoff und Ammoniak.
Welche Maßnahmen sind erforderlich, um salzbelastete Flächen langfristig zu beheben? Damit die richtige Saniermaßnahme ausgeführt werden kann, ist zunächst eine genaue Schadensanalyse ratsam. Dabei sollte insbesondere die Feuchtigkeitsquelle erkannt und abgestellt werden.
Häufig werden salzbelastete Flächen nicht mit den eigentlichen erforderlichen Maßnahmen behandelt, sondern aus Kostengründen lediglich mit einem neuen Anstrich „saniert“. Dabei ist allerdings zu beachten, dass salzbelastete Flächen kein geeigneter Untergrund für Beschichtungen sind und keine Gewährleistung für die Haltbarkeit gegeben ist. Langanhaltende Erfolge mit trockenen und ästhetischen Flächen werden mit perfekt aufeinander abgestimmten Sanierungskonzepten und geprüften Saniersystemen wie den Sanierputzsystemen Knauf Popo und Stens erreicht.
Wie funktionieren Sanierputze?
Durch ihren hohen Porenanteil sind Sanierputzsysteme hocheffizient gegen feuchte Wände, besonders im Sockel- und Kellerbereich. Sanierputze nehmen aufgrund ihres speziellen Gefüges Feuchtigkeit und die darin gelösten Salze auf, lagern die Salze in den Poren ein und halten sie langfristig von der Putzoberfläche fern. Die Salze kristallisieren bei Trocknung aus und die Feuchtigkeit wandert als Wasserdampf durch den Putz an die Oberfläche. Entscheidend dabei sind die Luftporen im Putz. In diesen Poren findet die Kristallisation statt. So werden die Salze unschädlich gemacht und der Putz bleibt an der Oberfläche langfristig trocken. Sanierputze haben einen Luftporengehalt von über 25 % und eine hohe Porosität von über 40 % des Festmörtelgefüges.
Was ist das Besondere an Popo?
Beim Verputzen von Kellerräumen ist darauf zu achten, dass die Raumfeuchte (relative Luftfeuchtigkeit < 65 %) abgeführt wird und somit eine Austrocknung des Putzes unterstützt wird. Kann dies nicht gewährleistet werden, besteht die Gefahr einer beschleunigten Salzeinwanderung und des Durchschlagens der Salze bis an die Putzoberfläche.
Der Sanierputz mit der patentierten, selbstaktiven Porenstruktur Popo wächst an der Wand um 30 %. 16 mm auftragen und auf 20 mm wachsen lassen. Das spart Zeit, Material und ist daher äußerst wirtschaftlich.


Was tun, wenn Sanierputze nicht mehr ausreichen?
Wo selbst hervorragende Sanierputze am Ende ihrer Leistungsfähigkeit sind, fängt die Satt Platte gerade mal an: die Sanierplatte, die auch höchster Beanspruchung Paroli bietet. Die Oberfläche bleibt trocken, auch dort, wo man nicht mehr ans Fundament kann, wo Sulfat- und Nitratbelastungen vorliegen, bei Kellergewölben und ehemaligen Stallungen. Eine Aufgabe bleibt jedoch: Feuchte Luft aus dem Raum abführen!
Sanierputze sind Putze, die gegen bauschädliche Salze resistent und daher insbesondere für den Einsatz auf feuchtem und/ oder salzbelastetem Mauerwerk im Innenund Außenbereich geeignet sind.
Das aus dem Mauerwerk aufgenommene Wasser bzw. die Salzlösung verdunstet, die dabei auskristallisierenden Salze werden im
Vorarbeiten
porigen Gefüge der Sanierputzsysteme von Knauf eingelagert – so bleibt die Putzoberfläche trocken und frei von Ausblühungen. Alle Knauf Sanierputze können auch maschinell und damit äußerst wirtschaftlich verarbeitet werden.
Die Wirkung aller Sanierputze ist wesentlich von Begleitmaßnahmen wie z. B. horizontalem und/oder vertikalem Feuchteschutz (DIN 1053/DIN 18533), dem Einbau einer Drän- oder Filterschicht im erdberührten Bereich und der Wasserableitung weg vom Gebäude durch Gefälleänderung abhängig.
Untergrund Vorbehandlung
Altputz Altputz bis auf 80 cm über der erkennbaren Durchfeuchtungszone komplett abschlagen und abfallenden Bauschutt umgehend entfernen mürbe Mauerwerksfugen ca. 2 cm tief auskratzen
Mörtelreste/Anstriche auf Mauerwerk vollständig entfernen und mechanisch reinigen schwach/nicht saugender Untergrund warzenförmig (ca. 50 % flächendeckend) oder volldeckend mit Stens Haft vorspritzen normal saugender Untergrund (Ziegel) keine kritisches, nicht tragfähiges Mauerwerk korrosionsbeständiger Putzträger

Ausblühungen auf gereinigtem Mauerwerk trocken abkehren Oberflächenfeuchte trocknen lassen größere Mauerwerksunebenheiten Stens Grund in 20 – 30 mm dicken Lagen auftragen und die Oberfläche aufrauen
Vorbereitung
Normal saugende Untergründe können ohne Untergrundvorbehandlung verputzt werden. Bei stark saugenden Untergründen erfolgt die Ausführung nass in feucht. Dabei eine Lage von 5 –10 mm vorlegen und die zweite Lage bis zur erforderlichen Putzdicke nass in feucht auftragen. Bei nicht saugenden Untergründen erfolgt die Untergrundvorbehandlung mit Stens Haft. Je nach Untergrund kann die Untergrundvorbehandlung teilflächig mit ca. 50 % oder vollflächig erfolgen.
Für die maschinelle Verarbeitung sind insbesondere die PFT G4, Luftporenmantel D6-3 oder die Förderschnecke D6-3 geeignet. Das Anmachen erfolgt durch intensives Mischen in der Putzmaschine. Die Wasserzugabe ist so zu regeln, dass eine schlanke Mörtelkonsistenz entsteht. Während des Spritzvorgangs dürfen keine Unterbrechungen eingelegt werden.
Sackinhalt mit der jeweils angegebenen Wassermenge knollenfrei anmischen. Maßgebend für die Wirkungsweise von Sanierputzen ist das Erreichen des Porenanteils des Frischmörtels. Beim Anmischen sauberes Wasser verwenden und keine Fremdstoffe zusetzen.
Geringe Salzbelas tung des Mauer werks
Mittlere bis hohe Salzbelas tung des Mauer werks

Auftragsdic
Oberfläche beim Ansteifen horizontal aufrauen und austrocknen lassen
Standzeit mindestens 1 Tag je mm Putzdicke Stens Grund Stens Hell Popo
Oberfläche beim Ansteifen horizontal aufrauen und austrocknen lassen
Standzeit mindestens 1 Tag je mm Putzdicke
Die Knauf Satt Platte ist harzgebunden und somit absolut salzbeständig. Die vollständig vorbereitete Sanierplatte kann leicht zugeschnitten werden und bietet die Möglichkeit der Hinterlüftung. Damit ist die Satt Platte ideal gegen extrem hohe Salz- und Feuchtebelastungen.
Sockel
Im Sockelbereich Satt Sockellabschlussprofil flutrecht mit Duo-Kleber ca. 20 mm über der Geländeoberkante verlegen und zusätzlich dübeln.

Fuge zwischen dem Sockelabschlussprofil und dem Bodenbelag mit Kompriband schließen oder Hohlkehle mit UP 310 und Sockel-Dicht ausführen.
Kleben der Satt Platte Duo-Kleber auf die Plattenecken punktuell oder in Streifen auftragen, sodass eine Klebeverbindungsfläche von 30 % entsteht.
Satt Sanierplatte im Verbund stumpf gestoßen verlegen, andrücken und ausrichten.
Dübeln der Satt Platte
Ca. zwei Stunden nach der Verklebung im T-Stoßbereich und in der Plattenmitte jeweils einen Satt Dübel im tragfähigen Mauerwerk setzen (8 Stk./m2). Satt Platten, Hohlkammersteine sowie Porenbeton immer im Drehgang bohren und anschließend die Edelstahlschraube vorsichtig eindrehen.

Vorbehandlungen
Gipsputze
Spachtel pastös
Kalkputze
Unterputze
Oberputze
Sanierung
Dämmschüttungen
Innendämmung
WARM-WAND Dämmstoffe
WARM-WAND Klebe- und Armiermörtel
WARM-WAND Zubehör
AQUAPANEL® VHF
Gestaltungselemente
Farben
Sanierung
Sanierputze Sanierplatte
Selbst porenbildender Sanierputz nach WTA-Merkblatt 2-9; Ausgabe 06.2018/D mit einem selbstaktiven Porenanteil von > 25 %. Einsatz auf feuchtem und/oder salzbelastetem Mauerwerk im Innen- und Außenbereich.
Das aus dem Mauerwerk aufgenommene Wasser bzw. die Salzlösung verdunstet innerhalb des Putzquerschnittes. Die dabei auskristallisierenden Salze werden im porigen Gefüge eingelagert. Durch den hohen Porenanteil bleibt die Putzoberfläche trocken und frei von Ausblühungen.
Details finden Sie im techn. Blatt P734.de
Eigenschaften und Mehrwert
› Werktrockenmörtel R nach EN 998-1
› Druckfestigkeitskategorie CS II nach DIN EN 998-1
› Hohe Wasserdampfdurchlässigkeit bei verminderter kapillarer Leitfähigkeit
› Resistent gegen bauschädliche Salze
› Luftporenanteil des Frischmörtel durch selbstaktive Porenbildung > 25 Vol.%


› Vergrößert sein Volumen nach dem Antragen um ca. 30 %
› Porosität > 50 Vol.%
› Wasserabweisend
› Für innen und außen
› Verarbeitung mit Maschine
Diese Angaben sind Zirka-Werte und können je nach Art des Untergrundes abweichen.
Sanierputz nach WTA Merkblatt 2-9; Ausgabe 03.2020/D. Einsatz auf feuchtem und/oder salzbelastetem Mauerwerk im Innen- und Außenbereich. Das aus dem Mauerwerk aufgenommene Wasser bzw. die Salzlösung verdunstet innerhalb des Putzquerschnittes von Stens Hell. Die dabei auskristallisierenden Salze werden im porigen Gefüge von Stens Hell eingelagert. Durch den hohen Porenanteil bleibt die Putzoberfläche trocken und frei von Ausblühungen.
Details finden Sie im techn. Blatt P733.de
Eigenschaften und Mehrwert
› Werktrockenmörtel R nach EN 998-1
› Druckfestigkeitskategorie CS II nach DIN EN 998-1
› Hohe Wasserdampfdurchlässigkeit bei verminderter kapillarer Leitfähigkeit
› Resistent gegen bauschädliche Salze
› Porenanteil > 25 % durch Tenside
› Porosität > 45 Vol.%
› Farbton hellbeige
› Wasserabweisend
› Für innen und außen
› Verarbeitung mit Maschine oder von Hand
Diese Angaben sind Zirka-Werte und können je nach Art des Untergrundes abweichen.


Grobkörniger Sanierspritzbewurf nach WTA Merkblatt 2-9; Ausgabe 03.2020/D. Als Untergrundvorbehandlung bei glatten oder schwach saugenden Untergründen auf feuchtem und/oder salzbelastetem Mauerwerk im Innen-und Außenbereich. Je nach Untergrund kann Stens Haft teilflächig oder auch vollflächig aufgetragen werden. Durch die Untergrundvorbehandlung wird der Kapillartransport zwischen Mauerwerk und Sanierputz nicht behindert.
Details finden Sie im techn. Blatt P731.de
Eigenschaften und Mehrwert
› Werktrockenmörtel R nach EN 998-1
› Druckfestigkeitskategorie CS IV nach DIN EN 998-1
› Auftragsdicke ca. 4 mm
› Resistent gegen bauschädliche Salze
› Für innen und außen
› Verarbeitung mit Maschine oder von Hand
Diese Angaben sind Zirka-Werte und können je nach Art des Untergrundes abweichen.
Grobkörniger Saniergrundputz nach WTA Merkblatt 2-9; Ausgabe 03.2020/D. Einsatz auf feuchtem und/oder salzbelastetem Mauerwerk im Innen- und Außenbereich. Das aus dem Mauerwerk aufgenommene Wasser bzw. die Salzlösung verdunstet innerhalb des Putzquerschnittes von Stens Grund. Die dabei auskristallisierenden Salze werden im porigen Gefüge von Stens Grund eingelagert. Durch den hohen Porenanteil bleibt die Putzoberfläche trocken und frei von Ausblühungen.
Besonders bei unebenen Mauerwerksuntergründen und als Salzspeicher bei hoher Untergrundversalzung. Die letzte Sanierputzlage ist mit Stens Hell oder Popo auszuführen.
Details finden Sie im techn. Blatt P732.de
Eigenschaften und Mehrwert
› Werktrockenmörtel R nach EN 998-1
› Druckfestigkeitskategorie CS II nach DIN EN 998-1
› Hohe Wasserdampfdurchlässigkeit bei verminderter kapillarer Leitfähigkeit
› Resistent gegen bauschädliche Salze
› Porenanteil > 20 % durch Tenside
› Porosität > 45 Vol.%
› Wasserhemmend
› Für innen und außen
› Verarbeitung mit Maschine oder von Hand
Diese Angaben sind Zirka-Werte und können je nach Art des Untergrundes abweichen.
Einzigartiges Feuchtwand-Saniersystem für den Innen- und Außenbereich. Bestehend aus Blähtonkugeln, die an den Berührungspunkten mit einem salzbeständigen Kleber verbunden sind. Durch die nicht vorhandene Kapillarität (Haufwerksporen) wird eine erneute Salzeinwanderung in die neu aufgebrachten Putzlagen verhindert. Die Putzoberfläche bleibt dauerhaft trocken und frei von Ausblühungen. Speziell da, wo Sanierputze aufgrund der hohen Feuchte und Salzbelastung an ihre Grenzen stoßen oder wo eine dauerhafte Lösung gefragt ist.
In Verbindung mit Satt Dübeln, Satt Sockelabschlussprofilen, dem speziellen Duo-Kleber und diffusionsoffenen Putz- und Farbsystemen aus dem Knauf Programm, ist die salz- und alkaliresistente Satt Platte Kernstück eines perfekt aufeinander abgestimmten Feuchtwand-Saniersystems.
Details finden Sie im techn. Blatt P735.de
Eigenschaften und Mehrwert
› Dauerhafte Sanierung bei salz- oder feuchtebelasteten Untergründen
› Vom Untergrund abgekoppeltes Saniersystem
› Sehr hohe Wasserdampfdurchlässigkeit
› Dauerhafte Sanier-Lösung
› Nicht kapillarleitend
› Resistent gegen bauschädliche Salze
› Über 40 % definiertes Hohlraumvolumen
Schraubdübel mit nicht-rostender Stahlschraube für die Befestigung der Satt Platte.
Details finden Sie im techn. Blatt
Eigenschaften und Mehrwert
› Dübellängen bis 115 mm
› Dübelteller Ø 50 mm
› Bohrer Ø 8 mm


Abgestimmtes Trogprofil aus Edelstahl zur Aufnahme der Satt Platte als Sockelprofil.
Details finden Sie im techn. Blatt
Eigenschaften und Mehrwert
› Edelstahl
› Ohne Abzugskante
› Mit Tropfnase
Systemgeprüfter, mineralischer Spezialkleber mit optimierter Früh-Abbindereaktion auf nicht oder schlecht saugenden Untergründen für Knauf WARM-WAND
Duo zur Aufdopplung bestehender Altfassaden.
Duo-Kleber eignet sich außerdem insbesondere für die Verklebung der Satt Platten, Fassadenprofile, Perfex Jalousiekasten und Jalousieschürze sowie der Kellerdeckendämmplatte 035.

Details finden Sie im techn. Blatt P393.de
Eigenschaften und Mehrwert
› Normalputzmörtel GP nach DIN EN 998-1
› Druckfestigkeitskategorie CS IV nach DIN EN 998-1
› Mit Haftzusatz
› Mineralischer Klebemörtel mit optimierter Abbindereaktion

› Wasserabweisend
› Sehr hohe Klebekraft
› Diffusionsoffen
› Farbton grau
› Für innen und außen
› Verarbeitung mit Maschine oder von Hand
Diese Angaben sind Zirka-Werte und können je nach Art des Untergrundes abweichen.
Vulkanisches Perlitgestein ist dank seiner hervorragenden Eigenschaften vielseitig einsetzbar. Es ist hochwärmedämmend, mineralisch und damit nicht brennbar. Damit findet es nicht nur Anwendung im Bereich der Innendämmung sondern auch als Dämmschüttung im Neubau oder der Sanierung. Die Einsatzbereiche der perlitbasierten Dämmschüttung erstrecken sich von zweischaligen Außenwänden bis hin zur Hohlraumdämmung von Decken, Dächern oder Schächten.

Vorbehandlungen
Gipsputze
Spachtel pastös
Kalkputze
Unterputze
Oberputze
Sanierung
Dämmschüttungen
Innendämmung
WARM-WAND Dämmstoffe
WARM-WAND Klebe- und Armiermörtel
WARM-WAND Zubehör
AQUAPANEL® VHF
Gestaltungselemente
Farben

Nicht wassersaugende Dämmstoffschüttung für zweischalige Außenwände, Hohlräume und Installationsschächte, nicht brennbar (Baustoffklasse A1). Seit Jahrzehnten hat sich Hyperlite-KD als dauerhafter Wärmedämmstoff in zweischaligen Außenwänden bewährt. In nur einem Arbeitsgang lassen sich fugenlose Wärmedämmschichten bis 15 cm realisieren. Hohlräume und Installationsschächte werden einfach aus dem Sack aufgefüllt.

Eigenschaften und Mehrwert
› Hochwärmedämmend
› Anwendungsgebiet WZ, DI, DZ nach DIN 4108-10
› Wasserabweisend
› Leicht und diffusionsoffen
› Einfache Verarbeitung
› Unempfindlich gegen Feuchtigkeit, Verrottung oder Ungeziefer
› Nichtbrennbar A1, gemäß Entscheidung 1996/603/EG
Einblasdämmung zur nachträglichen Kerndämmung zweischaliger Außenwände nach DIN 1053-1. Mit Hyperdämm lassen sich fugenlose Wärmedämmschichten zeit- und kostensparend in einem Arbeitsgang realisieren. Dazu wird Hyperdämm einfach zwischen Außen- und Innenschale trocken eingeblasen.
Details finden Sie im techn. Blatt P373H.de
Eigenschaften und Mehrwert
› Nichtbrennbar A1, gemäß Entscheidung 1996/603/EG
› Wasserabweisend
› sehr gute, ökologische Wärmedämmung
› Einfache Verarbeitung
› Leicht und diffusionsoffen
› Unempfindlich gegen Feuchtigkeit, Verrottung oder Ungeziefer
› Anwendungsbereich WZ nach DIN 4108-10
Energiekosten senken und gleichzeitig die Außenfassade eines Gebäudes erhalten – das sind zum Beispiel Anforderungen im Denkmalschutz. Mit einem Innendämmsystem können sie wirkungsvoll umgesetzt werden.
Die Kalkputzfamilie Rotkalk mit ihren feuchteregulierenden Eigenschaften in Verbindung mit einer kapillaraktiven und hochdiffusionsoffenen, nicht brennbaren Dämmplatte aus Perlitgestein sorgt für ein gesundes und angenehmes Wohlfühlklima.

Im abgestimmten System stehen drei mineralische Wärmedämmplatten aus dem natürlichen Rohstoff Perlit zur Verfügung, die in der energetischen Sanierung, zur Schimmelprävention und in Fachwerkgebäuden zum Einsatz kommen. Diese Platten werden mit einer Putzschicht aus diffusionsoffenem Rotkalk verputzt. Somit wirkt das Gesamtsystem feuchteregulierend. Die Wärme im Raum kann verbleiben und die Feuchte wird optimal ausgeglichen, indem sowohl der Putz als auch die Dämmplatte Feuchtigkeit aufnehmen und wieder abgeben können. Das Gesamtsystem überzeugt durch ein optimales Feuchtemanagement.
Optimale Dämmleistung –geprüft sicher und umweltschonend
Die Dämmplatten sind nicht brennbar und frei von Schadstoffen. Effektiver Schimmelschutz
Dämmung und Putz sind natürliche, kapillaraktive und diffussionsoffene Produkte.

Zur Auswahl des richtigen Innendämmsystems ist eine individuelle Beurteilung Ihrer Bausituation unerlässlich.
Energetische Sanierung
Das Rotkalk in-System mit der Rotkalk inBoard 045 TecTem® als Herzstück ist das Innendämmsystem, wenn es Ihnen um die energetische Ertüchtigung von Wohnräumen geht. Das System schafft ein angenehmes Raumklima bei bestmöglichem Wärmeschutz.
› Regulieren die Luftfeuchte



› Können große Mengen Wasser aufnehmen und bei Bedarf abgeben
› Beugen durch den hohen pH-Wert (> 12) auf natürliche Weise
Schimmelbildung vor
› Bauen aktiv Schadstoffe wie Formaldehyd, Kohlenwasserstoffverbindungen, Stickstoff und VOC ab
› Absorbieren nachweislich störende Gerüche, die z. B. beim Kochen entstehen
Schimmelsanierung & -prävention
Das Rotkalk in-System Climaprotect mit der Rotkalk in-Board Climaprotect ist speziell für die Anwendung in der Schimmelsanierung oder zur Schimmelprävention entwickelt. Das System mit der dünnen Aufbauhöhe erfüllt dabei die Anforderungen an den Mindestwärmeschutz.




Hochwirksam & sicher
Das Rotkalk in-System Historic mit der Dämmplatte Rotkalk in-Board 055 Historic und dem lehmhaltigen Grundputz und Klebemörtel kommt bei der Dämmung von Fachwerkgebäuden zum Einsatz: Das System ist optimal auf die statischen Besonderheiten von Fachwerkgebäuden abgestimmt.
Untergrund vorbereiten
Unebenheiten, Fehlstellen oder unverputzte Mauerwerkswände mit Rotkalk Grund oder Rotkalk Fein ausgleichen.
Dämmplatten zuschneiden
Passstücke mit einem feinzahnigen Fuchsschwanz und/oder einem Cutter auf das benötigte Maß zuschneiden.
Dichtungsband einbauen
Vor dem Verkleben der ersten Dämmplatte wird ein Knauf Dichtungsband eingebaut, um Lufthinterströmung zu vermeiden.
Klebemörtel auftragen
Auf die Dämmplatte wird Rotkalk in-Klebemörtel vollflächig aufgetragen und mit der Zahntraufel durchgekämmt.
Plattenverlegung in der Fläche
Dämmplatten in waagerechter Reihung mit gleichmäßigem Druck schiebend anbringen und ausrichten. Plattenversatz mindestens 20 cm.
Plattenverlegung Eckbereich
In Eckbereichen ist die Dämmplatte zu verzahnen. Überstehende Dämmplatten an Außenecken erst nach Abbinden des Klebers abschneiden. Weitere Details zur Verlegung finden Sie in der Rotkalk in-System-Verarbeitungsbroschüre.
Grundieren & Armieren
Nach Auftragen der Grundierung (Knauf Aufbrennsperre) wird die Armierschicht (Rotkalk Fein) aufgebracht. Dann erfolgt die vollflächige Einbettung des Gewebes.
Oberputz & Schlussbeschichtung
Nun werden der gewünschte RotkalkOberputz sowie die Rotkalk-Farbe als Schlussbeschichtung aufgetragen.
Weitere Ausführungs-Details z. B. zum Ausbilden von Anschlüssen, Kanten, Fugen oder Einbau von Elektrodosen finden Sie in der Verarbeitungsbroschüre: knauf.de/dokumentencenter







Einen Verarbeitungsclip zu Rotkalk in-System finden Sie außerdem auf www.youtube.com/knauf

Vorbehandlungen
Gipsputze
Spachtel pastös
Kalkputze
Unterputze
Oberputze
Sanierung
Dämmschüttungen
Innendämmung
WARM-WAND Dämmstoffe
WARM-WAND Klebe- und Armiermörtel
WARM-WAND Zubehör
AQUAPANEL® VHF
Gestaltungselemente
Farben
Innendämmung
Putzmörtel
Dämmstoffe
Zubehör
Rotkalk in-Klebemörtel Historic ist ein mineralischer, lehmhaltiger Putz mit Perlitanteilen und dient als Komponente des Innendämmsystems für Fachwerkhäuser als Klebemörtel für das vollflächige Verkleben der Rotkalk in-Board 055 Historic. Die optimale Funktionsfähigkeit des Rotkalk in-System Historic ergibt sich aus dem abgestimmten Zusammenspiel der hydrophilen, kapillaraktiven Dämmplatten und des speziell entwickelten saugfähigen und kapillarleitenden Rotkalk in-Klebemörtel Historic.
Details finden Sie im techn. Blatt P193H.de
Eigenschaften und Mehrwert
› Für den Innenbereich
› Nicht brennbar

› Dampfdiffusionsoffen
› Leichte Verarbeitung
› Brandverhalten A1
Rotkalk in-Grundputz Historic ist ein mineralischer, lehmhaltiger Putz, der speziell zum Ausgleich der Wände und Decken von Fachwerkgebäuden im Innenbereich entwickelt wurde. Der Ausgleich von Unebenheiten an Wänden und Decken garantiert eine optimale Funktionsweise des Rotkalk in-System Historic. Der Grundputz ist besonders saugfähig und kapillarleitfähig und besitzt eine optimale Plastizität, um Bewegungen aus dem Untergrund dauerhaft sicher aufnehmen zu können.
Details finden Sie im techn. Blatt P191H.de
Eigenschaften und Mehrwert
› Dampfdiffusionsoffen

› Erhöhte Feuchteaufnahme
› Einfache und schnelle Verarbeitung
› Verarbeitung mit Maschine oder von Hand
Hochwertiger mineralischer Klebemörtel zum Verkleben von Rotkalk in-Board 045 TecTem®, Rotkalk inBoard Laibung TecTem® sowie Rotkalk in-Board Climaprotect.


Details finden Sie im techn. Blatt P242T.de
und Mehrwert
› Normalputzmörtel GP nach DIN EN 998-1
› Druckfestigkeitskategorie CS IV nach DIN EN 998-1
› Mörtelgruppe P II nach DIN V 18550
› Für den Innenbereich
› Nicht brennbar
› Dampfdiffusionsoffen
Diese Angaben sind Zirka-Werte und können je nach Art des Untergrundes abweichen.
Manuell verarbeitbarer, mineralischer, hochergiebiger Werktrockenmörtel zum Verfüllen von eventuellen Fehlstellen und offenen Plattenfugen > 2 mm im Rotkalk in-System. Optimal auf Rotkalk in-Board 045 TecTem®, Rotkalk in-Board Laibung TecTem®, Rotkalk in-Board Climaprotect sowie Rotkalk in-Board 055 Historic abgestimmt.
Details finden Sie im techn. Blatt P265T.de
Eigenschaften und Mehrwert
› Dampfdiffusionsoffen
› Hohes Füllvermögen
› Geringe Wärmeleitfähigkeit
› Schnell erhärtend
Kalk-Oberputz mit Kaolin und Ziegelmehl zur Herstellung gefilzter oder frei strukturierter Oberflächen im Innen- und Außenbereich. Innen als Kalk-Dünnputz direkt auf Plansteinmauerwerk und Betonwänden sowie Decken, ggf. nach Vorbehandlung, zu verwenden. Rotkalk Fein ist optimal auf den Unterputz Rotkalk Grund abgestimmt. Ideal im Bereich der Denkmalpflege, bei der Kalkputze nach historischem Vorbild gefragt sind, als Armiermörtel für Rotkalk in-System oder als System Unter- und Oberputz.
Details finden Sie im techn. Blatt P203.de
Eigenschaften und Mehrwert
› Normalputzmörtel GP nach DIN EN 998-1
› Druckfestigkeitskategorie CS I nach DIN EN 998-1
› Für innen und außen
› Wasserhemmend
› Feuchtigkeitsregulierend und diffusionsoffen
› Hohe Alkalität, vorbeugend gegen Schimmelbildung
› Schadstoffabbauende Wirkung für VOC, Formaldehyd und Stickoxide
› Verarbeitung mit Maschine oder von Hand
› Farbton rötlich-braun

Diese Angaben sind Zirka-Werte und können je nach Art des Untergrundes abweichen.
Rotkalk in-Board 045 TecTem® ist eine mineralische, diffusionsoffene und kapillaraktive Dämmplatte aus expandiertem, natürlichem Perlitgestein. Zur Anwendung im Rotkalk in-System bei der energetischen Sanierung.

Details finden Sie im techn. Blatt P371T.de
Eigenschaften und Mehrwert
› Mineralisch
› Dampfdiffusionsoffen
› Hoch kapillaraktiv
› Schimmelpilzresistent
› Brandverhalten A1
› Recyclingfähig


Rotkalk in-Board Climaprotect ist eine mineralische und kapillaraktive Dämmplatte im Rotkalk in-System
Climaprotect. Rotkalk in-Board Climaprotect ist speziell für die Schimmelprävention geeignet und erfüllt trotz ihrer geringen Dicke den hygienischen Mindestwärmeschutz nach DIN 4108-2.
Details finden Sie im techn. Blatt P371C.de
Eigenschaften und Mehrwert
› Mineralisch
› Dampfdiffusionsoffen
› Hoch kapillaraktiv
› Schimmelpilzresistent
› Brandverhalten A1
› Recyclingfähig
› Einfache Verarbeitung
Rotkalk in-Board 055 Historic ist eine mineralische, diffusionsoffene und kapillaraktive Dämmplatte aus expandiertem, natürlichem Perlitgestein zur Anwendung im Rotkalk in-System Historic bei Fachwerkgebäudewänden. Die zugehörigen Komponenten Rotkalk in-Grundputz Historic und Rotkalk in-Klebemörtel Historic mit Lehmanteilen stellen eine dauerhafte Funktionstüchtigkeit des System sicher. Rotkalk inBoard 055 Historic ist einfach mit dem Cutter oder Fuchsschwanz bearbeitbar.
Details finden Sie im techn. Blatt P371H.de
Eigenschaften und Mehrwert
› Mineralisch
› Dampfdiffusionsoffen
› Hoch kapillaraktiv
› Schimmelpilzresistent
› Brandverhalten A1
› Recyclingfähig
› Einfache Verarbeitung
Rotkalk in-Board Laibung TecTem® ist eine mineralische und kapillaraktive Dämmplatte aus expandiertem, natürlichem Perlitgestein. Zur Anwendung im Rotkalk in-System.
Details finden Sie im techn. Blatt P372T.de
Eigenschaften und Mehrwert
› Mineralisch
› Dampfdiffusionsoffen
› Kapillaraktiv
› Schimmelpilzresistent
› Brandverhalten A1
› Recyclingfähig
› Leichte Verarbeitung
Europäisch technisch zugelassener Schraubdübel für die oberflächenbündige Montage bei dünnen Dämmstoffplatten im Rotkalk in-System und bei Knauf WARM-WAND Systemen. Zur Verarbeitung des Dübels ist ein IPR 30 (5 Stern) nötig.
Eigenschaften und Mehrwert
› Nutzungskategorien A, B, C, D und E
› ETA Zulassung ETA -17/0991
› Dübelteller Ø 60 mm
› Bohrer Ø 8 mm

› Verankerungstiefe 30 mm
› Verankerungstiefe Porenbeton 50 mm
› Für Dämmstoffe von 20 - 60 mm
› Verankerung in allen Untergründen
› Oberflächenbündige Montage
› Schraubantrieb IPR 30 (5 Stern) benötigt

Zur Befestigung dünner Dämmstoffplatten bei Innendämmung und WDVS (auf Anfrage)
Aufbrennsperre ist eine Kunstharzdispersion mit hoher Alkalibeständigkeit, die innen auf stark saugenden Untergründen eingesetzt wird, bevor diese mit Gipsputzen verputzt werden. Sie reduziert die Saugfähigkeit des Untergrundes und das Risiko des Aufbrennens. Aufbrennsperre wird ebenfalls auf den Dämmplatten im Rotkalk in-System verwendet. Das Konzentrat wird abhängig vom Untergrund mit Wasser verdünnt (1:1 bis 1:3 Raumteile).
Details finden Sie im techn. Blatt K456.de
Eigenschaften und Mehrwert
› Für den Innenbereich
› Lösemittelfrei
› Saugfähigkeitsregulierend
› Gelb pigmentiert
› Verarbeitung mit Maschine oder von Hand
› Hohe Alkalibeständigkeit
› Verdünnung 1:1 bis 1:3 (Raumteile)

Hoch festes, dauerhaftes, alkalibeständiges Armiergewebe mit einer Maschenweite von 4 x 4 mm für WARM-WAND Systeme und im Rotkalk in-System.
Details finden Sie im techn. Blatt K445a.de
Eigenschaften und Mehrwert
› Für innen und außen
› Dauerhaft alkalibeständig
› Maschenweite 4 x 4 mm
› Verschiebefest
› Weiß mit blauen Markierungen
› Zugfestigkeit ≥ 1800 N/5 cm
› Flächengewicht ca. 165 g/m²

Gewebeeckpfeile werden diagonal von allen Öffnungsecken (Fenster, Türen etc.) in den Armiermörtel unter die eigentliche Gewebearmierung oder oberflächennah im Unterputz eingebettet.

Eigenschaften und Mehrwert
› Maschenweite 6 x 6 mm
› Größe 560/400 x 330 mm
› Auch für Unterputz geeignet
Für die Eckarmierung von Außenecken
Kunststoff Gewebeeckwinkel mit alkalibeständigem Armiergewebe zur Ausbildung von lot- und fluchtgerechten Außenecken in Knauf WARM-WAND Systemen und im Rotkalk in-System.
Details finden Sie im techn. Blatt P385w.de
Eigenschaften und Mehrwert
› Alkalibeständiges Armiergewebe
› Maschenweite 4 x 4 mm
› Weißes Kunststoffprofil
› UV-beständig

Das Dichtungsband ist ein einseitig selbstklebender Dichtstreifen für Trennwandanschlüsse. Es ist in verschiedenen Breiten erhältlich und somit flexibel einsetzbar. Zum Entkoppeln der Dämmplatten des Rotkalk in-Systems im Bereich anstoßender Bauteile (Fußböden, Decken und Wände).
Details finden Sie im techn. Blatt K434.de
Eigenschaften und Mehrwert
› Handliche Verarbeitung mit Rolle


› Dauerelastisch
› Gutes Haftvermögen
› Weichmacherfrei
› Bei Minustemperaturen im Außenbereich elastisch
› Schnelle und saubere Verarbeitung
› Beständig gegen: Wasser, Salzwasser, Pilzbefall, Oxidation, UV-Bestrahlung, schwache Laugen, schwache Säuren, Witterung
Vorkomprimiertes, selbstklebendes, seitenflächenimprägniertes Fugendichtband aus Polyurethan-Weichschaumstoff zur Herstellung von schlagregendichten Anschlüssen bei Knauf WARM-WAND Systemen.
Details finden Sie im techn. Blatt P386c.de
Eigenschaften und Mehrwert
› Seitenflächen imprägniert
› Temperaturbeständig -30°C bis +90°C
› Schlagregendichtigkeit von Fugen ≥ 1050 Pa
› Zurückkomprimiertes Fugendichtband
› Temperaturunabhängig verlegbar
› Dampfdiffusionsoffen
› Witterungsbeständig
› Selbstklebend
Für schlagregendichte Anschlüsse bei WARM-WAND Systemen und Rotkalk in-System

Selbstklebendes, einteiliges Fensteranschlussprofil mit Dichtlippe für einen sauberen Anschluss an Fenster und Türen. Die Schlagregendichtheit wird ausschließlich durch ein zusätzliches Fugendichtband hergestellt. Die Schutzlippe schützt das PE-Dichtband und verdeckt die Fuge.
Details finden Sie im techn. Blatt P385a.de
Eigenschaften und Mehrwert
› Für Fenster- und Türgrößen ≤ 2,6 m²
› UV-beständige Schutzlippe
› Entspricht einer dauerelastischen Verfugung
› Mit leicht abziehbarer Schutzlasche
› Alkalibeständiges Armiergewebe mit Kunststoffschenkel verbunden
› Für Putzdicken von 6 bis 12 mm
Ständig steigende Energiekosten werden zunehmend zur massiven Belastung. Entsprechend wird der Wert eines Hauses heute auch daran gemessen, wie viel das warme Wohnen kostet. Aber nicht allein der Heizkostendruck sollte Auslöser zum Umdenken und Handeln sein.

Vielmehr muss es die Aufgabe eines Jeden sein, klimabewusst zu handeln. Durch eine wirkungsvolle Dämmung kann über einen langen Zeitraum viel CO2 eingespart werden, was einen Beitrag zur Klimaneutralität darstellt und Ausdruck eines gesteigerten Klimabewusstseins ist.
Mit einer gedämmten Fassade wird zudem beste Wohnqualität, ein Höchstmaß an Behaglichkeit, enorme Kostenersparnis und ein steigender Gebäudewert erreicht. Knauf als führender Hersteller von Wärmedämm-Systemen hat für jede Anforderung das perfekt abgestimmte System.
Die Wärmedämmung von Gebäuden gehört zu den wichtigsten Maßnahmen zur Energieeinsparung und zur Verminderung von CO2-Emissionen. Außerdem gleicht ein Knauf WARM-WAND System die Innenwand- und Raumlufttemperatur perfekt aus –das sorgt auch bei gedrosselter Heizung für angenehme Wärme im Haus.
Aber auch im Sommer steigert eine gedämmte Fassade den Wohnkomfort deutlich, da sie verhindert, dass zu viel Wärme durch die Fassade von außen nach innen gelangt. Professionelle Wärmedämmung sorgt also das ganze Jahr über für angenehmes Wohnklima und Behaglichkeit in den eigenen vier Wänden – effizient und klimaschonend.

Die Verwendung von WärmedämmVerbundsystemen wird in der Allgemeinen bauaufsichtilichen Zulassung (abZ) / Allgemeinen Bauartgenehmigung (abG) geregelt. Diese stellen einen Verwendungsnachweis für nicht (durch Normen) geregelte Bauprodukte und Bauarten im bauordnungsrechtlichen Bereich dar. Zuständig für die Erteilung der abZ ist das Deutsche Institut für Bautechnik (DIBt) in Berlin.
Sie wollen mehr über Wärmedämmung wissen?
Unser Film fasst die wichtigsten Informationen für Sie zusammen. www.youtube.com/knauf
Ein Knauf WARM-WAND System verhindert im Winter eine kalte Innenwandoberfläche und somit die Bildung von Kondenswasser und hält im Sommer die Hitze draußen. Das sorgt für eine angenehme Temperatur und ein behagliches Raumklima.
Hauswert steigern
Mit Knauf WARM-WAND Systemen gedämmte Gebäude sind einfacher zu vermieten und haben einen höheren Wiederverkaufswert. Die Außenwände sind geschützt vor Witterungseinflüssen und Temperaturunterschieden, die Frostgrenze liegt im Dämmsystem und die Innenseiten der Außenwände sind durchgehend warm.
Umwelt schonen
Auf das Beheizen von Wohnraum entfallen in Deutschland über 30 % des Verbrauchs fossiler Brennstoffe – ein enormes Einspar-
potenzial. Mit einer fachgerecht ausgeführten Dämmung lassen sich diese CO2-Emissionen deutlich senken. Mit Dämmungen von Fassaden kann ein wirkungsvoller Beitrag zur Klimaneutralität geleistet werden. Ein Beitrag, der ein gesteigertes Klimabewusstsein zum Ausdruck bringt.
Heizkosten sparen
Sowohl bei Neubauten als auch bei Gebäuden von älterer Bausubstanz ist Wärmedämmung ein entscheidender EnergiesparFaktor. Mit einem Knauf WARM-WAND System können die Energieverluste über Altbauwände entscheidend gesenkt werden.

Oberflächen gestalten
Bei Verwendung von Knauf WARM-WAND Systemen können Sie einzigartige Gebäudeoberflächen schaffen. Attraktive Putzstrukturen, Klinker oder Naturstein – alles ist möglich.
Ausgehend vom vorhandenen Schichtenaufbau sollten die Dämmstoffdicken so gewählt werden, dass die Mindestforderungen des aktuellen GEG erreicht werden. Die Wirtschaftlichkeit von Dämm-
maßnahmen kann aufgrund der langen Lebensdauer und angesichts steigender Energiepreise durch den Einsatz größerer Dämmstoffdicken verbessert werden.
Das Gebäudeenergiegesetz (GEG) ist die Durchführungsverordnung über energiesparenden Wärmeschutz und energiesparende Anlagentechnik bei Gebäuden, die sich aus dem Energieeinsparungsgesetz ergibt.
Sie gilt für Wohngebäude, Bürogebäude und gewisse Betriebsgebäude. Das GEG dient dazu, die Einsparung von Heiz- und Kühlenergie und damit die Reduzierung des CO2-Ausstoßes durch baulichen Wärmeschutz zu sichern.
Der Energiepass
Im Energiepass werden von Sachverständigen alle Prüfergebnisse und Schwachstellen im Gebäude protokolliert und der typische Heizwärmebedarf für das jeweilige Gebäude ermittelt. Er dient als wertvolle Planungsgrundlage, um gezielt sinnvolle Sanierungsmaßnahmen einzuleiten.
Durch Außenwände ohne Dämmung geht rund ein Drittel der Wärme verloren. Positiv ausgedrückt heißt das: Bis zu 30 % Heizenergie lassen sich allein durch sinnvolle Außendämmung einsparen. Keine andere Einzelmaßnahme besitzt dieses Potenzial!
Die Systeme
Systemaufbau
WARM-WAND Plus Die Schutzfassade

WARM-WAND Basis Die Standardfassade
Eigenschaften
n höchster Brandschutz durch absolute Nichtbrennbarkeit
n warme Wände und ein optimales Raumklima
n Ruhe und Entspannung durch zusätzlichen Schallschutz
n spart Energiekosten wirkungsvoll und effizient
n Dämmplatten wahlweise mit Nut&Feder-Technik zur Verhinderung von Wärmeverlusten
n besonders langlebig durch optimal abgestimmte Komponenten
Detailblatt-Nummer P323 P321

Zulassungen
Klebemörtel
Z-33.43-82
Z-33.44-83
SM700 Pro
SM700
SM300
Lustro
Sockel-SM
Duo-Kleber
Mechanische Befestigung
Dämmstoff
ggf. oberflächenbündig oder versenkt mit Schlag- oder Schraubdübeln
MW Volamit 040
MW Wolle 035
MW Wolle 035 plus
MW Wolle 035 plus M2
MW Wolle 035 plus L
Armiermörtel
SM700 Pro
SM700
SM300
Lustro
Sockel-SM
Armiergewebe
Grundierung
Oberputze
Armiergewebe 4 × 4 mm/5 × 5 mm
Isogrund/Quarzgrund Pro
Noblo
Noblo Filz
Mak3
SP 260 Pro
RP 240
Conni S
SM700 Pro
Carrara
Kati S
Addi S
MineralAktiv Scheibenputz
MineralAktiv Scheibenputz Dry
Z-33.41-81
Z-33.43-82
SM700 Pro
SM700
SM300
Lustro
Sockel-SM
Pastol
Duo-Kleber Speedero
ggf. oberflächenbündig oder versenkt mit Schlag- oder Schraubdübeln
EPS Standard 034/032 (auch elastifiziert)
EPS Nut&Feder 032 (auch elastifiziert)
EPS Sunja 032
EPS Standard 031
SM700 Pro
SM700
SM300
Lustro
Sockel-SM
Armiergewebe 4 × 4 mm/ 5 × 5 mm
Isogrund/Quarzgrund Pro
SP 260 Pro
RP 240
Noblo
Noblo Filz
Mak3
Carrara
SM700 Pro
Pastol
Armiergewebe Pastol
Conni S
Addi S
Kati S
MineralAktiv Scheibenputz
MineralAktiv Scheibenputz Dry
Farbanstrich
Siliconharz-EG-Farbe
Autol
Minerol
Fassadol
MineralAktiv Fassadenfarbe
Siliconharz-EG-Farbe
Autol
Minerol
Fassadol
MineralAktiv Fassadenfarbe
WARM-WAND Duo Die Modernisierungsfassade
WARM-WAND Slim Die Hochleistungsfassade

WARM-WAND Keramik / Naturstein Die Massivfassade
n energetische und architektonische Modernisierung vorhandener Wärmedämm-Systeme
n Wertsteigerung durch zeitgemäßen Wärmeschutz
n perfekt auf die Altfassade abgestimmte Systemtechnik
n absolut wärmebrückenfreie Fassade vom Sockel bis zum Dach
n dämmt über 30 % besser als Polystyrol
n bewahrt die Gebäudecharakteristik
n dauerhafter Schutz vor Witterungs- und Umwelteinflüssen
n unempfindlich gegen mechanische Einwirkungen
n keine Wartungs- und Instandhaltungskosten
n individuelle, vielfältige Gestaltungsmöglichkeiten
P321-E01, P323-E01 P327 P329
Z-33.49-981
Duo-Kleber SM700
SM700 Pro
SM300
Sockel-SM
Lustro
Pastol
oberflächenbündig oder versenkt mit Schlag- oder Schraubdübeln
MW Volamit 040
MW Wolle 035
MW Wolle 035 plus /plus M2 / plus L
EPS Standard 034/032 (auch elastifiziert)
EPS Nut&Feder 032 (auch elastifiziert)
EPS Sunja 032
EPS Standard 031
SM700
SM700 Pro
SM300
Sockel-SM
Lustro
Armiergewebe 4 × 4 mm/5 × 5 mm/Pastol
Isogrund/Quarzgrund Pro
Noblo
SP 260 Pro
RP 240
Conni S
Addi S
Kati S
Mak3
Siliconharz-EG-Farbe
Autol
Minerol Fassadol
MineralAktiv Fassadenfarbe
Pastol
Z-33.43-1235
Z-33.43-1408
Z-33.41-1382
SM700 Pro SM300
Duo-Kleber
ggf. oberflächenbündig oder versenkt mit Schlag- oder Schraubdübeln
PF Slimtherm 021
PU Slimtherm 024
PU Slimtherm 026
Z-33.46-424
Z-33.46-1703
SM700 Pro SM700
SM300
Lustro
Sockel-SM
ggf. oberflächenbündig oder versenkt mit Schlag- oder Schraubdübeln
MW Volamit 040
MW Wolle 035
MW Wolle 035 plus /plus M2 / plus L
EPS Standard 034/032
EPS Nut&Feder 032
EPS Sunja 032
EPS Standard 031
Carrara
Noblo Filz
SM700 Pro
MineralAktiv Scheibenputz
MineralAktiv Scheibenputz Dry
SM700 Pro
Armiergewebe 5 × 5 mm
Isogrund/Quarzgrund Pro
Noblo
Conni S
SM700 Pro *
SP 260 Pro *
RP 240 *
Addi S *
*sind nur für PU Slimtherm zugelassen
Siliconharz-EG-Farbe
Autol
Minerol
Fassadol
MineralAktiv Fassadenfarbe
SM300
Armiergewebe 5 × 5 mm
geklebte keramische Bekleidung (z. B. Feldhaus Klinker, Röben)
unbeschichtete Naturwerksteine Knauf Flex-Fliesenkleber
Knauf Flex-Fugenmörtel


1 Klebemörtel
2 Dämmstoff (Mineralwolle)
3 Putzsystem: Armiermörtel, Armiergewebe
1 Vorhandene Dämmfassade
4 (Grundierung), Oberputz, (Egalisationsanstrich)
5 Wärmebrückenfreier Sockelanschluss

Das System WARM-WAND Plus bietet optimale Wärmedämmung und erfüllt höchste Anforderungen an den Schallund Brandschutz – bei Neubau und Modernisierung. Die Dämmstoffplatten MW Wolle 035 plus/plus M2/plus L sorgen für ca. 12 % mehr Dämmleistung und für bis zu 16 dB mehr Schallschutz. Das System ist nicht brennbar. Wahlweise können statt MW-Dämmplatten auch Mineralwolle-Lamellenplatten angewendet werden. Einsetzbar ist das WARM-WAND Plus System auch im Hochhausbereich (Abweichungen in Landesbauverordnungen beachten).




Das System WARM-WAND Basis ist die wirtschaftliche Lösung zur spürbaren Senkung der Energiekosten und Erfüllung des GEG. Es besteht aus EPS-Dämmstoffplatten mit stumpfer Kantenausbildung oder Nut&Feder, mineralischem oder organischem Kleber und Armierlagen sowie mineralischer oder organischer Oberputze. WARM-WAND Basis schützt die Fassade vor Witterungseinflüssen und sichert so langfristig den Gebäudewert. In Verbindung mit dem Sockelanschluss Peri ist WARM-WAND Basis dabei absolut wärmebrückenfrei. Einsetzbar ist WARMWAND Basis bis zu einer Gebäudehöhe von 22 m über GOK (Abweichungen in Landesbauverordnungen beachten).
5
Das System WARM-WAND Duo eignet sich hervorragend zur energetischen Optimierung bereits gedämmter Altfassaden. Die sogenannte Aufdopplung ist ökologisch äußerst sinnvoll und spart Sanierungskosten: WARM-WAND Duo wird auf die bestehende Dämmung ausgeführt. So entfallen Abbruch- und Entsorgungskosten. Es können Dämmstoffe aus Mineralwolle oder EPS verwendet werden. Dämmplatten werden mit mineralischem Kleber auf den Untergrund geklebt und gedübelt. Einsetzbar ist WARM-WAND Duo bei „normal entflammbaren“ Brandeigenschaften bis 7 m, „schwer entflammbar“ bis 22 m und „nicht brennbar“ über 22 m Gebäudehöhe über GOK (Abweichungen in Landesbauverordnungen beachten).



Das Hochleistungs-Dämmsystem WARMWAND Slim dämmt effizienter als andere Systeme: Phenolharz-Hartschaum oder Polyurethan(PUR)-Dämmplatten sorgen für eine enorm schlanke Konstruktion. Das schafft bei Neubauten mehr Wohnraum und bietet bei der Sanierung Vorteile, z. B. bei Grenzbebauung, Dachüberständen und Detailanschlüssen. Es ist vom Sockel bis zum Dach wärmebrückenfrei. Bei Neubauten kommt das geklebte Dämmsystem zum Einsatz. Ein Brandriegel zur Erreichung einer schwer brennbaren Fassade (B1) ist nicht notwendig. Einsetzbar ist WARM-WAND Slim bis zu einer Gebäudehöhe von 22 m über GOK (Abweichungen in Landesbauverordnungen beachten).
Die Systeme WARM-WAND Keramik und WARM-WAND Naturstein bieten neben besten Wärmedämmeigenschaften hervorragende Voraussetzungen für einzigartige, äußerst robuste und dauerhaft funktionstüchtige Oberflächen.


Beide Systeme erfüllen die Anforderungen an normal entflammbare bis nicht brennbare Fassadensysteme. Damit können WARM-WAND Keramik und Naturstein sowohl bei kleinen Gebäuden als auch bei Hochhäusern Anwendung finden.
Die Dämmstoffplatten werden mittels Klebemörtel angebracht und ggf. zusätzlich gedübelt.

Die Systeme
Systemaufbau
Eigenschaften
Detailblatt-Nummer
Zulassungen
Klebemörtel
Mechanische Befestigung
Dämmstoff
Armiermörtel
Armiergewebe
Grundierung
Oberputze
Farbanstrich
WARM-WAND Plus Die Schutzfassade
WARM-WAND Basis Die Standardfassade
WARM-WAND Natur D Die Naturdämmfassade
WARM-WAND Natur S Die Naturdämmfassade
WARM-WAND Natur T Die Naturdämmfassade
n warme Wände und ein optimales Raumklima
n Ruhe und Entspannung durch zusätzlichen Schallschutz
n schwer entflammbares
Fassadensystem
n spart Energiekosten wirkungsvoll und effizient
n Dämmplatten wahlweise mit Nut&Feder-Technik zur Verhinderung von Wärmeverlusten
n schwer entflammbares Fassadensystem
n natürlicher Holzfaser-Dämmstoff in Kombination mit bewährten Produkten
n höchster Wohlfühlfaktor durch natürliche Wärmedämmung
n effizienter sommerlicher Hitzeschutz
wenn konstruktiv oberflächenbündig mit Schraubdübel STR H E oberflächenbündig mit Schraubdübel STR H oder Schraubdübel 6H oder Klammern mit Breitrückenklammern
MW Volamit 040
MW Wolle 035
MW Wolle 035 plus
MW Wolle 035 plus M2
MW Wolle 035 plus L
SM700 Pro Luis
SM300 (nur bei SP 260 Pro, Mak3, Noblo, RP 240, Carrara, Conni S, MineralAktiv Scheibenputz)
Armiergewebe 4 × 4 mm/5 × 5 mm
Isogrund/Quarzgrund Pro
Mak3
Noblo
Noblo Filz 1.0 / 1.5
SP 260 Pro
RP 240
Conni S
SM700 Pro
Kati S Addi S
MineralAktiv Scheibenputz
Siliconharz-EG-Farbe (bei Noblo und Conni S)
Autol Minerol
Fassadol
MineralAktiv Fassadenfarbe
EPS Standard 031/032 (elastifiziert)
EPS Nut&Feder 032 (elastifiziert)
EPS Sunja 032
EPS Standard 035 weiß
SM700 Pro Luis
Sockel-SM
Pastol (nur bei Conni S, Addi S, Kati S)
SM300
Pastol Dry
Armiergewebe 4 × 4 mm/5 × 5 mm
/Pastol
ISOLAIR PAVAWALL PAVAWALL Bloc





STEICOprotect dry H/M/L STEICOduo STEICOduo dry
AGEPAN THD Putz 050
SM700 Pro Luis SM300
SM700 Pro Luis
SM700 Pro SM700 Lustro Luis
Armiergewebe 4 × 4 mm/5 × 5 mm
Armiergewebe 4 × 4 mm/5 × 5 mm
Armiergewebe 4 × 4 mm/5 × 5 mm
Isogrund/Quarzgrund Pro Isogrund/Quarzgrund Pro Isogrund/Quarzgrund Pro Isogrund/Quarzgrund Pro
Noblo Filz 1.0 / 1.5
SP 260 Pro
RP 240
Conni S
SM700 Pro
Kati S
Addi S
MineralAktiv Scheibenputz
MineralAktiv Scheibenputz Dry
Siliconharz-EG-Farbe
Autol
Minerol
Fassadol
MineralAktiv Fassadenfarbe
Noblo
Noblo Filz 1.0 / 1.5
SP 260 Pro
RP 240
Conni S
SM700 Pro
Kati S
Addi S
MineralAktiv Scheibenputz
Siliconharz-EG-Farbe bei Anwendungen auf Plattenwerkstoffen!
Autol
Minerol
MineralAktiv Fassadenfarbe
Noblo
Noblo Filz 1.0 / 1.5
SP 260 Pro
RP 240
Conni S
SM700 Pro
Kati S
Addi S
MineralAktiv Scheibenputz
MineralAktiv Scheibenputz Dry
Siliconharz-EG-Farbe
Autol
Minerol
Fassadol
MineralAktiv Fassadenfarbe
Noblo
Noblo Filz 1.0 / 1.5
SP 260 Pro
RP 240
Conni S
SM700 Pro
Kati S
Addi S
MineralAktiv Scheibenputz
Siliconharz-EG-Farbe bei allen mineralischen Oberputzen
1 Klebemörtel
2 Dämmstoff (Mineralwolle)
3 Putzsystem: Armiermörtel, Armiergewebe
Das System WARM-WAND Plus im Holzbau erfüllt hohe Anforderungen an den Wärmeschutz bei gleichzeitig hervorragenden Schallschutzwerten. Das WDVSystem basiert auf Mineralwoll-Lamellen, die sowohl auf massive Holzuntergründe als auch auf organisch gebundene Holzwerkstoffplatten, zementgebundene Spanplatten, Gipsfaserplatten und viele andere im Holzbau übliche Untergründe geklebt werden können.
1 Klebemörtel 2 Dämmstoff (EPS)
3 Putzsystem: Armiermörtel, Armiergewebe
4 (Grundierung), Oberputz, (Egalisationsanstrich)
5 Wärmebrückenfreier Sockelanschluss



Das WARM-WAND Basis System ist die ökonomische Lösung für die Anwendung im Holzbau – sowohl beim Neubau als auch bei der Sanierung. Die EPS-Dämmplatten werden dabei einfach auf Massivholz oder auf den holzbauüblichen Plattenwerkstoff geklebt. Das WARM-WAND Basis System kann deshalb schnell umgesetzt werden und besticht in Kombination mit den sehr guten Wärmedämmeigenschaften durch hervorragende Wirtschaftlichkeit.
4 (Grundierung), Oberputz, (Egalisationsanstrich)
5 Wärmebrückenfreier Sockelanschluss


1 Dämmstoff (Holzfaserdämmplatte)
2 Putzsystem: Armiermörtel, Armiergewebe
3 (Grundierung), Oberputz, (Egalisationsanstrich)
4 Wärmebrückenfreier Sockelanschluss
Abbildung: WARM-WAND Natur D
Das WARM-WAND Natur System bietet höchsten Wohnkomfort im Einklang mit der Natur. Das System basiert auf dem nachwachsenden Rohstoff Holz, der seine Stärken beim Wärmeschutz im Sommer und im Winter hervorragend ausspielt. In Verbindung mit Beschichtungen aus dem Hause Knauf bietet WARMWAND Natur im Holzbau eine perfekte Verbindung von Ökonomie und Ökologie. Die Dämmplatten können sowohl auf Holzständerkonstruktionen als auch auf massive Holzuntergründe aufgebracht werden.

Die wichtigste Aufgabe eines WDV-Systems besteht darin, Wärmeverluste so gering wie möglich zu halten und die Anforderungen des Gebäudeenergiegesetzes (GEG) zu erfüllen. Voraussetzung dafür ist die fachgerechte und sorgfältige Ausführung des Systems durch qualifizierte Fachunternehmen. Bevor eine Außendämmung angebracht
werden kann, muss der Wandaufbau geprüft werden, damit die optimale Dämmmaßnahme und deren sichere Montage für das Objekt bestimmt werden kann. Knauf hat dafür die WARM-WAND Systeme entwickelt, die auf alle Wandaufbauten angepasst werden können. Die Wärmedämmplatten (Polystyrol-Hartschaum, Mi-
Prüfung auf Prüfmethode Erkennung
Oberflächenfestigkeit Kratzprobe mit festem, kantigem Gegenstand
Abreiben mit der Hand
Oberfläche wird bei mäßigem Druck beschädigt
neralwolle, Holzfaser oder Hochleistungsdämmstoffe) werden entweder direkt auf die Außenwand geklebt, geklebt und gedübelt oder nur mechanisch befestigt und mit einer Schlussbeschichtung aus Putz oder anderen Materialien als Wetterschutz versehen.
Technische Hinweise und Maßnahmen
lose, lockere oder mürbe Teile manuell oder maschinell entfernen
bei geringem Abrieb Bauteiloberfläche mit putzfestigendem Grundschichtungsstoff behandeln
bei starkem, tiefgehendem Abrieb Bauteiloberfläche mit putzfestigendem Grundschichtungsstoff behandeln; nicht tragfähigen Putz/Beschichtung entfernen
nicht ausreichende Tragfähigkeit vorhandener Altbeschichtungen
Annässen bis zur Sättigung mit Wasser und Kratzprobe
Kratzprobe mit festem, kantigem Gegenstand
Klebebandtest: ca. 10 cm Klebebandstreifen bzw. Tesakrepp
4310 fest andrücken und ruckartig abreißen; vorher im Prüfbereich Gitterschnitt ausführen
Feuchtigkeit Augenschein und ggf. Kratzprobe
Ausblühungen Augenschein
Moos-, Algen-, Pilzbefall1)
Sonstige Verschmutzungen
bei Benetzungsprobe erweicht die Oberfläche
Beschichtungsteile splittern bereits bei mäßigem Druck ab; Kratzspur ist gezackt oder ausgewölbt
die Beschichtung lässt sich leicht abziehen; deutlich sichtbare Beschichtungsteile bleiben am Streifen kleben
feuchte Flächen, Wasserränder, Verfärbungen zeichnen sich ab
meist weiße Salze oder Kalkauslagerungen
nicht tragfähigen Putz/Beschichtung entfernen
Altbeschichtung entfernen
Altbeschichtung entfernen
bautechnische/bauphysikalische Ursachen sind bauseits zu beseitigen; austrocknen lassen
bautechnische/bauphysikalische Ursachen sind bauseits zu beseitigen; danach austrocknen lassen und Salze trocken entfernen
Abweichungen von der Ebenheit 2)
Abweichungen vom Lot 2) (Winkeltoleranz)
Eignung der Anschlüsse
Augenschein
Augenschein, Haptik (Fühlprobe)
Benetzungsprobe mit Wasser
Augenschein (parallel zur Fläche fluchten)
Augenschein der Gebäudekanten und vorhandener Bezugslinien angrenzender Bauteile
Augenschein; Messen der Überstände z. B. von Abdeckungen
grüner bzw. dunkler Bewuchs mechanisch oder durch Algizid (verarbeitungsfertige Sanierlösung) und Reinigen mit Hochdruckwasserstrahl entfernen
Farbe, Schmiereffekt, Klebrigkeit entfernen
bei starker Saugfähigkeit rasche Wasseraufnahme und schnelle Dunkelfärbung
deutlich störend sichtbare
n Abweichungen von der geraden Linie (Wellenform)
n fluchtabweichende Vorsprünge oder Überstände z. B. durch Geschossdecke
deutlich störend sichtbare Abweichungen vom Lot: unterschiedliche Abstände zur Bezugslinie, z. B. ungleiche Breite von Fensterlaibungen
ungleiche und/oder zu geringe Überstandsmaße
stark bzw. unterschiedlich saugende Untergründe sind durch Grundbeschichtung zu egalisieren
Ausmaß der Abweichungen durch Vermessungstechnik feststellen lassen; Ausgleichsputz herstellen, ggf. störende Überstände abstemmen lassen oder Ausgleich durch unterschiedliche Dämmschichtdicken vorsehen
Ausmaß der Abweichungen durch Vermessungstechnik feststellen lassen; Korrekturmaßnahmen an der Vorleistung durchführen lassen, ggf. Ausgleichsschichten herstellen
angrenzende Bauteile an das geplante WDVS anpassen lassen
1) Siehe auch Abschnitt 3.5 des „Merkblattes Nr. 21“ vom Bundesausschuss Farbe und Sachwertschutz, Frankfurt am Main, Ausgabe Februar 2005.
2) Bei Altbauten, z. B. bei historischen Gebäuden mit offensichtlichem Schiefstand oder großen Maßabweichungen, wird üblicherweise kein Ausgleich erwartet oder gestattet. Anderenfalls sollten im Einzelfall detaillierte Maßnahmen vereinbart werden.
Sockel-Abschlussprofil waagrecht montieren und mit Nageldübeln im Abstand von ca. 300 mm befestigen. Untergrundtoleranzen mit Unterlegscheiben ausgleichen. Stöße der Sockel-Abschlussprofile mit H-Verbindern zusammenstecken.
Montageset für Sockel-Abschlussprofil, bestehend aus 75 Nageldübeln, 50 Unterlegscheiben und 10 H-Verbindern zur Befestigung des Sockel-Abschlussprofils verwenden.


Klebemörtel aufspritzen Dämmplatten schneiden Armierungskleber aufspritzen
Armierungsgewebe einbetten
Für höchste Risssicherheit Sockel-Aufsteckprofile aus Kunststoff mit 100 mm breitem Gewebeschenkel auf Sockelabschlussprofile aufstecken. Wahlweise mit einer Abzugskante von 6 mm, 10 mm oder 14 mm für Kratzputz und dickschichtige Putzsysteme.

Grundierung aufspritzen
Oberputz aufspritzen Egalisationsfarbe aufspritzen
*Letztlich maßgeblich sind die jeweiligen Richtlinien bzw. Empfehlungen des Materialherstellers.
Weitere Informationen zur Maschinentechnik finden Sie unter www.pft.eu
Randwulst-Punkt-Verklebung
Der Kleberauftrag erfolgt üblicherweise durch Randwulst-Punkt-Verklebung mit einer Klebeverbindungsfläche von 40 bis 60 % (je nach WARM-WAND System) mit dem Untergrund nach dem Anpressen der Dämmplatten. Dabei umlaufend am Dämmplattenrand einen ca. 50 mm breiten Streifen und plattenmittig drei handtellergroße Kleberbatzen oder -streifen aufbringen.


Bei sehr ebenen Untergründen kann der Klebemörtel vollflächig mit einer Zahntraufel auf die Dämmplatten aufgetragen werden. Im Holzbau ist die Verklebung generell nur vollflächig zulässig.

Maschineller Kleberauftrag auf Untergrund Alternativ kann der Kleberauftrag auch maschinell erfolgen. Kleber dabei in Form von Wülsten direkt auf den Untergrund im Abstand von max. 80 mm auftragen (Mäanderverfahren) und Dämmplatten einschwimmen. Die erforderliche Klebeverbindungsfläche beträgt hier mind. 60 %, max. 3 m Kleberauftrag in Verlegerichtung vorlegen. Durch Verziehen des Klebers auf der Wand können die Dämmplatten auch vollflächig verklebt werden.
Ohne Eckverzahnung bis 200 mm Dämmstoffdicke
≥ 100 mm Stoßversatz
Dämmstoffe sind unverzüglich in das frische Klebemörtelbett einzudrücken, einzuschwimmen und anzupressen. Die Dämmplatten passgenau im Verband bei ≥ 100mm Stoßversatz von unten fortlaufend
ankleben. Dämmplatten bis zu einer Dicke von 200 mm ohne Eckverzahnung möglich, ab 220 mm mit Eckverzahnung verlegen. Ausgenommen hiervon ist das System WARM-WAND Keramik (Z-33.46-424).
Es darf kein Kleber in die Dämmplattenstöße gebracht werden. Eventuell entstandene Fugen sind sauber mit gleichwertigen Dämmstoffstreifen zu schließen.

Bei neuwertigen Untergründen ohne Putz, wie Mauerwerk nach DIN 1053 und Beton nach DIN 1045 sowie bei verputzten Untergründen, welche eine Abreißfestigkeit von ≥ 0,08 N/mm² aufweisen, kann in Abhängigkeit der jeweiligen Systemzulassung von einer zusätzlichen Verdübelung des Dämmmaterials abgesehen werden.
Schlagdübel: oberflächenbündige Montage
Bei gestrichenen Untergründen ist zusätzlich zur Verklebung immer eine Dübelung zu empfehlen. Dabei ist sicherzustellen, dass die Wand eine ausreichende Tragfähigkeit besitzt. Geklebt und gedübelt werden muss auch dann, wenn das Dämmmaterial aus Mineralwolle, Phenolharz (PF Slimtherm 021) oder Holzfaser besteht.

Bohrlöcher sind rechtwinklig zur Oberfläche zu erstellen. Bei oberflächenbündiger Montage ist eine Bohrlochtiefe von ≥ 10 mm und bei einer versenkbaren Montage eine Bohrlochtiefe einzuhalten, die ≥ 25 mm tiefer als die tatsächliche Setztiefe liegt. Das Bohrloch ist anschließend zu reinigen.






Bohren
Schlag- bzw. Hammerbohrer bei Beton und Vollstein verwenden, bei Lochbaustoffen nur im Drehgang bohren. Die Bohrlochtiefe muss ≥ 10 mm als die tatsächliche Dübelsetztiefe betragen. Zur Herstellung der Bohrlöcher werden 4-Schneider SDS Bohrer empfohlen Nach der Bohrlocherstellung ist das Bohrloch gründlich zu reinigen.

Schraubdübel: versenkte Dübelmontage
Einstecken und Einschlagen
Nach dem Einstecken des Dübels in das gereinigte Bohrloch wird das Spreizteil mittels Hammerschlägen in die Dübelhülse eingeschlagen bzw. mittels Schrauber eingeschraubt. Die Montage ist abgeschlossen, wenn der Kopf des Spreizteils bündig am Dübelteller anliegt.
Platzierung
Der Dübel ist richtig montiert, wenn der Dübelteller bündig am Dämmstoffmaterial anliegt. Bitte beachten Sie, dass die Montagetemperatur nicht unter 0 °C liegen darf.
Schraubdübel: oberflächenbündige Montage
Die Bohrlochtiefe muss 25 mm mehr als die tatsächliche Dübelsetztiefe betragen. Nach der Bohrlochreinigung wird der Dübel in das Bohrloch gesteckt und die Dübelschraube mittels des STR-Tools in die Hülse gedreht. Der Einschraubvorgang ist abgeschlossen, wenn die Anschlagplatte des STR-Tools bündig an der Oberfläche des Dämmmaterials (EPS oder Mineralwolle) anliegt.
Aufsetzen der Rondelle Nachdem der Dübel versenkt montiert ist, wird die für den jeweiligen Dämmstoff passende Rondelle aufgesetzt. Die Montage ist abgeschlossen, wenn die Rondelle bündig mit der Dämmstoffoberfläche abschließt.
Verschrauben mittels STR-Tool
Die Bohrlocherstellung und Platzierung des Dübels im Bohrloch erfolgt analog Schlagdübel. Die Dübelschraube wird mit oder ohne Einschraubtool eingeschraubt. Der Einschraubvorgang ist beendet, wenn der Schraubenkopf am Hülsengrund aufliegt.
Untergründe
Plattenwerkstoffe und Massivholzwände

Dämmplatten aus EPS oder Mineralwolle werden geklebt und konstruktiv zusätzlich mechanisch befestigt. Holzfaserdämmplatten werden mittels Schraubdübel oder Breitrückenklammer befestigt. Die Befestigung muss bei Holzfaserdämmplatten durch den Plattenwerkstoff in der Holzrahmenkonstruktion mit einer Verankerungstiefe ≥ 30 mm erfolgen.

Schraubdübel: oberflächenbündige Montage
Holzrahmenkonstruktion
Jede Holzfaserdämmplatte ist auf mind. zwei Holzständern mit mindestens drei Befestigungsmitteln je Ständer zu befestigen. Bei Nut&Feder-Ausbildung sind fliegende Stöße möglich. Platten mit stumpfen Kanten müssen auf den Riegeln gestoßen werden. Die Befestigung erfolgt in diesem Fall ausschließlich mit Klammern.
Mauerwerk / Beton
Nichttragende Holzrahmenkonstruktion
Die Befestigung der Holzfaserdämmplatten erfolgt mit definierten Breitenrückenklammern oder Systemdübeln im Holzständer, die im Abstand ≤ 625 mm fest am Untergrund montiert sind.
Richtiges Platzieren
Unter Berücksichtigung der statischen Anforderung werden Dübelanzahl und -platzierung bestimmt. Die Schraubdübel werden per Hand in die Dämmung gesteckt bzw. zum Verschrauben angesetzt. Die Montage erfolgt dabei in den tragenden Untergrund. Ein Vorbohren ist nicht erforderlich.
Breitrückenklammern
Zur Befestigung von Holzfaserdämmplatten auf massiven Holzuntergründen oder Holzständerwerken werden neben Schraubdübeln Breitrückenklammern verwendet. Die Verarbeitung erfolgt durch pneumatisch betriebene Klammergeräte. Die maximale Klammerlänge beträgt derzeit 180 mm.
Die notwendige Eindringtiefe in den tragenden Untergrund ist mindestens 30mm.

Bei größeren Dämmstoffdicken müssen
Schraubdübel werden mittels Akku- oder Elektroschrauber direkt montiert. Der Einschraubvorgang ist beendet, wenn der Dübelteller sich so weit in die Oberfläche des Dämmstoffs eingezogen hat, dass der Dübelteller bündig mit der Dämmstoffoberfläche abschließt.
Stopfen aufsetzen
Nach der Dübelmontage wird ein Kunststoffstopfen in den Dübelschaft gesteckt. Die Montage ist abgeschlossen, wenn der Stopfen bündig mit dem Dübelteller abschließt.
Schraubdübel oder Spezialschrauben verwendet werden. Erforderliche Abstände zu Plattenrändern, Abstände zu Rändern des tragenden Untergrundes und Anzahl der Klammern pro m2 sind aus der jeweils geltenden allgemeinen Bauartengenehmigung zu entnehmen.
Armieren
Armieren von Gebäudekanten und Laibungen
Gewebeeckwinkel 100/150 mm lot- und fluchtgerecht anbringen. Armiermörtel 5 – 7 mm (Pastol/2 – 3 mm) dick auftragen und eben verziehen.
Standzeit bei Armierung
Eine Standzeit von mind. einem Tag je mm Schichtdicke vor jeder weiteren Beschichtung einhalten. Bei Pastol beträgt die witterungsabhängige Standzeit mind. drei Tage.
Armieren von Öffnungsecken
Diagonal von allen Öffnungsecken Gewebeeckpfeile (560/400 × 330 mm) oder ca. 300 × 500 mm große Armiergewebestreifen direkt vom Eck beginnend im Nassmörtel einbetten.
Armieren von Wandflächen
Das Armiergewebe ganzflächig an den Stößen mind. 100 mm überlappend, nass in nass im äußeren Drittel der Armierschicht einbetten. Das Gewebe muss vollständig überdeckt sein. Übermäßiges Glätten der Armierschicht vermeiden, um eine Feinteilanreicherung an der Oberfläche auszuschließen.
Putzschicht
Grundieren
Grundierung entsprechend dem Oberputz auswählen. Den Eimerinhalt gut aufrühren und gelegentlich nachrühren. Anschließend die Grundierung vollflächig und gleichmäßig mit Rolle oder Bürste auftragen bzw. mit einem geeigneten Gerät aufsprühen.

Wassermenge und Anrühren gemäß aktuellem technischen Blatt befolgen. Dann den Oberputz mit rostfreier Glättkelle, Traufel oder wenn möglich maschinell auftragen, abziehen und nach Wunsch sofort mit geeignetem Werkzeug (Kunststoff-Traufel, Moosgummi- oder Schwammscheibe) strukturieren.




Bei mineralischen Oberputzen empfiehlt sich eine Beschichtung mit Siliconharz-Fassadenfarbe, eine speziell für die Egalisation (einmaliges Überstreichen) von mineralischen Oberputzen wie SP 260 Pro oder SM 700 Pro abgestimmte Fassadenfarbe.

Sockel mit geringer Geländeeinbindung
FD empfohlen bei nachträglichem Einbau der Sockeldämmplatten
Sockelausbildung zurückspringend mit abgeschrägter Perimeter-Dämmplatte
Bei zurückgesetzten Sockelflächen sind Wartungsarbeiten, z. B. durch mechanische Beschädigungen, effektiver instand zu setzen, ohne dass die komplette Fassade überarbeitet werden muss.
Fugendichtband FD emp ohlen bei nachträglichem Einbau der Sockeldämmplatten
Z. B Trennband oder Trennstreifen
Dämmstoff Sockel-Abschlussprof z B Peri Dübe (Verankerung im tragenden
Putzsystem Sockel-SM Pro, d ≥ 7 mm Durchgehender
ert
Sockelausbildung zurückspringend mit geradem Abschluss (Dämmung ≤140 mm)
Weisen Sie darauf hin, bei der Ausführung den Bereich unterhalb der Dämmung fachgerecht zu verdichten und zwischen Platte und Erdreich eine kapillarbrechende Schicht, z. B. Schotter, einzubauen.
Sockelausbildung flächenbündig
Bei Bauwerksabdichtungen, die mit bituminösen Dickbeschichtungen ausgeführt sind, kann Sockel-SM Pro als Klebemörtel verwendet werden.
Sockelausbildung flächenbündig –Oberputzausführung nach Fertigstellung der Belagsarbeiten
Wenn der Oberputz in gleicher Struktur über die gesamte Fassadenfläche ausgeführt wird, endet dieser 5 cm über der Geländeoberkante. Ein zusätzlicher Feuchteschutz kann dann entfallen. Ein Anstrich wird empfohlen.
Sockelausbildung zurückspringend
Durch den nicht kapillaraktiven SockelSM Pro ist eine Hinterfeuchtung der Perimeter-Dämmplatte ausgeschlossen.
Sockelausbildung flächenbündig
Bei einer durchgehenden Dämmstoffdicke endet der Oberputz über dem Sockelbereich. Die Sockelfläche wird gefilzt.
Mehr zu den besonderen Vorteilen des Sockel-SM Pro finden Sie hier: www.knauf.de/sockelsmpro
Einen Verarbeitungsclip zu unserem Sockel-SM Pro finden Sie außerdem auf www.youtube.com/knauf

Vorbehandlungen
Gipsputze
Spachtel pastös
Kalkputze
Unterputze
Oberputze
Sanierung
Dämmschüttungen
Innendämmung
WARM-WAND Dämmstoffe
WARM-WAND Klebe- und Armiermörtel
WARM-WAND Zubehör
AQUAPANEL® VHF
Gestaltungselemente
Farben
WARM-WAND Dämmstoffe
Mineralwolldämmplatten
EPS-Dämmplatten
Hochleistungsdämmplatten
Sockeldämmplatten
Nichtbrennbare Fassadendämmplatte aus Steinwolle mit beidseitig aufgebrachter Haftbeschichtung für WARM-WAND Systeme Plus, Duo, Keramik und Naturstein. Für die tiefversenkte bzw. versenkte oder oberflächenbündige Dübelmontage mit Schraubdübel STR U 2G oder mit Schlagdübel CNplus 8 mit oder ohne zusätzlichem Dübelteller VT 2G oder DT 90.
Details finden Sie im techn. Blatt P365d.de
Eigenschaften und Mehrwert
› MW nach DIN EN 13162
› Anwendungstyp WAP-zg nach DIN 4108-10
› Beidseitig aufgebrachte Haftbeschichtung
› Bemessungswert der Wärmeleitfähigkeit λ = 0,035 W/(mK)
› Erhöhte Zugfestigkeit
› Wärme- und schalldämmend
› Diffusionsoffen
› Nicht brennbar
› Bis 340 mm Dämmstoffdicke verarbeitbar (Aufdopplung)

MW Wolle 035 Plus L ist bis zu einer Plattendicke von max. 300 mm auf Anfrage bestellbar. Die zulässige Dämmstoffdicke im System beträgt 400 mm (Aufdopplung).
Nichtbrennbare Fassadendämmplatte aus Steinwolle mit beidseitig aufgebrachter Haftbeschichtung für WARM-WAND Systeme Plus, Duo, Keramik und Naturstein. Für die oberflächenbündige Dübelmontage mit Schraubdübel STR U 2G oder mit Schlagdübel CNplus 8 mit oder ohne zusätzlichem Dübelteller VT 2G oder DT 90.
Details finden Sie im techn. Blatt P365e.de
›
Eigenschaften und Mehrwert
› 30 % leichter als übliche MW-Platten

› Anwendungstyp WAP-zg nach DIN 4108-10
› Brandverhalten A1
› Bemessungswert der Wärmeleitfähigkeit λ = 0,035 W/(mK)
› Wärme- und schalldämmend
› Wasserabweisend
› Diffusionsoffen
› Beidseitig vorbeschichtete Oberfläche
›
Die nichtbrennbare Fassadendämmplatte MW Wolle 035 plus mit beidseitiger Haftbeschichtung und verdichteter Oberlage auf der Außenseite ist Systembestandteil der WARM-WAND Systeme Plus und Duo. Der Kleberauftrag erfolgt auf die Platte mit einer Klebeverbindungsfläche von ≥ 50 %. Eine zusätzliche Dübelung ist erforderlich.
Für die versenkte oder oberflächenbündige Dübelmontage mit Schraubdübel STR U 2G oder mit Schlagdübel CNplus 8 mit oder ohne zusätzlichem Dübelteller VT 2G oder DT 90. Eine tiefversenkte Dübelmontage ist auch möglich.
Details finden Sie im techn. Blatt P365.de
Eigenschaften und Mehrwert
› Wärme- und schalldämmend
› Wasserabweisend
› Diffusionsoffen
› Zweiseitig aufgebrachte Haftbeschichtung
› Chemisch neutral
› Alterungsbeständig
› Druckbelastbar

› Anwendungstyp WAP-zg nach DIN 4108-10
› Bemessungswert der Wärmeleitfähigkeit λ = 0,035 W/(mK)
› Bis 400 mm Dämmstoffdicke verarbeitbar (Aufdopplung)
Die nichtbrennbare Laibungsdämmplatte MW Wolle 035 Laibung plus mit beidseitiger Haftbeschichtung ist Systembestandteil der WARM-WAND Systeme.
Details finden Sie im techn. Blatt P365k.de
Eigenschaften und Mehrwert
› MW nach DIN EN 13162
› Anwendungstyp WAP-zg nach DIN 4108-10
› Brandverhalten A1
› Bemessungswert der Wärmeleitfähigkeit λ = 0,036 W/(mK)
› Plattenmaß: 400 x 1200 mm

› Kantenausbildung stumpf
› Bei Baustellenlieferung nur ganze Paletten lieferbar
› Wärme- und schalldämmend
› Diffusionsoffen
› Druckbelastbar
Die nichtbrennbare Fassadendämmplatte MW Wolle 035 verfügt über eine verdichtete Oberlage auf der Außenseite und eine flexible, weiche Rückseite. Diese flexible Plattenseite ermöglicht ein einfaches Verkleben auf das Mauerwerk und gleicht leichte Unebenheiten perfekt aus. Die verdichtete Außenseite der Dämmplatte ist besonders stabil und stellt eine hohe mechanische Festigkeit der Fassade sicher und ermöglicht eine noch zuverlässigere Dübelmontage.
MW Wolle 035 ist Systembestandteil der WARMWAND Systeme Plus und Duo. Eine zusätzliche Dübelung ist erforderlich.
MW Wolle 035 ist bis zu einer Plattendicke von max. 300 mm auf Anfrage bestellbar. Die zulässige Dämmstoffdicke im System beträgt 400 mm (Aufdopplung).
Details finden Sie im techn. Blatt P365a.de
Eigenschaften und
› Brandverhalten A1

› Wärme- und schalldämmend
› Wasserabweisend
› Schallabsorbierend
› Diffusionsoffen
› Chemisch neutral
› Alterungsbeständig
› Bemessungswert der Wärmeleitfähigkeit λ = 0,035 W/(mK)
› Druckfester Dämmstoff
Die nichtbrennbare Laibungsdämmplatte MW Wolle 035 Laibung mit einer höheren verdichteten Oberfläche auf der Armierseite ist Systembestandteil der WARM-WAND Systeme.
Details finden Sie im techn. Blatt P365l.de
Eigenschaften und Mehrwert
› MW nach DIN EN 13162
› Anwendungstyp WAP-zg nach DIN 4108-10
› Brandverhalten A1
› Bemessungswert der Wärmeleitfähigkeit λ = 0,035 W/(mK)
› Plattenmaß: 400 x 1200 mm

› Kantenausbildung stumpf
› Bei Baustellenlieferung nur ganze Paletten lieferbar
Die nichtbrennbare Mineralwolle-Lamellenplatte
MW Volamit 040 im handlichen Format und beidseitiger Haftbeschichtung ist Systembestandteil der WARM-WAND Plus, Duo, Keramik und Naturstein. Auf Grund der Faserausrichtung muss der Dämmstoff mit Putzbeschichtung im Neubau bis zu einer Windlast von 1,59 kN/m² nicht gedübelt werden. Der Kleberauftrag kann maschinell teil- oder vollflächig auf die Wand oder vollflächig auf die Dämmplatte aufgebracht werden. Ab einer Dicke von 300 mm erfolgt die Auslieferung in unbeschichteter Ausführung.
Details finden Sie im techn. Blatt P366.de
Eigenschaften und Mehrwert
› Mineralwolle-Dämmplatte WAP-zh gem. DIN 4108-10

› Brandverhalten A1
› Bemessungswert der Wärmeleitfähigkeit λ = 0,041 W/(mK)
› Diffusionsoffen
› Beidseitig aufgebrachte Haftbeschichtung
› Chemisch neutral
› Alterungsbeständig
› Formstabil
› Druckfester Dämmstoff
› Bis 400 mm Dämmstoffdicke bei nur geklebter Variante verarbeitbar
Mit einem Bemessungswert der Wärmeleitfähigkeit von 0,035 W/(mK) und dem Format 200 x 1200 mm die wirtschaftliche Lösung für den Brandschutz. Brandriegel und Brandbarrieren werden vollflächig verklebt und zusätzlich gedübelt. Die nichtbrennbare Mineralwolle-Dämmplatte MW Brandriegel 035 plus im handlichen Format und beidseitig aufgebrachter Haftbeschichtung ist bei EPS Fassade als Brandriegel oder Brandbarriere bei Dämmstoffdicken ab 100 mm einsetzbar.
Eigenschaften und Mehrwert
› MW nach DIN EN 13262
› Anwendungstyp WAP nach DIN 4108-10
› Brandverhalten A1
› Bemessungswert der Wärmeleitfähigkeit λ = 0,035 W/(mK)
› Plattenmaß: 200 x 1200 mm

› Kantenausbildung stumpf
› Beidseitig aufgebrachte Haftbeschichtung
› Bei Baustellenlieferung nur ganze Paletten lieferbar
MW Kellerdeckendämmplatte 035 plus wird mit Duo-Kleber oder SM700 Pro im Randwulst-Punkt-Verfahren oder vollflächig auf der Seite mit den beschichtungsfreien Streifen verklebt. Ab einer Dämmstoffstärke von ≥ 180 mm die Verklebung zwingend vollflächig und mit Duo-Kleber ausführen. Eine zusätzliche Verdübelung kann ggf. erforderlich sein. Nicht für die Anwendung im WDVS.
Die nichtbrennbare MW Kellerdeckendämmplatte 035 plus mit beidseitiger Haftbeschichtung eignet sich besonders als unterseitige Dämmung von Keller-, Garagen- und Hallendecken mit untergeordneten optischen Ansprüchen.
Details finden Sie im techn. Blatt D391.de
Eigenschaften und Mehrwert
› Anwendungstyp DI nach DIN 4108-10
› Wärme- und schalldämmend
› Schallabsorbierend
› Bemessungswert der Wärmeleitfähigkeit λ = 0,035 W/(mK)
› Diffusionsoffen
› Dimensions- und formstabil
› Beidseitig aufgebrachte Haftbeschichtung
› Kantenausbildung stumpf
› Schallabsorbierend
› Plattenmaß: 400 x 1200 mm

Nicht für die Anwendung im WDVS. Für die Anwendung mit untergeordneten optischen Ansprüchen. Die nichtbrennbare MW Kellerdeckendämmplatte 035 vlies mit einseitiger Vlieskaschierung eignet sich besonders zur Dämmung von Decken und Wänden in Industrie- und Gewerbehallen oder im Kellerbereich. MW Kellerdeckendämmplatte 035 vlies wird mit der geriffelten Seite vollflächig mit Duo-Kleber oder SM700 Pro auf einen tragfähigen Untergrund verklebt. Ab einer Dämmstoffstärke von ≥ 180 mm die Verklebung zwingend mit Duo-Kleber ausführen. Die vliesbeschichtete Seite ist die Sichtseite und darf nicht überputzt und farblich beschichtet werden.
Details finden Sie im techn. Blatt D391V.de
Eigenschaften und Mehrwert
› Anwendungstyp DI nach DIN 4108-10
› Brandverhalten A1
› Bemessungswert der Wärmeleitfähigkeit λ = 0,035 W/(mK)
› Wärme- und schalldämmend
› Schallabsorbierend
› Diffusionsoffen
› Formstabil
› Plattenmaß: 600 x 1200 mm

› Kantenausbildung stumpf
› Bei Baustellenlieferung nur ganze Paletten lieferbar

Die Fassadendämmplatte EPS Standard 031 mit sehr guten Wärmedämmeigenschaften bei geringen Dicken mit stumpfer Kantenausbildung ist Systembestandteil der Wärmedämm-Verbundsysteme WARMWAND Basis, Duo, Keramik und Naturstein. Bei höheren Anforderungen, z. B. an den Schallschutz, können vollelastifizierte Dämmplatten angefragt werden.
Details finden Sie im techn. Blatt P361d.de
Eigenschaften und Mehrwert
› Anwendungstyp WAP nach DIN 4108-10
› Brandverhalten B1
› Bemessungswert der Wärmeleitfähigkeit λ = 0,031 W/(mK)
› Form- und alterungsbeständig

Bei höheren Anforderungen, z. B. an den Schallschutz, können vollelastifizierte Dämmplatten angefragt werden.
Die Fassadendämmplatte EPS Nut&Feder 032 mit hohen Wärmedämmeigenschaften bei geringen Dicken, Nut- und Federausbildung sowie umlaufender Mörteltasche zur Vermeidung von Wärmebrücken ist Systembestandteil der Wärmedämm-Verbundsysteme
WARM-WAND Basis, Duo, Keramik und Naturstein. Das aufwendige Überschleifen der Oberfläche entfällt.
Details finden Sie im techn. Blatt P363a.de
Eigenschaften und Mehrwert
› Anwendungstyp WAP nach DIN 4108-10
› Brandverhalten B1
› Bemessungswert der Wärmeleitfähigkeit λ = 0,032 W/(mK)
› Form- und alterungsbeständig
› Nut- und Federausbildung
› Mörteltasche

Eine zusätzliche Verschattung der Fassade ist nicht erforderlich. Zusätzlich bindet der Armiermörtel optimal auf der Oberfläche ab – ein Aufbrennen und ein Festigkeitsverlust wird dadurch vermieden. Die zweischichtige Fassadendämmplatte EPS Sunja 032 mit hohen Wärmedämmeigenschaften und stumpfer Kantenausbildung ist Systembestandteil der WARM-WAND Basis, Duo, Keramik und Naturstein. Details finden Sie im techn. Blatt P362a.de
Eigenschaften und Mehrwert
› Anwendungstyp WAP nach DIN 4108-10
› Brandverhalten B1
› Graue Dämmplatte mit weißer Oberfläche
› Keine zusätzliche Verschattung der Fassade erforderlich
› Bemessungswert der Wärmeleitfähigkeit λ = 0,032 W/(mK)
› Form- und alterungsbeständig

Bei höheren Anforderungen, z. B. an den Schallschutz, können vollelastifizierte Dämmplatten angefragt werden.
Die Fassadendämmplatte EPS Standard 032 mit sehr guten Wärmedämmeigenschaften bei geringen Dicken mit stumpfer Kantenausbildung ist Systembestandteil der Wärmedämm-Verbundsysteme WARMWAND Basis, Duo, Keramik und Naturstein.
Details finden Sie im techn. Blatt P361a.de
Eigenschaften und Mehrwert
› Anwendungstyp WAP nach DIN 4108-10
› Brandverhalten B1
› Bemessungswert der Wärmeleitfähigkeit λ = 0,032 W/(mK)
› Form- und alterungsbeständig

Die Fassadendämmplatte EPS Standard 034 mit hohen Wärmedämmeigenschaften bei geringen Dicken mit stumpfer Kantenausbildung ist Systembestandteil der Wärmedämm-Verbundsysteme WARM-WAND Basis, Duo, Keramik und Naturstein. Bei höheren Anforderungen, z. B. an den Schallschutz, können vollelastifizierte Dämmplatten angefragt werden.
Details finden Sie im techn. Blatt P361b.de
Eigenschaften und Mehrwert
› Anwendungstyp WAP nach DIN 4108-10
› Brandverhalten B1
› Bemessungswert der Wärmeleitfähigkeit λ = 0,034 W/(mK)
› Form- und alterungsbeständig
Die Fassadendämmplatte EPS Standard 035 weiß mit hohen Wärmedämmeigenschaften bei geringen Dicken mit stumpfer Kantenausbildung ist Systembestandteil der Wärmedämm-Verbundsysteme WARMWAND Basis, Duo, Keramik und Naturstein.
Details finden Sie im techn. Blatt P361c.de
und Mehrwert
› Anwendungstyp WAP nach DIN 4108-10
› Brandverhalten B1
› Bemessungswert der Wärmeleitfähigkeit λ = 0,035 W/(mK)
› Form- und alterungsbeständig
› Plattenmaß: 500 x 1000 mm

Hochleistungs-Fassadendämmplatte aus Phenolharz-Hartschaum mit beidseitiger Vlieskaschierung ist Systembestandteil der WARM-WAND Slim.
Die geschlossene Zellstruktur erreicht mit der leichten Dämmplatte schon bei geringen Dämmstoffdicken eine hoch effiziente Wärmedämmung.
Details finden Sie im techn. Blatt P367.de
Eigenschaften und Mehrwert
› Brandverhalten C-s2, d0
› Bemessungswert der Wärmeleitfähigkeit:
Plattendicke < 45 mm = 0,022 W/(mK)
› Bemessungswert der Wärmeleitfähigkeit:
Plattendicke 45 mm - 120 mm = 0,021 W/(mK)
› Bemessungswert der Wärmeleitfähigkeit:
Plattendicke > 120 mm = 0,022 W/(mK)
› Maximale Dämmleistung bei minimaler Dicke
› Kantenausbildung stumpf
› Plattenmaß: 400 x 1200 mm

› Leichte Verarbeitung
› Beidseitige Vlieskaschierung
› Handliches Format
Hochleistungs-Fassadendämmplatte aus Polyurethan-Hartschaum ist Systembestandteil des Wärmedämm-Verbundsystems WARM-WAND Slim.
Durch die besondere geschlossene Zellstruktur und eine spezielle mineralische Beschichtung kann schon bei geringen Dämmstoffdicken ein hocheffizientes WARM-WAND System mit dauerhaftem und kraftschlüssigem Haftverbund zwischen Dämmung und Untergrund hergestellt werden.
Details finden Sie im techn. Blatt P370.de
Eigenschaften und Mehrwert
› Anwendungstyp WAP nach DIN 4108-10
› Brandverhalten: WDVS schwerentflammbar
› Kantenausbildung stumpf
› Plattenmaß: 500 x 1000 mm

› Mit minimaler Dicke maximale Dämmleistung
› Besonders geeignet für Passivhausbau
› Auch im Sockelbereich einsetzbar
› Bemessungswert der Wärmeleitfähigkeit:
Plattendicke ≤ 80 mm 0,026 W/(mK), Plattendicke < 120 mm 0,025 W/(mK), Plattendicke ≥ 120 mm 0,024 W/(mK)
› Sehr leicht schleifbar
› Versenkte Dübelmontage
Die Sockeldämmplatte 035 mit geprägter Oberfläche für einen optimalen Haftverbund ist einsetzbar im Spritzwasser- und erdberührten Bereich. Sie ist optimal auf die WARM-WAND Systeme abgestimmt. Anwendung auf bereits ausgeführte Bauwerksabdichtung, auch als Perimeterdämmplatte, für Einbautiefe bis max. 3 m.
Details finden Sie im techn. Blatt P361s.de
Eigenschaften und Mehrwert
› EPS nach DIN EN 13163
› Anwendungstyp nach ETA und abG: bei Dämmstoffstärken von 60 mm bis 300 mm
› WAP nach DIN 4108-10: bei Dämmstoffstärken 30 mm bis 50 mm und > 300 mm
› Brandverhalten B1
› Bemessungswert der Wärmeleitfähigkeit im Sockelbereich λ = 0,035 W/(mK)
› Bemessungswert der Wärmeleitfähigkeit im Erdreich λ ≤ 0,041 W/(mK)
› Dämmstoffstärken größer 200 mm bis einschließlich 300 mm sind mit einer Kantenprofilierung (Stufenfalz) versehen
› Plattenmaß: 500 x 1000 mm

› Geprägte Oberfläche bei Dicken von 60 mm bis 300 mm
› Lieferzeit bei Dämmstoffdicke >200 mm auf Anfrage
Die Sockeldämmplatte 032 mit geprägter Oberfläche für einen optimalen Haftverbund ist einsetzbar im Spritzwasser- und erdberührten Bereich. Sie ist optimal auf die WARM-WAND Systeme abgestimmt. Anwendung auf bereits ausgeführte Bauwerksabdichtung, auch als Perimeterdämmplatte, für Einbautiefe bis max. 3 m. Graphitfarbene Zuschläge für eine verbesserte Wärmedämmung bei geringen Dicken.
Details finden Sie im techn. Blatt P361r.de
Eigenschaften und Mehrwert
› EPS nach DIN EN 13163
› Anwendungstyp nach ETA und abG: bei Dämmstoffstärken von 60 mm bis 300 mm
› WAP: bei Dämmstoffstärken 40 mm und 50 mm
› Brandverhalten B1
› Plattenmaß: 500 x 1000 mm

› Geprägte Oberfläche bei Dicken von 60 mm bis 300 mm
› Bemessungswert der Wärmeleitfähigkeit im Sockelbereich λ = 0,032 W/(mK)
› Bemessungswert der Wärmeleitfähigkeit im Erdreich λ = 0,036 W/(mK)
› Dämmstoffstärken größer 200 mm bis einschließlich 300 mm sind mit einer Kantenprofilierung (Stufenfalz) versehen
Vorbehandlungen
Gipsputze
Spachtel pastös
Kalkputze
Unterputze
Oberputze
Sanierung
Dämmschüttungen
Innendämmung
WARM-WAND Dämmstoffe
WARM-WAND Klebe- und Armiermörtel
WARM-WAND Zubehör
AQUAPANEL® VHF
Gestaltungselemente
Farben
WARM-WAND
Klebe- und Armiermörtel
Mineralische Klebe- und Armiermörtel
Organische Klebe- und Armiermörtel
Klebeschaum
Sockelausbildung
Klebe- und Fugenmörtel
Systemgeprüfter, mineralischer, universeller Alleskönner für die Fassade und den Sockel. SM700 Pro eignet sich insbesondere für das Verkleben und Armieren aller Knauf WARM-WAND Systeme. Die spezielle Faserverstärkung bietet dabei höchste Sicherheiten. SM700 Pro kann naturweiß oder eingefärbt als Oberputz gefilzt oder frei strukturiert werden. Auch als universeller Renoviermörtel zur Überarbeitung von Putzen und Fassaden ist SM700 Pro bestens geeignet. Für besondere Highlights an der Fassade kann SM700 Pro auch in Besenstrich-, Kammzugtechnik, Betonoptik oder sonstigen Oberputzstrukturen aufgebracht werden.

Details finden Sie im techn. Blatt P241c.de
Eigenschaften und Mehrwert
› Normalputzmörtel GP nach DIN EN 998-1
› Druckfestigkeitskategorie CS III nach DIN EN 998-1
› Faser- und Haftzusatz
› Sehr hoch wasserabweisend
› Sehr hohe Klebekraft
› Diffusionsoffen
› Körnung 1,0 mm
› Farbton weiß (ca. RAL 9001)
› Eingeschränkt tönbar nach Farbtonfächer Knauf ColorConcept
Diese Angaben sind Zirka-Werte und können je nach Art des Untergrundes abweichen.
Systemgeprüfter, mineralischer Alleskönner für die Fassade. SM700 eignet sich insbesondere für das Verkleben und Armieren aller Knauf WARM-WAND Systeme sowie als Renoviermörtel und als Haftmörtel.

Details finden Sie im techn. Blatt P241a.de
Eigenschaften und Mehrwert
› Normalputzmörtel GP nach DIN EN 998-1
› Druckfestigkeitskategorie CS III nach DIN EN 998-1
› Faser- und Haftzusatz
› Sehr hoch wasserabweisend
› Sehr hohe Klebekraft
› Diffusionsoffen
› Körnung 1,5 mm
› Farbton grau
WARM-WAND Klebe- und Armiermörtel

Systemgeprüfter, mineralischer Klebe- und Armiermörtel für alle Knauf WARM-WAND Systeme im Massivbau. Auch als Renovier- und Haftmörtel einsetzbar.
Details finden Sie im techn. Blatt P248.de
Eigenschaften und Mehrwert
› Normalputzmörtel GP nach DIN EN 998-1
› Druckfestigkeitskategorie CS III nach DIN EN 998-1
› Mit Haftzusatz
› Hoch wasserabweisend
› Hohe Klebekraft
› Diffusionsoffen
› Körnung 1,0 mm
› Farbton grau
Diese Angaben sind Zirka-Werte und können je nach Art des Untergrundes abweichen.

Systemgeprüfter, mineralischer, hochergiebiger und ultraleichter Klebe- und Armiermörtel für Knauf WARM-WAND Systeme Basis und Plus.
Details finden Sie im techn. Blatt P246.de
Eigenschaften und Mehrwert
› Leichtputzmörtel LW nach DIN EN 998-1
› Druckfestigkeitskategorie CS II nach DIN EN 998-1
› Faser- und Haftzusatz
› Leichtzuschlag aus Polystyrol
› Wasserabweisend
› Hohe Klebekraft
› Diffusionsoffen
› Körnung 1,2 mm
› Farbton naturweiß
Diese Angaben sind Zirka-Werte und können je nach Art des Untergrundes abweichen.

Systemgeprüfter, mineralischer, hochergiebiger und ultraleichter Klebe- und Armiermörtel für Knauf WARM-WAND Systeme Basis und Plus, bei nachfolgender Beschichtung mit Mak3. Auch als Haftmörtel bei Verwendung von Leichtunterputzen einsetzbar.
Details finden Sie im techn. Blatt P246.de
Eigenschaften und Mehrwert
› Leichtputzmörtel LW nach DIN EN 998-1
› Druckfestigkeitskategorie CS II nach DIN EN 998-1
› Faser- und Haftzusatz
› Leichtzuschlag aus Polystyrol
› Wasserhemmend
› Hohe Klebekraft
› Diffusionsoffen
› Körnung 1,2 mm
› Farbton naturweiß
Systemgeprüfter, mineralischer Spezialkleber mit optimierter Früh-Abbindereaktion auf nicht oder schlecht saugenden Untergründen für Knauf WARM-WAND Duo zur Aufdopplung bestehender Altfassaden. Duo-Kleber eignet sich außerdem insbesondere für die Verklebung der Satt Platten, Fassadenprofile, Perfex Jalousiekasten und Jalousieschürze sowie der Kellerdeckendämmplatte 035.
Details finden Sie im techn. Blatt P393.de
Eigenschaften und Mehrwert
› Normalputzmörtel GP nach DIN EN 998-1
› Druckfestigkeitskategorie CS IV nach DIN EN 998-1
› Mit Haftzusatz
› Mineralischer Klebemörtel mit optimierter Abbindereaktion

› Wasserabweisend
› Sehr hohe Klebekraft
› Diffusionsoffen
› Farbton grau
› Für innen und außen
› Verarbeitung mit Maschine oder von Hand
Diese Angaben sind Zirka-Werte und können je nach Art des Untergrundes abweichen.
Systemgeprüfter, mineralischer Klebe- und Armiermörtel für Knauf WARM-WAND Systeme im Holzbau.
Details finden Sie im techn. Blatt P247.de
Eigenschaften und Mehrwert
› Normalputzmörtel GP nach DIN EN 998-1
› Druckfestigkeitskategorie CS III nach DIN EN 998-1
› Faser- und Haftzusatz
› Verarbeitung mit Maschine oder von Hand
› Farbton naturweiß
Pastol Dry zeichnet sich durch eine leichte und geschmeidige Verarbeitung aus und weist ein vergleichsweise geringes Transportgewicht auf. Ein Reinigen der Maschine ist über Nacht mit Pastol Dry nicht notwendig.
Organisch gebundene, systemgeprüfte Klebe-und Armiermasse zum Einsatz in WARM-WAND Plus und EPS im Holzbau. Pastol Dry enthält mineralische Leichtzuschläge für eine hohe Ergiebigkeit. Zum Kleben von Dämmstoffplatten aus EPS und Mineralwolle auf Plattenwerkstoffen zum Armieren von EPS-Dämmstoffplatten im Holzbau.

Details finden Sie im techn. Blatt P394b.de
Eigenschaften und Mehrwert
› Faserverstärkt mit mineralischen Leichtzuschlägen
› Hohe Klebekraft
› Hohes Standvermögen
› Farbton naturweiß

› Organisch gebunden
› Verarbeitung mit Maschine oder von Hand
› Wasserabweisend

Verarbeitungsfertig eingestellte, organisch gebundene, faser- und siliconverstärkte Klebe- und Armiermasse mit mineralischen Leichtzuschlägen für eine hohe Ergiebigkeit zum Kleben und Armieren des Wärmedämm-Verbundsystems WARM-WAND Basis sowie zur Verklebung von Dämmstoffplatten aus EPS auf Plattenwerkstoffe im Holzbau.
Details finden Sie im techn. Blatt P394.de
Eigenschaften und Mehrwert
› Faser- und Siloxanverstärkt
› Hohe Schlagfestigkeit
› Mit Leichtzuschlag
› Wasserabweisend
› Hohe Klebekraft
› Leichte Verarbeitung
› Hohes Standvermögen
› Farbton naturweiß
› Verarbeitung mit Maschine oder von Hand
Diese Angaben sind Zirka-Werte und können je nach Art des Untergrundes abweichen.
Einkomponentiger, selbstexpandierender Polyurethanschaum zur Verklebung des Wärmedämm-Verbundsystems WARM-WAND Basis und Plus, zur Verklebung von Perfex Laibungsplatte und Perfex Keilplatte sowie zum Ausschäumen von Dämmplattenfugen.
Details finden Sie im techn. Blatt P392.de
Eigenschaften und Mehrwert
› Hohe Ergiebigkeit
› Schnelle Verarbeitung
› Zum Ausschäumen von Plattenfugen sehr gut geeignet
› Armierung bereits nach 2 Stunden möglich
› Sehr gute Klebkraft auf tragfähigen Beton- und Mauerwerksuntergründen sowie Bitumendickbeschichtungen
› Kostenlose Entsorgung der Verpackung mit dem PDR System

Sockel-SM Pro ist als systemgeprüfter, mineralischer Alleskönner als Klebemörtel, Armiermörtel und Oberputz universell im Spritzwasserbereich einsetzbar. Bei Verwendung als Armiermörtel und Oberputz, bei einer Gesamtputzdicke 7 mm, ist kein zusätzlicher Schutz des Putzes vor Bodenfeuchte (Feuchteschutz) notwendig. Das spart ein zusätzliches Produkt und eine Anfahrt auf die Baustelle und macht bei der Anlage der Geländeoberkante flexibel. Der Nachweis des Feuchteschutzes ist durch ein allgemeines bauaufsichtliches Prüfzeugnis bestätigt. Als Klebemörtel und mineralische Haftbrücke auf mineralischer Dichtungsschlämme (MDS), Bitumendickbeschichtung (PMBC) und bestreuter Polymerbitumen-Schweißbahn. Als Armiermörtel und gefilzter Oberputz auf Sockelputze.
Als Klebemörtel, wenn kapillar nicht leitfähige Klebemörtel gefordert sind. Als Armiermörtel und Oberputz auf Beton und Mauerwerk.
Details finden Sie im techn. Blatt P213.de
Eigenschaften und Mehrwert
› Normalputzmörtel GP nach DIN EN 998-1
› Druckfestigkeitskategorie CS IV nach DIN EN 998-1
› Für innen und außen
› Als Putzhaftbrücke einsetzbar
› Integrierter Feuchteschutz
› Nicht kapillar leitend
› Dicht-, Faser- und Haftzusatz
› Verarbeitung mit Maschine oder von Hand
› Körnung 1,0 mm
› Farbton grau
Diese Angaben sind Zirka-Werte und können je nach Art des Untergrundes abweichen.
Systemgeprüfter, mineralischer und universeller Alleskönner im Spritzwasserbereich. Als Klebemörtel bei Sockeldämmplatten, als Armiermörtel und gefilzter Oberputz auf Sockeldämmplatten und Sockelputzen. Als mineralische Haftbrücke bei Sockelputzen.
Details finden Sie im techn. Blatt P213.de
Eigenschaften und Mehrwert
› Normalputzmörtel GP nach DIN EN 998-1
› Druckfestigkeitskategorie CS IV nach DIN EN 998-1
› Für innen und außen
› Als Putzhaftbrücke einsetzbar
› Faser- und Haftzusatz
› Wasserabweisend
› Körnung 1,0 mm
› Verarbeitung mit Maschine oder von Hand
› Farbton grau
Diese Angaben sind Zirka-Werte und können je nach Art des Untergrundes abweichen.
Flexible Dichtschlämme für den Feuchteschutz im Sockel-Bereich
Rissüberbrückende, mineralische und flexible Dichtschlämme als Putzabdichtung auf Außenputzen, die ins Erdreich einbinden. Als mineralische, rissüberbrückende Dichtschlämme (MDS) zur Anwendung nach DIN 18533 und als rissüberbrückende, mineralische Dichtschlämme (CM) zur Anwendung nach DIN 18534.
Details finden Sie im techn. Blatt P292a.de
Eigenschaften und Mehrwert
› Einkomponentige, zementgebundene Dichtschlämme
› Allgemeine bauaufsichtliche Prüfzeugnisse P-AB074-03 und 084-03
› Für innen und außen
› Wasserundurchlässig
› Hoch flexibel
› Rissüberbrückung bis 0,2 mm
› Überstreich- und überputzbar
› Streich- und spachtelfähig
› Lösemittelfrei
› Verarbeitung von Hand

Diese Angaben sind Zirka-Werte und können je nach Art des Untergrundes abweichen.

Polymervergüteter Fliesenkleber für die Verlegung von keramischen Fliesen- und Plattenbelägen auf Wärmedämm-Verbundsystem WARM-WAND Keramik.
Erfüllt die festgelegten Anforderungen für Trinkwasserbereiche gemäss DVGW-Arbeitsblätter W 347 (Hygienische Anforderungen im Trinkwasserbereich) und W 270 (Einsatz im Trinkwasserbereich).
Details finden Sie im techn. Blatt K512a.de
Eigenschaften und Mehrwert
› Für außen
› Verarbeitung von Hand
› Weniger Staub
› Brandverhalten A1
› Hohes Standvermögen
› Haftfestigkeit gemäß DIN EN 1348 > 1,0 N/mm²
› Geschmeidige Konsistenz
› Hydraulisch abbindend
› Verringertes Abrutschen
› Hoch vergütet
Hoch flexibler Fugenmörtel zum Verfugen von keramischen Fliesen- und Plattenbelägen auf Wärmedämm-Verbundsystem WARM-WAND Keramik.
Details finden Sie im techn. Blatt K512b.de
Eigenschaften und Mehrwert
› Für außen
› Verarbeitung von Hand

› Wasserabweisend
› Frostwiderstandsfähig
› Hoch flexibel
› Abriebfest
› Geschmeidige Konsistenz
› Hydraulisch abbindend

› Rissfrei aushärtend
› Verformungsfähig
Vorbehandlungen
Gipsputze
Spachtel pastös
Kalkputze
Unterputze
Oberputze
Sanierung
Dämmschüttungen
Innendämmung
WARM-WAND Dämmstoffe
WARM-WAND Klebe- und Armiermörtel
WARM-WAND Zubehör
AQUAPANEL® VHF
Gestaltungselemente
Farben
WARM-WAND
Zubehör Sockel
Dübel
Armiergewebe
Gewebeeckwinkel
Fensteranschlussprofile
Gewebeleisten
Befestigungselemente
Dichtbänder
Perfex
2. Fenster-Dichtebene
Die Peri Montageschiene, erhältlich in 3 verschiedenen Ausladungen, bildet mit dem Sockel-Abschlussprofil Peri eine geschlossene Fläche zum Abschluss der WDVS-Dämmung für Dämmstärken von 50 bis 200 mm.
Details finden Sie im techn. Blatt P385p.de
Eigenschaften und Mehrwert
› Ausladung 50 mm für Dämmstoffdicken bis zu 90 mm in Verbindung mit Sockel-Abschlussprofil Peri
› Ausladung 100 mm für Dämmstoffdicken bis zu 140 mm in Verbindung mit Sockel-Abschlussprofil Peri


› Ausladung 160 mm für Dämmstoffdicken bis zu 200 mm in Verbindung mit Sockel-Abschlussprofil Peri
Die Peri Verlängerung aus Kunststoff erweitert die Ausladung der Peri Montageschiene um 30 bis 50 mm. In Kombination mit dem Peri Sockel-Abschlussprofil, zwei Verlängerungen und der Peri Montageschiene (Ausladung 160 mm) sind damit Dämmstärken bis 300 mm möglich.
Details finden Sie im techn. Blatt P385p.de
Eigenschaften und Mehrwert
› Wärmebrückenfrei
› Farbe: weiß
Kunststoff Sockel-Abschlussprofil Peri für einen wärmebrückenfreien Sockelabschluss zwischen Sockelund Fassadendämmung mit integrierter Tropfkante. Einsatz bei Überstand der Fassadendämmung zur Sockeldämmung bis 50 mm.
Details finden Sie im techn. Blatt P385p.de
Eigenschaften und Mehrwert
› Wärmebrückenfrei
› Keine mechanische Befestigung erforderlich
› Leichte Verarbeitung
› Für alle Dämmstoffdicken im Sockelbereich
› Für jede Putzausführung das passende Profil
› Mit integriertem Armiergewebe
› Fluchtrechte Stoßverbindungen
› Gewebeschenkel 125 mm

Das Sockelabschlussprofil ist auch variabel erhältlich und besteht aus zwei übereinanderliegenden Profilen, einsetzbar für Dämmstoffdicken von 200 mm bis 300 mm.
Trogprofil aus Aluminium zur Aufnahme von Dämmplatten als Sockelprofil.

Details finden Sie im techn. Blatt P385s.de
Eigenschaften und Mehrwert
› Aluminium
› Ohne Abzugskante
› Mit Tropfkante
› Für Sockel-Aufsteckprofil mit 6, 10 und 14 mm Abzugskante
Wahlweise mit 6 mm Abzugskante, 10 mm Abzugskante für dickschichtige Systeme oder 14 mm Abzugskante für dickschichtige Systeme und für Kratzputz.
Kunststoff-Aufsteckprofil mit Tropfkante und 100 mm breitem Gewebeschenkel für das Sockel-Abschlussprofil für höhere Risssicherheit.
Details finden Sie im techn. Blatt P385s.de
Eigenschaften und Mehrwert
› Kunststoff weiß
› Tropfkante
› Abzugskante 6 mm, 10 mm oder 14 mm
› Gewebeschenkel 100 mm
Montageset für die Montage von 25 m Sockel-Abschlussprofilen bestehend aus 10 H-Verbindern, 50 Unterlegscheiben und 75 Nageldübeln.
Details finden Sie im techn. Blatt P385s.de
Eigenschaften und Mehrwert
› Verbinder für Abschlussprofil PVC


› Verbindungsteil verhindert Versprünge an Stoßstellen von Abschlussprofilen
› Unterlegscheiben zum Ausgleichen von Unebenheiten bei der Befestigung von Sockel-Abschlussprofilen
› Nageldübel zur Befestigung von Sockel-Abschlussprofilen
› Nageldübel für Beton, Vollstein und Lochsteinmauerwerk
› Verankerungstiefe der Nageldübel mind. 50 mm
› Bohrer Ø 8 mm
Die Sockel-Schutzplatte Vandalit wird an stark beanspruchten Flächen als Wandschutzplatte bei WARMWAND Systemen auf Sockelflächen verwendet.
Die Platte wird vollflächig (10 mm Zahntraufel) auf die um 20 mm zurückgesetzte Sockeldämmung aufgeklebt. Nach Verfestigung, jedoch immer am Verlegetag, mit 5 Schraubdübeln STR U 2G pro Platte befestigen. Nach Plattenverlegung sofort eine vollflächige Gewebearmierung mit SM300, SM700
Pro oder Sockel-SM auftragen. Diese ist auch im Übergang zur Wärmedämmung in 30 cm Breite anzuordnen. Die Flächenarmierung wird als zweite Lage über diese Sockelarmierung geführt.
Details finden Sie im techn. Blatt P383.de
Eigenschaften und Mehrwert
› Brandverhalten A2
› Rohdichte 1200 kg/m³
› Bemessungswert der Wärmeleitfähigkeit λ = 0,030 W/(mK)
› Plattenmaß: 600 x 1250 mm

› Plattendicke: 10 mm
› Vormontierte, versenkte Bohrlöcher
› Formstabil
Europäisch technisch zugelassener Schlagdübel mit der Option zum Schrauben mit innovativem Verbundnagel für die oberflächenbündige und versenkte Verdübelung (in EPS) von WARM-WAND Systemen. Mit einer integrierten Kompressionszone und den nur 2,5 mm dicken Tellerstärken werden die Dübelteller kontrolliert bündig in den Dämmstoff eingezogen. Durch das asymmetrische Spreizelement und die Stahlspitze des glasfaserverstärkten Verbundnagels werden hohe Auszuglasten erreicht. Auch anwendbar zur Befestigung von Brandriegeln in der Schutzzone Sockel- und Raumbrand.
Details finden Sie im techn. Blatt P389i.de
Eigenschaften und Mehrwert
› Nutzungskategorien A, B, C, D und E
› ETA Zulassung ETA-18/0366
› Dübellängen bis 390 mm
› Dübelteller Ø 60 mm
› Bohrer Ø 8 mm
› Verankerungstiefe 35 mm
› Chi-Wert 0,001 (W/K)
› Sehr dünne Tellerstärke 2,5 mm

› Einsetzbar für Slimtherm, Mineralwolle, EPS und Holzfaserdämmplatten
› Auch in Kombination mit Dübelteller DT 90 oder bei MW Volamit 040 mit Dübelteller DT 140
Dübelteller zur Befestigung von MW Wolle-Dämmplatten gemäß allgemeiner bauaufsichtlicher Zulassung bei Dübelung unter dem Armiergewebe in Kombination mit Schlagdübel CNplus 8.
Die Anwendung von Dübeltellern ist abhängig von der Dämmstoffzulassung und kann den jeweiligen Detailblättern der Dämmstoffe entnommen werden.
Dübelteller zur Befestigung von MW Volamit 040 gemäß allgemeiner bauaufsichtlicher Zulassung bei Dübelung unter dem Armiergewebe in Kombination mit Schlagdübel CNplus 8.
Die Anwendung von Dübeltellern ist abhängig von der Dämmstoffzulassung und kann den jeweiligen Detailblättern der Dämmstoffe entnommen werden.


Eigenschaften und Mehrwert
› Erhöhte Montagesicherheit
› Reduzierung der Dübelanzahl bei statischer Relevanz möglich
Eigenschaften und Mehrwert
› Optimal auf Dübelgeometrie abgestimmt
Europäisch technisch zugelassener Schraubdübel für die versenkte oder oberflächenbündige, statisch relevante Verdübelung für alle WARM-WAND Systeme. Einsatzgebiete für alle Verankerungsgründe wie: Beton, Voll- und Lochsteine, Haufwerksporiger Leichtbeton oder Porenbeton.
Details finden Sie im techn. Blatt P389b.de
Eigenschaften und Mehrwert
› Durch minimale Verankerungstiefe von 25 mm (Porenbeton 65 mm) wirtschaftliche Dübellängen
› Sicherheit durch höchste charakteristische Lasten
› 100 % Setzkontrolle, nicht verankerte Dübel werden sofort erkannt
› Für oberflächenbündige und versenkte Montage
› Verwendung für EPS, Mineralwolle-, Holzfaser- und Hochleistungsdämmstoffe
› Für extra dicke Dämmstoffdicken bis 400 mm
› Dauerhafter Anpressdruck

› Vormontierte Schraube für schnelle Montage
› Bei MW Volamit in Kombination mit Dübelteller SBL 140 plus
Europäisch technisch zugelassener Schraubdübel für die oberflächenbündige Montage bei dünnen Dämmstoffplatten im Rotkalk in-System und bei Knauf WARM-WAND Systemen. Zur Verarbeitung des Dübels ist ein IPR 30 (5 Stern) nötig.
Eigenschaften und Mehrwert
› Nutzungskategorien A, B, C, D und E
› ETA Zulassung ETA -17/0991
› Dübelteller Ø 60 mm
› Bohrer Ø 8 mm


› Verankerungstiefe 30 mm
› Verankerungstiefe Porenbeton 50 mm
› Für Dämmstoffe von 20 - 60 mm
› Verankerung in allen Untergründen
› Oberflächenbündige Montage
› Schraubantrieb IPR 30 (5 Stern) benötigt
Montagewerkzeug für die versenkte und oberflächenbündige Montage von Schraubdübel STR U 2G und STR H. Ersatzteilkit für Montagewerkzeug besteht aus je 3 Schneideblechen und Schraubbits.
Details finden Sie im techn. Blatt P389b.de
Eigenschaften und Mehrwert
› Einfache Montage
› Universell einsetzbar
› Robuste Ausführung für hohe Standzeit
› Schnell auswechselbare Verschleißteile
Dübelteller VT 2G ist statisch vergleichbar mit der Anwendung eines Dübeltellers DT 90.
Dübelteller für die vertiefte Montage bei MW Wolle-Dämmplatten in Kombination mit Schraubdübel
STR U 2G gemäß allgemeiner bauaufsichtlicher Zulassung bei Dübelung unter dem Armiergewebe.
Eigenschaften und Mehrwert
› Glasfaserverstärkter Kunststoff
› Ist statisch vergleichbar mit der Anwendung eines 90er-Tellers
› Ist bauphysikalisch vergleichbar mit versenkter Dübelmontage


Die Anwendung von Dübeltellern ist abhängig von der Dämmstoffzulassung und kann den jeweiligen Detailblättern der Dämmstoffe entnommen werden. Dübelteller zur Befestigung von MW Volamit 040 gemäß allgemeiner bauaufsichtlicher Zulassung bei Dübelung unter dem Armiergewebe in Kombination mit Schraubdübel STR U 2G.
Eigenschaften und Mehrwert
› Optimal auf Dübelgeometrie abgestimmt
Verschlussstopfen aus EPS für die oberflächenbündige Montage von Schraubdübel STR U 2G und STR H.
Eigenschaften und Mehrwert
› Dämmstoff EPS
› Farbe: weiß


Rondelle aus EPS für die versenkte Dübelmontage
Rondelle aus EPS in grau und weiß für die versenkte/ vertiefte Dübelmontage von Schraubdübel STR U 2G.
Eigenschaften und Mehrwert
› Dämmstoff EPS
› Farbe: weiß oder grau
Rondelle aus Mineralwolle für die versenkte Dübelmontage von Schraubdübel STR U 2G.
Eigenschaften und Mehrwert
› Dämmstoff: Mineralwolle
Schraubdübel für Holz- und Plattenwerkstoffe
Im Wärmedämm-Verbundsystem zugelassener, vormontierter Schraubdübel für oberflächenbündige Befestigungen bei der Verwendung von Knauf WARMWAND Systemen im Holzbau.
Bei EPS und Mineralwolle ist auch eine versenkte Montage möglich. STR-Stopfen für die oberflächenbündige Montage sind im Lieferpaket enthalten.
Details finden Sie im techn. Blatt P389h.de
Eigenschaften und Mehrwert
› Sehr dünner Dübelteller
› Dauerhafter Anpressdruck


› Vertiefte und oberflächenbündige Montage
› Kompatibel mit STR U 2G Montagewerkzeug und STR-Rondelle für die versenkte Montage
› Korrosionsgeschützte 6 mm Schraube
› Inkl. STR-Stopfen für die oberflächenbündige Montage
Im Wärmedämm-Verbundsystem zugelassener, vormontierter Schraubdübel für oberflächenbündige Befestigungen bei der Verwendung von Knauf WARMWAND Systemen auf Holz- und Plattenwerkstoffen.
Details finden Sie im techn. Blatt P389g.de
Eigenschaften und Mehrwert
› Verankerungstiefe 30 mm
› Korrosionsgeschützte Schraube
› Schraubenantrieb Torx T25

› Dübelteller Ø 60 mm

Durch den Einsatz der Gerüstanker-Verschlussstopfen entsteht eine ruhende Luftschicht im Gerüstankerkanal in der Dämmung, wodurch eine Wärmebrückenwirkung verhindert wird.
Dauerelastischer Gerüstanker-Verschlussstopfen aus feinporigem Polyurethan-Weichschaum für einen schnellen, dauerhaften und schlagregendichten Verschluss von Gerüstlöchern in Knauf WARM-WAND Systemen.
Details finden Sie im techn. Blatt P386s.de
Eigenschaften und Mehrwert
› Überbrückt Lochdurchmessertoleranzen
› UV- und ozonbeständig
› Überstreichbar mit lösemittelfreien Farben
› Wärmebrückenfrei
› Wasserdampfdiffusionsoffen
› Schlagregen- und winddicht
› Verträglich mit allen gängigen lösemittelfreien
Bau- und Dichtstoffen
› Brandverhalten B1
› Keine Entsorgung als Sondermüll
› Schnelle und sichere Verarbeitung
Schraubdübel für die oberflächenbündige Montage für Knauf WARM-WAND Systeme Basis, Plus, Keramik sowie Systemaufdopplungen im Massivbau.
Dübelteller HDT 90 und HDT 140 zur Befestigung von Mineralwolle-Dämmstoffen gemäß allgemeiner bauaufsichtlicher Zulassung bei Dübelung unter dem Armiergewebe.
Eigenschaften und Mehrwert
› Nutzungskategorien A, B, C, D und E
› ETA Zulassung ETA-16/0116
› Dübelteller Ø 60 mm

› Bohrer Ø 8 mm

› Verankerungstiefe 30 mm
› Chi-Wert 0,000 (W/K)
Dübelteller zur Befestigung von Mineralwolle-Dämmstoffen gemäß allgemeiner bauaufsichtlicher Zulassung bei Dübelung unter dem Armiergewebe in Kombination mit Schraubdübel HTR-P. Die Anwendung von Dübeltellern ist abhängig von der Dämmstoffzulassung und kann den jeweiligen techn. Datenblättern oder Systemzulassungen entnommen werden.
Eigenschaften und Mehrwert
› Optimal auf Dübelgeometrie abgestimmt
Dübelteller zur Befestigung von Mineralwolle-Dämmstoffen gemäß allgemeiner bauaufsichtlicher Zulassung bei Dübelung unter dem Armiergewebe in Kombination mit Schraubdübel HTR-P. Die Anwendung von Dübeltellern ist abhängig von der Dämmstoffzulassung und kann den jeweiligen techn. Datenblättern oder Systemzulassungen entnommen werden.
Eigenschaften und Mehrwert
› Optimal auf Dübelgeometrie abgestimmt
Zur tiefenversenkten Montage für Knauf WARMWAND Systeme Basis, Plus. Die Anwendung in den jeweiligen Dämmstoffen ist aus den Systemzulassungen zu entnehmen.
Eigenschaften und Mehrwert
› Einheitliche Verankerungstiefe für alle Baustoffe
› Universelle Größe für Dämmstoffdicken von 100 - 400 mm
› Reduzierung der Komplexität
› Nutzungskategorien A, B, C, D und E
› ETA Zulassung ETA-12/0208
› Dübelteller Ø 66 mm
› Bohrer Ø 8 mm


Verschlussstopfen aus EPS für die tiefenversenkte Montage des Termoz SV II Ecotwist.
Eigenschaften und Mehrwert
› Dämmstoff EPS
› Farbton grau
› Durchmesser 15 mm


› Dicke 40 mm
Robustes Setzwerkzeug mit Anschlagscheibe, für einen einfachen und präzisen Setzvorgang des Termoz SV II Ecotwist.
Eigenschaften und Mehrwert
› Gewährleistung der geforderten Verankerungstiefe
Hoch festes, dauerhaftes, alkalibeständiges Armiergewebe mit einer Maschenweite von 5 x 5 mm für alle WARM-WAND Systeme und zur Rissüberbrückung im Altbaubereich.
Details finden Sie im techn. Blatt K445b.de
Eigenschaften und Mehrwert
› Für innen und außen
› Dauerhaft alkalibeständig
› Maschenweite 5 x 5 mm
› Verschiebefest
› Weiß mit blauen Markierungen
› Zugfestigkeit ≥ 2500 N/5 cm
› Flächengewicht ca. 205 g/m²
Hoch festes, dauerhaftes, alkalibeständiges Armiergewebe mit einer Maschenweite von 4 x 4 mm für WARM-WAND Systeme und im Rotkalk in-System.
Details finden Sie im techn. Blatt K445a.de
Eigenschaften und Mehrwert
› Für innen und außen
› Dauerhaft alkalibeständig
› Maschenweite 4 x 4 mm
› Verschiebefest
› Weiß mit blauen Markierungen
› Zugfestigkeit ≥ 1800 N/5 cm
› Flächengewicht ca. 165 g/m²


Armiergewebe für die Knauf WARM-WAND Basis bei Verwendung von Pastol. Gewebe ≥ 100 mm überlappend, mittig in Pastol einlegen und vollständig überdecken. Auch geeignet für den Einsatz als Armiergewebe in Rotkalk Glätte, wenn die Oberfläche geglättet wird.
GEWEBEECKPFEIL
Maschenweite 6 x 6 mm
Gewebeeckpfeile werden diagonal von allen Öffnungsecken (Fenster, Türen etc.) in den Armiermörtel unter die eigentliche Gewebearmierung oder oberflächennah im Unterputz eingebettet.

Eigenschaften und Mehrwert
› Dauerhaft alkalibeständig
› Maschenweite 3 x 4 mm
› Flächengewicht 150 g/m²

› Zugfestigkeit ca. 1800 N/50mm
Eigenschaften und Mehrwert
› Maschenweite 6 x 6 mm
› Größe 560/400 x 330 mm
› Auch für Unterputz geeignet
Panzergewebe als zusätzlicher Stoßschutz im Sockelbereich und in beanspruchten WARM-WAND Flächen.
Details finden Sie im techn. Blatt K445d.de
Eigenschaften und Mehrwert
› Dauerhaft alkalibeständig
› Maschenweite 8 x 6 mm
› Flächengewicht ca. 340 g/m²


Kunststoff Gewebeeckwinkel mit alkalibeständigem Armiergewebe zur Ausbildung von lot- und fluchtgerechten Außenecken in Knauf WARM-WAND Systemen und im Rotkalk in-System.
Details finden Sie im techn. Blatt P385w.de
Eigenschaften und Mehrwert
› Alkalibeständiges Armiergewebe
› Maschenweite 4 x 4 mm
› Weißes Kunststoffprofil
› UV-beständig

Kunststoff Gewebeeckwinkel mit alkalibeständigem Armiergewebe zur Ausbildung von flexiblen lot- und fluchtgerechten Außen- und Innenecken in Knauf WARM-WAND Systemen. Mit Roll-Eckwinkel sind verschiedene Winkelgrößen ausführbar.
Eigenschaften und Mehrwert
› Alkalibeständiges Armiergewebe
› Maschenweite 4 x 4 mm
› Weißes Kunststoffprofil
› UV-beständig
Gewebeeckwinkel mit alkalibeständigem Armiergewebe zur Ausbildung von flexiblen lot- und fluchtgerechten Außen- und Innenecken in Knauf WARMWAND Systemen.
Details finden Sie im techn. Blatt P385y.de
Eigenschaften und Mehrwert
› Alkalibeständiges Armiergewebe
› Schenkel 70/90 mm

› UV-beständig
› Für innen und außen
› Verschiebefest
Für die Eckenarmierung von Außen- und Innenecken
Für den Einbau in den Eckbereich Sturz/Laibung und für die Diagonalarmierung von Fenster und Türöffnungen. Gewebesturzwinkel werden vor den Gewebeeckwinkel angebracht. Einsetzbar für Laibungstiefen bis 200 mm.
Eigenschaften und Mehrwert
› Alkalibeständiges Armiergewebe
› Maschenweite 4 x 4 mm
Für fluchtrechte und stoßsichere Kanten, überputzbar. Die Abzugskante gewährleistet die vorgegebene Auftragsstärke von 5 – 7 mm bei der Gewebearmierung und vereinfacht die Verarbeitung.
Details finden Sie im techn. Blatt P385k.de
Eigenschaften und Mehrwert
› Kunststoff weiß mit codierter Oberfläche
› Mit Steckverbinder
› Alkalibeständiges Armiergewebe
› Maschenweite 4 x 4 mm
› Gewebeschenkel 125 x 125 mm


Tropfkantenprofil für horizontale, optisch saubere Putzanschlüsse. Aus UV- und witterungsbeständigem, schlagzähem Hart-PVC mit alkalibeständigem Armiergewebe.
Details finden Sie im techn. Blatt P385t.de
Eigenschaften und Mehrwert
› Kunststoff weiß
› Optisch saubere Putzabschlüsse
› Ohne sichtbare Tropfkante
Ausführung mit breitem Kunststoffschenkel sowie verjüngter Abzugskante, speziell für Kratzputzsystem und dickschichtige Putzsysteme.
Details finden Sie im techn. Blatt P385v.de
Eigenschaften und Mehrwert
› Alkalibeständiges Armiergewebe
› Kunststoff weiß mit codierter Oberfläche
› Maschenweite 4 x 4 mm
› Optisch saubere Putzabschlüsse
› Kunststoff weiß
› Länge: 2500 mm
› Gewebeschenkel 125 x 125 mm


Ausführung mit breitem Kunststoffschenkel sowie verjüngter Abzugskante, speziell für Kratzputzsystem und dünnschichtige Putzsysteme.
Details finden Sie im techn. Blatt P385u.de
Eigenschaften und Mehrwert
› Alkalibeständiges Armiergewebe
› Kunststoff weiß mit codierter Oberfläche
› Maschenweite 4 x 4 mm
› Optisch saubere Putzabschlüsse
› Gewebebreite Laibung: 100 mm
› Gewebebreite Fläche: 150 mm


› Länge: 2500 mm
Selbstklebendes, bewegliches Fensteranschlussprofil für einen schlagregendichten Anschluss an Fenster und Türen mit optisch ansprechender Schattenfuge. Das Profil ermöglicht exaktes Anarbeiten mit Armiermörtel und Oberputz durch spezielle Abzugskanten.
Details finden Sie im techn. Blatt P385b.de
Eigenschaften und Mehrwert
› Schlagregendicht
› Bewegungsaufnahme Klasse A
› Exaktes Anarbeiten durch Abzugskante möglich
› Empfohlen für Dämmstoffdicken ≤ 300 mm und Fenster- und Türgrößen ≤ 10 m²
› Codierter Putzabschluss für Oberputz ermöglicht sehr gute Haftung
› Einfache und handliche Montage
› Entfernbare Schutzlasche mit Klebeband für Abklebearbeiten
› Alkalibeständiges Armiergewebe mit Kunststoffschenkel verbunden
› Für Putzdicken von 6 bis 12 mm
Mit optisch ansprechender Schattenfuge, schlagregendicht
Selbstklebendes, zweiteiliges 3D-Laibungsanschlussprofil mit Gewebe, einem starren Abziehstreifen und weißem PE-Schaumklebeband für einen schlagregendichten Anschluss an Fenster und Türen. Durch die mechanische Entkoppelung werden Bewegungen zwischen Bauelement und Wärmedämm-Verbundsystem nahezu kraftlos aufgenommen. Im verputzten Zustand ist das Fensteranschlussprofil Duo G10 nicht sichtbar (Schattenfuge).
Details finden Sie im techn. Blatt P384c.de
Eigenschaften und Mehrwert
› Schlagregendicht
› Optisch ansprechender Putzanschluss (Schattenfuge)
› Für Putzdicken von 6 bis 15 mm
› Exaktes Anarbeiten durch Abzugskante möglich
› Dreidimensionale Bewegungsaufnahme
› Alkalibeständiges Armiergewebe mit Kunststoffschenkel verbunden
› Bewegungsaufnahme Klasse A
› Empfohlen für Dämmstoffdicken ≤ 300 mm und Fenster- und Türgrößen ≤ 10 m²
Selbstklebendes, zweiteiliges 3D-Laibungsanschlussprofil mit Gewebe, einem starren Abziehstreifen und weißem PE-Schaumklebeband für einen schlagregendichten Anschluss an Fenster und Türen. Durch die mechanische Entkoppelung werden Bewegungen zwischen Bauelement und Wärmedämm-Verbundsystem nahezu kraftlos aufgenommen. Im verputzten Zustand ist das Fensteranschlussprofil Duo G6 nicht sichtbar (Schattenfuge).
Details finden Sie im techn. Blatt P385m.de
Eigenschaften und Mehrwert
› Schlagregendicht
› Empfohlen für Dämmstoffdicken ≤ 300 mm und Fenster- und Türgrößen ≤ 10 m²


› Für Putzdicken von 6 bis 12 mm
› Optisch ansprechender Putzanschluss (Schattenfuge)
› Exaktes Anarbeiten durch Abzugskante möglich
› Dreidimensionale Bewegungsaufnahme
› Mit leicht abziehbarer Schutzlasche
› Alkalibeständiges Armiergewebe mit Kunststoffschenkel verbunden
› Bewegungsaufnahme Klasse B
› Darf bei mauerwerksbündigen und vor dem Mauerwerk sitzenden Fenstern nur bis 240 mm Dämmstoffdicke verwendet werden
FENSTERANSCHLUSSPROFIL DUO G6
Zweiteiliges Laibungsanschlussprofil, schlagregendicht
Selbstklebendes, zweidimensional bewegliches Fensteranschlussprofil für Anschlüsse an Fenster und Türen sowie Rolladenkästen.
Details finden Sie im techn. Blatt P385f.de
Eigenschaften und Mehrwert
› Empfohlen für Dämmstoffdicken ≤ 300 mm und Fenster- und Türgrößen ≤ 10 m²
› Schlagregendicht
› Mit leicht abziehbarer Schutzlasche
› Alkalibeständiges Armiergewebe mit Kunststoffschenkel verbunden
› Für Putzdicken von 6 bis 10 mm
› Anbringen vor der Dämmplattenverklebung
› Bewegungsaufnahme Klasse A
Selbstklebendes Fensteranschlussprofil aus Kunststoff, Farbton weiß mit TPE Schlaufe und PE-Dichtband, alkalibeständiges Gewebe, mit abknickbarer Schutzlasche für seitliche Anschlüsse an Vorbaurollladensysteme. Zum Herstellen des Putzanschlusses für den seitlichen Anschluss an Vorbaurollläden. Der Putzanschluss erfolgt seitlich an den Führungsschienen des Rollladens, damit die Revisionsblende nach dem Putzaufbau noch zugänglich ist. Die Bewegungsaufnahme erfolgt über die dehnbare TPE-Schlaufe im Profil, welche beim Abreißen der Schutzlasche aktiviert wird.
Details finden Sie im techn. Blatt P385d.de
Eigenschaften und Mehrwert
› Schlagregendicht
› Empfohlen für Dämmstoffdicken ≤ 300 mm und Fenster- und Türgrößen ≤ 10 m²


› Mit leicht abziehbarer Schutzlasche
› Alkalibeständiges Armiergewebe mit Kunststoffschenkel verbunden
› Für Putzdicken von 6 bis 10 mm
› Anbringen vor der Dämmplattenverklebung
› Bewegungsaufnahme Klasse A
Für Rollladenführungsschienen, schlagregendicht
Selbstklebendes, zweiteiliges Fensteranschlußprofil mit integriertem Fugendichtband. Speziell für schlagregendichte Anschlüsse bei größeren Dämmstoffdicken, Fenstergrößen und klebeungeeigneten Untergründen. Das Profil ist mit einem komprimierten PUR-Band ausgestattet, welches durch Entfernen des Schutzmechanismus ausgelöst wird, direkt am Bauteil expandiert und schlagregendicht abdichtet.
Details finden Sie im techn. Blatt P385n.de
Eigenschaften und Mehrwert
› Empfohlen für Dämmstoffdicken ≤ 400 mm und Fenster- und Türgrößen ≤ 15 m²
› UV-beständige Schutzlippe
› Bei Fenster- und Türanlagen, bei denen mit größeren Ausgleichsbewegungen gerechnet werden muss
› Mit leicht abziehbarer Schutzlasche
› Alkalibeständiges Armiergewebe mit Kunststoffschenkel verbunden
› Für Gesamtputzdicken von 6 bis 12 mm
› Anbringen vor der Dämmplattenverklebung
› Bewegungsaufnahme Klasse A
Selbstklebendes, zweiteiliges Fensteranschlussprofil mit integriertem Fugendichtband. Speziell für schlagregendichte Anschlüsse bei größeren Dämmstoffdicken, Fenstergrößen und klebeungeeigneten Untergründen. Das Profil ist mit einem komprimierten PUR-Band ausgestattet, welches durch Entfernen des Schutzmechanismus ausgelöst wird, direkt am Bauteil expandiert und schlagregendicht abdichtet. Geeignet für Putzdicken von 15 bis 18 mm (z. B. Kratzputz Mak3).
Details finden Sie im techn. Blatt P385o.de
Eigenschaften und Mehrwert
› Für Kratzputz
› Für Putzdicken von 15 bis 18 mm
› Schlagregendicht
› Empfohlen für Dämmstoffdicken ≤ 200 mm und Fenster- und Türgrößen ≤ 15 m²


› UV-beständige Schutzlippe
› Bei Fenster- und Türanlagen, bei denen mit größeren Ausgleichsbewegungen gerechnet werden muss
› Mit leicht abziehbarer Schutzlasche
› Alkalibeständiges Armiergewebe mit Kunststoffschenkel verbunden
› Anbringen vor der Dämmplattenverklebung
› Bewegungsaufnahme Klasse A
FENSTERANSCHLUSSPROFIL UNIVERSAL-K PRO Für Kratzputz mit integriertem PUR-Fugendichtband, schlagregendicht
Als Anputzleiste für keramische Bekleidungen an Fenstern und Türen geeignet. Anputzleiste mit selbstklebendem PE-Dichtband, weicher Schutzlippe, integriertem PUR-Fugendichtband und Schutzlasche für Abdeckfolie zur Herstellung sauberer und gerader Putzanschlüsse an Fenster und Türen. Das Auslösen des PUR-Dichtbandes erfolgt durch Abtrennen der Schutzlasche.
Eigenschaften und Mehrwert
› Dauerhaft UV-beständige Bewegungsfuge
› PUR-Dichtband 5/25 x 10 mm

› Kunststoff weiß
› Ohne Armiergewebe
› Für saubere Anschlüsse an keramische Bekleidungen
› Bewegungsaufnahme Klasse A
› Empfohlen für Dämmstoffdicken ≤ 200 mm und Fenster- und Türgrößen ≤ 10 m²

Kunststoffprofil zur Ausbildung eines horizontalen, wasserabführenden Übergangs mit sauberem Putzabschluss von Putzflächen zu Keramikbelägen. Gelochtes Kunststoffprofil mit Abzugskante, Schutzlasche, geneigtem Schenkel mit Tropfkante und verschweißtem Armiergewebe.
Details finden Sie im techn. Blatt P385x.de
Eigenschaften und Mehrwert
› Für saubere, horizontale Übergänge zwischen Putz und Keramikbelägen
› Dauerhaft UV-beständiges Übergangsprofil
› Gewebeschenkel 125 mm
› Maschenweite 4 x 4 mm
› Kunststoff weiß
› Geneigte Schenkelausbildung
Das Brüstungsprofil bildet bei Ausführung einer zweiten Dichtebene einen sauberen Putzabschluss unterhalb der Fensterbank. Das Profil ist mit zwei Kunststoffschenkeln ausgestattet. Die weiche, transparente Tropfkante kann das Wasser gezielt abführen. Durch die vorgegebene Profilkontur wird die erforderliche Neigung von mind. 5 Grad im Fensterbankbereich eingehalten.

Details finden Sie im techn. Blatt P385r.de
Eigenschaften und Mehrwert
› Sauberer Putzabschluss unterhalb der Fensterbank
› Mit weicher, transparenter Tropfkante
› Einseitiger Gewebeüberstand in Längsrichtung
› Gewebeschenkel 125 mm
› Maschenweite 4 x 4 mm

Dehnfugenprofil aus zwei gelochten Kunststoffprofilen mit zwei Abzugskanten und Verbindungslasche aus TPE-Folie. Mit beidseitig fest angebrachtem, 100 mm breitem Armiergewebe. Einsetzbar für Innenecken zur dauerhaften und witterungsbeständigen Abdichtung von vertikalen Bewegungsfugen.
Details finden Sie im techn. Blatt P385l.de
Eigenschaften und Mehrwert
› Kunststoff weiß
› Dauerhafte und witterungsbeständige Abdichtung
› Mit fest angeklebtem Armiergewebe
› Mit überstehender Lasche für den Stoßbereich
› Für Putzdicken von 6 bis 12 mm (inkl. Oberputz)
Einsetzbar für die Fläche zur dauerhaften und witterungsbeständigen Abdichtung von vertikalen Bewegungsfugen.
Dehnfugenprofil aus zwei gelochten Kunststoffprofilen mit zwei Abzugskanten und Verbindungslasche aus TPE-Folie. Mit beidseitig fest angebrachtem, 100 mm breitem Armiergewebe.
Details finden Sie im techn. Blatt P385q.de
Eigenschaften und Mehrwert
› Kunststoff weiß
› Dauerhafte und witterungsbeständige Abdichtung
› Mit fest angeklebtem Armiergewebe
› Mit überstehender Lasche für den Stoßbereich
› Für Putzdicken von 6 bis 12 mm (inkl. Oberputz)
Dehnfugenprofil aus Kunststoff mit Fugendeckband zur Ausbildung von fluchtgerechten Dehnfugen mit sauberem Putzabschluss für Kratzputz Mak3 und dickschichtige Putzsysteme.
Details finden Sie im techn. Blatt P385i.de
Eigenschaften und Mehrwert
› Kunststoff weiß
› Gewebeschenkel 125 x 125 mm


› Dauerhafte und witterungsbeständige Abdichtung
› Mit fest angeklebtem Armiergewebe
Gewebeleiste mit TPE-Bewegungslasche für kleine Bauteilbewegungen.
Eigenschaften und Mehrwert
› Kunststoff
› Dauerhafte und witterungsbeständige Abdichtung
› Mit fest angeklebtem Armiergewebe
› Für Putzdicken von 6 bis 12 mm (inkl. Oberputz)


Als Abschluss- und Anschlussprofil an Bauteile, die nicht überputzt werden sollen.
Details finden Sie im techn. Blatt P385j.de
Als Abschluss an Attika-Abdeckungen oder als Fensterbankanschluss bei Ausführung der 2. Dichtebene unter Fensterbänken bei WARM-WAND Systemen. Vermeidung von Wasserhinterwanderung bei entstehendem Windstaudruck.

Details finden Sie im techn. Blatt P385h.de
Eigenschaften und Mehrwert
› Kunststoff
› Gewebeschenkel 125 mm
› Für Putzdicken von 6 bis 12 mm
Als Anschlussprofil für Blechverwahrungen und Untersichten von Rollladenkästen mit Abtropfkante.
Eigenschaften und Mehrwert
› Kunststoff
› Gewebeschenkel 125 mm
› Aufkantung 6 mm

Montagezylinder aus EPS-Hartschaum mit wellenförmiger Mantelfläche ohne Zulassung. Anwendbar als wärmebrückenfreie konstruktive Befestigung von Rohrschellen, Lampen, Briefkasten usw. in EPS mit bis zu 17 kg Vertikallasten.
Darf nicht für schwere, statisch relevante Lasten wie z. B. Markisen, Vordächer oder ähnliche Elemente, bei denen Personen im Versagensfall zu Schaden kommen können, verwendet werden.
Eigenschaften und Mehrwert
› Raumgewicht 170 kg/m³
› Durchmesser 70 mm bzw. 125 mm
› Einbautiefe 70 mm


› 17 kg Gebrauchslast
› Wärmeleitfähigkeit λ = 0,045 W/(mK)
Einkomponentiger, flexibler und spannungsausgleichender Montagekleber zum Schließen von Plattenstößen bei Perfex Laibungsplatten und Perfex Keilplatte. Zur Angleichung der Fugen an die Endbeschichtung kann der Montagekleber nach 6 Stunden Standzeit mit Fugenspachtel Struktur beschichtet werden.
Details finden Sie im techn. Blatt P381.de
Eigenschaften und Mehrwert
› Einkomponentiger Hybrid-Kleb- bzw. Dichtstoff
› Flexibel und spannungsausgleichend
› Für innen und außen
› Farbe: weiß
› Lieferzeit ca. 5 – 8 Arbeitstage
Der Montagequader ohne Zulassung ist besonders als Montageunterlage zur wärmebrückenfreien, konstruktiven Befestigung von leichten Gegenständen wie z. B. Lampen oder Briefkästen mit bis zu 20 kg Vertikallasten oder als Druckunterlage bei weichen Dämmstoffen geeignet. Einsetzbar ist der Montagequader in allen Knauf WARM-WAND Systemen. Er wird mit einem EPS Heißschneidedraht auf die gewünschte Dämmstoffdicke abgeschnitten und mit Spezial-Montagekleber kraftschlüssig mit dem tragfähigen Untergrund verklebt. Fremdmontagen erfolgen ohne Vorbohren durch die fertige Putzbeschichtung mit rostfreien Schrauben und zylindrischem Grobgewinde. Darf nicht für schwere, statisch relevante Lasten wie z. B. Markisen, Vordächer oder ähnliche Elemente, bei denen Personen im Versagensfall zu Schaden kommen können, verwendet werden.
Eigenschaften und Mehrwert
› Raumgewicht ca. 150 kg/m³
› Format 120 x 160 x 1000 mm
› Optimale Lagerhaltung
› Individuell einsetzbar
› Mit umlaufendem 20 mm-Raster für genauen Sägeschnitt
› Schneidbar mit Heißschneidedraht

Der Montagequader ohne Zulassung ist besonders für wärmebrückenfreie, konstruktive Befestigung leichter bis mittelschwerer Gegenstände in allen Knauf WARM-WAND Systemen geeignet und darf nur zur Aufnahme von Druckkräften verwendet werden. Die Verankerungen erfolgen grundsätzlich immer im Mauerwerk. Verschraubungen im Montagequader sind nicht zulässig.
Die Montagequader werden mit dem Kleben der Dämmplatten kraftschlüssig mit dem tragfähigen Untergrund verklebt. Fremdmontagen werden durch Vorbohren durch die Putzbeschichtung in den Untergrund mit entsprechenden Schraubdübeln im Mauerwerk verankert. Darf nicht für schwere, statisch relevante Lasten wie z. B. Markisen, Vordächer oder ähnliche Elemente, bei denen Personen im Versagensfall zu Schaden kommen können, verwendet

Der Montagewinkel aus PU-Hartschaum ist Bestandteil des bauaufsichtlich zugelassenen Befestigungssystems Iso-Corner und dient zur Aufnahme statisch relevanter Lasten von Anbauteilen in WARM-WAND Systemen. Zusammen mit einem auf den Untergrund abgestimmten Dübel-Kit, sowie dem Iso-Corner Schrauben-Set für die Befestigung des Anbauteils im Tragelement ergibt sich somit ein perfekt aufeinander abgestimmtes Befestigungsystem am Montagewinkel.
Montagewinkel Iso-Corner ist geeignet für die Montage von mittelschweren bis schweren Anbauteilen, wie Fenstergitter, Vordächer und Markisen.
Details finden Sie im techn. Blatt P388C-B.de
Eigenschaften und Mehrwert
› Maßgenaues Ablängen des Montagewinkels auf der Baustelle
› Bauaufsichtlich zugelassenes Montagesystem
› Reduzierte Wärmebrücke durch thermische Entkopplung
› Material: PU-Hartschaum
› Zwei Montageflächen in einem Element (Stirn- und Längsseite)
› Variabele Position des Schraubensets am Montagewinkel
› Einsetzbar in allen WARM-WAND Systemen


› Befestigung des Anbauteils durch Direktverschraubung
Das Kit beinhaltet drei bauaufsichtlich zugelassene Fassadendübel zur Verankerung des Iso-Corner Montagewinkels in Beton. Schraubdübel Kit Iso-Corner besteht aus einer hochwertigen Dübelhülse aus Polyamid mit passender galvanisch verzinkter Stahlschraube mit Sechskant- und Torx-Antrieb sowie angepresster Scheibe. Die radiale Spreizung bietet dabei einen besonders sicheren Halt.
Details finden Sie im techn. Blatt P388C-B.de
Eigenschaften und Mehrwert
› Europäisch technisch zugelassen (ETA-10/0305)
› Sicherer Halt durch radiale Spreizung
› Cr(VI)-freie Oberfläche der Dübelschraube
› Doppelte Verdrehsicherheit
Das Kit beinhaltet drei bauaufsichtlich zugelassene Injektionsdübel bestehend aus einer galvanisch verzinkten Gewindestange M10 mit passender Unterlegscheibe und Gewindemutter zur Verankerung im Mauerwerk. Zur Verankerung in Lochsteinmauerwerk wird zudem eine passende Siebhülse USF verwendet. Die Gewindestange wird mit einem bauaufsichtlich zugelassenen, styrolfreien Injektionsmörtel verklebt.
Details finden Sie im techn. Blatt P388B-C.de
Eigenschaften und Mehrwert
› Europäisch technisch zugelassen (ETA-16/0089)
› Ankerstange: Festigkeitsklasse 5,8 oder 6,8 nach EN ISO 898-1
› Mutter: Festigkeitsklasse 5 oder 6 nach EN 20898-2
› Scheibe: nach EN ISO 7089


Styrolfreier, bauaufsichtlich zugelassener Injektionsmörtel zur dauerhaft sicheren Verklebung des Injektionsdübel Kit Iso-Corner in Voll- und Lochsteinmauerwerk. Ausreichend für ca. 11 Verankerungen pro Kartusche. Die Lieferung erfolgt inklusive Mischdüse.
Details finden Sie im techn. Blatt P388B-C.de
Eigenschaften und Mehrwert
› Europäisch technisch zugelassen (ETA-16/0089)
› Vinylharz, styrolfrei
› Verarbeitung mit handelsüblicher Auspresspistole möglich
› Lieferung inklusive Mischdüse
› Verarbeitungszeit bei Raumtemeratur: ca. 6 min
› Aushärtezeit bei Raumtemperatur: ca. 45 min
Das Schrauben-Set ist Bestandteil des bauaufsichtlich zugelassenen Befestigungssystems Iso-Corner. Die Befestigung der Anbauteile erfolgt durch einfache Direktverschraubung im Montagewinkel Iso-Corner. Zuvor ist ein Kernloch von 8 mm mit einer Bohrlochtiefe mit ≥ 40 mm zu erstellen. Die Spezialschraube dreht bei der Montage ihr Gewinde direkt in den Montagewinkel ein.

Details finden Sie im techn. Blatt P388C-B.de
Eigenschaften und Mehrwert
› Hoch belastbare Direktverschraubung in Kunststoff
› Direktverschraubung spart Zeit und Arbeitsgänge
› Einfache Montage
› Hohe Dauerschwingfestigkeit
› Sicherheit durch hohe Zug-, Torsions- und Vibrationsfestigkeit

› Großer Einschraub- und Drehzahlbereich möglich
Vorkomprimiertes, selbstklebendes, seitenflächenimprägniertes Fugendichtband aus Polyurethan-Weichschaumstoff zur Herstellung von schlagregendichten Anschlüssen bei Knauf WARM-WAND Systemen.
Details finden Sie im techn. Blatt P386c.de
Eigenschaften und Mehrwert
› Seitenflächen imprägniert
› Temperaturbeständig -30°C bis +90°C
› Schlagregendichtigkeit von Fugen ≥ 1050 Pa
› Zurückkomprimiertes Fugendichtband
› Temperaturunabhängig verlegbar
› Dampfdiffusionsoffen
› Witterungsbeständig
› Selbstklebend
Der Schutzpuffer für Putzanschlüsse aus Moosgummi. Dient als Antidröhnband und schützt Putz vor Druckspannungen an allen Kontaktstellen zu anderen Bauteilen (insbesondere bei Aluminium) unter thermischem Einfluss.
Beim Anbringen unter Fensterbänken oder am Fensterrahmen wird deren Bewegung nicht starr übertragen, was bei schmalen Laibungen besonders wichtig ist.
Details finden Sie im techn. Blatt P386a.de
Eigenschaften und Mehrwert
› Farbe: weiß
› Ozonbeständig
› Witterungsbeständig
› Schwitzwasserbeständig
› UV-beständig
› Selbstklebend
› 56 mm breit, teilbar in 38 mm und 18 mm

Gebrauchsfertiger, einkomponentiger, selbstexpandierender und hochergiebiger Polyurethanschaum der Baustoffklasse B1.
Details finden Sie im techn. Blatt P386p.de
Eigenschaften und Mehrwert
› Hohe Ergiebigkeit
› Schnelle Verarbeitung
› Zum Ausschäumen von Plattenfugen sehr gut geeignet
› Baustoffklasse: B1- schwer entflammbar
› Kostenlose Entsorgung der Verpackung mit dem PDR System
Jalousiekasten aus 040er Mineralwolle zur wärmebrückenfreien Montage von Sicht- und Sonnenschutzrollos bei WARM-WAND Systemen. Geringes Gesamtgewicht und innenliegende, gewerkeübergreifende Alu-Halteschiene für zusätzliche Sicherheit im Brandfall sowie werkseitig eingebautes Putzabschlussprofil sorgen für einen rationellen und unkomplizierten Baufortschritt. Mit dem Perfex Jalousiekasten ist die Jalousie elegant in die Dämmfassade integriert und sorgt für eine besonders ansprechende Optik.
Details finden Sie im techn. Blatt P381.de
Eigenschaften und Mehrwert
› Flexible Elementlängen, Außenblendhöhen, Innenschachtbreiten, Wandanschlussdämmungen sowie Außen- und Innenecken.
› Hochdämmende MW-Dämmplatte zur
› MW-Dämmstoff mit Wärmeleitfähigkeit λ = 0,040 W/(mK)
› Integriertes Putzabschlussprofil mit Tropfkante
› Mit aufgedrucktem Dübelbereich zur einfachen Montage
› Fertige Oberflächenbeschichtung in der Innenseite, Unteransicht ist streichfertig
› Schachtinnen- und Stirnseite der Vorder- und Hinterblende auch in anthrazit ausführbar
› Ab 160 mm Dämmstoffdicke einsetzbar. Sondermaße nach Absprache möglich
› Lieferzeit ca. 16 Arbeitstage
Jalousieschürze zur wärmebrückenfreien Montage von Sicht- und Sonnenschutzrollos bei WARMWAND Systemen. Die Jalousieschürze besteht aus 040er Mineralwolle und ist für die Montage über dem Fenster zur Wandseite offen. Geringes Gesamtgewicht und innenliegende, gewerkeübergreifende Alu-Halteschiene für erhöhte Sicherheit im Brandfall sowie integriertes Putzabschlussprofil sorgen für einen rationellen und unkomplizierten Baufortschritt. Mit der Perfex Jalousieschürze ist die Jalousie elegant in die Dämmfassade integriert und sorgt für eine besonders ansprechende Optik.
Details finden Sie im techn. Blatt P381.de
Eigenschaften und Mehrwert
› Flexible Elementlängen, Außenblendhöhen, Innenschachtbreiten, Wandanschlussdämmungen sowie Außen- und Innenecken.
› MW-Dämmstoff mit Wärmeleitfähigkeit λ = 0,040 W/(mK)


› Integriertes Putzabschlussprofil mit Tropfkante
› Mit aufgedrucktem Dübelbereich zur einfachen Montage
› Fertige Oberflächenbeschichtung in der Innenseite, Unteransicht ist streichfertig
› Schachtinnen- und Stirnseite der Vorder- und Hinterblende auch in anthrazit ausführbar
› Ab 140 mm Dämmstoffdicke einsetzbar. Sondermaße nach Absprache möglich
› Lieferzeit ca. 16 Arbeitstage
Mit dem Perfex Jalousiekasten ist die Jalousie elegant in die Dämmfassade integriert und sorgt für eine besonders ansprechende Optik.
Jalousiekasten aus 032er EPS zur wärmebrückenfreien Montage von Sicht- und Sonnenschutzrollos bei WARM-WAND Systemen. Geringes Gesamtgewicht und innenliegende, gewerkeübergreifende Alu-Halteschiene für zusätzliche Sicherheit im Brandfall sowie werkseitig eingebautes Putzabschlussprofil sorgen für einen rationellen und unkomplizierten Baufortschritt.
Details finden Sie im techn. Blatt P381.de
Eigenschaften und Mehrwert
› Flexible Elementlängen, Außenblendhöhen, Innenschachtbreiten, Wandanschlussdämmungen sowie Außen- und Innenecken.
› Hochdämmende EPS-Dämmplatte zur Wandseite
› EPS-Dämmstoff mit Wärmeleitfähigkeit λ = 0,032 W/(mK)
› Integriertes Putzabschlussprofil mit Tropfkante
› Mit aufgedrucktem Dübelbereich zur einfachen Montage
› Fertige Oberflächenbeschichtung in der Innenseite, Unteransicht ist streichfertig
› Schachtinnen- und Stirnseite der Vorder- und Hinterblende auch in anthrazit ausführbar
› Ab 160 mm Dämmstoffdicke einsetzbar. Sondermaße nach Absprache möglich
› Lieferzeit ca. 16 Arbeitstage
Jalousieschürze zur wärmebrückenfreien Montage von Sicht- und Sonnenschutzrollos bei WARMWAND Systemen. Die Jalousieschürze besteht aus 032er EPS und ist für die Montage über dem Fenster zur Wandseite offen. Geringes Gesamtgewicht und innenliegende, gewerkeübergreifende Alu-Halteschiene für erhöhte Sicherheit im Brandfall sowie integriertes Putzabschlussprofil sorgen für einen rationellen und unkomplizierten Baufortschritt. Mit der Perfex Jalousieschürze ist die Jalousie elegant in die Dämmfassade integriert und sorgt für eine besonders ansprechende Optik.
Details finden Sie im techn. Blatt P381.de
Eigenschaften und Mehrwert
› Flexible Elementlängen, Außenblendhöhen, Innenschachtbreiten, Wandanschlussdämmungen sowie Außen- und Innenecken.
› EPS-Dämmstoff mit Wärmeleitfähigkeit λ = 0,032 W/(mK)


› Integriertes Putzabschlussprofil mit Tropfkante
› Mit aufgedrucktem Dübelbereich zur einfachen Montage
› Fertige Oberflächenbeschichtung in der Innenseite, Unteransicht ist streichfertig
› Schachtinnen- und Stirnseite der Vorder- und Hinterblende auch in anthrazit ausführbar
› Ab 140 mm Dämmstoffdicke einsetzbar. Sondermaße nach Absprache möglich
› Lieferzeit ca. 16 Arbeitstage
Dient zur dauerhaften Verbindung aneinanderstoßender Jalousiekästen und -schürzen bei Gesamtlängen > 3000 mm.
Details finden Sie im techn. Blatt P381.de
Eigenschaften und Mehrwert
› Vorgefertige Innen- und Außenecke
› Verbinder aus Edelstahl


› Bei Gesamtlängen > 3000 mm
Jalousiekasten aus 032er EPS zur wärmebrückenfreien Montage von Sicht- und Sonnenschutzrollos bei WARM-WAND Systemen. Bei Ausführung des WDVS dünner 180 mm kommt die systemgleiche Jalousieschürze zum Einsatz.
Eigenschaften und Mehrwert
› EPS-Dämmstoff mit Wärmeleitfähigkeit λ = 0,032 W/(mK)
› Zusätzliche mechanische Befestigung mit Schraubdübel STR U 2G
› Ohne Jalousie
› Minimierung von Wärmebrücken
› Integrierte Abschlussleiste
› Einfache Montage
› Zusätzliche mechanische Befestigung durch Befestigungswinkel
› Kabeldurchführung
› Lieferstärke 160 - 400 mm
Zur wärmebrückenfreien Montage von Sicht- und Sonnenschutzrollos (auf Anfrage)
Hochdämmende MW-Laibungsplatte zur Herstellung besonders gerader, schlagregen- und winddichter Fensteranschlüsse bei WARM-WAND Systemen. Mit integrierter Putzabzugskante und fest angebrachtem Armiergewebe für exakte, gerade Laibungen in Rekordzeit. Lieferbar in den Plattendicken 12,5 mm, 20 mm und 30 mm.
Details finden Sie im techn. Blatt P381.de
Eigenschaften und Mehrwert
› Anwendungstyp WAP nach DIN 4108-10
› Brandverhalten A2-s1, d0
› Bemessungswert der Wärmeleitfähigkeit λ = 0,040 W/(mK)
› Keine Wärmebrücken
› Schlagregen- und winddichter Fensteranschluss
› Mit integriertem Gewebeprofil
› Fertig beschichtete Oberfläche kann direkt mit Oberputz versehen werden
› Optional mit Tropfkante bestellbar (für mögliche Sturzausbildung)

› Individuelle Gewerkelochfräsung möglich
› Sichtseite weiß oder anthrazit ausführbar
Hochdämmende EPS-Laibungsplatte zur Herstellung besonders gerader, schlagregen- und winddichter Fensteranschlüsse bei WARM-WAND Systemen. Mit integrierter Putzabzugskante und fest angebrachtem Armiergewebe für exakte, gerade Laibungen in Rekordzeit.
Lieferbar in den Plattendicken 12,5 mm, 20 mm und 30 mm.
Details finden Sie im techn. Blatt P381.de
Eigenschaften und Mehrwert
› Anwendungstyp WAP nach DIN 4108-10
› Bemessungswert der Wärmeleitfähigkeit λ = 0,032 W/(mK)

› Keine Wärmebrücken
› Schlagregen- und winddichter Fensteranschluss
› Mit integriertem Gewebeprofil
› Fertig beschichtete Oberfläche kann direkt mit Fassadenfarbe oder Oberputz versehen werden
› Schnelle Baustellenabwicklung
› Individuelle Gewerkelochfräsung möglich
› Sichtseite weiß oder anthrazit ausführbar
› Optional mit Tropfkante bestellbar (für mögliche Sturzausbildung)
Selbstklebendes Fensteranschlussprofil mit Schutzlippe zur Aufnahme der Perfex Laibungsplatten für einen sauberen und schlagregendichten Fensteranschluss. Geeignet für Fenstergrößen ≤ 2 m² und Dämmstoffdicken ≤ 200 mm. Lieferbar für Plattendicken von 12,5 mm, 20 mm und 30 mm.
Details finden Sie im techn. Blatt P381.de
Eigenschaften und Mehrwert
› Empfohlen für Dämmstoffdicken ≤ 200 mm und Fenstergrößen ≤ 2 m²


› Innenliegendes PE-Band für eine Verklebung mit der Laibungsplatte (optional auch ohne bestellbar)
› Zur Aufnahme von Laibungsplatten ab 12,5 mm
› Mit zwei leicht abziehbaren Schutzlaschen
› Schlagregendicht
› Lieferzeit ca. 5 - 8 Arbeitstage
› Mit Schutzlippe (optional auch ohne bestellbar)
› Profilauftragsstärke 7 mm
Selbstklebendes Fensteranschlussprofil mit integriertem Fugendichtband und sichtbarer Schattenfuge zur Aufnahme der Perfex Laibungsplatten für einen sauberen und schlagregendichten Fensteranschluss. Durch das integrierte Fugendichtband kann das Profil Bewegungen in alle Richtungen aufnehmen. Geeignet für alle Anwendungen und Laibungsplattenstärken. Lieferbar für alle Plattendicken ab 12,5 mm.
Details finden Sie im techn. Blatt P381.de
Eigenschaften und Mehrwert
› Innenliegendes PE-Band für eine Verklebung mit der Laibungsplatte (optional auch ohne bestellbar)
› Zur Aufnahme von Laibungsplatten ab 12,5 mm
› Mit zwei leicht abziehbaren Schutzlaschen und einem Klemmprofil zur Aktivierung des Fugendichtbandes
› Schlagregendicht
› Bewegungsaufnahme horizontal und vertikal
› Mit Edelputzsteg
› Profilauftragsstärke 10 mm
› Lieferzeit ca. 5 – 8 Arbeitstage
Mit fest angebrachtem U-Profil aus Kunststoff für die Aufnahme von 12,5 mm dicken Laibungsplatten und dauerhaften Rollladenanschlag.
Spezielles Sturzanschlussprofil für eine seitliche Verklebung des Profils am Untergrund im Sturzbereich. Starke Klebkraft durch Hotmelt-Klebeband für eine einfache Montage auf verschiedene Untergründe wie Putz, Stein, Beton usw.
Details finden Sie im techn. Blatt P381.de
Eigenschaften und Mehrwert
› Innenliegendes PE-Band für eine Verklebung mit der Laibungsplatte (optional auch ohne bestellbar)
› Zur Aufnahme von Laibungsplatten von 12,5 mm

› U-Profil mit Hotmelt-Klebeband für seitliche Verklebung des Profils
› Mit Rollladenanschlagskante
› Lieferzeit ca. 5 – 8 Arbeitstage

Hochdämmende MW Dämmplatte mit fertiger Oberflächenbeschichtung zur Herstellung einer zweiten Dichtebene unter der Fensterbank bei WARMWAND Systemen. Die Keilplatten stehen mit 5° Gefälle für Alu-Fensterbänke oder 2,5° Gefälle für Steinfensterbänke zur Verfügung. Die Stärke der Plattenhinterkante variiert je nach Ausladung. Die Plattenstärken können Sie in der Keilplattendefinition im technischen Blatt ablesen.
Details finden Sie im techn. Blatt P381.de
Eigenschaften und Mehrwert
› Bemessungswert der Wärmeleitfähigkeit im Erdreich λ ≤ 0,040 W/(mK)
› Keine Wärmebrücken
› Schlagregen- und winddichter Fensteranschluss
› Exakte, gerade Brüstungsebene mit 5°oder 2,5°Neigungswinkel-Gefälle nach außen in Rekordzeit herstellbar
› Schnelle Baustellenabwicklung
› Mit integriertem Gewebeprofil und transparenter Tropfkante
› Wasserdichte Oberfläche
› Maßgenau in fertiger Einbaulänge bis max. 3000 mm/ Stück lieferbar
› Lieferzeit ca. 5 – 8 Arbeitstage
Hochdämmende XPS Dämmplatte mit fertiger Oberflächenbeschichtung zur Herstellung einer zweiten Dichtebene unter der Fensterbank bei WARMWAND Systemen. Die Keilplatten stehen mit 5° Gefälle für Alu-Fensterbänke oder 2,5° Gefälle für Steinfensterbänke zur Verfügung. Die Stärke der Plattenhinterkante variiert je nach Ausladung. Die Plattenstärken können Sie in der Keilplattendefinition im technischen Blatt ablesen.
Details finden Sie im techn. Blatt P381.de
Eigenschaften und Mehrwert
› Wärmeleitfähigkeit λ = 0,033 W/(mK)

› Keine Wärmebrücken
› Schlagregen- und winddichter Fensteranschluss
› Exakte, gerade Brüstungsebene mit 5°oder 2,5°Neigungswinkel-Gefälle nach außen in Rekordzeit herstellbar
› Schnelle Baustellenabwicklung
› Mit integriertem Gewebeprofil und transparenter Tropfkante
› Maßgenau in fertiger Einbaulänge bis max. 3000 mm/ Stück lieferbar
› Lieferzeit ca. 5 – 8 Arbeitstage
› Wasserdichte Oberfläche

Innovatives Fensterbanksystem für dauerhaft dichte Fensterbankanschlüsse aus stanggepresstem Aluminium mit Schutzfolie. Die Fensterbank wird dauerhaft mit Perfex Montagekleber auf der Perfex Keilplatte verklebt.
Wird objektbezogen maßgenau in fertiger Einbaulänge angefertigt. Für die Bestellung bitte die Hinweise zu den benötigten Angaben im technischen Blatt beachten. Bei Fensterbänken > 3000 mm sind Stoßverbinder einzusetzen.
Details finden Sie im techn. Blatt P381.de
Eigenschaften und Mehrwert
› Entkoppeltes Fensterbanksystem
› Dauerhaft schlagregendicht
› Montage nach Oberputzauftrag
› Maßgenau in fertiger Einbaulänge bis max. 3000 mm/Stück lieferbar
› Weitere Ausladung auf Anfrage
› Lieferzeit ca. 5 – 8 Arbeitstage
› Farbton weiß (ca. RAL 9016)
Innovatives Fensterbanksystem für dauerhaft dichte Fensterbankanschlüsse aus hochwertigem Aluminium. Die Fensterbank wird dauerhaft mit Perfex Montagekleber auf der Perfex Keilplatte verklebt. Thermisch bedingte Längenänderungen können von den Perfex Gleitabschlüssen sicher aufgenommen werden.

Details finden Sie im techn. Blatt P381.de
Eigenschaften und Mehrwert
› Entkoppeltes Fensterbanksystem
› Dauerhaft schlagregendicht
› Montage nach Flächenarmierung
› Weitere Ausladung auf Anfrage
› Lieferzeit ca. 5 – 8 Arbeitstage
› Farbton weiß (ca. RAL 9016)
Eckverbinder aus hochwertigem Aluminium zur einfachen und sicheren Montage der Perfex Fensterbank über 90° Außenecken. Bei Bestellung bitte immer Ausladung der Perfex Fensterbank angeben.
Details finden Sie im techn. Blatt P381.de
Eigenschaften und Mehrwert
› Entkoppeltes Fensterbanksystem
› Dauerhaft schlagregendicht
› Montage nach Oberputzauftrag
› Lieferzeit ca. 5 – 8 Arbeitstage
› Farbton weiß (ca. RAL 9016)


Stoßverbinder aus hochwertigem Aluminium zur einfachen und sicheren Montage der Perfex Fensterbank. Außenfensterbänke sind mindestens alle 3000 mm zu unterbrechen und durch Stoßverbinder zu verknüpfen. Bei Bestellung bitte immer Ausladung der Perfex Fensterbank angeben.
Details finden Sie im techn. Blatt P381.de
Eigenschaften und Mehrwert
› Entkoppeltes Fensterbanksystem
› Dauerhaft schlagregendicht
› Montage nach Oberputzauftrag
› Lieferzeit ca. 5 – 8 Arbeitstage
› Farbton weiß (ca. RAL 9016)

Wird objektbezogen maßgenau in fertiger Einbaulänge angefertigt. Für die Bestellung bitte die Hinweise zu den benötigten Angaben im technischen Blatt beachten. Bei Fensterbänken > 3000 mm sind Stoßverbinder einzusetzen.
Innovatives Fensterbanksystem für dauerhaft dichte Fensterbankanschlüsse aus stanggepressten Aluminium mit Schutzfolie. Die Fensterbank wird dauerhaft mit Perfex Montagekleber auf der Perfex Keilplatte verklebt.
Details finden Sie im techn. Blatt P381.de
Eigenschaften und Mehrwert
› Entkoppeltes Fensterbanksystem
› Dauerhaft schlagregendicht
› Montage nach Oberputzauftrag
› Maßgenau in fertiger Einbaulänge bis max. 3000 mm/Stück lieferbar
› Weitere Ausladung auf Anfrage
› Lieferzeit ca. 5 – 8 Arbeitstage
› Silber (ca. EV1)
Innovatives Fensterbanksystem für dauerhaft dichte Fensterbankanschlüsse aus hochwertigem Aluminium. Die Fensterbank wird dauerhaft mit Perfex Montagekleber auf der Perfex Keilplatte verklebt. Thermisch bedingte Längenänderungen können von den Perfex Gleitabschlüssen sicher aufgenommen werden.

Details finden Sie im techn. Blatt P381.de
Eigenschaften und Mehrwert
› Entkoppeltes Fensterbanksystem
› Dauerhaft schlagregendicht
› Montage nach Flächenarmierung
› Weitere Ausladung auf Anfrage
› Lieferzeit ca. 5 – 8 Arbeitstage
› Silber (ca. EV1)
Eckverbinder aus hochwertigem Aluminium zur einfachen und sicheren Montage der Perfex Fensterbank über 90° Außenecken. Bei Bestellung bitte immer Ausladung der Perfex Fensterbank angeben.

Details finden Sie im techn. Blatt P381.de
Eigenschaften und Mehrwert
› Entkoppeltes Fensterbanksystem
› Dauerhaft schlagregendicht
› Montage nach Oberputzauftrag
› Lieferzeit ca. 5 – 8 Arbeitstage
› Silber (ca. EV1)
Stoßverbinder aus hochwertigem Aluminium zur einfachen und sicheren Montage der Perfex Fensterbank. Außenfensterbänke sind mindestens alle 3000 mm zu unterbrechen und durch Stoßverbinder zu verknüpfen. Bei Bestellung bitte immer Ausladung der Perfex Fensterbank angeben.
Details finden Sie im techn. Blatt P381.de
Eigenschaften und Mehrwert
› Entkoppeltes Fensterbanksystem

› Dauerhaft schlagregendicht
› Montage nach Oberputzauftrag
› Lieferzeit ca. 5 – 8 Arbeitstage
› Silber (ca. EV1)
Wird objektbezogen maßgenau in fertiger Einbaulänge angefertigt. Für die Bestellung bitte die Hinweise zu den benötigten Angaben im technischen Blatt beachten. Bei Fensterbänken > 3000 mm sind Stoßverbinder einzusetzen.
Innovatives Fensterbanksystem für dauerhaft dichte Fensterbankanschlüsse aus stranggepresstem Aluminium mit Schutzfolie. Die Fensterbank wird dauerhaft mit Perfex Montagekleber auf der Perfex Keilplatte verklebt.
Details finden Sie im techn. Blatt P381.de
Eigenschaften und Mehrwert
› Entkoppeltes Fensterbanksystem
› Dauerhaft schlagregendicht
› Montage nach Oberputzauftrag
› Maßgenau in fertiger Einbaulänge bis max. 3000 mm/Stück lieferbar
› Weitere Ausladung auf Anfrage
› Lieferzeit: ca. 18 Arbeitstage
› Bestellbar in allen RAL-Farbtönen

Innovatives Fensterbanksystem für dauerhaft dichte Fensterbankanschlüsse aus hochwertigem Aluminium. Die Fensterbank wird dauerhaft mit Perfex Montagekleber auf der Perfex Keilplatte verklebt. Thermisch bedingte Längenänderungen können von den Perfex Gleitabschlüssen sicher aufgenommen werden.

Details finden Sie im techn. Blatt P381.de
Eigenschaften und Mehrwert
› Entkoppeltes Fensterbanksystem
› Dauerhaft schlagregendicht
› Montage nach Flächenarmierung
› Weitere Ausladung auf Anfrage
› Lieferzeit: ca. 18 Arbeitstage
› Bestellbar in allen RAL-Farbtönen
Eckverbinder aus hochwertigem Aluminium zur einfachen und sicheren Montage der Perfex Fensterbank über 90° Außenecken. Bei Bestellung bitte immer Ausladung der Perfex Fensterbank angeben.
Details finden Sie im techn. Blatt P381.de
Eigenschaften und Mehrwert
› Entkoppeltes Fensterbanksystem
› Dauerhaft schlagregendicht
› Montage nach Oberputzauftrag
› Lieferzeit: ca. 18 Arbeitstage
› Bestellbar in allen RAL-Farbtönen
Stoßverbinder aus hochwertigem Aluminium zur einfachen und sicheren Montage der Perfex Fensterbank. Außenfensterbänke sind mindestens alle 3000 mm zu unterbrechen und durch Stoßverbinder zu verknüpfen. Bei Bestellung bitte immer Ausladung der Perfex Fensterbank angeben.
Details finden Sie im techn. Blatt P381.de
Eigenschaften und Mehrwert
› Entkoppeltes Fensterbanksystem
› Dauerhaft schlagregendicht
› Montage nach Oberputzauftrag
› Lieferzeit: ca. 18 Arbeitstage
› Bestellbar in allen RAL-Farbtönen


Selbstklebendes Abdichtband aus Polymerkautschuk kann optional zum Abdichten der zweiten Dichtebene auf der Perfex Keilplatte vor dem Einbau der Perfex Fensterbank eingesetzt werden. Das Dichtband dient als Verlängerung der Perfex Fensterbank-Dichtecke.
Details finden Sie im techn. Blatt P381.de
Eigenschaften und Mehrwert
› Dauerhaft reißfest und wasserdicht
› Bitumenverträglich
› Leichte Verarbeitung
› Asymmetrisch geteiltes Trennpapier
› Selbstklebend
› Abmessung 25/55 mm
› Lieferzeit ca. 5 – 8 Arbeitstage
Selbstklebende Abdichtbandecke aus Polymerkautschuk kann optional zum Abdichten der zweiten Dichtebene auf der Perfex Keilplatte vor dem Einbau der Perfex Fensterbank eingesetzt werden.
Details finden Sie im techn. Blatt P381.de
Eigenschaften und Mehrwert
› Dauerhaft reißfest und wasserdicht
› Bitumenverträglich
› Leicht verarbeitbar
› Asymmetrisch geteiltes Trennpapier


› Selbstklebend
› Schenkelbreite: 100/100 mm
› Abmessung 25/55 mm
› Lieferzeit ca. 5 –8 Arbeitstage
Systemgeprüfter, mineralischer Spezialkleber mit optimierter Früh-Abbindereaktion auf nicht oder schlecht saugenden Untergründen für Knauf WARM-WAND
Duo zur Aufdopplung bestehender Altfassaden.
Duo-Kleber eignet sich außerdem insbesondere für die Verklebung der Satt Platten, Fassadenprofile, Perfex Jalousiekasten und Jalousieschürze sowie der Kellerdeckendämmplatte 035.
Details finden Sie im techn. Blatt P393.de
Eigenschaften und Mehrwert
› Normalputzmörtel GP nach DIN EN 998-1
› Druckfestigkeitskategorie CS IV nach DIN EN 998-1
› Mit Haftzusatz
› Mineralischer Klebemörtel mit optimierter Abbindereaktion
› Wasserabweisend
› Sehr hohe Klebekraft
› Diffusionsoffen
› Farbton grau
› Für innen und außen
› Verarbeitung mit Maschine oder von Hand
Diese Angaben sind Zirka-Werte und können je nach Art des Untergrundes abweichen.
Einkomponentiger, selbstexpandierender Polyurethanschaum zur Verklebung des Wärmedämm-Verbundsystems WARM-WAND Basis und Plus, zur Verklebung von Perfex Laibungsplatte und Perfex Keilplatte sowie zum Ausschäumen von Dämmplattenfugen.
Details finden Sie im techn. Blatt P392.de
Eigenschaften und Mehrwert
› Hohe Ergiebigkeit
› Schnelle Verarbeitung
› Zum Ausschäumen von Plattenfugen sehr gut geeignet
› Armierung bereits nach 2 Stunden möglich
› Sehr gute Klebkraft auf tragfähigen Beton- und Mauerwerksuntergründen sowie Bitumendickbeschichtungen
› Kostenlose Entsorgung der Verpackung mit dem PDR System

Einkomponentiger, flexibler und spannungsausgleichender Montagekleber zum Schließen von Plattenstößen bei Perfex Laibungsplatten und Perfex Keilplatte. Zur Angleichung der Fugen an die Endbeschichtung kann der Montagekleber nach 6 Stunden Standzeit mit Fugenspachtel Struktur beschichtet werden.
Details finden Sie im techn. Blatt P381.de
Eigenschaften und Mehrwert
› Einkomponentiger Hybrid-Kleb- bzw. Dichtstoff


› Flexibel und spannungsausgleichend
› Für innen und außen
› Farbe: weiß
› Lieferzeit ca. 5 – 8 Arbeitstage
Körnige Spachtelmasse auf Acryl-Dispersionsbasis für saubere Übergänge an Platten- und Gehrungsfugen der Perfex Laibungsplatten. Mit einem feinen Schwamm kann der Fugenspachtel an die Struktur der Endbeschichtung optimal angeglichen werden.
Details finden Sie im techn. Blatt P381.de
Eigenschaften und Mehrwert
› Bewegungsausgleichend
› Filzbar
› Dauerhaft Witterungsbeständig
› Nach einer Trocknungszeit von mindestens 3 Tagen
überstreichbar
› Farbe: weiß
› Lieferzeit ca. 5 – 8 Arbeitstage
Die Anwendung erfolgt nach der Verklebung der Laibungsplatte. Erleichtert die Montage der Perfex Laibungsplatte durch das Fixieren des Gewebeschenkels an der Flächendämmung, bis der Klebeschaum ausexpandiert hat.
Details finden Sie im techn. Blatt P381.de
Eigenschaften und Mehrwert
› Aus Kunststoff
› Länge 40 mm
› 50 Stück pro Paket
Für einen einfachen Breiten-Zuschnitt der Perfex Laibungsplatte. Zwei Klingen ermöglichen bequemes, beidseitiges Schneiden von Perfex Laibungsplatten in einem Arbeitsgang. Mit verstellbarer Schnitttiefe und Zwei-Komponenten-Griff für einen besonders sicheren Halt.
Eigenschaften und Mehrwert
› Geeignet für Plattendicken von 12,5 mm und 20 mm
› Maximale Schnitttiefe 120 mm


Die Fenster-Anschlussbahn ist Bestandteil der 2. Fensterdichtebene und wird in WARM-WAND Systemen im Holzbau eingesetzt. Mit den geprüften und aufeinander abgestimmten Systembestandteilen von Knauf wird eine schlagregendichte zweite Dichtebene zum Schutz der Konstruktion und feuchteempfindlicher Dämmstoffe erzielt.
Details finden Sie in der Montageanleitung
P651-A01.de
Eigenschaften und Mehrwert
› Bestandteil der 2. Fensterdichtebene
› Selbstklebend
› Maße: 0,75 x 170 mm
Die Fenster-Dichtbahn ist Bestandteil der 2. Fensterdichtebene und wird in WARM-WAND Systemen im Holzbau eingesetzt. Mit den geprüften und aufeinander abgestimmten Systembestandteilen von Knauf wird eine schlagregendichte zweite Dichtebene zum Schutz der Konstruktion und feuchteempfindlicher Dämmstoffe erzielt.
Details finden Sie in der Montageanleitung
P651-A01.de
Eigenschaften und Mehrwert
› Bestandteil der 2. Fensterdichtebene
› Selbstklebend
› Maße: 1,0 x 250 mm


Die Fenster-Dichtecke ist Bestandteil der 2. Fensterdichtebene und wird in WARM-WAND Systemen im Holzbau eingesetzt. Mit den geprüften und aufeinander abgestimmten Systembestandteilen von Knauf wird eine schlagregendichte zweite Dichtebene zum Schutz der Konstruktion und feuchteempfindlicher Dämmstoffe erzielt.
Details finden Sie in der Montageanleitung P651-A01.de
Eigenschaften und Mehrwert
› Bestandteil der 2. Fensterdichtebene
› Selbstklebend
› Maße: 200 x 140 mm

› 1 Set = 1x linke und 1x rechte Dichtecke
Der WARM-WAND Dämmkeil ist Bestandteil der 2. Fensterdichtebene und wird in WARM-WAND Systemen im Holzbau eingesetzt. Mit den geprüften und aufeinander abgestimmten Systembestandteilen von Knauf wird eine schlagregendichte zweite Dichtebene zum Schutz der Konstruktion und feuchteempfindlicher Dämmstoffe erzielt.
Details finden Sie in der Montageanleitung P651-A01.de
Eigenschaften und Mehrwert
› Dämmstoff EPS
› Farbe: weiß
› Bestandteil der 2. Fensterdichtebene
› Maße: 1000 x 180 x 24,3/40 mm

Die vorgehängte hinterlüftete Fassade (VHF) ist ein Erfolgsmodell moderner Fassadentechnik. Egal ob Neubau oder Modernisierung – die VHF ist für alle Gebäudetypen geeignet und vereint enorme Gestaltungsfreiheit mit hoher Widerstandsfähigkeit, hervorragender Wirtschaftlichkeit und besten bauphysikalischen Eigenschaften. Die Knauf Putzträgerplatte Aquapanel Outdoor garantiert mit den dazugehörigen Befestigungsmöglichkeiten und dem abgestimmten Putzsystem eine sichere und anspruchsvolle Oberflächengestaltung.

Die vorgehängte hinterlüftete Fassade (VHF) ist nicht umsonst eines der Erfolgsmodelle der zeitgemäßen Fassadentechnik. In ihr fließen gleich mehrere wesentliche Anforderungen an moderne Gebäude zusammen – egal, ob es sich um einen Neubau oder eine Sanierung handelt.

Mit der Knauf Putzträgerplatte AQUAPANEL® Outdoor ist eine anspruchsvolle Oberflächengestaltung mit einem hochwertigen Putzsystem auf allen gängigen Unterkonstruktionen von Holz bis Metall umsetzbar.
Die Vorteile auf einen Blick
› Wirtschaftliche Überlegenheit
Die VHF hat eine hohe Lebensdauer und einen geringen Wartungsaufwand. So erweist sich die VHF über die Jahre als wahres Sparmodell.
› Ausgereifte Technik
Bei der VHF sind der Wärme- und Witterungsschutz konstruktiv voneinander getrennt. Das führt zu einer geringeren Anfälligkeit für Schäden.
› Perfekte Gestaltbarkeit
Mit Knauf AQUAPANEL ® Outdoor sind geschwungene Formen, räumliche Tiefe und zahllose Oberflächenstrukturen problemlos ausführbar.

Bei der vorgehängten hinterlüfteten Fassade sind die Funktionen Witterungsschutz und Wärmedämmung konstruktiv voneinander getrennt. Das sorgt nicht nur für hervorragenden Werterhalt, sondern auch für ein angenehmes Wohnklima. So profitieren Bauherr und Bewohner gleichermaßen.
Keine Durchfeuchtung der Wärmedämmung durch Schlagregen, auch wenn Durchdringungen/Öffnungen vorhanden sind.
Sommerlicher Wärmeschutz durch Hinterlüftung der aufgeheizten Fassade führt zu einem kühl bleibendem Baukörper.

Die hinterlüftete Außenwandbekleidung ist in der Norm DIN 18516-1 geregelt. Sie legt Planungs-, Bemessungs- und Konstruktionsgrundsätze für dauerhafte Konstruktionen fest.
Gemäß DIN 18516-1 ist u. a. für das Bekleidungselement einer hinterlüfteten Außenwandbekleidung eine allgemeine bauaufsichtliche Zulassung / allgemeine Bauartgenehmigung oder Zustimmung im Einzelfall erforderlich.
Baufeuchte kann ganzjährig nach außen abtrocknen.
Regenschutz
Insbesondere bei heftigem, langanhaltendem Regen wird die Fassade als Bauteil am meisten beansprucht. Mit der VHF geben solche Situationen keinen Anlass mehr zur Sorge, da sie der Beanspruchungsgruppe III nach DIN 4180-3 entspricht und damit schlagregendicht ist. Durch den Hinterlüftungsraum zwischen Dämmung und Verkleidung kann zudem Feuchtigkeit gut entweichen.

Feuchte- und Tauwasserschutz
Baufeuchte wird bei der VHF sicher und wirksam durch den Hinterlüftungsraum abgegeben. Durch die vorgehängte hinterlüftete Fassade entsteht ein von innen nach außen abnehmender Wasserdampfdiffusionswiderstand, der dafür sorgt, dass die Dämmung trocken bleibt und in ihrer Funktion nicht beeinträchtigt wird. Das Ergebnis: ein rundum gesundes und angenehmes Wohlfühlklima.
Die brandschutztechnische Einordnung eines VHF Systems leitet sich aus der Klassifizierung der Einzelkomponenten ab. Kommen nur Bestandteile zur Anwendung, die der Baustoffklasse A zugeordnet sind (z. B. Dämmstoff: Mineralfaser; Unterkonstruktion: Aluminium; Bekleidung: Zementbauplatte), so ist auch das Gesamtsystem als nicht brennbar einzustufen. Zusätzliche Sicherheit im Brandfall bieten die in das System eingebrachten Brandbarrieren. Sie verhindern die Brandweiterleitung im Hinterlüftungsspalt. Das Verhalten
einer VHF wird im Brandfall wesentlich schlechter, wenn die Dämmplatten nicht vollflächig auf der Massivwandoberfläche aufliegen. In dem hier nicht gewollten Luftspalt kann es zu einem Übergreifen des Feuers auf andere Teile des Bauwerks oder andere Geschosse kommen.
Schallschutz
Nach DIN 4109, Bbl.1 Absatz 10.1.1 darf bei einer Außenwandkonstruktion mit vorgehängter Bekleidung lediglich die Schalldämmung der inneren Tragschale rechnerisch berücksichtigt werden. Tatsache ist jedoch,
dass VHF einen überaus positiven Einfluss auf die schalldämmende Wirkung der Außenwand haben. Untersuchungen hierzu wurden vom Fachverband Baustoffe und Bauteile für vorgehängte hinterlüftete Fassaden e. V. (FVHF) beauftragt. Demnach steigt das erzielbare Schalldämmmaß bei größerer Dämmschichtdicke und höherer Masse der Bekleidung bei einer unbekleideten Wand von z. B. 54 dB um bis zu 16 dB auf 70 dB.

Vorbehandlungen
Gipsputze
Spachtel pastös
Kalkputze
Unterputze
Oberputze
Sanierung
Dämmschüttungen
Innendämmung
WARM-WAND Dämmstoffe
WARM-WAND Klebe- und Armiermörtel
WARM-WAND Zubehör
AQUAPANEL® VHF
Gestaltungselemente
Farben
AQUAPANEL® VHF
Zementgebundene Platten
AQUAPANEL® Zubehör

Die robuste, nicht brennbare Platte AQUAPANEL® Cement Board Outdoor ist die optimale Putzträgerplatte für Außenwände in hinterlüfteter oder direktbeplankter Bauweise. Sie besteht aus einem Kern aus Portlandzement und Zuschlagstoffen und ist beidseitig mit einem Glasgittergewebe armiert.
Die Enden sind geschnitten und zwei Kanten verstärkt (EasyEdge™). Sie bildet einen soliden Untergrund, der extremen Witterungsbedingungen standhält.
Mit ETA 07/0173 für den Einsatz als Putzträgerplatte an Fassaden sowie für Unterdecken und Deckenbekleidungen im Außenbereich.
Die Anwendung der Aquapanel® Cement Board Outdoor in der VHF wird durch die allgemeine bauaufsichtliche Zulassung Z-33.1-1338 geregelt.
Details finden Sie im techn. Blatt K917.de
Eigenschaften und Mehrwert
› Ideale Alternative zur Massivbauweise
› Optimale Putzträgerplatte für diverse Oberflächenbeschichtungen
› Geeignet für vorgehängte, hinterlüftete oder direktbeplankte Konstruktionen
› Stabil, robust, schlagfest und nicht brennbar
› Witterungs- und wasserbeständig
› Leicht und einfach zu montieren
› Flexible Oberflächengestaltung
› Nicht brennbar
› Biegbar
Zur Befestigung von AQUAPANEL® Cement Board Outdoor auf Holzunterkonstruktionen
Die Fassadenschraube SN 40 ist aus rostfreiem Edelstahl V2A hergestellt. Das Gewinde der AQUAPANEL® Fassadenschrauben SN 40 ist als HiLo-Gewinde ausgeführt.
Die Schraube ist zugelassen als Befestigungsmittel für die Aquapanel Cement Board Outdoor an Holzunterkonstruktionen.
Eigenschaften und Mehrwert
› Schraube: Edelstahl V2A
Zur Befestigung von AQUAPANEL® Cement Board Outdoor auf Aluminiumunterkonstruktionen
Die Fassadenschraube SB 40 ist aus rostfreiem Edelstahl V2A hergestellt. Das Gewinde der AQUAPANEL® Fassadenschraube ist als HiLo-Gewinde ausgeführt.
Die Schraube ist zugelassen als Befestigungsmittel für die Aquapanel Cement Board Outdoor an Aluminiumunterkonstruktionen.
Eigenschaften und Mehrwert
› Schraube: Edelstahl V2A


AQUAPANEL® Fugenspachtel - grau ist eine zementäre Spachtelmasse für die vollständige Verspachtelung der Fuge von Hand. Geeignet für alle AQUAPANEL® Cement Board Bauplatten.
Eigenschaften und Mehrwert
› Normalputzmörtel CS IV nach DIN EN 998 - 1
› Flexible Oberflächengestaltung

AQUAPANEL® Fugenband (10 cm) ist ein Glasgittergewebe mit einem alkaliresistenten Überzug. Es wird zur Armierung der Fugen bei Innenanwendungen und bei Außenanwendungen im Wand- und Deckenbereich verwendet.

Eigenschaften und Mehrwert
› Flexible Oberflächengestaltung
› Länge: 50 m
› Breite: 100 mm
› Farbe: blau
AQUAPANEL® Armierungsband - außen wird im Außenwandbereich zur Fugenarmierung verwendet, wenn auf dem AQUAPANEL® Klebe- und Armiermörtel ein Farbanstrich anstelle einer Putzbeschichtung erfolgen soll.
Eigenschaften und Mehrwert
› Flexible Oberflächengestaltung
› Farbe: blau

› Breite: 200 mm
AQUAPANEL® Klebe- und Armiermörtel - weiß ist ein zementgebundener, kunststoffvergüteter Armiermörtel für AQUAPANEL® Cement Board Outdoor zur Aufnahme von dünnlagigen Oberputzen.
Eigenschaften und Mehrwert
› Flexible Oberflächengestaltung
› Flexible Oberflächengestaltung
› Faser- und Haftzusatz
› Wasserabweisend
› Diffusionsoffen
› Gutes Haftvermögen
› Farbton naturweiß
› Verarbeitung mit Maschine oder von Hand
› Optimale Kornverteilung für glatte Oberflächen
› Flexible Oberflächengestaltung

AQUAPANEL® Gewebe ist ein alkaliresistentes Glasgewebe und wird zur Armierung des AQUAPANEL® Klebe- und Armiermörtels - weiß und des AQUAPANEL® Fugen- und Flächenspachtels - weiß verwendet.
Eigenschaften und Mehrwert
› Flexible Oberflächengestaltung

› Länge: 50 m
› Farbe: blau

AQUAPANEL® Putzgrundierung gehört zum AQUAPANEL® System und reguliert Saugfähikeit sowie Haftfestigkeit des Untergrundes. Sie wird auf AQUAPANEL® Klebe- und Armiermörtel - weiß aufgetragen und dient als Voranstrich für dünnlagige Oberputze wie z. B. AQUAPANEL® Mineralischer Oberputz.
Eigenschaften und Mehrwert
› Hohe Alkalibeständigkeit
› Trocknet weiß färbend aus

AQUAPANEL® Mineralischer Oberputz - weiß ist ein Edelputz mit einer Körnung von 2 mm zum Auftrag in Scheibenputzstruktur auf AQUAPANEL® Klebe- und Armiermörtel - weiß. Durch unterschiedliche Werkzeuge und Bearbeitung lassen sich beliebige, richtungsfreie Strukturen für hochwertige Putzflächen im Außenbereich ausführen.
Eigenschaften und Mehrwert
› Farbton brilliantweiß
› Tönbar
› Für innen und außen
› Druckfestigkeitskategorie CS II nach DIN EN 998-1
› Wasserabweisend
› Diffusionsoffen
› Gutes Haftvermögen
› Witterungsbeständig
› Verarbeitung mit Maschine oder von Hand
› Leicht strukturierbar
Abschlussprofil zum Aufstecken auf Putzträgerplatten für Putzstärke von 6 mm.
Details finden Sie im techn. Blatt P311a.de
Eigenschaften und Mehrwert
› Putzstärke 6 mm
› Alkalibeständiger Gewebeschenkel 100 mm

› Hart-PVC
› Farbe: weiß
› Maschenweite 4 x 4 mm
Abschlussprofil mit Tropfkante zum Aufstecken auf Putzträgerplatten für Putzstärken von 7 mm.
Eigenschaften und Mehrwert
› Putzstärke 7 mm
› Alkalibeständiger Gewebeschenkel 125 mm

› Hart-PVC
› Farbe: weiß
Details finden Sie im techn. Blatt P311b.de
› Maschenweite 4 x 4 mm

› Mit Steckverbinder
› Innenliegendes, selbstklebendes PE-Dichtband
Dreiteilige Profilkombination aus Kunststoff zur Ausbildung horizontaler Bewegungsfugen bei angrenzenden Putzträgerplatten. Profilkombination besteht aus Grundprofil, Bewegungsfugenprofil horizontal oben sowie Bewegungsfugenprofil horizontal unten.
Details finden Sie im techn. Blatt P312a.de
Eigenschaften und Mehrwert
› Putzstärke 5 mm
› Alkalibeständiger Gewebeschenkel 100 mm
› Hart-PVC
› Farbe: weiß
Selbstklebendes, zweiteiliges 3D-Laibungsanschlussprofil mit Gewebe, einem starren Abziehstreifen und weißem PE-Schaumklebeband für einen schlagregendichten Anschluss an Fenster und Türen. Durch die mechanische Entkoppelung werden Bewegungen zwischen Bauelement und Wärmedämm-Verbundsystem nahezu kraftlos aufgenommen. Im verputzten Zustand ist das Fensteranschlussprofil Duo G10 nicht sichtbar (Schattenfuge).
Details finden Sie im techn. Blatt P384c.de
Eigenschaften und Mehrwert
› Schlagregendicht
› Optisch ansprechender Putzanschluss (Schattenfuge)
› Für Putzdicken von 6 bis 15 mm
› Exaktes Anarbeiten durch Abzugskante möglich
› Dreidimensionale Bewegungsaufnahme
› Alkalibeständiges Armiergewebe mit Kunststoffschenkel verbunden
› Bewegungsaufnahme Klasse A
› Empfohlen für Dämmstoffdicken ≤ 300 mm und Fenster- und Türgrößen ≤ 10 m²


Für die Eckarmierung von Außen- und Innenecken
Kunststoff Gewebeeckwinkel mit alkalibeständigem Armiergewebe zur Ausbildung von flexiblen lot- und fluchtgerechten Außen- und Innenecken in Knauf WARM-WAND Systemen. Mit Roll-Eckwinkel sind verschiedene Winkelgrößen ausführbar.
Details finden Sie im techn. Blatt P384a.de
Eigenschaften und Mehrwert
› Alkalibeständiges Armiergewebe
› Maschenweite 4 x 4 mm
› Weißes Kunststoffprofil
› UV-beständig
Gewebeeckwinkel mit alkalibeständigem Armiergewebe zur Ausbildung von flexiblen lot- und fluchtgerechten Außen- und Innenecken in Knauf WARMWAND Systemen.
Details finden Sie im techn. Blatt P385y.de
Eigenschaften und Mehrwert
› Alkalibeständiges Armiergewebe
› Schenkel 70/90 mm

› UV-beständig
› Für innen und außen
› Verschiebefest
Dehnfugenprofil aus zwei gelochten Kunststoffprofilen mit zwei Abzugskanten und Verbindungslasche aus TPE-Folie. Mit beidseitig fest angebrachtem, 100 mm breitem Armiergewebe. Einsetzbar für Innenecken zur dauerhaften und witterungsbeständigen Abdichtung von vertikalen Bewegungsfugen.
Details finden Sie im techn. Blatt P385l.de

Eigenschaften und Mehrwert
› Kunststoff weiß
› Dauerhafte und witterungsbeständige Abdichtung
› Mit fest angeklebtem Armiergewebe
› Mit überstehender Lasche für den Stoßbereich
› Für Putzdicken von 6 bis 12 mm (inkl. Oberputz)
Dehnfugenprofil aus zwei gelochten Kunststoffprofilen mit zwei Abzugskanten und Verbindungslasche aus TPE-Folie. Mit beidseitig fest angebrachtem, 100 mm breitem Armiergewebe.
Einsetzbar für die Fläche zur dauerhaften und witterungsbeständigen Abdichtung von vertikalen Bewegungsfugen.
Details finden Sie im techn. Blatt P385q.de
Eigenschaften und Mehrwert
› Kunststoff weiß
› Dauerhafte und witterungsbeständige Abdichtung
› Mit fest angeklebtem Armiergewebe
› Mit überstehender Lasche für den Stoßbereich
› Für Putzdicken von 6 bis 12 mm (inkl. Oberputz)

Für die Eckarmierung von Außenecken
Kunststoff Gewebeeckwinkel mit alkalibeständigem Armiergewebe zur Ausbildung von lot- und fluchtgerechten Außenecken in Knauf WARM-WAND Systemen und im Rotkalk in-System.
Details finden Sie im techn. Blatt P385w.de
Eigenschaften und Mehrwert
› Alkalibeständiges Armiergewebe
› Maschenweite 4 x 4 mm
› Weißes Kunststoffprofil
› UV-beständig

Gewebeleiste mit TPE-Bewegungslasche für kleine Bauteilbewegungen.
Eigenschaften und Mehrwert
› Kunststoff
› Dauerhafte und witterungsbeständige Abdichtung
› Mit fest angeklebtem Armiergewebe
› Für Putzdicken von 6 bis 12 mm (inkl. Oberputz)
Als Anschlussprofil für Blechverwahrungen und Untersichten von Rollladenkästen mit Abtropfkante.
Eigenschaften und Mehrwert
› Kunststoff
› Gewebeschenkel 125 mm

› Aufkantung 6 mm

Vorkomprimiertes, selbstklebendes, seitenflächenimprägniertes Fugendichtband aus Polyurethan-Weichschaumstoff zur Herstellung von schlagregendichten Anschlüssen bei Knauf WARM-WAND Systemen.
Details finden Sie im techn. Blatt P386c.de
Der Schutzpuffer für Putzanschlüsse aus Moosgummi. Dient als Antidröhnband und schützt Putz vor Druckspannungen an allen Kontaktstellen zu anderen Bauteilen (insbesondere bei Aluminium) unter thermischem Einfluss.
Beim Anbringen unter Fensterbänken oder am Fensterrahmen wird deren Bewegung nicht starr übertragen, was bei schmalen Laibungen besonders wichtig ist.
Eigenschaften und Mehrwert
› Seitenflächen imprägniert
› Temperaturbeständig -30°C bis +90°C
› Schlagregendichtigkeit von Fugen ≥ 1050 Pa
› Zurückkomprimiertes Fugendichtband
› Temperaturunabhängig verlegbar
› Dampfdiffusionsoffen
› Witterungsbeständig
› Selbstklebend
Eigenschaften und Mehrwert
› Farbe: weiß
› Ozonbeständig
› Witterungsbeständig
› Schwitzwasserbeständig
› UV-beständig
› Selbstklebend
› 56 mm breit, teilbar in 38 mm und 18 mm


Mit modernen Werkstoffen und Systemen, handwerklich perfekt umgesetzt, kann der kreative Fassadenspezialist jedem Haus seine eigene, unverwechselbare Note geben. Zahlreiche Möglichkeiten der Fassadengestaltung lassen keine Wünsche offen.
Anspruchsvolle Fassadenarchitektur lässt sich auch mit einem Wärmedämm-Verbundsystem Knauf WARM-WAND verwirklichen. Beispielsweise mit Fassadenprofilen kombiniert, entstehen Gebäude mit stimmigen Proportionen und reizvollen Details. Und mit einer durchdachten Farbgestaltung in Verbindung mit einer außergewöhnlichen Putztechnik können ganz besondere Akzente gesetzt werden.

Die stiltypischen Stuckprofile, Bossenelemente und Faschen aus beschichtetem Polystyrol-Hartschaum sind auf alle Knauf WARM-WAND Systeme abgestimmt. Sie sind handlich, robust, witterungs- und UVbeständig. Und sie können – nach Anfertigung einer Detailzeichnung – in jeder

gewünschten Größe und Form hergestellt werden. Die Fassadenprofile werden mit Knauf Duo-Kleber auf planebenem, tragfähigem Untergrund im Rand-Wulst-Verfahren angeklebt. Anschließend werden die Profilstöße mit Perfex Montagekleber verklebt und mit Stoßarmiermörtel verspachtelt. Bei
Knauf WARM-WAND Systemen sind die Profile auf die Armierungsschicht aufzubringen. Der Anstrich erfolgt immer mit Knauf Autol-Siliconharz-Farbe.


















































Bossenprofil BF

Gestaltungselemente
Fassadenprofile
Vorbehandlungen
Gipsputze
Spachtel pastös
Kalkputze
Unterputze
Oberputze
Sanierung
Dämmschüttungen
Innendämmung
WARM-WAND Dämmstoffe
WARM-WAND Klebe- und Armiermörtel
WARM-WAND Zubehör
AQUAPANEL® VHF
Gestaltungselemente
Farben
Hochwertig beschichtete Fassadenprofile aus EPS mit sehr geringem Eigengewicht für einfache Verarbeitung zur schnellen Umsetzung von eleganten Gestaltungskonzepten. Durch die gewebearmierte, zementfreie Beschichtung weisen die Profile eine hohe Dehnungsfähigkeit und Schlagfestigkeit auf. Die kratzfeste Oberfläche ist hoch witterungs- und alterungsbeständig und optimal auf die WARM-WAND Systeme abgestimmt.
Fugenspachtel für das Verspachteln von Stoßfugen ist im Lieferpaket enthalten. Perfex Montagekleber zum Verkleben der Stöße ist nicht im Lieferpaket enthalten.

Details finden Sie im techn. Blatt P384.de
Eigenschaften und Mehrwert
› Geringes Gewicht
› Einfache und schnelle Verarbeitung
› Hohe Dehnungsfähigkeit
› Hohe Schlagfestigkeit
› Streichfertige, kratzfeste, organisch gebundene Oberflächenbeschichtung
› Witterungsbeständig
› Hoch elastisch
› Profillänge 2000 mm
Hochwertig beschichtete Fassadenprofile aus EPS mit sehr geringem Eigengewicht für einfache Verarbeitung zur schnellen Umsetzung von eleganten Gestaltungskonzepten. Durch die gewebearmierte, zementfreie Beschichtung weisen die Profile eine hohe Dehnungsfähigkeit und Schlagfestigkeit auf. Die kratzfeste Oberfläche ist hoch witterungs- und alterungsbeständig und optimal auf die WARM-WAND Systeme abgestimmt.
Fugenspachtel für das Verspachteln von Stoßfugen ist im Lieferpaket enthalten. Perfex Montagekleber zum Verkleben der Stöße ist nicht im Lieferpaket enthalten.

Details finden Sie im techn. Blatt P384.de
Eigenschaften und Mehrwert
› Geringes Gewicht
› Einfache und schnelle Verarbeitung
› Hohe Dehnungsfähigkeit
› Hohe Schlagfestigkeit
› Streichfertige, kratzfeste, organisch gebundene Oberflächenbeschichtung
› Witterungsbeständig
› Hoch elastisch
› Profillänge 2000 mm

Hochwertig beschichtete Fassadenprofile aus EPS mit sehr geringem Eigengewicht für einfache Verarbeitung zur schnellen Umsetzung von eleganten Gestaltungskonzepten. Die kratzfeste Oberfläche ist hoch witterungs- und alterungsbeständig und optimal auf die WARM-WAND Systeme abgestimmt.
Eigenschaften und Mehrwert
› Geringes Gewicht
› Einfache und schnelle Verarbeitung
› Streichfertige, kratzfeste, organisch gebundene Oberflächenbeschichtung
› Witterungsbeständig
› Alterungsbeständig
› Hoch elastisch

Hochwertig beschichtete Fassadenprofile aus EPS mit sehr geringem Eigengewicht für einfache Verarbeitung zur schnellen Umsetzung von eleganten Gestaltungskonzepten. Die kratzfeste Oberfläche ist hoch witterungs- und alterungsbeständig und optimal auf die WARM-WAND Systeme abgestimmt.
Eigenschaften und Mehrwert
› Geringes Gewicht
› Einfache und schnelle Verarbeitung
› Streichfertige, kratzfeste, organisch gebundene Oberflächenbeschichtung
› Witterungsbeständig
› Alterungsbeständig
› Hoch elastisch

Hochwertig beschichtete Fassadenprofile aus EPS mit sehr geringem Eigengewicht für einfache Verarbeitung zur schnellen Umsetzung von eleganten Gestaltungskonzepten. Die kratzfeste Oberfläche ist hoch witterungs- und alterungsbeständig und optimal auf die WARM-WAND Systeme abgestimmt.
Eigenschaften und Mehrwert
› Geringes Gewicht
› Einfache und schnelle Verarbeitung
› Streichfertige, kratzfeste, organisch gebundene Oberflächenbeschichtung
› Witterungsbeständig
› Alterungsbeständig
› Hoch elastisch

Farbe ist in der Architektur Ausdruck von Individualität und Lebensgefühl – innen wie außen. Fassadenfarben unterstreichen die Beschaffenheit eines Gebäudes, heben einzelne Bauteile gekonnt hervor und tragen maßgeblich zur Gestaltung eines Stadtbildes bei.
Im Innenraum kann ein durchdachtes Farbkonzept der Raumaufteilung Struktur verleihen oder die Persönlichkeit seiner Bewohner widerspiegeln. Und das natürlich ökologisch unbedenklich und schadstofffrei. Mit dem erstklassigen Farbsortiment von Knauf sind der Kreativität bei der Realisierung inspirierender Farbkonzepte keine Grenzen gesetzt.
Farbe kommt in der Architektur eine besondere Bedeutung zu. Neben den vielfältigen gestalterischen Möglichkeiten, die einem Gebäude seinen individuellen Charakter verleihen, erfüllen Farben eine Vielzahl an
wichtigen Funktionen, um das Gebäude langfristig zu schützen und zu erhalten. Ob Sanierung oder Neubau – mit Farben von Knauf lassen sich moderne und zeitlose Architekturkonzepte noch ideenreicher

umsetzen. Mit Knauf Farben individuelles Ambiente gestalten – innen wie außen, in erstklassiger Qualität mit einem großen Spektrum an Möglichkeiten.
Das Material für ein Objekt sollte komplett bestellt werden, da bei späterer Nachbestellung ein rohstoffbedingter Farbtonunterschied nicht auszuschließen ist. Vor Verarbeitung ist der Farbton immer zu prüfen und bei Nachlieferungen mit der Erstbestellung zu vergleichen. Wir empfehlen, eine Probefläche anzulegen, da Beanstandungen zu Farbtonunterschieden nach der Verarbeitung nicht anerkannt werden können.

Der Farbtonfächer Knauf ColorConcept umfasst rund 500 ausgewählte Farbtöne, die keine Wünsche offen lassen. Von brillanten strahlenden Farben bis hin zu raffinierten Pastelltönen – hier sind der Gestaltung
keine Grenzen gesetzt. Die Farbtöne dieser Farbtonkarte können mit organischen Produkten wie Addi, Fassadol oder Intol geliefert werden. Die Machbarkeiten der einzelnen Farbtöne in ausgewählten Raum-
Carrara | Mak3 | Noblo | Noblo Filz | Pico | Rotkalk Filz | Rotkalk Struktur |
RP 240 | SM700 Pro | SP 260
Addi | Conni | Conni TS | Kati | MineralAktiv SP | Raumklima SP |
Raumklima Spritz
Autol | Diamantweiss | EG-Farbe | Faserfarbe | Fassadol | Intol | Malerweiss |
MineralAktiv Farbe | Minerol | Raumklima Farbe | Rotkalk Farbe | Silikatweiss
BG057
Carrara | Mak3 | Noblo | Noblo Filz | Pico | Rotkalk Filz | Rotkalk Struktur |
RP 240 | SM700 Pro | SP 260
Addi | Addi TS | Conni | Conni TS | Kati | MineralAktiv SP | Raumklima SP |
Raumklima Spritz
Autol | Diamantweiss | EG-Farbe | Faserfarbe | Fassadol | Intol | Malerweiss |
MineralAktiv Farbe | Minerol | Raumklima Farbe | Rotkalk Farbe | Silikatweiss
BG045
Addi | Conni | Conni TS | Kati
Autol | EG-Farbe | Faserfarbe | Fassadol | Intol | Malerweiss
BG034
Addi | Addi TS | Conni | Kati
Autol | EG-Farbe | Fassadol | Intol | Malerweiss
BG023
Addi | Addi TS | Conni | Kati
Autol | EG-Farbe | Fassadol | Intol | Malerweiss
BG012
Addi | Conni
Autol | EG-Farbe | Fassadol | Fassadol TSR | Intol
BG001
12,50
klima-Produkten, Siliconharz-EG-Farbe, Siliconharzputzen und -farben sowie mineralischen Produkten lassen sich bequem im Fächer auslesen.
BG 057

Hellbezugswertbereich Aufhellung
Vergrauung
Farbort in englischer Kennung: BG = Blue Greenish
Auf der Rückseite jeder Karte des Farbtonfächers finden Sie die Information, mit welchen Knauf Produkten der jeweilige Farbton umsetzbar ist.
Die Preisgruppen sind dem jeweiligen Produktkatalog zugeordnet. Es gibt die Preisgruppen II, III und IV.
Bezeichnet den Hellbezugswert. Auf Knauf WARM-WAND und anderen WDV-Systemen mit organischen Oberputzen den Hellbezugswert von > 20, bei mineralischen Oberputzen von > 30 einhalten. Mit Fassadol TSR und Autol TSR können auch dunklere Farben sicher realisiert werden. Der Hellbezugswert ist eine bauphysikalische Kenngröße und gibt zusammen mit dem TSR-Wert Auskunft über den Grad der Helligkeit und das Reflexionsvermögen eines Farbtons. Durch Umwandlung von Licht in Wärme wird die Fassadenfläche aufgeheizt.
Mit dem Online-Tool Knauf Farbcenter lässt sich schnell und einfach die Machbarkeit von über 70.000 Farbtönen bei Knauf Produkten prüfen. In neuem Look präsentiert sich das Farbcenter auf der Knauf Website mit zusätzlichen Filter- und Suchfunktionen, einer Anzeigemöglichkeit für ähnliche Farbtöne und einer direkten Suche nach dem nächsten Baustoff-Fachhändler mit Tönanlage.

Den richtigen Farbton für die Gestaltung von Innenwänden und Fassaden zu finden ist nicht immer einfach. Da ist zunächst die nahezu unendliche Vielfalt verschiedener Farbtöne und Farbnuancen. Dann gilt es, die individuellen Wünsche und Vorstellungen von Bauherren und Bewohnern zu berücksichtigen. Und am Ende steht noch die entscheidende Frage, ob der gewünschte Farbton für die eingesetzten Materialien überhaupt machbar ist.
Mit dem Farbcenter bietet Knauf genau das richtige Werkzeug, um solche Fragen schnell und unkompliziert zu beantworten. Auf Basis jahrzehntelanger Erfahrung und Kompetenz im Bereich Putz und Farben hat das Unternehmen das ausgereifte und nützliche Online-Tool entwickelt, mit dem sich in Sekundenschnelle die Machbarkeiten von Farbtönen prüfen lassen. Dieses Tool hat Knauf jetzt nochmals verbessert und um weitere sinnvolle Funktionen ergänzt.

Der Einstieg erfolgt über die Knauf Website oder den direkten Link www.knauf.de/ farbcenter. In der einfach und intuitiv gestalteten Suche lassen sich Farbtöne entweder per Stichwortsuche oder anhand der hinterlegten Farbfächer finden. Mehr als 70.000 Farbtöne aus einer Vielzahl verschiedener Farbfächer, wie z. B. Knauf ColorConcept oder RAL Classic, können so ausgewählt werden. Wird der Wunschfarbton angeklickt, öffnet sich eine übersichtliche Darstellung, in der sämtliche Knauf Produkte und Produktgrup-
pen im Bereich Farbe, Putz und mineralischer Trockenmörtel aufgelistet sind. Über eine Filterfunktion lässt sich diese Auswahl auf die gewünschten Produkte weiter eingrenzen. Selbsterklärende Symbole zeigen auf einen Blick, ob der ausgesuchte Farbton mit dem entsprechenden Knauf Produkt machbar ist. Bei einem negativen Ergebnis hilft die Zusatzfunktion „ähnliche Farbtöne“ eine machbare Farbe zu ermitteln.

Über eine Merkfunktion kann eine individuelle Auswahl an favorisierten Farbtönen angelegt werden. Zusätzlich hat man Zugriff auf eine automatisch generierte Liste aller zuletzt angesehenen Farbtöne. So behält man immer den Überblick. Hat man den passenden Farbton gefunden, lässt sich zu guter Letzt über die Fachhändler-Suche direkt der nächstgelegene Fachhandels-Standort mit Knauf Tönstation ermitteln.
Farben mit anorganischen Pigmenten können nach fünf Tagen auf mineralische und nach 24 Stunden auf pastöse Oberputze gestrichen werden. Bei pastösen Oberputzen mit organischen Pigmenten wird auf frisch erstellten mineralischen und alkalischen Untergründen nach Trocknung und Erhärtung (mind. fünf Tage Standzeit) ein Voranstrich mit eingefärbtem Quarzgrund Pro notwendig.
Der individuelle Ausdruck einer Fassade wird maßgeblich durch ihre Farbe beeinflusst. Sie unterstützt die Architektur und ist Ausdrucksmittel für Stil und Lebensgefühl.
Kombiniert mit hochwertigen Putzen und als Finish für Knauf WARM-WAND Systeme sind Knauf Farben das perfekte Material für handwerkliche Spitzenleistungen. Doch Far-



be bestimmt nicht nur die Optik eines Hauses, sie erfüllt auch eine wichtige Schutzfunktion. Ein atmungsaktiver Anstrich mit qualitativ hochwertigen Farben von Knauf kann eine Fassade lange schützen und den Wohn- und Immobilienwert steigern. Knauf Außenfarben sind sehr ergiebig und wirtschaftlich, leicht in der Verarbeitung und perfekt im Ergebnis.
Vorarbeiten
Untergrund Vorbehandlung
Schmutzempfindliche Bauteile
Wetterseitige Arbeitsflächen
Staub, Schmutz oder andere die Haftung beeinträchtigende Teile am Untergrund
Altputz
Stark saugende, schwach kreidende Untergründe oder mineralische Anstriche
Neuputzstellen
Die Premium Siliconharz-Fassadenfarbe Autol verfügt über einen Selbstreinigungseffekt. Durch die stark reduzierte Anhaftung von Schmutzpartikeln wird der Schmutz von der Fassade bereits bei Beregnung abgewaschen. Sie ist außerdem hoch diffusionsoffen, sehr wasserabweisend, trocknet spannungsarm auf und ist strukturerhaltend.
Abdecken und wasserfest abkleben
Vor Niederschlag schützen, bei direkter Sonneneinstrahlung und sehr warmer Witterung Gerüst mit Netzen abhängen oder Ausführung auf eine günstigere Wetterlage verlegen
Vollständig entfernen, ggf. sandstrahlen oder wasserhochdruckreinigen und vor Weiterarbeit trocknen lassen
Auf Haftung prüfen, Hohlstellen herausschlagen, Putzgrund säubern und entsprechend dem vorhandenen Material und der Struktur aufputzen
Mit Knauf Grundol Tiefengrund E.L.F. satt tränkend streichen/verfestigen, vor Weiterarbeit mind. 12 Std. trocknen lassen
Trocknen und erhärten lassen
Mit Knauf Algizid behandeln und gründlich reinigen Ausblühungen auf gereinigtem Mauerwerk Trocken abkehren
Pilz- und algenbefallene Flächen
Oberflächenfeuchte
Trocknen lassen
Vor Arbeitsbeginn
Kontrollieren Sie die Farb- und Chargennummern bei allen Gebinden und prüfen Sie den Farbton durch einen Probeanstrich auf dessen Richtigkeit. Unterschiedliche Gebinde sollten nicht zusammen an einer Hausseite verarbeitet werden oder vorher in einem sauberen Gefäß miteinander vermischt werden.
Vorbereitung
Knauf Farben sind verarbeitungsfertig eingestellt und müssen vor der Verarbeitung lediglich gut aufgerührt werden.
Je nach Saugverhalten des Untergrundes können jedoch bis zu 5 % Wasser zugegeben werden. Bitte beachten Sie die technischen Detailblätter der einzelnen Produkte.
Knauf Fassadenfarben können im Streich-, Roll- und Spritzverfahren verarbeitet werden. Die Farbe ist dünn und gleichmäßig nass in nass auf den Oberputz oder den Altanstrich aufzutragen.
Hybrid-Fassadenfarben:
Hochwirksam gegen Algen und Pilze
Die Besonderheit dieser Fassadenfarben ist ein mineralisches Hybrid-Bindemittel. Seine bauphysikalischen Eigenschaften und seine dauerhafte Alkalität schaffen für lange Zeit bewuchsfeindliche Bedingungen und schützen Fassaden so vor Algen und Pilzen –ohne biozide Filmkonservierung. Das System ist so formuliert, dass Regentropfen schnell von der Fassaden-Oberfläche abgeführt werden. Tautropfen werden aufgenommen und rückverdunstet. So fehlt Algen und Pilzen zudem das nötige Wasser. Die zugegebenen infrarotaktiven Farbpigmente erhöhen zudem die Oberflächentemperatur der Fassade. Das verringert Tau-Niederschlag und beschleunigt die Rücktrocknung. Die Farben sind hoch diffusionsoffen, bestechen mit enormem Weißgrad, sehr hoher Deckkraft, strukturerhaltender Wirkung und hoher Ergiebigkeit. Durch Abtönen mit anorganischen Farbpigmenten lassen sich lichtechte und sehr stabile Farbtöne in typisch mineralischen Nuancen erstellen.
Siliconharzfarben:
Für höchste Atmungsaktivität
Für die Langlebigkeit einer Fassade ist es von entscheidender Bedeutung, dass sie möglichst trocken bleibt – denn eine feuchte Fas-
sade ist der optimale Nährboden für Algen und Pilze, die die Fassade zerstören können. Für einen effizienten Fassadenschutz ist es daher entscheidend, dass Nässe und Feuchtigkeit nicht eindringen können. Gleichzeitig muss die Feuchtigkeit von innen so schnell wie möglich nach außen transportiert werden, da ansonsten die Gefahr von Abplatzungen besteht.
Mit Knauf Siliconharzfarben kein Problem: Siliconharzfarben sind Verbindungen von Dispersionen mit hochwertigen Siliconharzen. Dadurch sorgen sie für perfekte Wasserdampfdurchlässigkeit und Wasserabweisung für einen langfristig wirkungsvollen Schutz der Fassade.
Silikatfarben: Eine dauerhafte Verbindung Silikatfarben enthalten für den Außenbereich Kaliwasserglas als Hauptbindemittel und einen geringen Anteil von Dispersion. Durch den Dispersionsanteil wird im Außenbereich die Haftung, Lager- und Witterungsbeständigkeit entscheidend verbessert. Anders als andere Anstriche bilden Silikatfarben keine filmbildende Schicht auf dem Untergrund, sondern gehen mit ihm eine chemische, unlösbare Verbindung ein.
Dadurch entsteht sowohl eine feste Vereinigung der Füllstoffe und Pigmente als auch eine sehr gute Haftung der Farbe mit dem Untergrund. Demzufolge sind Silikatfarben besonders hart und vollkommen wasserfest. Natürliche, matte, strukturerhaltende Farben mit einem sehr hohen Deckvermögen ohne Verbleichen lassen keine Wünsche bei der Gestaltung offen.
Siliconverstärkte Reinacrylatfarben: Gute Stimmung bei jedem Wetter
Dispersionen sind die am häufigsten eingesetzten Bindemittel für Farben. Dispersion auf Basis von Reinacrylat bewirkt einen hohen Witterungsschutz. Durch die Zugabe von Siliconen wird die Wasserabweisung verbessert und die Wasserdampfdurchlässigkeit erhöht. Neben dem Vorteil, dass sie sich durch ein sehr hohes Deckvermögen sowie eine besondere Dauerhaftigkeit auszeichnen, sind sie extrem lichtunempfindlich und bleichen daher auch bei starker Sonneneinstrahlung nicht aus. Außerdem schützen Reinacrylatfarben das dahinter liegende Mauerwerk vor aggressiven Luftschadstoffen. Mit siliconverstärkten Reinacrylatfarben lassen sich intensivste Farbtöne realisieren, die durch die hohe Farbtonstabilität langanhaltend schöne Fassaden garantieren.
MineralAktiv
Fassadenfarbe
Autol /Autol TSR
Siliconharz-Fassadenfarbe
Siliconharz-EG-Farbe
Farbtonegalisierende
Siliconharzfarbe
Faserfarbe Armierende
Siliconharz-Fassadenfarbe
Fassadol/Fassadol TSR
Siliconverstärkte Reinacrylatfarbe
Fassadol Metallic
Metallic-Effekt-Beschichtung
Minerol
Silikat-Fassadenfarbe
Hybrid Siliconharz Dispersion Silikat Bindemittel-Basis
Alterungsbeständigkeit
Farbtonvielfalt
Wasserdampfdurchlässigkeit
Wasserdurchlässigkeit
Deckvermögen
Es gibt einfache Methoden, einen Raum optisch zu verändern – und es muss nicht immer eine große Modernisierung sein. Schon mit neuen Farben setzt man starke oder zarte Akzente. Farbe bestimmt die optische Wahrnehmung von Räumen und lässt ganzheitliche Wohnkonzepte Wirklichkeit werden, in denen auch das menschliche Wohlbefinden eine wichtige Rolle spielt. Denn nur humanökologisch unbedenkliche Farben sind heute zeitgemäß. Deshalb bietet Knauf kompro-
misslos alle Innenfarben in E.L.F.-Qualität an. Ob hoch diffusionsoffen oder extrem deckend – kein Anspruch, für den Knauf nicht die jeweils optimale Innenfarbe im Programm hat.
Abhängig vom Untergrund kann eine Untergrundvorbehandlung notwendig werden. Genaue Angaben entnehmen Sie bitte dem technischen Blatt der einzelnen Produkte.
Die Bezeichnung E.L.F. gibt an, dass die Knauf Innenfarben lösemittel- und weichmacherfrei sowie emissionsarm sind. Damit sind sie auch frei von foggingaktiven Substanzen – in TÜV-geprüfter Qualität.
sehr gut geeignet
Vor Arbeitsbeginn

Der Untergrund oder eine vorhandene Beschichtung der zu streichenden Fläche sind zunächst auf ihre Eignung und Tragfähigkeit zu prüfen. Für ein optimales Ergebnis müssen gegebenenfalls entsprechende Maßnahmen zur Untergrundvorbehandlung ergriffen werden.
Farbauftrag im Streich- und Rollverfahren
Knauf Innenfarben können im Streich- und Rollverfahren verarbeitet werden. Die Farbe ist gleichmäßig nass in nass in einem Zug zu beschichten. Dadurch werden Ansätze vermieden.


Die Nassabriebklassen bezeichnen die Nassabriebbeständigkeit und beurteilen damit die Beständigkeit der Beschichtung gegen wiederholtes Reinigen. Die Einteilung erfolgt in die Klassen 1 – 5, wobei die Klasse 1 die größte Nassabriebbeständigkeit beschreibt.
Das Deckvermögen oder auch Kontrastverhältnis bezeichnet die Fähigkeit einer Beschichtung, die Farbe oder Farbunterschiede eines Untergrundes zu überdecken. Man unterscheidet dabei die Stufen 1– 4, wobei Beschichtungen der Stufe 1 das höchste Deckvermögen aufweisen.
Nach der DIN EN 13300 werden die vier Glanzabstufungen glänzend, mittlerer Glanz, matt und stumpfmatt unterschieden.
Vorbehandlungen
Gipsputze
Spachtel pastös
Kalkputze
Unterputze
Oberputze
Sanierung
Dämmschüttungen
Innendämmung
WARM-WAND Dämmstoffe
WARM-WAND Klebe- und Armiermörtel
WARM-WAND Zubehör
AQUAPANEL® VHF
Gestaltungselemente
Farben
Farben
Innenfarben
Fassadenfarben

Hoch diffusionsoffene, schadstoffgeprüfte, konservierungsmittelfreie, stumpfmatte Silikatfarbe für hochwertigste Anstriche an Wände und Decken im Innenraum, systemgeprüft und speziell abgestimmt auf das Rotkalk-Putzsystem.
Details finden Sie im techn. Blatt B125.de
Eigenschaften und Mehrwert
› Emissionsarm
› Hoch diffusionsoffen
› Frei von Konservierungsmitteln, Lösemitteln und Weichmachern
› Frei von fogging-aktiven Substanzen
› Farbton weiß (ca. RAL 9016)
› Sehr hohe Deckkraft
› Kontrastverhältnis: Klasse 2 bei 7 m²/l
› Eingeschränkt tönbar nach Farbtonfächer Knauf ColorConcept
Diese Angaben sind Zirka-Werte und können je nach Art des Untergrundes abweichen.

Diffusionsoffene, schadstoffgeprüfte, stumpfmatte Dispersions-Silikatfarbe für hochwertige Anstriche an Wände und Decken im Innenraum.
Details finden Sie im techn. Blatt B128.de
Eigenschaften und Mehrwert
› Emissionsarm
› Diffusionsoffen
› Frei von Konservierungsmitteln, Lösemitteln und Weichmachern
› Frei von fogging-aktiven Substanzen
› Hohe Deckkraft
› Kontrastverhältnis: Klasse 2 bei 7 m²/l
› Farbton weiß (ca. RAL 9016)
› Glanzgrad: stumpfmatt
Diese Angaben sind Zirka-Werte und können je nach Art des Untergrundes abweichen.
Hoch diffusionsoffene, schadstoffgeprüfte, stumpfmatte Innenfarbe auf Hybridbindemittelbasis ohne Zusatz von Konservierungsmitteln, Lösemitteln und Weichmachern.
Details finden Sie im techn. Blatt B129.a.de
Eigenschaften und Mehrwert
› Hoch diffusionsoffen
› Strukturerhaltend
› Sehr emissionsarm
› Frei von Konservierungsmitteln, Lösemitteln und Weichmachern
› Frei von fogging-aktiven Substanzen
› Hygienisch unbedenklich
› Glanzgrad: stumpfmatt
› Farbton weiß (ca. RAL 9016)
› Eingeschränkt tönbar nach Farbtonfächer
Knauf ColorConcept


Diese Angaben sind Zirka-Werte und können je nach Art des Untergrundes abweichen.
Hochdeckende, schadstoffgeprüfte, stumpfmatte Innendispersionsfarbe für hochwertige Anstriche auf Wände und Decken.
Details finden Sie im techn. Blatt B121.de
Eigenschaften und Mehrwert
› Emissionsarm
› Lösemittel- und weichmacherfrei
› Frei von fogging-aktiven Substanzen
› Sehr hohe Deckkraft
› Kontrastverhältnis: Klasse 1 bei 7 m²/l
› Farbton weiß (ca. RAL 9003)
› Glanzgrad: stumpfmatt
› Tönbar nach Farbtonfächer Knauf ColorConcept
Diese Angaben sind Zirka-Werte und können je nach Art des Untergrundes abweichen.

Sehr gut deckende, schadstoffgeprüfte, stumpfmatte Innendispersionsfarbe für Wände und Decken.
Details finden Sie im techn. Blatt B127.de
Eigenschaften und Mehrwert
› Emissionsarm
› Diffusionsfähig
› Frei von Lösemitteln, Weichmachern und fogging-aktiven Substanzen
› Sehr hohe Deckkraft
› Kontrastverhältnis: Klasse 2 bei 7 m²/l
› Farbton weiß (ca. RAL 9016)
› Glanzgrad: stumpfmatt
Diese Angaben sind Zirka-Werte und können je nach Art des Untergrundes abweichen.
Hoch diffusionsoffene, matte Siliconharz-Egalisationsfarbe zum einmaligen, strukturerhaltenden Überstreichen von mineralischen Oberputzen.
Details finden Sie im techn. Blatt B133.de
Eigenschaften und Mehrwert
› Hoch diffusionsoffen
› Wasserabweisend
› Hohe Ergiebigkeit
› Spannungsarm
› Strukturerhaltend
› Farbton weiß (ca. RAL 9016)
› Tönbar nach Farbtonfächer Knauf ColorConcept
Diese Angaben sind Zirka-Werte und können je nach Art des Untergrundes abweichen.

Hoch diffusionsoffene, matte Premium Siliconharz-Fassadenfarbe mit Selbstreinigungs-Effekt. Eine stark reduzierte Anhaftung von Schmutzpartikeln führt zum Abwaschen des Schmutzes allein durch Beregnung.
Details finden Sie im techn. Blatt B131.de
Eigenschaften und Mehrwert
› Premium Siliconharz-Fassadenfarbe mit Selbstreinigungs-Effekt
› Hoher Kontaktwinkel > 130°
› Hoch diffusionsoffen
› Hoch wasserabweisend
› Spannungsarm
› Strukturerhaltend
› Hohe Deckkraft
› Farbton weiß (ca. RAL 9016)
› Tönbar nach Farbtonfächer Knauf ColorConcept
Diese Angaben sind Zirka-Werte und können je nach Art des Untergrundes abweichen.

Hoch diffusionsoffene, matte Siliconharz-Fassadenfarbe mit Selbstreinigungseffekt. Reflexionsoptimiert, geringe solare Aufheizung und erhöhte Sicherheit gegen Rissbildung im Untergrund.
Details finden Sie im techn. Blatt B131T.de
Eigenschaften und Mehrwert
› Für außen
› Premium Siliconharz-Fassadenfarbe mit Selbstreinigungs-Effekt
› Verringert solare Aufheizung und erhöht dadurch die Sicherheit gegen Rissbildung im Untergrund
› Hoch diffusionsoffen
› Hohe Füllkraft
› TSR-optimiert; ermöglicht dunkle Farbtöne (HBW ≤ 20) auf WARM-WAND Systemen
Diese Angaben sind Zirka-Werte und können je nach Art des Untergrundes abweichen.

Armierende Siliconharz-Fassadenfarbe
Spezial-Fassadenfarbe zur Füllung von Haar- und Schwindrissen mit einer Rissbreite von < 0,2 mm.
Details finden Sie im techn. Blatt B134.de
Eigenschaften und Mehrwert
› Armierende Siliconharz-Fassadenfarbe
› Haar- und schwindrissfüllend
› Diffusionsoffen
› Wasserabweisend
› Spannungsarm
› Sehr hohe Deckkraft
› Farbton weiß (ca. RAL 9016)
› Tönbar nach Farbtonfächer Knauf ColorConcept
Diese Angaben sind Zirka-Werte und können je nach Art des Untergrundes abweichen.


Strukturerhaltende, mineralische Fassadenfarbe auf Hybrid-Bindemittelbasis ohne Zusatz von Weichmachern sowie Konservierungs- und Lösemittel. Zur natürlichen Algen- und Pilzprävention ohne bioziden Fassadenschutz im System mit MineralAktiv Scheibenputz oder allen mineralischen Oberputzen.
Details finden Sie im techn. Blatt B135m.de
Eigenschaften und Mehrwert
› Für außen
› Optimiertes Feuchtemanagement zur Algen- und Pilzprävention
› Ohne biozide Filmkonservierung
› Mineralisch matter Charakter
› Hoch diffusionsoffen
› Sehr hohe Deckkraft
› Wasserverdünnbar
› Hohe Ergiebigkeit
› Farbton weiß (ca. RAL 9016)
› Eingeschränkt tönbar nach Farbtonfächer Knauf ColorConcept

Diffusionsoffene, matte, siliconverstärkte Fassadenfarbe für intensive Farbtönung.
Details finden Sie im techn. Blatt B132.de
Eigenschaften und Mehrwert
› Für außen
› Hoch farbtonstabil
› Hohe Füll- und Deckkraft
› Diffusionsoffen
› Farbton weiß (ca. RAL 9003)
› Tönbar nach Farbtonfächer Knauf ColorConcept
Diese Angaben sind Zirka-Werte und können je nach Art des Untergrundes abweichen.


Reflexionsoptimierte, siliconverstärkte, hoch farbtonstabile und hoch deckende Reinacrylat-Fassadenfarbe mit einem tuchmatten Erscheinungsbild. Sie ist diffusionsoffen, hoch wasserabweisend und trocknet spannungsarm auf.
Mit Fassadol TSR sind auch Farbtöne mit Hellbezugswert < 20 auf WARM-WAND Systemen möglich.
Details finden Sie im techn. Blatt B132T.de
Eigenschaften und Mehrwert
› Für außen
› Glanzgrad: tuchmatt
› Verringert solare Aufheizung und erhöht dadurch die Sicherheit gegen Rissbildung im Untergrund
› Diffusionsoffen
› Wasserabweisend
› Ergiebig
Diese Angaben sind Zirka-Werte und können je nach Art des Untergrundes abweichen.
Hochdeckende, siliconverstärkte, sehr farbtonstabile Effekt-Beschichtung mit metallischem Charakter in verschiedenen Farbtönen. Fassadol Metallic eignet sich besonders für kreative Oberflächengestaltung im Innenbereich und an der Fassade.
Details finden Sie im techn. Blatt B132M.de
Eigenschaften und Mehrwert
› Hohes Deckvermögen
› Hohe Farbtonstabilität
› Ohne biozide Filmkonservierung
› Schnell trocknend
› Für innen und außen
› Glanzgrad glänzend
› Metallisch glänzender Charakter
› Lieferbare Farbtöne: Gold, Silber, Kupfer, Carbon, Carneol, Kiesel, Kristall und Smaragd

Hoch diffusionsoffene, matte, einkomponentige Silikat-Fassadenfarbe mit organischen Stabilisatoren, strukturerhaltend für mineralische Untergründe. Verbindet sich durch Verkieselung mit dem Untergrund.
Details finden Sie im techn. Blatt B135.de
Eigenschaften und Mehrwert
› Mineralisch matter Charakter
› Max. 5 % organischer Anteil
› Nicht filmbildend
› Hoch diffusionsoffen
› Wasserabweisend
› Sehr hohe Deckkraft
› Für außen
› Farbton weiß (ca. RAL 9016)
› Eingeschränkt tönbar nach Farbtonfächer Knauf ColorConcept
Diese Angaben sind Zirka-Werte und können je nach Art des Untergrundes abweichen.Der exakte Materialbedarf ist durch einen Probeauftrag am Objekt zu ermitteln.
Neben der hohen Verarbeitungsqualität unserer Produkte liegt uns auch deren Wirtschaftlichkeit am Herzen – die ökonomische Baustelle, optimal vorbereitet und deshalb klar kalkulierbar. So bietet Knauf beispielsweise bei der Wärmeschutzfassade einen hocheffektiven Logistikservice zur Einrichtung der Baustelle an. Die Silologistik hat Knauf selbst in die Hand genommen.
Wir garantieren Ihnen einen 24-Stunden-Service und eine Anlieferung Just-inTime. Perfekte Betreuung durch unsere Service-Mitarbeiter und hochwertige Maschinentechnik der Knauf PFT für alle Anforderungen der modernen Bauweise.

Zeit ist Geld – das gilt heute mehr denn je. Gerade bei großen Objekten kann auf den Einsatz moderner Maschinen- und Logistiklösungen aus Effizienzgründen kaum verzichtet werden. Am deutlichsten zeigt sich der Vorteil bei der Verarbeitung von
Wärmedämm-Verbundsystemen wie Knauf WARM-WAND. Ob Kleben, Armieren oder beim Putzauftrag – Maschinentechnik erleichtert die Arbeitsabläufe und verbessert die Arbeitsbedingungen auf der Baustelle enorm.
Und mit dem einzigartigen Logistikservice SPRINTER plus IMBAG bei Fassadendämmung leisten wir unseren Beitrag zu perfekter Arbeitsorganisation und optimaler Wirtschaftlichkeit.
Die kompakte, pneumatische Förderanlage mit hoher Leistung ist direkt am Behälterrahmen verschraubt und daher mit geringstem Montageaufwand sofort einsatzbereit.
SILOJET fördert vollautomatisch Gipsputze wie MP 75 Diamant, MP 75 L, MP 75 G/F aus dem Silo über große Distanzen direkt zum Verarbeitungsort wie z. B. Mischpumpe, Putzmaschine oder Durchlaufmischer.
Ausführung: komplett als 140er Anlage im „robusten“ Rahmen zum Anflanschen.
Vorteile auf einen Blick:
› Förderleistung bis zu 140 m
› Automatische Silobelüftung
› Düsenautomatik
› Kontrolle bei Werksbefüllung
› Antistopferprogramm
Die stufenlos regulierbare Misch- und Förderpumpe mit Hydraulikmotor ermöglicht angenehmes, bedarfsgerechtes Arbeiten mit perfekter Mörtelkonsistenz.
MA-MA ist betriebsbereit am Silo angeflanscht, so kann ohne Zeitverlust sofort mit der Arbeit begonnen werden. MA-MA ist insbesondere zum Mischen und Spritzen von Unterputzen wie LUP 222, Super Lupp und Lustro bestens geeignet.
Darüber hinaus verfügen Sie mit MA-MA, bei entsprechender Schlauchzahl, über einen großen Aktionsradius – das Schleppen der vollen und Entsorgen der leeren Säcke entfällt.
Vorteile auf einen Blick:
› Einfache Bedienung
› Schnelle Reinigung
› Hydraulikantrieb
› Kein Schneckenmantelwechsel
› Großer Aktionsradius
Die Misch- und Förderpumpe ist betriebsbereit am Silo angeflanscht und speziell zum Mischen, Transportieren und Spritzen von Lustro Klebe- und Armiermörtel im Silo konzipiert.



Das Kleben und Armieren von WARMWAND Systemen oder die Überarbeitung von Altfassaden gelingt damit besonders wirtschaftlich.
Die Leistung ist durch die Wahl des Schneckenmantels regulierbar – so hat man genau die Mörtelmenge an der Wand, die man verarbeiten kann.
Vorteile auf einen Blick:
› Optimal auf den Klebe- und Armiermörtel Lustro abgestimmt
› Kein Transportaufwand durch Festeinbau
› Schnelles und rationelles Kleben und Armieren von WARM-WAND Systemen
Besonders vorteilhaft und rationell zu verarbeiten ist lose Ware, die in Silos zur Baustelle transportiert wird.
Knauf hat die Silologistik selbst in die Hand genommen. Wir garantieren Ihnen: LogistikKnow-how, 24-Stunden-Service, Just-inTime-Anlieferungen, qualifizierte Betreuung durch unsere Servicemitarbeiter, komplette Logistiklösungen sowie bei Gipsputzen Förderung bis in die Etage. Zur reibungslosen und wirtschaftlichen Ab-
wicklung erhalten Sie das auf das Produkt und die benötigte Menge abgestimmte Silo. Maschinenputze werden in Freifall- oder Drucksilos mit einem Volumen von bis zu 22,5 m³ zur Baustelle transportiert. Das maximale Befüllgewicht hängt vom Produkt und dem maximalen Transportgewicht des eingesetzten Fahrzeugs ab. Für die Verarbeitung aus Freifallsilos werden drucklose pneumatische Förderanlagen (z. B. SILOMAT-Anlagen von PFT) und Rüttler benötigt. Für die Verarbeitung aus Drucksilos benö-

tigt man Druckförderanlagen. Sowohl der Fahrer des Silo-LKWs (bei Baustellenbefüllung) als auch der Aufsteller der Silos und/ oder der Benutzer des Baustellenbehälters müssen dabei die Aufstellbedingungen des Bundesverbandes Gips erfüllen.
PuMax
Basierend auf der bewährten Technik der PFT G4 verfügt die kontinuierlich arbeitende Mischpumpe PuMax über einen noch stärkeren Antriebsmotor. In Verbindung mit einer speziellen Pumptechnik können somit Schlauchlängen bis zu 65 m realisiert werden – ein Aktionsradius der sich sehen lassen kann!
Außerdem ist sie betriebsbereit direkt am Silo angebracht. Technisch ausgereift verhindert eine Phasenfehleranzeige und eine Nasssonde effektiv das Eindringen von Nassmörtel in die Trockenzone. Der Drehflügelmelder steuert automatisch den Rüttler und verhindert damit effizient Leerfahrten.
Vorteile auf einen Blick:
› Schlauchlängen bis 65 m realisierbar
› Gummimischzone reduziert den Reinigungsaufwand
› Kein Eindringen von Nassmörtel in die Trockenzone
› Zusätzlich schaltbare Amaturenheizung
› Materialzugabe auch über NotSackaufnahme möglich
› einfache Bedienung über stirnseitigen
Betreiber von Baustellensilos sowie die Fahrer von Spediteuren, Silostellern und Silofahrzeugen sollten einige Hinweise und Bedingungen beachten, um den gefahrlosen Umgang mit Baustellensilos auf der Baustelle sicherzustellen.
Diese Bedingungen sind nachfolgend als Richtlinien für das Aufstellen und Benutzen von Baustellensilos zusammengefasst. Anhand der Piktogramme ist ersichtlich, wer in welchen Situationen in der Regel verantwortlich ist.
Baustellenanforderungen der Silologistik
der Betreiber/ Benutzer auf der Baustelle
der Fahrer des Silostellers/(Mörtel-) Herstellers
der Fahrer des Siloaufliegers
Gut zu wissen
Knauf Container Next
Mit der neuen Bestellplattform für lose Ware, Knauf Container Next, gewinnen Sie täglich Zeit für Ihr Geschäft.
› Neustellung, Nachfüllung und Rückholung per Fingertipp
› Silobewegungen planen & beauftragen –wann Sie wollen
› Bestell- und Lieferstatus tagesaktuell sichtbar
› ... und vieles mehr www.knauf.de/containernext
Mindestbreite 3,0 m Tragfähigkeit
Beim Aufstellen/Verladen dürfen sich keine unbefugten Personen im Gefahrenbereich des Baustellenbehälters aufhalten.
Baustellenbehälter dürfen nur an den Aufnahmebeschlägen und nur mit einem dafür geeigneten Gerät durch befugte Personen transportiert oder umgestellt werden.
Der Aufstellplatz für den Behälter ist so zu wählen und vorzubereiten, dass das Behälter-Transportfahrzeug und der Silowagen auf sicherer Fahrbahn an- und abfahren können. Ein Sicherheitsabstand zu elektrischen Freileitungen ist zu beachten. Kann dieser nicht eingehalten werden, ist Rücksprache mit dem Energieversorgungsunternehmen zu führen. Der von der örtlichen Bauleitung ausgewählte Standplatz ist persönlich zuzuweisen oder eindeutig zu kennzeichnen.
Es muss ein ebener Aufstellplatz von mindestens 3 x 3 m Größe vorhanden sein. Der Aufstellplatz muss gegen Unterspülen und seitliches Abrutschen gesichert sein. Bei Aufstellung im Bereich von verbauten Baugruben und Gräben ist der Verbau nach DIN 4124 statisch nachzuweisen.
Der Behälter muss senkrecht stehen. Besondere Vorsicht ist geboten im Randbereich von Baugruben, Rohrgräben, Böschungen u. Ä., bei aufgeschüttetem Boden, bei längerer Standzeit des Behälters sowie bei ungünstigen Witterungsbedingungen (z. B. gefrorener Boden).
Während der Standzeit, insbesondere aber beim Befüllen des Behälters, ist der Unterbau ständig auf etwaiges Einsinken zu beobachten und sind ggf. Gegenmaßnahmen rechtzeitig einzuleiten.
Werden Baustellenbehälter im öffentlichen Verkehrsraum abgestellt, so ist eine Sondernutzungserlaubnis für das Abstellen auf Gehwegen oder Straßen nach StVO einzuholen; der Behälter ist mit reflektierenden Folien in den Farben Rot und Weiß zu kennzeichnen. Die Erlaubnis nach StVO ist dem Aufsteller nachzuweisen.
Die Bodenbelastung beträgt bei gefülltem Behälter bis zu 0,3 N/mm². Dementsprechend ist die Tragfähigkeit des Aufstellplatzes zu gewährleisten.
Bei unzureichender Tragfähigkeit des Bodens ist eine Fundamentierung durchzuführen. Im Regelfall sind Stahlbetonfundamente zu wählen. Dabei ist Platten- und/oder Streifenfundamenten der Vorzug vor Einzelfundamenten zu geben. Anstelle von Betonfundamenten kann auch ein Schwellenlager angelegt werden, wenn tragfähiger Untergrund mit einer zulässigen Bodenpressung von mehr als 0,2 N/mm² vorhanden ist. Für ein Schwellenlager verwendete Bohlen müssen 3 bis 3,5 m lang, 30 cm breit und 8 cm dick sein. Für die zulässige Belastung des Baugrundes gilt die DIN 1054.
Leere Behälter müssen ggf. gegen Windkräfte verankert werden.
Vor dem Befüllen sind Füll- und Entlüftungsleitungen auf freien Durchgang sowie sämtliche Sicherheitseinrichtungen auf Funktionstüchtigkeit zu überprüfen; der Staubsack ist anzuschließen. Die Behälter müssen stoßfrei befüllt werden. Der im Behälter entstehende Befülldruck darf 0,1 bar nicht überschreiten. Die Entspannung der Restluft im Behälter ist verboten.
Die Entlüftungsleitungen sind stets offenzuhalten; Druck darf sich im Behälter nicht aufbauen!
Alle am Baustellenbehälter festgestellten Schäden und Manipulationen sind dem Eigentümer des Behälters unverzüglich zu melden.
Der Besteller/Mieter/Benutzer haftet für alle Gefahren und Schäden, die durch die Benutzung des Behälters auftreten.
Wird bei der Entnahme zur Verbesserung des Materialauslaufverhaltens ein elektrischer Rüttler verwendet, so soll dieser eine Fliehkraft von max. 3 kN (300 kp) haben. Zur Befestigung des Rüttlers dient ausschließlich die angeschweißte Rüttlerplatte. Ein Rüttler darf nur zeitgleich mit der Förderanlage oder Mischmaschine in Betrieb sein. Bei leerem Silo ist der Rüttler sofort abzuschalten!
Beim Aufladen des Baustellenbehälters auf das Transportfahrzeug müssen alle eingebauten Anlagen und Maschinen aus dem Schwenkbereich entfernt sein. Vor dem Transport müssen Dach und Standrahmen des Behälters von Verschmutzungen gesäubert sein; Befüllöffnung und Auslaufklappe des Baustellenbehälters müssen geschlossen sein.
Es gelten die nachfolgenden Sicherheitsbestimmungen und Unfallverhütungsvorschriften:
n ZH 1/589 Richtlinien für austauschbare Kipp- und Absetzbehälter
n VBG 1 Allgemeine Vorschriften
n VBG 74 Leitern und Tritte
n VBG 112 Silos
n allgemeine Unfallverhütungsvorschriften
Kernpunkte der Knauf Silologistik sind regionale Dispositionsstellen, die mit EDV-Unterstützung die gesamte Organisation von der Auftragsannahme bis zur Anlieferung steuern. Durch das weit gespannte Netzwerk sind wir in der Lage, Kundenwünsche flexibel und kurzfristig umzusetzen.
Intelligente Maschinentechnik vereinfacht die Baustellenlogistik und verkürzt die Misch- und Pumpzeiten der Werktrockenmörtel. Auf Basis regelmäßiger Gespräche mit unseren Partnern und Kunden optimieren wir ständig die Abläufe auf Baustellen und suchen immer wieder nach Verbesserungsmöglichkeiten für unsere Produkte.

Bei technischen Störungen an KNAUFMaschinentechnik, können Sie sich gerne an unseren Service-Support wenden:
Telefon:
+49 9323-31-6042
E-Mail: LoseLogistikService@knauf.com
Iphofen
Auftragsmanagement
Putz- & Fassadensysteme
Telefon: +499323-31-9345
E-Mail: LoseLogistikPF@knauf.com

Die Imbags werden sicher miteinander verbunden, per Flaschenzug am Gerüst hochgezogen und in senkrechter Reihe an dessen Außenseite eingehakt – fertig.
Die wertvollen Dämmplatten sind so vor Wind und Wetter geschützt, hängen zu hoch für Diebe und sind höchst entgegenkommend bei der Montage. Denn Imbag, das sackstarke Materialdepot,
hängt außen am Gerüst. Das Gerüst bleibt frei – das gibt Platz auf dem Gerüst und erhöht die Arbeitssicherheit.

Kompetente Knauf Mitarbeiter helfen Ihnen bei der Planung. Verlassen Sie sich auf unsere Erfahrung für effektive Logistik an der Fassade. Für eine ganz klare Kalkulation und maximale Planungssicherheit.
Der SPRINTER plus IMBAG Service ist bei einer Vielzahl von Stahlgerüsten 70/100 möglich. Für EPS-Dämmstoffe ist auch das Gerüst Layher Alu 70 m bis 16 m Höhe zulässig. Aktuelle Informationen und Voraussetzungen erfahren Sie bei Ihrem Ansprechpartner Jörg Schmidt (09323 31-1572) oder bei Ihrem Knauf Berater.
Unter www.knauf.de im Dokumenten-Center (Suchbegriff „Imbag“) haben wir eine Checkliste als Grundlage für Ihre Planung mit den entsprechenden Ansprechpartnern hinterlegt. Diese können Sie bequem am PC ausfüllen und schon kann es losgehen!
Leistungsbeschreibung Sprinterlogistik
1. Warenannahme am Bauvorhaben durch Sprinterteam
2. Entladung Dämmmaterial durch Sprinterteam Mitnahmestapler zum Entladen notwendig (Spedition)
3. Entsorgung der Verpackungsfolie durch Sprinterteam
4. Befüllung der Imbags mit Dämmmaterial und Hängen an das Baugerüst durch Sprinterteam
5. Räumung der leeren Imbags vom BvH nach Freigabe Fachunternehmer durch Sprinterteam
6. Umladung der sortenreinen Produktreste WDV aus Imbags in Schrumpfhauben am BvH zur Verfügung der Fachunternehmer
Fassungsvermögen in m² pro Imbag abhängig von Dämmstoffdicke und System
Mitnahmestapler zum Entladen notwendig (Spedition)

Das Unternehmen PFT gilt weltweit als innovativer Hersteller und Impulsgeber für Maschinentechnologien der Extra-Klasse. 100 % Qualität, Service auf höchstem Niveau, Zuverlässigkeit „Made by PFT“, hohe Produktionstiefe und Innovationen












dafür steht das weltweit agierende Unternehmen. Die hohe Produktionstiefe ist der Schlüssel für die Spitzenqualität, die unsere Produkte seit über 40 Jahren auszeichnet.


Das PFT Produktprogramm umfasst unter anderem: Förderanlagen, Durchlaufmischer, Mischpumpen, Förderpumpen und Airless-Geräte. Knauf PFT sorgt mit Vertriebsund Service-Centern in über 100 Ländern auf großen sowie auf kleinen Baustellen mit der Erfahrung aus über 50 Jahren erfolgreich für den „FLUSS DER DINGE“.
PFT Pneumatische Förderanlagen Verputzen
… übernehmen vollautomatisch den Materialtransport des Werktrockenmörtels aus dem Silo/Container zur Mischpumpe bzw. zum Mischer.
Verputzen heißt heute: Topfit sein mit modernster PFT-Maschinentechnik. Im PFT-Produktprogramm findet sich für jede Aufgabe die wirtschaftlichste Lösung.
PFT Mischpumpen Beschichten
… mischen und pumpen kontinuierlich und vollautomatisch alle maschinengängigen Werktrockenmörtel auf Gips-, Kalk- und Zementbasis mit Wasser zu einem verarbeitungsfähigen Mörtel.
Moderne Maschinentechnik ist heute ein Muss für professionelle Beschichtungen – als Arbeitserleichterung und für die Wirtschaftlichkeit und Konkurrenzfähigkeit.
… mischen kontinuierlich und vollautomatisch Werktrockenmörtel zu einem verarbeitungsfertigen Material. Einsetzbar mit Sackware, Kombination Sackund Siloware oder ausschließlich mit Siloware.
PFT Horizontale Durchlaufmischer Schneiden
Einfaches Schneiden von Dämmplatten. Sauber, genau und schnell – bei minimalem Verschnitt. Auch hochformatig oder in jedem Winkel zu schneiden.
PFT Zwangsmischer WDVS-Arbeiten
… sind geeignet zum Anmischen von verschiedenen Komponenten sowie Mischungen aus Sand, Zement und Kalk. Auch Saniermörtel und erdfeuchte Materialien wie Lehmputze sind möglich.
Maschinelles Kleben, Armieren, Schneiden und Verputzen. Beim Verarbeiten von WDVS hilft die Maschinentechnik von PFT, die Arbeitsabläufe zu rationalisieren.
PFT Förderpumpen Aufspritzen
… sind universell einsetzbar mit stufenlos einstellbarer Förderleistung für Mörtel, Putze, pastöse Massen und flüssige Medien. In verschiedenen Leistungsklassen lieferbar.
Das nebelarme Spritzen mit einem Airless-Spritzgerät der PFT SAMBA-Familie oder der Förderpumpe PFT SWING airless rundet das Komplett-System zum Erstellen der WDVS-Fassade ab.
PFT AirlessSpritzgeräte Trockenbau
… sind flexibel einsetzbare Spritzmaschinen für zahlreiche pastöse Materialien und Farben, die direkt aus einem Eimer bzw. Vorlagegefäß angesaugt werden.
Der Einsatz des PFT BOARDMASTERs zur Gestaltung im Trockenbau eignet sich optimal für schnelle, saubere und kostensparende Verarbeitung von Gipskartonplatten sowie anderen Materialien.
PFT Schneidetisch Sanieren/ Renovieren
PFT Spezialmaschinen
… zur Verarbeitung von Gipskartonplatten und ähnlichen Werkstoffen für Plattengrößen bis zu 600 x 125 cm (LxB). Speziell für den Fassaden- und Innenausbau entwickelt.
… werden nach unterschiedlichsten Anforderungen und speziellen Einsatzgebieten nach Kundenwunsch entwickelt und produziert.
Verfüllen/ Verfugen
Das richtige Zusammenspiel von Material und Maschine macht den Erfolg aus. So beobachtet PFT den Markt, um immer auf dem neuesten Stand zu sein.
Für diese Arbeiten benötigt man Fingerspitzengefühl. Ein echter Vorteil: die stufenlose Mörtelflusssteuerung.
… schneiden Wärmedämmplatten bis zu einer Dicke von max. 310 mm und bis zu einer Höhe von max. 1350 mm mit nur einer kurzen Armbewegung von vorn nach hinten schnell und mühelos durch.
PFT Heißdrahtschneidegeräte Vergießen
Estrich muss fließen. PFT bietet komplette Maschinen-Systeme: Vom Großprojekt mit Silofahrzeugversorgung bis zu Kleinobjekten mit Sackwarenbeschichtung.
… zum PFT System gehören zahlreiche baustellenerprobte und praxisgerechte Spezialgeräte, Werkzeuge und Hilfsmittel.
PFT Geräte/Werkzeug/ Zubehör Injizieren/ Verpressen
Die kraftsparende Methode der Mörtelverarbeitung. Injizieren und Verpressen in einem Arbeitsgang.
75 L Fire, MP 75 G/F, MP 75 Diamant, MP 75 L-F, MP 75 F, MP 75, MP 75
Rotband Pro, MP 75 L Raumklima
Klebemörtel aufspritzen
Maschinelles Kleberauftragen mit der Mischpumpe plus Feinputzspritzgerät auf die Wand oder direkt auf die Dämmplatte mit der PFT ZARGOMAT-Pistole.




Dämmplatten schneiden
Einfaches Schneiden der Dämmplatten. Sauber, genau und schnell – kaum Verschnitt und wenig Polystyrol-Abfall. Direkt am Gerüst montierbar. Auch hochformatig oder in jedem Winkel zu schneiden.
Armierungskleber aufspritzen
Auf die fertig gedübelte Fassade wird der Armierungskleber gleichmäßig mit dem Spritzgerät für Zier- und Armierungsputz aufgespritzt.
Dies erleichtert das Einbetten des Armierungsgewebes und das aufwendige Glattziehen kann entfallen.
PFT Maschinenempfehlung:
Mischpumpen PFT G 4, PFT RITMO oder Maschinenkombination aus Durchlaufmischer PFT HM/PFT LOTUS und Förderpumpen PFT SWING.
PFT Maschinenempfehlung:
Heißdrahtschneidegerät PFT CUTMASTER und für kleine Schnitte das Handgerät PFT MINICUT.
PFT Maschinenempfehlung:
Mischpumpe bzw. Durchlaufmischer mit Förderpumpe sowie einem PFT Luftkompressor zum Aufspritzen.
Grundierung aufspritzen
Die flüssige Grundierung kann vollflächig mit der PFT SWING airless aufgespritzt oder auch mit einer Mischpumpe oder Förderpumpe und innengespeister Farbrolle aufgetragen werden.
PFT Maschinenempfehlung:
Mischpumpen PFT RITMO, Förderpumpen PFT SWING oder PFT SWING airless.
Oberputz aufspritzen
Maschinelles Auftragen des Oberputzes. Strukturierung mit der Maschine plus Spritzgerät für Oberputze.
Egalisationsfarbe aufspritzen
Das nebelarme Spritzen mit Airlesstechnologie rundet das Komplett-System zum Erstellen der WDVS-Fassade ab.
PFT Maschinenempfehlung:
Mischpumpen PFT RITMO, PFT G4 oder Förderpumpen PFT SWING mit PFT Luftkompressor.
PFT Maschinenempfehlung:
Förderpumpe PFT SWING airless oder ein Airless-Spritzgerät PFT SAMBA .


Unser technischer Auskunftsservice – von Profis für Profis! Wählen Sie den direkten Draht zur Just-in-time-Beratung und nutzen Sie unsere langjährige Erfahrung für Ihre Sicherheit.
Trockenbau- und Boden-Systeme
Tel. 09001 31-1000*
Putz- und Fassadensysteme
Tel. 09001 31-2000*
Mo – Do 7:00 – 18:00 Uhr und Fr 7:00 – 17:00 Uhr


Mit qualitativ hochwertigen und praxisorientierten Seminaren sowie Webinaren bieten wir Ihnen fundiertes Wissen für heute und auch für morgen. Nutzen Sie diesen Vorsprung für sich und Ihre Mitarbeiter, denn Bildung ist Zukunft!
Tel. 09323 31-487
www.knauf-akademie.de
Web, App oder Social Media – technische Unterlagen, interaktive Animationen, Videos und vieles mehr gibt es rund um die Uhr stets aktuell und natürlich kostenlos in der digitalen Welt von Knauf. Diese Klicks lohnen sich!
www.knauf.de
www.youtube.com/knauf
www.twitter.com/knauf_DE www.facebook.com/knaufDE
Technische Änderungen vorbehalten. Es gilt die jeweils aktuelle Auflage. Unsere Gewährleistung bezieht sich nur auf die einwandfreie Beschaffenheit unseres Materials. Konstruktive, statische und bauphysikalische Eigenschaften von Knauf Systemen können nur erreicht werden, wenn die ausschließliche Verwendung von Knauf Systemkomponenten oder von Knauf ausdrücklich empfohlenen Produkten sichergestellt ist. Verbrauchs-, Mengen- und Ausführungsangaben sind Erfahrungswerte, die im Falle abweichender Gegebenheiten nicht ohne Weiteres übertragen werden können. Die enthaltenen Angaben entsprechen unserem derzeitigen Stand der Technik. Der Prospekt kann aber nicht den Gesamtstand allgemein anerkannter Regeln der Bautechnik, einschlägiger Normen, Richtlinien und handwerklicher Regeln enthalten. Diese müssen vom Ausführenden neben den Verarbeitungsvorschriften entsprechend beachtet werden. Alle Rechte vorbehalten. Änderungen, Nachdrucke und fotomechanische sowie elektronische Wiedergabe, auch auszugsweise, bedürfen der ausdrücklichen Genehmigung der Firma Knauf Gips KG, Am Bahnhof 7, 97346 Iphofen. Lieferung über den Fachhandel lt. unseren jeweils gültigen allgemeinen Geschäfts-, Lieferungs- und Zahlungsbedingungen (AGB).
* Ein Anruf bei Knauf Direkt wird mit 0,39 €/Min. berechnet. Anrufer, die nicht mit Telefonnummer in der Knauf Gips KG Adressdatenbank hinterlegt sind, z. B. private Bauherren oder Nicht-Kunden, zahlen 1,69 €/Min. aus dem deutschen Festnetz. Mobilfunkanrufe können abweichen, sie sind abhängig von Netzbetreiber und Tarif.
Knauf Gips KG
Am Bahnhof 7
97346 Iphofen
Knauf Ceiling Solutions
Decken-Systeme
Knauf Bauprodukte
Profi-Lösungen für das Zuhause
Knauf Design
Oberflächenkompetenz
Knauf Gips
Trockenbau-Systeme
Boden-Systeme
Putz- und Fassadensysteme
Knauf Insulation
Dämmsysteme für Sanierung und Neubau
Knauf Integral
Gipsfasertechnologie für Boden, Wand und Decke
Knauf Performance Materials
Veredeltes Perlit für Horticulture und Industrieanwendungen, technische Isolierungen
Knauf PFT
Maschinentechnik und Anlagenbau
Marbos
Mörtelsysteme für Pflasterdecken im Tiefbau
Sakret Bausysteme
Trockenmörtel für Neubau und Sanierung